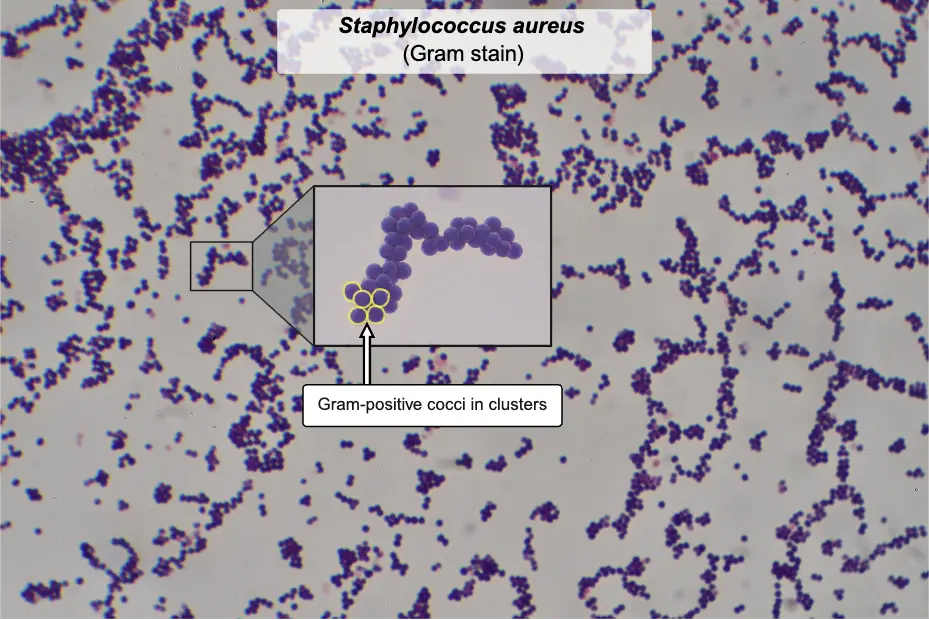
Staphylococcus aureus labeled

Block 1, Question 1
Correct Answer: A. Anti-citrullinated peptide antibodyExplanation
This 53-year-old woman presents with a chronic history of hand stiffness, pain, and fine motor impairment accompanied by visible swan-neck deformities of the fingers. These progressive joint changes are classic manifestations of long-standing rheumatoid arthritis, a systemic autoimmune condition that is most specifically confirmed by testing for an anti-citrullinated peptide antibody.
Rheumatoid arthritis is a chronic autoimmune disease characterized by inflammatory polyarthritis predominantly affecting the small joints. The pathogenesis involves an immune response against citrullinated proteins, where arginine residues are converted to citrulline during inflammation. Testing for anti-citrullinated peptide antibodies provides the highest diagnostic specificity. While rheumatoid factor, an autoantibody directed against the Fc portion of IgG, is also commonly measured and highly sensitive, it lacks specificity. Chronic articular inflammation leads to the formation of a pannus, an abnormal layer of fibrovascular granulation tissue that proliferates over the joint surface. This invasive tissue causes progressive cartilage destruction and classic joint derangements, including the swan-neck deformity visible in this patient.
Patients classically experience prolonged morning stiffness lasting greater than one hour that improves with use. In addition to the proximal interphalangeal hyperextension and distal interphalangeal flexion seen here, patients may develop a boutonniere deformity, characterized by proximal flexion and distal hyperextension. There is a strong genetic predisposition linked to the HLA-DR4 allele. Because the disease causes progressive and irreversible joint destruction, early initiation of disease-modifying antirheumatic drugs is critical. The primary first-line therapeutic agent is methotrexate, a folate antimetabolite that suppresses the abnormal immune response and halts disease progression. Without adequate treatment, patients are at increased risk for systemic complications, including accelerated atherosclerosis and interstitial lung disease.
Key TakeawayWhy the Other Choices Are Wrong
- Rheumatoid arthritis is a chronic autoimmune polyarthritis that causes progressive joint destruction, including swan-neck and boutonniere deformities.
- Anti-citrullinated peptide antibodies are the most specific diagnostic marker for rheumatoid arthritis, while rheumatoid factor is sensitive but less specific.
Choice B: Antimitochondrial antibody assay is the primary diagnostic test for primary biliary cholangitis, an autoimmune liver disease. Primary biliary cholangitis classically presents with severe fatigue, pruritus, hepatomegaly, and elevated alkaline phosphatase due to progressive destruction of intrahepatic bile ducts. This patient's isolated chronic joint pain and classic finger deformities make an autoimmune cholestatic liver disease unlikely.
Choice C: Human leukocyte antigen-DQ2 testing is utilized in the evaluation of celiac disease, an autoimmune enteropathy triggered by gluten exposure. Celiac disease typically manifests with chronic diarrhea, steatorrhea, weight loss, and nutritional deficiencies, though it can also cause a pruritic vesicular rash known as dermatitis herpetiformis. This patient's progressive hand stiffness and visible joint destruction without gastrointestinal symptoms make celiac disease unlikely.
Choice D: Precursor of the erythroid cell line infections, specifically by parvovirus B19, can cause joint symptoms. Parvovirus B19 replicates in erythroid progenitors and causes an acute, symmetric polyarthropathy in adults that closely mimics early rheumatoid arthritis, often accompanied by a viral prodrome. This patient's 6-year history of symptoms and permanent joint deformities make an acute viral arthropathy unlikely.
Choice E: Precursor of the thrombopoietic line abnormalities are characteristic of essential thrombocythemia, a myeloproliferative neoplasm driven by megakaryocyte proliferation. Essential thrombocythemia typically presents with vasomotor symptoms like erythromelalgia (burning pain and erythema of the hands and feet), headache, and an increased risk of thrombosis. This patient's structural joint deformities and chronic stiffness without burning neuropathic pain or digital ischemia make a myeloproliferative neoplasm unlikely.
Video Review: Rheumatoid Arthritis
Block 1, Question 2
Correct Answer: B. Asymmetric smileExplanation
This 80-year-old woman presents with right-sided hemiparesis, right-sided loss of vibration, and an inability to abduct the left eye. These clinical findings localize the infarction to the left medial pons, affecting the corticospinal tract, medial lemniscus, and abducens nerve. Because facial nerve fibers loop around the abducens nucleus here, an infarct would also predictably cause an asymmetric smile.
Medial pontine syndrome is most commonly caused by an atherothrombotic occlusion of the paramedian branches of the basilar artery. The resulting ischemia damages several key structures in the medial aspect of the pons. Involvement of the corticospinal tract in the basis pontis leads to contralateral spastic hemiparesis, hyperreflexia, and a positive Babinski sign. Concurrently, damage to the medial lemniscus disrupts the ascending dorsal column pathway, causing contralateral loss of tactile, vibratory, and position sense. The abducens nerve (CN VI) nucleus or fascicle is also affected, resulting in an ipsilateral lateral rectus palsy that prevents eye abduction.
In addition to these classic deficits, medial pontine lesions frequently involve the facial nerve (CN VII). The motor fibers of CN VII originate in the caudal pons and sweep dorsally to loop around the abducens nucleus, forming a bulge on the floor of the fourth ventricle known as the facial colliculus. Because of this intimate anatomical relationship, a medial pontine infarct extending dorsally often damages the CN VII fascicle as it wraps around CN VI. This combined structural damage leads to an ipsilateral lower motor neuron facial palsy, which manifests clinically as an asymmetric smile and inability to close the eye.
Key TakeawayWhy the Other Choices Are Wrong
- Medial pontine syndrome presents with contralateral hemiparesis, contralateral loss of proprioception/vibration, and ipsilateral abducens (CN VI) palsy.
- Because the facial nerve (CN VII) fibers loop around the abducens nucleus in the caudal pons, a medial pontine infarct can also damage CN VII, producing ipsilateral lower motor neuron facial weakness — clinically manifest as an asymmetric smile.
Choice A: Anesthesia of the left side of the face indicates a lesion of the trigeminal nerve (CN V) or its nucleus, located in the lateral pons. Lateral pontine syndrome typically results from anterior inferior cerebellar artery occlusion and presents with contralateral pain and temperature loss, ipsilateral facial paralysis, and ipsilateral facial anesthesia. This patient's left eye abduction deficit and right-sided hemiparesis make a lateral pontine lesion unlikely.
Choice C: Hoarseness results from damage to the nucleus ambiguus (CN IX and X), which is characteristic of lateral medullary (Wallenberg) syndrome. This condition typically occurs due to posterior inferior cerebellar artery occlusion and presents with dysphagia, hoarseness, absent gag reflex, and loss of pain and temperature sensation on the contralateral body and ipsilateral face. This patient's right-sided hemiparesis and left eye abduction deficit make lateral medullary syndrome unlikely.
Choice D: Loss of accommodation implies damage to the Edinger-Westphal nucleus or the oculomotor nerve (CN III), located in the midbrain. Medial midbrain (Weber) syndrome presents with an ipsilateral CN III palsy, characterized by a "down and out" eye, ptosis, pupillary dilation, and loss of accommodation, alongside contralateral hemiparesis. This patient's isolated left eye abduction deficit localizes the lesion to the pons, making a midbrain infarct unlikely.
Choice E: Paralysis of the tongue results from damage to the hypoglossal nerve (CN XII), a hallmark of medial medullary syndrome. This syndrome occurs due to anterior spinal artery occlusion, presenting with ipsilateral tongue deviation, contralateral hemiparesis, and contralateral proprioception loss. Despite the image description suggesting a medullary lesion, this patient's left eye abduction deficit definitively localizes the infarct to the pons, making medial medullary syndrome unlikely.
Video Review: Midbrain, Pons, and Medulla
Block 1, Question 3
Correct Answer: B. Factor V Leiden mutationExplanation
This 27-year-old woman presents with acute-onset dyspnea, hypoxemia, tachycardia, and tachypnea with clear lungs following prolonged immobilization on a cross-country flight. Combined with unilateral calf swelling and tenderness, these findings are highly suspicious for a deep vein thrombosis that has embolized to the pulmonary vasculature, a presentation in a young patient most commonly caused by Factor V Leiden mutation.
Factor V Leiden is the most common inherited thrombophilia in populations of European descent, resulting from an arginine to glutamine substitution in the factor V protein. This alteration makes the coagulation factor resistant to degradation by activated protein C, a natural anticoagulant that normally inactivates factors Va and VIIIa. The mutant factor Va remains active longer, leading to a hypercoagulable state with unchecked thrombin generation. Patients typically develop recurrent venous thromboembolism, often triggered by transient risk factors like prolonged immobilization or oral contraceptive use.
Diagnosis of a pulmonary embolism is confirmed using computed tomography pulmonary angiography, which reveals filling defects within the pulmonary vasculature. Acute management of a hemodynamically stable patient, as evidenced by her maintained blood pressure despite a history of borderline hypertension, involves immediate anticoagulation, often with a direct oral anticoagulant to prevent clot extension. In patients with inherited thrombophilias, the risk of recurrence is significantly elevated. A major long-term complication of recurrent pulmonary emboli is chronic thromboembolic pulmonary hypertension, which can eventually lead to right ventricular failure.
Key TakeawayWhy the Other Choices Are Wrong
- Factor V Leiden is the most common inherited thrombophilia, caused by a mutation rendering factor Va resistant to cleavage by activated protein C.
- It typically presents as deep vein thrombosis and pulmonary embolism in young patients following transient immobilization.
Choice A: Antithrombin III deficiency is an inherited thrombophilia that reduces the body's ability to inactivate thrombin and factor Xa. Patients classically present with venous thromboembolism and exhibit a blunted partial thromboplastin time prolongation following heparin administration. While this patient has a venous thromboembolism, antithrombin III deficiency is significantly less common than factor V Leiden, making it a less likely etiology.
Choice C: Glanzmann thrombasthenia is an autosomal recessive bleeding disorder caused by a deficiency or dysfunction of the platelet glycoprotein IIb/IIIa receptor. This defect prevents fibrinogen cross-linking, leading to impaired platelet aggregation. Patients typically present with mucocutaneous bleeding, epistaxis, and petechiae. This patient's presentation of a hypercoagulable state with deep vein thrombosis and pulmonary embolism makes a bleeding diathesis unlikely.
Choice D: Protein C deficiency is an inherited hypercoagulable disorder characterized by the inability to adequately inactivate factors Va and VIIIa. This condition predisposes individuals to venous thromboembolism and classically causes warfarin-induced skin necrosis upon initiation of vitamin K antagonists. Although it causes identical clinical manifestations to factor V Leiden, it is epidemiologically much rarer, making it a less probable diagnosis.
Choice E: von Willebrand disease is the most common inherited bleeding disorder, resulting from a quantitative or qualitative defect in von Willebrand factor. This protein normally bridges platelets to exposed subendothelial collagen and stabilizes factor VIII. Patients manifest with easy bruising, menorrhagia, and prolonged bleeding times. This patient's thrombotic presentation with calf swelling and hypoxemia directly contradicts a bleeding disorder.
Video Review: Peripheral Venous Disease
Block 1, Question 4
Correct Answer: C. HIV infectionExplanation
This 32-year-old man presents with a 2-week history of fever, tachycardia, pharyngitis with tonsillar exudates, and generalized lymphadenopathy. His presentation initially mimics infectious mononucleosis, but the presence of severe pancytopenia (anemia, leukopenia, thrombocytopenia) and a negative heterophile antibody test point toward an alternative viral etiology. This constellation of findings, particularly the diffuse lymph node involvement and profound bone marrow suppression, is highly characteristic of acute HIV infection.
Acute HIV infection typically manifests 2 to 4 weeks after initial exposure as acute retroviral syndrome, a mononucleosis-like illness driven by rapid viral replication and widespread dissemination. Patients classically develop fever, fatigue, pharyngitis, and generalized lymphadenopathy involving cervical, axillary, and inguinal nodes. While Epstein-Barr virus causes similar symptoms, acute HIV is frequently distinguished by mucocutaneous ulcerations, a characteristic maculopapular rash, and profound cytopenias. The severe anemia, leukopenia, and thrombocytopenia seen in this patient occur due to direct viral bone marrow suppression and immune-mediated destruction of circulating blood cells.
Diagnosis of acute HIV requires recognizing the window period when standard antibody tests may be falsely negative. The initial screening test of choice is a fourth-generation immunoassay that detects both HIV antibodies and the viral p24 antigen. If this test is indeterminate or if suspicion remains high during the early acute phase, an HIV RNA viral load test should be obtained to confirm the diagnosis. The profound lymphadenopathy reflects robust follicular hyperplasia as the immune system attempts to mount a response, while the virus simultaneously infects and depletes CD4+ T lymphocytes within these lymphoid tissues.

Why the Other Choices Are Wrong
- Acute HIV infection often presents as a mononucleosis-like illness with fever, generalized lymphadenopathy, and pharyngitis.
- It can be distinguished from Epstein-Barr virus by a negative heterophile antibody test, characteristic rash, and prominent cytopenias.
Choice A: Epstein-Barr virus infection causes infectious mononucleosis, a viral illness common in adolescents and young adults. It classically presents with fever, pharyngitis, fatigue, and posterior cervical lymphadenopathy. Atypical lymphocytosis is typically seen on a peripheral blood smear. This patient's negative heterophile antibody test, generalized (rather than localized cervical) lymphadenopathy, and severe pancytopenia make Epstein-Barr virus unlikely.
Choice B: Gonococcal pharyngitis is a localized mucosal infection caused by Neisseria gonorrhoeae following oral sexual exposure. It is often asymptomatic but can present with a sore throat, pharyngeal exudates, and isolated cervical lymphadenitis. Systemic dissemination can occasionally cause tenosynovitis and a pustular rash. This patient's generalized lymphadenopathy involving axillary and inguinal nodes, along with profound pancytopenia, make a localized gonococcal infection unlikely.
Choice D: Lymphogranuloma venereum infection is a sexually transmitted disease caused by Chlamydia trachomatis serovars L1-L3. It initially presents as a painless, transient genital ulcer, followed weeks later by painful, fluctuant, suppurative inguinal lymphadenopathy (buboes). Systemic symptoms like fever and malaise can accompany the lymph node involvement. This patient's prominent pharyngitis, generalized lymphadenopathy beyond the inguinal region, and severe pancytopenia make lymphogranuloma venereum unlikely.
Choice E: Streptococcal pharyngitis is a bacterial infection caused by Streptococcus pyogenes (Group A Strep). It typically presents with sudden-onset fever, severe sore throat, tonsillar exudates, and tender anterior cervical lymphadenopathy. It lacks viral symptoms like cough or rhinorrhea and typically causes a neutrophilic leukocytosis. This patient's diffuse axillary and inguinal lymphadenopathy, negative heterophile test context, and marked leukopenia rather than leukocytosis make streptococcal pharyngitis unlikely.
Block 1, Question 5
Correct Answer: C. Interstitial inflammatory infiltrateExplanation
This 60-year-old woman presents with fever, arthralgias, and a diffuse maculopapular rash after receiving 21 days of intravenous oxacillin, with a clean central line site making catheter infection unlikely. Laboratory evaluation reveals acute kidney injury with hyperkalemia, metabolic acidosis, peripheral eosinophilia, and urine white blood cell casts. This classic presentation of fever, rash, and eosinophilia following beta-lactam administration describes acute interstitial nephritis, which is characterized histologically by an interstitial inflammatory infiltrate.
Acute interstitial nephritis is an immune-mediated condition primarily triggered by medications, most commonly beta-lactam antibiotics, nonsteroidal anti-inflammatory drugs, proton pump inhibitors, and diuretics. The pathogenesis involves a type IV hypersensitivity reaction where the drug acts as a hapten, binding to tubular cells and inducing a T-cell-mediated immune response. This leads to an influx of lymphocytes, macrophages, and eosinophils into the renal interstitium, causing edema and tubular damage. Patients typically develop an acute kidney injury within weeks of initiating the offending agent. Affected individuals classically develop a maculopapular rash, fever, and arthralgias, though this full triad is present in a minority of cases.
Diagnosis of this condition is supported by peripheral eosinophilia and characteristic urinalysis findings, including sterile pyuria, eosinophiluria, and white blood cell casts. These casts form in the renal tubules due to the intense interstitial inflammation and localize the pathology to the tubulointerstitium rather than the glomerulus. The patient's significant hyperkalemia and metabolic acidosis reflect impaired distal tubular secretion and reduced glomerular filtration secondary to this interstitial damage. Management centers on prompt discontinuation of the offending agent, which typically leads to full recovery of renal function. In severe cases with persistent renal failure, systemic corticosteroids may be administered to accelerate recovery and reduce interstitial fibrosis.
Key TakeawayWhy the Other Choices Are Wrong
- Acute interstitial nephritis is an immune-mediated hypersensitivity reaction often triggered by beta-lactam antibiotics, presenting with fever, rash, eosinophilia, and acute kidney injury.
- Urinalysis characteristically shows sterile pyuria, eosinophiluria, and WBC casts reflecting an interstitial inflammatory infiltrate.
Choice A: Collapsing focal segmental glomerulosclerosis is a severe variant of FSGS characterized by collapse of the glomerular tuft. Affected patients classically develop massive proteinuria, nephrotic syndrome, and rapid progression to end-stage renal disease, most commonly in the setting of HIV infection, parvovirus B19, or severe COVID-19. This patient's prominent eosinophilia, WBC casts, and recent oxacillin use make an interstitial process more likely than a primary glomerular disease.
Choice B: Glomerular hypertrophy with hemorrhage and necrosis describes the pathologic findings of rapidly progressive glomerulonephritis. Patients typically present with nephritic syndrome, characterized by acute renal failure, hypertension, hematuria, and red blood cell casts. It is often associated with ANCA-associated vasculitides or anti-GBM disease. This patient's urinalysis showing WBC casts and eosinophils, rather than red blood cell casts, makes a nephritic syndrome unlikely.
Choice D: Mesangial expansion with glomerular basement membrane thickening is the classic histologic hallmark of diabetic nephropathy. This condition develops over years of poorly controlled diabetes mellitus. Patients initially develop microalbuminuria before progressing to overt nephrotic syndrome and eventual chronic kidney disease. This patient's acute onset of renal failure, normal blood glucose level, and systemic allergic symptoms rule out a chronic diabetic complication.
Choice E: Proximal tubular dilation with loss of brush border describes the histologic changes seen in acute tubular necrosis. This condition typically results from ischemic injury (e.g., severe hypotension) or nephrotoxic agents (e.g., aminoglycosides). Urinalysis characteristically reveals muddy brown granular casts. This patient's normotensive state, lack of exposure to classic tubular nephrotoxins, and presence of WBC casts rather than granular casts make this diagnosis unlikely.
Video Review: Type III Hypersensitivity Reactions
Block 1, Question 6
Correct Answer: D. TraumaExplanation
This 20-year-old woman presents with progressive upper extremity weakness, decreased pinprick sensation, headache, and back pain managed with ibuprofen, with MRI confirming a cervical spinal cord syrinx. This classic "cape-like" loss of pain and temperature sensation combined with lower motor neuron weakness indicates syringomyelia, an acquired form of which is most commonly associated with prior Trauma.
Syringomyelia involves the formation of a fluid-filled cavity within the spinal cord, most frequently in the cervical region. The expanding syrinx initially compresses the anterior white commissure, disrupting the decussating fibers of the spinothalamic tract and causing bilateral loss of pain and temperature sensation in the upper extremities. As the cavity enlarges, it can compress the anterior horn cells, leading to lower motor neuron signs such as flaccid weakness and atrophy in the hands and arms. Acquired syringomyelia frequently develops as a late complication of spinal cord injury, often presenting months to years after the initial event.
While acquired cases often follow mechanical injury, meningitis, or tumors, congenital syringomyelia is strongly associated with Chiari type I malformation. In this condition, downward displacement of the cerebellar tonsils through the foramen magnum obstructs cerebrospinal fluid flow, which can manifest with occipital headaches and neck or back pain. Patients may also develop Horner syndrome if the syrinx extends laterally to involve the sympathetic chain in the lower cervical or upper thoracic cord. Diagnosis relies on MRI, and definitive management of a symptomatic, expanding cavity typically requires surgical decompression to restore normal cerebrospinal fluid dynamics.
Key TakeawayWhy the Other Choices Are Wrong
- Syringomyelia is a fluid-filled spinal cord cavity that damages the crossing spinothalamic tracts, causing bilateral loss of pain and temperature sensation.
- Acquired syringomyelia is strongly associated with prior spinal cord trauma, which can precede symptom onset by months to years.
Choice A: Diet history is essential for evaluating nutritional deficiencies like subacute combined degeneration caused by vitamin B12 deficiency. Vitamin B12 deficiency classically presents with progressive symmetric paresthesias, sensory ataxia, and spastic paresis due to demyelination of the dorsal columns and lateral corticospinal tracts. This patient's isolated loss of pinprick sensation, lower motor neuron weakness, and structural cervical syrinx make a dietary nutritional deficiency unlikely.
Choice B: Family illness history is relevant for inherited neurologic disorders such as amyotrophic lateral sclerosis. Familial amyotrophic lateral sclerosis involves degeneration of upper and lower motor neurons, leading to progressive weakness, fasciculations, hyperreflexia, and eventual respiratory failure without sensory deficits. This patient's prominent sensory deficits to pinprick and structural spinal cord cavity on MRI make an inherited neurodegenerative disease unlikely.
Choice C: Recent travel history is crucial when suspecting infectious myelopathies, such as poliovirus. Poliovirus infection causes an asymmetric flaccid paralysis due to the destruction of anterior horn cells, typically accompanied by a viral prodrome of fever, malaise, and aseptic meningitis. This patient's symmetric upper extremity weakness, prominent sensory loss, and structural syrinx on MRI make a travel-related infectious myelopathy unlikely.
Choice E: Unintended weight loss is a systemic symptom raising suspicion for a neoplastic process like an intramedullary spinal cord tumor. Spinal cord ependymomas can cause progressive myelopathy, localized back pain, and secondary syringomyelia due to obstructed cerebrospinal fluid flow. While a tumor could cause a syrinx, this patient's MRI shows an isolated cavity without an enhancing mass, making a neoplastic process less likely.
Video Review: Central Cord Syndrome
Block 1, Question 7
Correct Answer: E. Vascular obstruction by lipid-rich plaquesExplanation
This 68-year-old man presents with bilateral exertional lower extremity pain relieved by rest, absent pedal pulses, and atrophic skin changes in the setting of multiple cardiovascular risk factors. These findings are classic for intermittent claudication due to peripheral artery disease, which is driven by atherosclerosis and ultimately results in vascular obstruction by lipid-rich plaques.
Peripheral artery disease is primarily caused by atherosclerosis of the large and medium-sized arteries supplying the lower extremities. The pathogenesis begins with chronic endothelial injury from risk factors like hypertension, diabetes mellitus, and dyslipidemia, all present in this patient. This damage allows low-density lipoproteins to enter the tunica intima, where they are oxidized and engulfed by macrophages to form foam cells. Smooth muscle cells then migrate from the media to the intima, proliferating and synthesizing extracellular matrix to create a fibrous cap over the lipid core. This growing atheromatous plaque progressively narrows the arterial lumen.
The resulting flow-limiting stenosis prevents adequate oxygen delivery during exertion, causing intermittent claudication. Chronic hypoperfusion also leads to the observed trophic changes, including dermal atrophy, alopecia, and cool extremities. Diagnosis is typically confirmed using the ankle-brachial index, with a ratio of less than 0.9 indicating significant disease. As the arterial narrowing worsens, patients may develop ischemic rest pain or tissue necrosis. Management includes aggressive risk factor modification with statins and antiplatelet therapy, both of which this patient is receiving. Symptomatic relief of claudication can be achieved with a supervised exercise program or cilostazol, a phosphodiesterase inhibitor that promotes vasodilation.

Why the Other Choices Are Wrong
- Peripheral artery disease is caused by atherosclerosis, where endothelial injury leads to the formation of lipid-rich plaques in the arterial intima.
- Progressive vessel narrowing causes exertional ischemia (intermittent claudication) and chronic hypoperfusion signs like dermal atrophy, hair loss, and absent pulses.
Choice A: Fibromuscular dysplasia is a nonatherosclerotic, noninflammatory vascular disease characterized by abnormal cellular proliferation within arterial walls. It classically presents in young to middle-aged women with resistant hypertension due to renal artery stenosis or headache and tinnitus from carotid artery involvement. This patient's older age, male sex, and classic lower extremity claudication make fibromuscular dysplasia unlikely.
Choice B: Giant cell arteritis is a systemic granulomatous vasculitis that primarily affects the large branches of the aorta, particularly the external carotid artery. Patients typically present with new-onset headache, scalp tenderness, jaw claudication, and visual disturbances. It is strongly associated with polymyalgia rheumatica. This patient's lower extremity pain and lack of cranial symptoms make giant cell arteritis unlikely.
Choice C: Hyaline arteriosclerosis involves the thickening of small arteries and arterioles due to the deposition of homogenous, pink hyaline material. This process is driven by chronic hemodynamic stress from longstanding benign hypertension or diabetes mellitus, typically causing progressive nephropathy. While this patient's diabetic nephropathy indicates underlying hyaline arteriosclerosis, his macrovascular lower extremity symptoms are caused by atherosclerosis.
Choice D: Segmental inflammation of medium-sized vessels describes thromboangiitis obliterans (Buerger disease), a nonatherosclerotic vasculitis. This condition is characterized by highly cellular, inflammatory thrombi that spare the blood vessel wall. It almost exclusively affects young, heavy cigarette smokers and presents with distal extremity ischemia. This patient's older age, extensive atherosclerotic risk factors, and lack of a heavy smoking history make Buerger disease unlikely.
Video Review: Peripheral Artery Disease
Block 1, Question 8
Correct Answer: D. Fused commissuresExplanation
This 31-year-old woman presents with progressive dyspnea, fatigue, and signs of pulmonary edema and pleural effusion (crackles, dullness to percussion) in the setting of a childhood febrile heart illness in a developing country. This presentation strongly suggests left-sided heart failure secondary to chronic rheumatic heart disease, which characteristically causes mitral stenosis due to fused commissures.
Acute rheumatic fever typically occurs weeks after an untreated group A streptococcal pharyngitis, leading to immune-mediated pancarditis via molecular mimicry. While the acute phase can cause mitral regurgitation, repeated inflammatory episodes over decades lead to chronic rheumatic heart disease. The hallmark anatomic change is progressive fibrosis, calcification, and fusion of the valve leaflets at their edges. This produces a characteristic "fish-mouth" deformity resulting in severe mitral stenosis. The stenotic valve obstructs left ventricular filling during diastole, causing elevated left atrial pressures that transmit backward into the pulmonary vasculature, manifesting clinically as progressive dyspnea, cardiogenic pulmonary edema, and pleural effusions.
Cardiac auscultation of this valvular lesion classically reveals a loud S1, an early diastolic opening snap, and a low-pitched mid-to-late diastolic rumbling murmur heard best at the cardiac apex. The severity of the stenosis inversely correlates with the time interval between the A2 component of the second heart sound and the opening snap; a shorter interval indicates more severe disease. Over time, chronic pressure overload leads to profound left atrial dilation, which significantly increases the risk of developing atrial fibrillation and subsequent mural thrombus formation. Patients are consequently at high risk for systemic thromboembolism, particularly ischemic stroke.
Key TakeawayWhy the Other Choices Are Wrong
- Chronic rheumatic heart disease is a late complication of acute rheumatic fever, most commonly causing mitral stenosis.
- The hallmark anatomic finding is fusion of the valve commissures, producing a "fish-mouth" deformity that obstructs diastolic ventricular filling.
Choice A: Ballooned leaflets are the hallmark anatomic finding in mitral valve prolapse (MVP). This condition is characterized by enlarged, floppy leaflets that prolapse into the left atrium during systole, producing a mid-systolic click and late systolic murmur. This patient's history of a childhood febrile heart condition and current presentation of severe heart failure make chronic rheumatic heart disease much more likely than MVP.
Choice B: Bulky cusp vegetations are the classic pathologic finding in infective endocarditis. These friable masses consist of fibrin, inflammatory cells, and microorganisms, typically forming on the valve leaflets. Patients present with acute or subacute fever, new heart murmurs, and embolic phenomena such as Janeway lesions. This patient's normal temperature and lack of peripheral stigmata of endocarditis make an active infectious valvular process unlikely.
Choice C: Calcified nodules at the base of the aortic cusps are the primary anatomic change in calcific aortic stenosis. This degenerative process typically presents in patients over 65 years old, causing a crescendo-decrescendo systolic murmur and the classic triad of angina, syncope, and heart failure. This patient's young age and specific history of a childhood febrile heart illness point toward a post-inflammatory rheumatic etiology rather than age-related degenerative calcification.
Choice E: Myxomatous degeneration is the underlying histologic mechanism responsible for mitral valve prolapse. This process involves the accumulation of glycosaminoglycans within the valve layer, leading to structural weakening and leaflet redundancy. It is frequently associated with connective tissue disorders like Marfan syndrome. This patient's clinical picture of chronic post-inflammatory valvular scarring following a childhood infection in an endemic region does not align with a primary myxomatous process.
Video Review: Mitral Stenosis
Block 1, Question 9
Correct Answer: A. "Are there any reasons why you might want to quit smoking?"Explanation
This 58-year-old man presents with chronic obstructive pulmonary disease and a stated lack of readiness to quit smoking despite a 35-pack-year history. His previous unsuccessful quit attempts and current reluctance indicate he is in the precontemplation stage of behavioral change. The most effective approach is to gently explore his internal motivations using open-ended questions, making the most appropriate physician statement "Are there any reasons why you might want to quit smoking?"
In the precontemplation stage, patients do not intend to take action in the foreseeable future and may be unaware that their behavior is problematic. The physician's goal is to build rapport, avoid confrontation, and gently encourage the patient to evaluate the pros and cons of their actions. Motivational interviewing is a patient-centered counseling style designed to elicit behavior change by helping patients explore and resolve ambivalence. Asking open-ended questions about potential reasons to quit encourages change talk, allowing the patient to articulate their own arguments for smoking cessation rather than feeling pressured by the physician.
After precontemplation comes the contemplation stage, where patients recognize the problem and intend to change within six months but remain ambivalent. This is followed by the preparation stage, characterized by planning to take action within the next month, often accompanied by small steps like setting a quit date. Finally, patients enter the action stage by actively modifying their behavior, and later the maintenance stage to prevent relapse. Recognizing a patient's current stage is critical because interventions must be tailored to their specific level of readiness to maximize success.
Key TakeawayWhy the Other Choices Are Wrong
- Motivational interviewing uses open-ended questions to elicit "change talk" and help patients explore their own reasons for behavioral modification.
- For patients in the precontemplation stage, physicians should avoid confrontation, unsolicited advice, or guilt, and instead foster collaborative exploration.
Choice B: "Are you aware that your lung condition is chronic at this point?" is a closed-ended, confrontational question focusing on health education. Providing unsolicited medical facts or emphasizing illness severity often provokes defensiveness in patients who are not ready to change. This patient's explicit statement that he is not ready to quit indicates that highlighting his COPD chronicity will likely increase resistance rather than foster motivation.
Choice C: "I'm sure you don't want your wife to suffer as a result of your smoking" is a guilt-inducing statement that leverages a family member's distress. Using shame or emotional manipulation damages the therapeutic alliance and often leads to patient withdrawal. This patient's wife's complaints of cough and chest tightness should be addressed, but using her symptoms to shame the patient violates the principles of nonjudgmental motivational interviewing.
Choice D: "The majority of your health issues would improve if you quit smoking" is a directive statement providing unsolicited advice about the benefits of cessation. Telling patients what they should do or why they should do it typically elicits pushback, as it ignores their autonomy. This patient's prior unsuccessful quit attempts suggest he is likely already aware of the health benefits of quitting, making this paternalistic statement ineffective.
Choice E: "Why haven't you been able to stay off cigarettes?" is a "why" question that focuses on past failures. Questions beginning with "why" often sound accusatory and force patients to defend their negative behaviors, highlighting barriers rather than focusing on self-efficacy. This patient's history of two unsuccessful quit attempts makes him vulnerable to feelings of failure; asking him to justify these relapses will likely decrease his confidence.
Video Review: Transtheoretical Model of Change
Block 1, Question 10
Correct Answer: B. Caloric insufficiencyExplanation
This 18-month-old girl presents for a well-child examination with a recent drop in weight from the 25th to below the 5th percentile, while her length has remained stable at the 25th percentile. Her diet of only 16 ounces of formula and minimal table food provides inadequate energy to sustain normal growth, a pattern of isolated weight deceleration characteristic of caloric insufficiency.
Pediatric failure to thrive is most commonly caused by inadequate dietary intake, often stemming from poor feeding practices or a delayed transition to solid foods. The sequence of growth parameter deceleration provides crucial diagnostic clues. In cases of nutritional deprivation, weight is typically the first parameter to decline, crossing two or more major percentile lines on standard growth curves. As the deficiency persists, linear growth subsequently decelerates. In severe, prolonged cases, a decline in head circumference eventually occurs, reflecting brain-sparing mechanisms being overwhelmed. This patient's isolated drop in weight with preserved length strongly points to an early nutritional deficit rather than an intrinsic systemic disease.
Management of nutritional insufficiency requires a detailed dietary history to identify specific deficits. By 18 months of age, toddlers should be consuming a diverse diet of solid foods, as liquid nutrition alone cannot meet their increasing energy demands. The recommended daily caloric requirement for this age group is approximately 1000 kilocalories. This patient's intake of 16 ounces of formula provides only about 320 kilocalories, leaving a substantial deficit if table food consumption is minimal. Initial intervention involves targeted dietary counseling to increase energy-dense solid foods and establish structured mealtime routines. If weight gain does not improve, further investigation for malabsorption syndromes or underlying organic diseases is warranted.
Key TakeawayWhy the Other Choices Are Wrong
- In pediatric failure to thrive from caloric insufficiency, weight is the first growth parameter to decline, followed by length, and eventually head circumference.
- An isolated drop in weight percentiles with preserved length strongly suggests inadequate nutritional intake rather than an endocrine disorder.
Choice A: Adrenal insufficiency involves inadequate production of glucocorticoids and mineralocorticoids from the adrenal cortex. Primary adrenal insufficiency classically presents with fatigue, weight loss, gastrointestinal distress, hypotension, hyponatremia, hyperkalemia, and hyperpigmentation due to elevated corticotropin levels. This patient's normal developmental milestones, lack of gastrointestinal symptoms, and isolated drop in weight without other systemic signs of illness make adrenal insufficiency unlikely.
Choice C: Constitutional growth delay is a benign variant of normal growth characterized by a temporary deceleration in linear growth during early childhood. Children with this condition typically have a delayed bone age, a family history of "late bloomers," and eventually reach a normal adult height after a delayed pubertal growth spurt. This patient's isolated drop in weight with a preserved length at the 25th percentile contradicts the linear growth deceleration that defines constitutional growth delay.
Choice D: Familial short stature is a genetic predisposition to a lower final adult height based on parental statures. Children with this growth pattern establish a growth trajectory at or below the 5th percentile for length early in life but maintain a normal growth velocity and have a bone age matching their chronological age. This patient's parents are of average height, and her length remains normal at the 25th percentile, ruling out familial short stature.
Choice E: Growth hormone deficiency is an endocrine disorder characterized by inadequate secretion of somatotropin from the anterior pituitary gland. Patients typically exhibit severe short stature, a markedly decreased linear growth velocity, delayed bone age, and increased subcutaneous fat, often resulting in a chubby appearance with a prominent forehead. This patient's normal length at the 25th percentile and thin appearance directly contrast with the linear growth failure and increased adiposity expected in growth hormone deficiency.
Block 1, Question 11
Correct Answer: A. Internal validityExplanation
This question describes a prospective cohort study of 256 women aged 45 to 65 evaluating the association between dietary calcium consumption and osteoporosis risk, with bone mineral density measured via DEXA scan. Investigators notice a major dietary calcium source is missing from the self-reported food frequency questionnaire and add it prior to distribution. Correcting this measurement flaw ensures accurate exposure classification, thereby improving the study's internal validity.
Internal validity refers to the degree to which a study accurately establishes a cause-and-effect relationship, free from systematic error. In this prospective cohort study, the exposure is dietary calcium consumption. Failing to include yogurt, a major calcium source, would result in misclassification bias because participants consuming high amounts of yogurt would be incorrectly categorized as having low intake. This specific flaw, known as measurement bias, distorts the true association between exposure and outcome. By adding yogurt to the questionnaire, investigators ensure accurate data collection.
While internal validity focuses on accuracy within the study cohort, researchers must also consider how well findings apply to outside populations, a concept known as external validity. A study cannot be generalizable if its internal metrics are flawed. Furthermore, data collection tools must demonstrate reliability, meaning they produce consistent results upon repeated testing. An instrument can be highly reproducible but completely inaccurate, highlighting that consistency does not guarantee correctness. Adding yogurt to this questionnaire directly improves the accuracy of the calcium intake assessment rather than just its consistency.
Key TakeawayWhy the Other Choices Are Wrong
- Internal validity is the degree to which a study accurately measures what it intends to measure within its sample, minimizing systematic errors.
- Correcting a questionnaire to include all major exposure sources prevents measurement bias and improves internal validity.
Choice B: Inter-rater reliability is a measure of consistency that evaluates the degree of agreement among different observers assessing the same variable. High inter-rater agreement ensures that subjective measurements, such as physical exam findings or radiological interpretations, are not dependent on the specific clinician performing the assessment. This study utilizes a self-reported food frequency questionnaire rather than observer-based assessments, making this metric irrelevant to the addition of yogurt.
Choice C: Response rate represents the proportion of invited individuals who actually complete and return a study questionnaire. High participation minimizes nonresponse bias, which occurs when non-participants differ systematically from participants, potentially skewing results. Adding items to a survey typically decreases rather than improves participant completion, and this study's addition of yogurt aims to fix data quality rather than boost participation numbers.
Choice D: Type I error is the probability of incorrectly rejecting a true null hypothesis, effectively claiming a false-positive association. This statistical parameter is determined by the alpha level set by investigators before data collection begins, conventionally established at 0.05 in most medical literature. Adding yogurt to the questionnaire improves the factual correctness of the exposure data but does not directly alter the predefined statistical threshold for this study's hypothesis testing.
Video Review: Longitudinal Studies
Block 1, Question 12
Correct Answer: D. Reduviid bugExplanation
This 40-year-old woman presents with asymptomatic Trypanosoma cruzi parasitemia incidentally discovered during blood donation screening. Her history of residence in El Salvador establishes exposure in an endemic region for Chagas disease, a parasitic infection transmitted by the feces of a Reduviid bug.
Trypanosoma cruzi is a protozoan parasite responsible for American trypanosomiasis, commonly known as Chagas disease. The infection is endemic to Central and South America. The reduviid bug (kissing bug) acquires the parasite by taking a blood meal from an infected host. During subsequent nocturnal feedings, the bug defecates on the human host's skin. Transmission occurs when the sleeping host inadvertently rubs the infected triatomine feces into the bite wound or mucous membranes. Acute infection is often asymptomatic but can present with localized swelling at the inoculation site, such as unilateral periorbital edema known as Romana sign.
Following the acute phase, patients enter a prolonged asymptomatic indeterminate phase that can last for decades, matching this patient's current presentation. However, approximately one-third of infected individuals eventually develop chronic symptomatic disease due to persistent low-grade tissue parasitism and immune-mediated damage. The most severe complication is dilated cardiomyopathy, which frequently features a characteristic apical aneurysm and can lead to fatal arrhythmias or congestive heart failure. Destruction of the enteric nervous system myenteric plexus leads to severe gastrointestinal dysmotility, classically manifesting as megaesophagus or megacolon.
Key TakeawayWhy the Other Choices Are Wrong
- Trypanosoma cruzi causes Chagas disease and is transmitted by the feces of the reduviid (kissing) bug in Central and South America.
- Chronic Chagas disease can lead to severe complications including dilated cardiomyopathy, apical aneurysms, megaesophagus, and megacolon.
Choice A: Bedbugs (Cimex lectularius) are parasitic insects that feed on human blood during the night. Infestations classically present with intensely pruritic, erythematous papules arranged in a linear "breakfast, lunch, and dinner" pattern on exposed skin. This patient's positive serology for Trypanosoma cruzi makes a bedbug bite unlikely, as they are not known vectors for major human pathogens.
Choice B: Black flies (Simulium species) are the primary vectors for Onchocerca volvulus, a tissue nematode endemic to sub-Saharan Africa and parts of Latin America. Onchocerciasis (river blindness) classically manifests with severely pruritic subcutaneous nodules, patchy depigmentation, and progressive corneal scarring leading to blindness. This patient's lack of dermatologic or ocular findings, along with her confirmed T. cruzi infection, rules out a black fly vector.
Choice C: Mosquitoes serve as vectors for numerous pathogens, including Plasmodium species (malaria), Wuchereria bancrofti (lymphatic filariasis), and various arboviruses like Dengue and Zika. Malaria classically presents with cyclic fevers, chills, and hemolytic anemia, while arboviruses often cause acute febrile illnesses with rash and arthralgias. This patient's asymptomatic presentation and specific positive serology for T. cruzi make a mosquito-borne illness incorrect.
Choice E: Ticks are arachnid vectors responsible for transmitting several important diseases, including Lyme disease (Borrelia burgdorferi), babesiosis (Babesia microti), and Rocky Mountain spotted fever (Rickettsia rickettsii). Tick-borne illnesses typically present acutely with fever, characteristic rashes (erythema migrans or petechial rash), and systemic symptoms like myalgias or arthralgias. This patient's chronic, asymptomatic T. cruzi parasitemia acquired in Central America makes a tick vector incorrect.
Video Review: Trypanosoma Cruzi
Block 1, Question 13
Correct Answer: A. "Help me to understand what you are hoping I can do for you today."Explanation
This 40-year-old man presents with recurrent lower abdominal pain consistent with his known irritable bowel syndrome, alongside a history of medication refusal and reliance on herbal remedies. Despite declining pharmacologic intervention and having an unremarkable physical examination, his repeated visits indicate an unmet need or underlying concern. To best address this, the physician should explore the patient's goals for the visit by asking, "Help me to understand what you are hoping I can do for you today."
When a patient repeatedly seeks medical care but declines recommended treatments, physicians must avoid expressing frustration and instead focus on understanding the patient's underlying motivations. This scenario requires a patient-centered interviewing approach to uncover the specific reasons prompting the visit. Patients may return for reassurance, symptom validation, or alternative management strategies rather than pharmacotherapy. By directly asking about the patient's goals, the physician fosters a collaborative environment and identifies hidden concerns, such as fear of disease progression or psychosocial stressors. Establishing clear visit expectations prevents mutual frustration and allows the physician to tailor their counseling to the patient's actual needs, thereby strengthening the therapeutic alliance.
Patients with chronic functional disorders like irritable bowel syndrome often experience fluctuating symptoms that drive them to seek alternative therapies. When patients utilize complementary and alternative medicine, physicians should explore these practices nonjudgmentally to ensure they are safe and do not interact with other conditions. Respecting patient autonomy is paramount; individuals have the right to refuse conventional medications, and this refusal should not result in the withdrawal of care. Instead, the physician should provide education on the natural history of the condition and offer non-pharmacologic interventions, such as dietary modifications, behavioral therapy, or stress management, which align better with this patient's preferences.
Key TakeawayWhy the Other Choices Are Wrong
- When patients repeatedly seek care but refuse standard treatments, physicians should use open-ended questions to explore their underlying expectations and goals for the visit.
- Respecting patient autonomy and maintaining the therapeutic alliance are essential when navigating medication refusal.
Choice B: Recommending medication again attempts to push a previously rejected pharmacologic treatment plan. While physicians should periodically reassess a patient's willingness to accept standard therapies, repeatedly pressing the issue without understanding the patient's perspective can damage rapport and lead to defensive behavior. This patient's explicit refusal of medication at prior visits makes it counterproductive to immediately suggest prescriptions before exploring his current goals.
Choice C: Expressing confusion or frustration directly confronts the patient in an adversarial manner. Confrontational statements can make patients feel alienated, judged, or unwelcome, which severely degrades trust and communication. Physicians should maintain a professional, empathetic demeanor even in challenging encounters. This patient's repeated visits despite an unremarkable physical examination indicate an unmet need; an accusatory statement fails to uncover this need and damages the physician-patient relationship.
Choice D: Focusing immediately on the herbal tea prioritizes a specific detail over the patient's primary reason for the visit. While obtaining a comprehensive history of supplements is important to evaluate for potential toxicities or interactions, it should follow the establishment of the visit's main agenda. This patient's herbal tea consumption is relevant, but discussing it before understanding his overarching goals for this third visit fails to address his primary underlying concerns.
Choice E: Stating that nothing can be done represents an ultimatum and an inappropriate threat of patient abandonment. Physicians have an ethical obligation to provide ongoing care and support, even when patients decline the recommended standard of care. Alternative management strategies, such as lifestyle counseling or simple reassurance, are valid medical interventions. This patient's right to refuse medication must be respected, and threatening to withdraw care violates ethical principles.
Video Review: Interviewing Patients
Block 1, Question 14
Correct Answer: B. α₁-Adrenergic antagonismExplanation
This 72-year-old man presents with lower urinary tract symptoms, including frequency, nocturia, and a slow urinary stream, alongside a diffusely enlarged, symmetric prostate on digital rectal examination. These findings are classic for benign prostatic hyperplasia, a common condition in older men that causes bladder outlet obstruction, for which the first-line pharmacotherapy relies on α₁-adrenergic antagonism.
Benign prostatic hyperplasia causes both static obstruction from glandular enlargement and dynamic bladder outlet obstruction mediated by increased sympathetic tone. The prostate stroma and bladder neck are rich in alpha-1 receptors, which are targeted by first-line medications like tamsulosin and terazosin. By blocking these receptors, these agents induce smooth muscle relaxation within the prostatic urethra, rapidly decreasing resistance to urinary flow and alleviating symptoms such as hesitancy and a weak stream. This symptomatic relief occurs within days to weeks, making these agents the preferred initial monotherapy for patients with moderate to severe symptoms.
While alpha-1 blockers provide rapid symptomatic relief, they do not alter the underlying disease progression or reduce prostate volume. Non-selective agents can cause systemic vasodilation leading to orthostatic hypotension and dizziness, though uroselective agents minimize these risks. Another notable complication of these medications is intraoperative floppy iris syndrome, which complicates cataract surgery. For patients with significantly enlarged prostates who do not respond adequately to monotherapy, 5-alpha-reductase inhibitors such as finasteride can be added; these agents block the conversion of testosterone to dihydrotestosterone, gradually shrinking the glandular epithelium over several months to prevent urinary retention.
Key TakeawayWhy the Other Choices Are Wrong
- First-line pharmacotherapy for benign prostatic hyperplasia utilizes alpha-1 adrenergic antagonists to relax the smooth muscle of the prostate and bladder neck.
- These agents provide rapid relief of lower urinary tract symptoms by decreasing dynamic bladder outlet obstruction.
Choice A: α₁-Adrenergic agonism is the mechanism of action for medications like midodrine and pseudoephedrine, which cause vascular smooth muscle contraction. These agents are typically used to treat orthostatic hypotension or nasal congestion by increasing peripheral vascular resistance and elevating blood pressure. This patient's normal blood pressure and need for prostatic smooth muscle relaxation make an alpha-1 agonist inappropriate, as it would actually worsen his urinary retention.
Choice C: α₂-Adrenergic agonism is the mechanism of central sympatholytics such as clonidine and dexmedetomidine, which decrease sympathetic outflow from the central nervous system. These medications are primarily utilized for the management of hypertensive emergencies, attention-deficit/hyperactivity disorder, or as sedative agents in the intensive care unit. This patient's normotensive status and presentation of benign prostatic hyperplasia make central alpha-2 agonists unhelpful, as they do not target prostatic smooth muscle tone.
Choice D: α₂-Adrenergic antagonism is the mechanism of action for mirtazapine, an atypical antidepressant that increases the release of norepinephrine and serotonin. This medication is highly effective for treating major depressive disorder, particularly in patients who also experience insomnia and significant weight loss, due to its sedating and appetite-stimulating properties. This patient's lack of depressive symptoms and isolated lower urinary tract complaints make an alpha-2 antagonist an incorrect therapeutic choice.
Choice E: β₁-Adrenergic agonism is the primary mechanism of dobutamine, an inotropic agent that increases cyclic AMP levels in cardiac myocytes. This stimulation leads to increased myocardial contractility and heart rate, making it a first-line treatment for cardiogenic shock or severe decompensated heart failure requiring hemodynamic support. This patient's normal pulse of 66/min, lack of cardiovascular distress, and localized prostatic enlargement make a beta-1 agonist completely unnecessary and potentially harmful.
Choice F: β₁-Adrenergic antagonism is the mechanism of cardioselective beta-blockers like metoprolol and atenolol, which decrease heart rate and myocardial contractility. These medications are foundational treatments for rate control in atrial fibrillation, management of stable angina, and improving mortality in patients with chronic heart failure. This patient's benign prostatic hyperplasia requires targeted urologic therapy; his normal resting heart rate and blood pressure indicate no need for beta-blockade.
Video Review: Benign Prostatic Hyperplasia
Block 1, Question 15
Correct Answer: A. Bipolar disorder, manic, with psychotic featuresExplanation
This 33-year-old woman presents with a two-month history of grandiose and paranoid delusions, auditory hallucinations, pressured speech, loose associations, and a decreased need for sleep. These findings represent a distinct period of abnormally elevated mood and energy accompanied by psychotic symptoms, which is highly characteristic of Bipolar disorder, manic, with psychotic features.
A diagnosis of bipolar I disorder requires at least one lifetime manic episode, defined as a distinct period of abnormally elevated or expansive mood and persistently increased energy lasting at least one week. The diagnosis requires three or more characteristic symptoms, which include a decreased need for sleep, pressured speech, flight of ideas, and grandiosity. The presence of delusions and auditory hallucinations indicates severe impairment, automatically qualifying the episode as manic rather than hypomanic. Acute management of severe mania with psychotic features typically requires hospitalization and treatment with first-generation antipsychotics or mood stabilizers such as lithium.
Differentiating this condition from primary psychotic disorders requires establishing the temporal relationship between mood and psychotic symptoms. In bipolar disorder with psychotic features, delusions and hallucinations occur exclusively during the mood episode. If psychotic symptoms persist for at least two weeks in the absence of a major mood episode, the diagnosis is schizoaffective disorder. Furthermore, while this patient uses natural substances and refuses a toxicology screen, a substance-induced psychotic disorder must be ruled out clinically, as stimulants like cocaine or amphetamines can mimic mania. Long-term maintenance therapy often incorporates valproate to prevent recurrent mood episodes.
Key TakeawayWhy the Other Choices Are Wrong
- Bipolar I disorder requires at least one manic episode, characterized by elevated mood, decreased need for sleep, and pressured speech lasting at least one week.
- Psychotic features (delusions, hallucinations) can occur during severe manic episodes but do not occur independently of the mood disturbance.
Choice B: Brief psychotic disorder involves the sudden onset of at least one psychotic symptom (delusions, hallucinations, disorganized speech, or disorganized behavior). Symptoms last between one day and one month, followed by a full return to the premorbid level of functioning. This patient's two-month duration of symptoms and prominent mood features (decreased need for sleep, pressured speech) make this diagnosis unlikely.
Choice C: Delusional disorder is characterized by the presence of one or more delusions for at least one month without other prominent psychotic symptoms. Functioning is typically not markedly impaired outside the direct impact of the delusion. This patient's auditory hallucinations, pressured speech, loose associations, and decreased need for sleep make delusional disorder unlikely.
Choice D: Psychotic disorder due to a general medical condition features prominent hallucinations or delusions that are the direct pathophysiological consequence of another somatic illness, such as a brain tumor, central nervous system infection, or autoimmune encephalitis. This patient's lack of focal neurologic deficits, classic manic symptoms, and previously healthy status make a primary medical etiology unlikely.
Choice E: Schizophrenia is a chronic psychiatric disorder requiring at least two active-phase symptoms (delusions, hallucinations, disorganized speech, or negative symptoms) for at least one month, with continuous signs of disturbance for at least six months. This patient's two-month symptom duration and prominent manic syndrome (pressured speech, decreased sleep need) make schizophrenia unlikely.
Video Review: Schizophrenia
Block 1, Question 16
Correct Answer: B. BExplanation
This 63-year-old woman with chronic indigestion and heartburn undergoes gastric pH monitoring after receiving cimetidine and omeprazole. Cimetidine is a histamine H2-receptor antagonist with a rapid onset and shorter duration of action, corresponding to a quick, transient rise in gastric pH. Omeprazole is a proton pump inhibitor with a slower onset but a sustained, robust increase in pH, making the correct curve pairing B.
Cimetidine acts as a reversible competitive antagonist at histamine H2 receptors on the basolateral membrane of gastric parietal cells. This mechanism provides a rapid onset of action, quickly decreasing acid secretion and raising gastric pH. However, because it is reversible and has a relatively short half-life, the pH drops back down rapidly, as seen in curve B. In contrast, omeprazole is a prodrug that undergoes activation in the acidic secretory canaliculi of parietal cells. The active form binds covalently to the H+/K+ ATPase pump, causing irreversible inhibition of the final common pathway of gastric acid secretion.
While both medication classes effectively treat gastroesophageal reflux disease, their adverse effect profiles differ significantly. Cimetidine is notorious for being a potent CYP450 inhibitor, which increases the serum concentrations of drugs like warfarin, theophylline, and phenytoin. It also exerts antiandrogenic effects by blocking androgen receptors and increasing prolactin levels, potentially causing gynecomastia, impotence, and galactorrhea in patients. Proton pump inhibitors like omeprazole are generally well-tolerated but carry long-term risks due to profound acid suppression. Chronic use decreases the absorption of calcium and magnesium, increasing the risk of osteoporotic fractures and potentially leading to hypomagnesemia.

Why the Other Choices Are Wrong
- H2-receptor antagonists like cimetidine produce a rapid but transient increase in gastric pH due to reversible competitive inhibition.
- Proton pump inhibitors like omeprazole produce a delayed but sustained increase in gastric pH due to irreversible inhibition of the H+/K+ ATPase pump.
Choice A: Choice A incorrectly pairs cimetidine with Curve A and omeprazole with Curve D. Curve D represents a rapid decrease in gastric pH, characteristic of acid secretagogues like pentagastrin or bethanechol. These agents stimulate parietal cells to rapidly secrete hydrochloric acid. This patient's receipt of omeprazole, an irreversible proton pump inhibitor that raises pH, makes a curve demonstrating increased acid production unlikely.
Choice C: Choice C incorrectly pairs cimetidine with Curve B and omeprazole with Curve D. Curve D illustrates a rapid and sustained drop in gastric pH. Agents that lower gastric pH include cholinergic agonists or synthetic gastrin analogs, which directly stimulate acid secretion. This patient's administration of omeprazole, which profoundly suppresses acid secretion and raises pH, makes an acidifying curve unlikely.
Choice D: Choice D incorrectly pairs cimetidine with Curve C and omeprazole with Curve A. Curve C demonstrates a rapid, sustained increase in gastric pH. This pattern might be seen with a theoretical irreversible H2-receptor antagonist or a massive dose of a long-lasting antacid. This patient's receipt of cimetidine, which has a short duration of action, makes a sustained plateau curve unlikely.
Choice E: Choice E incorrectly pairs cimetidine with Curve C and omeprazole with Curve D. Curve C shows a rapid, sustained pH increase, while Curve D shows a rapid pH decrease. These curves correspond to a theoretical rapid-acting irreversible suppressor and a potent acid secretagogue, respectively. This patient's use of cimetidine and omeprazole, which produce transient and delayed pH rises, makes this combination unlikely.
Choice F: Choice F incorrectly pairs cimetidine with Curve D and omeprazole with Curve A. Curve D represents a rapid decrease in gastric pH. A sharp drop in pH is characteristic of gastric acid secretagogues like bethanechol or pentagastrin, which stimulate parietal cell acid production. This patient's administration of cimetidine, which raises gastric pH by blocking histamine receptors, makes an acidifying curve unlikely.
Video Review: Proton Pump Inhibitors and H2 Antagonists
Block 1, Question 17
Correct Answer: B. Inferior vena cavaExplanation
This 65-year-old woman presents with fatigue and new hepatic and pulmonary masses one year after a right colon resection for stage III colon cancer. Her presentation indicates metastatic spread from the primary midgut malignancy to the liver via the portal venous system, followed by subsequent hematogenous dissemination to the lungs through the inferior vena cava.
The venous drainage of the gastrointestinal tract dictates the predictable pattern of hematogenous metastasis for enteric malignancies. The right colon, which includes the cecum and ascending colon, drains via the superior mesenteric vein. This vessel joins the splenic vein to form the portal vein, making the liver the most common initial site of distant spread for colorectal carcinomas. Once tumor cells establish secondary tumors in the hepatic parenchyma, they can invade the hepatic veins. These vessels drain directly into the systemic venous circulation, allowing malignant cells to travel toward the cardiopulmonary system.
From the hepatic veins, blood flows into the inferior vena cava, which empties into the right atrium. Tumor emboli then pass through the right ventricle and enter the pulmonary circulation, eventually lodging in the pulmonary capillary bed to form lung metastases. This explains the sequential liver-to-lung spread seen in this patient. In contrast, malignancies of the distal rectum bypass the portal system entirely. The inferior rectal vein drains directly into the systemic circulation via the internal iliac vein, meaning distal rectal cancers frequently metastasize to the lungs without prior liver involvement.
Key TakeawayWhy the Other Choices Are Wrong
- Right-sided colon cancers metastasize to the liver via the superior mesenteric and portal veins.
- Subsequent spread to the lungs occurs when tumor cells enter the hepatic veins, travel up the inferior vena cava, and lodge in the pulmonary capillary bed.
Choice A: The inferior mesenteric vein drains the hindgut, encompassing the descending colon, sigmoid colon, and upper rectum. It typically empties into the splenic vein before joining the portal circulation. This patient's primary malignancy was located in the right colon, which is a midgut derivative that drains via the superior mesenteric vein, making hindgut venous drainage unlikely to be involved.
Choice C: The left colic vein is a major tributary of the inferior mesenteric vein that specifically drains the descending colon and the splenic flexure. Malignancies in these regions utilize this venous pathway to reach the portal system and metastasize to the liver. This patient's history of a right colon resection indicates a primary tumor location that contradicts left-sided venous drainage.
Choice D: The middle colic artery is a branch of the superior mesenteric artery that supplies oxygenated blood to the transverse colon. While lymphatic metastasis often follows arterial supply routes, hematogenous spread of gastrointestinal malignancies occurs via venous drainage rather than arterial supply. This patient's distant metastases to the liver and lungs represent venous dissemination rather than arterial spread.
Choice E: The pulmonary veins carry oxygenated blood from the pulmonary capillaries to the left atrium for systemic distribution. Malignancies that invade the pulmonary veins typically disseminate to systemic organs such as the brain, bone, or adrenal glands. This patient's tumor emboli arrived at the lungs from the systemic venous circulation via the pulmonary arteries, not the pulmonary veins.
Choice F: The superior mesenteric artery arises from the abdominal aorta and provides the primary arterial blood supply to midgut structures, including the distal duodenum, jejunum, ileum, and right colon. Hematogenous metastasis from gastrointestinal tumors relies on venous outflow rather than arterial inflow. This patient's distant spread to the liver and lungs involves venous pathways rather than arterial vessels.
Choice G: The superior vena cava drains deoxygenated blood from the head, neck, upper extremities, and upper thorax into the right atrium. Malignancies originating in these superior regions, or those invading the azygos venous system, can utilize this pathway for pulmonary metastasis. This patient's gastrointestinal malignancy and subsequent hepatic metastases necessitate spread through the inferior venous circulation instead.
Video Review: Colorectal Cancer
Block 1, Question 18
Correct Answer: E. ScabiesExplanation
This 4-year-old boy presents with a 3-week history of severe pruritus and a rash characterized by short, elevated serpiginous tracks with terminal vesicles in the axillae, interdigital web spaces, waistline, and inner thighs. The presence of these intensely pruritic epidermal burrows in classic flexural and interdigital distributions is highly characteristic of an infestation with scabies.
Scabies is a highly contagious ectoparasitic skin infection caused by the Sarcoptes scabiei mite. Transmission typically occurs through direct, prolonged skin-to-skin contact, making it common in crowded environments like daycares. The female mite burrows into the stratum corneum to lay eggs and deposit feces. The characteristic intense, progressively worsening pruritus is not caused directly by the mite's bite, but rather by a delayed type IV hypersensitivity reaction to the mite, its eggs, and its excrement. This explains why symptoms often take three to six weeks to develop following a primary infestation.
Diagnosis is primarily clinical based on the classic distribution of burrows, but can be confirmed by visualizing mites or eggs via microscopic examination of a skin scraping. The first-line treatment is topical permethrin cream, which acts by disrupting the voltage-gated sodium channels of the parasite, leading to paralysis. Oral ivermectin is an alternative for severe or crusted presentations. Because intense scratching compromises the skin barrier, patients are at high risk for secondary bacterial infections, most notably impetigo caused by Staphylococcus aureus or Streptococcus pyogenes. Environmental control, including washing all clothing and bedding in hot water, is essential.
Key TakeawayWhy the Other Choices Are Wrong
- Scabies is an intensely pruritic infestation characterized by serpiginous epidermal burrows in the interdigital web spaces, axillae, and groin.
- The severe pruritus is a delayed type IV hypersensitivity reaction to the mite, and first-line treatment is topical permethrin.
Choice A: Chickenpox (varicella-zoster virus) is a highly contagious viral infection. It classically presents with a prodrome of fever and malaise followed by a generalized, pruritic vesicular rash that erupts in successive crops, resulting in lesions at various stages of healing (macules, papules, vesicles, and crusts). This patient's lack of systemic symptoms and the presence of serpiginous epidermal burrows rather than diffuse, grouped vesicles make chickenpox unlikely.
Choice B: Ehrlichiosis is a tick-borne bacterial infection caused by Ehrlichia chaffeensis, which infects monocytes. It typically presents with acute febrile illness, headache, myalgias, and sometimes a maculopapular or petechial rash, along with laboratory findings of leukopenia, thrombocytopenia, and elevated transaminases. This patient's isolated, intensely pruritic serpiginous tracks and absence of fever or systemic illness make ehrlichiosis unlikely.
Choice C: Lyme disease is a tick-borne illness caused by the spirochete Borrelia burgdorferi. The hallmark early localized cutaneous manifestation is erythema migrans, a slowly expanding erythematous macule or papule that often develops central clearing to form a targetoid appearance. This patient's intensely itchy, short serpiginous tracks in the interdigital spaces and flexural areas make Lyme disease unlikely.
Choice D: Pediculosis (lice infestation) is caused by ectoparasites that feed on human blood and lay eggs on hair shafts. Head lice cause severe scalp pruritus, while body lice cause pruritus on the trunk with visible excoriations. This patient's serpiginous tracks in the webbed spaces of the hands and axillae make pediculosis unlikely, as lice do not burrow into the epidermis.
Video Review: Sarcoptes
Block 1, Question 19
Correct Answer: E. Overload of unconjugated bilirubinExplanation
This 18-year-old woman presents with severe right upper quadrant abdominal pain radiating to the right shoulder and nausea following a high-fat meal. Her history of sickle cell disease and ultrasonography confirming gallstones strongly suggest symptomatic cholelithiasis secondary to pigmented stones. The chronic hemolysis associated with her underlying hematologic condition leads to an overload of unconjugated bilirubin.
Sickle cell disease is characterized by chronic extravascular hemolysis due to the destruction of abnormally shaped erythrocytes by splenic macrophages. This continuous red blood cell breakdown generates excessive amounts of heme, which is metabolized into unconjugated bilirubin. Although the liver conjugates this pigment for biliary excretion, the sheer volume overwhelms the system, leading to high concentrations of bilirubin in the bile. When unconjugated bilirubin binds with calcium, it precipitates to form black pigment stones. The consumption of a high-fat meal stimulates the release of cholecystokinin, which promotes gallbladder contraction and forces these stones against the cystic duct, causing biliary colic.
The characteristic radiation of this patient's pain to the right shoulder occurs due to irritation of the phrenic nerve, which shares somatic innervation pathways with the diaphragm and gallbladder peritoneum. While ultrasonography is the preferred initial imaging modality for detecting these radiopaque stones, patients with chronic hemolysis often require prophylactic cholecystectomy to prevent recurrent attacks. If a stone becomes permanently impacted in the cystic duct, it can progress to acute cholecystitis, typically presenting with fever, leukocytosis, and a positive Murphy sign. Furthermore, passage of a stone into the common bile duct risks life-threatening ascending cholangitis.

Why the Other Choices Are Wrong
- Chronic hemolysis in sickle cell disease leads to excess unconjugated bilirubin production, predisposing patients to black pigment gallstones.
- High-fat meals trigger cholecystokinin release, causing gallbladder contraction and acute biliary colic when stones obstruct the cystic duct.
Choice A: Decreased hepatic secretion of lecithin contributes to the formation of cholesterol gallstones. Lecithin is a phospholipid that normally helps solubilize cholesterol within bile micelles. When lecithin levels are low, cholesterol supersaturates and precipitates into yellow-green stones. This patient's history of sickle cell disease makes hemolysis-induced pigment stones much more likely than cholesterol stones.
Choice B: Decreased reabsorption of bile salts occurs in conditions affecting the terminal ileum, such as Crohn disease or surgical resection. Because bile salts are required to keep cholesterol dissolved in bile, their loss through the gastrointestinal tract leads to cholesterol supersaturation and stone formation. This patient's hematologic disorder points toward an entirely different mechanism of cholelithiasis.
Choice C: A high ratio of cholesterol to bile acids in bile is the primary driver of cholesterol gallstone formation. This typically occurs in states of estrogen excess, obesity, or rapid weight loss, which increase hepatic cholesterol hypersecretion or decrease bile acid synthesis. This patient lacks classic risk factors for cholesterol stones, and her sickle cell disease strongly favors pigment stones.
Choice D: Infestation with parasites secreting β-glucuronidase, such as Clonorchis sinensis or Ascaris lumbricoides, is a classic cause of brown pigment gallstones. The parasitic enzyme deconjugates bilirubin within the biliary tree, leading to precipitation. These infections typically occur in endemic regions like East Asia and present with signs of biliary obstruction, making it an unlikely etiology for this patient.
Video Review: Cholelithiasis
Block 1, Question 20
Correct Answer: D. Proto-oncogeneExplanation
This 34-year-old man presents with chronic diarrhea, a previously treated pheochromocytoma, a maternal history of a parathyroid tumor, and a neck mass identified as medullary thyroid carcinoma. His normotension indicates successful management of his prior adrenal tumor. This constellation of endocrine neoplasms indicates a diagnosis of multiple endocrine neoplasia type 2A, which is caused by a mutation in a proto-oncogene.
Multiple endocrine neoplasia type 2A is characterized by medullary thyroid carcinoma, pheochromocytoma, and primary hyperparathyroidism. The disorder is caused by a germline mutation in the RET gene, which encodes a receptor tyrosine kinase involved in cellular growth and differentiation. Unlike most inherited cancer syndromes that result from loss-of-function mutations, this condition arises from continuous, ligand-independent receptor activation. Because RET normally promotes cell proliferation, its constitutively active mutated form acts as an oncogene. This gain-of-function mutation drives the neoplastic transformation of neuroendocrine tissues and is transmitted through autosomal dominant inheritance.
Medullary thyroid carcinoma is typically the first manifestation of this syndrome and arises from the parafollicular C cells of the thyroid gland. These neuroendocrine cells secrete excess calcitonin, which causes secretory diarrhea and flushing, explaining this patient's gastrointestinal symptoms. Histologic examination characteristically reveals nests of polygonal cells within an amyloid stroma derived from the altered hormone. Because of the high penetrance and aggressive nature of this malignancy, patients identified with a known RET mutation should undergo a prophylactic thyroidectomy early in life to prevent metastatic disease.
Key TakeawayWhy the Other Choices Are Wrong
- Multiple endocrine neoplasia type 2A classically presents with medullary thyroid carcinoma, pheochromocytoma, and primary hyperparathyroidism.
- The syndrome is caused by a gain-of-function mutation in the RET proto-oncogene, which encodes a receptor tyrosine kinase.
Choice A: Cell cycle regulation genes control the progression of cells through the cell cycle, and mutations can lead to unchecked proliferation. Cyclin-dependent kinase inhibitor 2A (CDKN2A) is a classic example, with loss-of-function mutations predisposing individuals to familial atypical multiple mole melanoma syndrome and pancreatic cancer. This patient's lack of cutaneous melanomas and presence of an endocrine neoplasm triad make a cell cycle regulation gene mutation unlikely.
Choice B: DNA mismatch repair genes encode proteins that correct errors occurring during DNA replication. Germline mutations in these genes, such as MLH1 and MSH2, cause Lynch syndrome, which classically presents with early-onset colorectal, endometrial, and ovarian cancers. This patient's lack of primary gastrointestinal malignancies and presence of a parafollicular cell neoplasm make a DNA mismatch repair gene mutation unlikely.
Choice C: Metastasis suppressor genes encode proteins that slow or prevent the spread of tumor cells to distant organs without affecting the primary tumor growth. Examples include NM23, which is often downregulated in metastatic breast and colon cancers. This patient's presentation of a newly diagnosed primary neuroendocrine neoplasm rather than widespread metastatic disease makes a metastasis suppressor gene mutation unlikely.
Choice E: Tumor suppressor genes encode proteins that normally inhibit cell proliferation or promote apoptosis, requiring a two-hit loss-of-function mutation for tumorigenesis. Multiple endocrine neoplasia type 1 is caused by a mutation in the MEN1 tumor suppressor gene, presenting with parathyroid, pituitary, and pancreatic tumors. This patient's parafollicular cell neoplasm and history of an adrenal tumor, rather than pituitary or pancreatic masses, make a tumor suppressor gene mutation unlikely.
Video Review: Thyroid Malignancies
Block 2, Question 1
Correct Answer: A. Central activation of neuronsExplanation
This 6-year-old girl presents with early onset of secondary sexual characteristics (thelarche, pubarche) and vaginal bleeding accompanied by elevated gonadotropins and sex steroids. The presence of high follicle-stimulating hormone and luteinizing hormone driving elevated estradiol and testosterone indicates early maturation of the hypothalamic-pituitary-gonadal axis, which is driven by central activation of neurons.
Precocious puberty is defined as secondary sexual development before age 8 in girls. It is classified into central (gonadotropin-dependent) and peripheral (gonadotropin-independent) forms. In central precocious puberty, early pulsatile release of gonadotropin-releasing hormone from the hypothalamus stimulates the anterior pituitary to secrete FSH and LH. These gonadotropins subsequently activate the gonads to produce sex steroids, leading to premature physical maturation. A key diagnostic feature of this central etiology is an elevated basal or stimulated LH level, distinguishing it from peripheral causes where gonadotropins are suppressed via negative feedback. Most cases in girls are idiopathic, though CNS lesions must be ruled out.
Evaluation of central precocious puberty requires magnetic resonance imaging of the brain to exclude hypothalamic hamartomas or other intracranial tumors. Because premature sex steroid secretion accelerates skeletal maturation and causes early epiphyseal closure, affected children often have an initial growth spurt but ultimately suffer from short adult stature. This patient's normal height and weight percentiles suggest early disease before significant bone age advancement. Treatment involves continuous administration of leuprolide, which downregulates pituitary receptors and halts pubertal progression. Her normal TSH and ACTH levels appropriately rule out primary hypothyroidism and adrenal etiologies, respectively.
Key TakeawayWhy the Other Choices Are Wrong
- Central precocious puberty is driven by early pulsatile GnRH release, resulting in elevated FSH, LH, and sex steroids.
- Diagnosis requires differentiating central (elevated LH) from peripheral (suppressed LH) causes, followed by brain imaging to rule out CNS lesions.
Choice B: Ectopic prolactin secretion typically arises from paraneoplastic syndromes or pituitary adenomas (prolactinomas). Hyperprolactinemia classically presents with galactorrhea, amenorrhea, and suppression of the hypothalamic-pituitary-gonadal axis due to inhibition of pulsatile GnRH release. This patient's elevated FSH, LH, and estradiol levels, along with the absence of galactorrhea, make ectopic prolactin secretion unlikely.
Choice C: Exogenous sex steroid exposure occurs through accidental ingestion or topical contact with estrogen or androgen formulations. Peripheral precocious puberty driven by exogenous hormones presents with rapid development of secondary sexual characteristics, but the high circulating sex steroids suppress pituitary gonadotropin release. This patient's elevated FSH and LH levels indicate a gonadotropin-dependent process, which makes exogenous sex steroid exposure unlikely.
Choice D: Germline GNAS activating mutations cause McCune-Albright syndrome, a disorder of G-protein signaling. This syndrome classically presents with the triad of peripheral precocious puberty, irregular café-au-lait macules, and polyostotic fibrous dysplasia. The autonomous ovarian cyst production of estrogen suppresses central gonadotropins. This patient's lack of characteristic skin or bone findings, combined with her elevated FSH and LH levels, make a GNAS activating mutation unlikely.
Choice E: 21-Hydroxylase deficiency is the most common cause of congenital adrenal hyperplasia. This condition shunts steroidogenesis toward androgen production, classically presenting with virilization, salt-wasting (hyponatremia, hyperkalemia), and elevated ACTH due to absent cortisol negative feedback. This patient's normal ACTH level, elevated estradiol, and elevated gonadotropins (FSH and LH) make 21-hydroxylase deficiency unlikely.
Video Review: Anterior and Posterior Pituitary
Block 2, Question 2
Correct Answer: E. Nondisjunction of X chromosome during meiosisExplanation
This 16-year-old boy presents with delayed puberty, tall stature with long extremities, gynecomastia, and small testes. Laboratory studies reveal primary hypogonadism with low testosterone and compensatory elevations in follicle-stimulating hormone and luteinizing hormone, while a normal TSH rules out thyroid-related developmental delays. These findings are diagnostic of Klinefelter syndrome, caused by nondisjunction of X chromosome during meiosis.
Klinefelter syndrome is the most common congenital cause of primary hypogonadism in males, typically resulting from a 47,XXY karyotype. The extra X chromosome leads to progressive destruction and hyalinization of the seminiferous tubules, which causes profound testicular atrophy. This destruction impairs Sertoli cell function, leading to decreased inhibin B production and a subsequent loss of negative feedback on the anterior pituitary, resulting in markedly elevated follicle-stimulating hormone. Additionally, Leydig cell dysfunction causes decreased testosterone production, which triggers a compensatory rise in luteinizing hormone. The resulting high estrogen-to-testosterone ratio drives the development of gynecomastia and eunuchoid skeletal proportions.
Patients with this condition face an increased risk of several long-term complications, notably breast cancer and extragonadal germ cell tumors. Due to the progressive nature of testicular fibrosis, nearly all affected individuals experience azoospermia and subsequent infertility, though advanced reproductive technologies can sometimes extract viable sperm if performed early in adulthood. Management centers on lifelong testosterone replacement therapy, which promotes secondary sexual characteristics, improves muscle mass, and prevents osteoporosis. Additionally, these patients often experience mild cognitive deficits, particularly in language development and executive functioning, requiring early educational interventions.

Why the Other Choices Are Wrong
- Klinefelter syndrome (47,XXY) is caused by meiotic nondisjunction and presents with tall stature, gynecomastia, and small, firm testes.
- Laboratory evaluation classically reveals primary hypergonadotropic hypogonadism with low testosterone and elevated follicle-stimulating hormone and luteinizing hormone.
Choice A: Constitutional delay in puberty is a transient, often familial condition characterized by a late onset of pubertal development. Patients typically present with short stature, delayed bone age, and temporarily low levels of gonadotropins and sex steroids that eventually normalize. This patient's markedly elevated follicle-stimulating hormone and luteinizing hormone levels make a transient constitutional delay unlikely.
Choice B: Hypoplasia of hypothalamic gonadotropin-releasing hormone neurons describes Kallmann syndrome, a genetic disorder of olfactory and neuronal migration. Affected individuals classically present with delayed puberty, anosmia, and hypogonadotropic hypogonadism featuring low gonadotropin levels. This patient's elevated follicle-stimulating hormone and luteinizing hormone levels indicate primary testicular failure, making a central hypothalamic defect unlikely.
Choice C: Inactivating mutation of the follicle-stimulating hormone-receptor causes isolated follicle-stimulating hormone resistance. Affected males typically have normal Leydig cell function, resulting in normal testosterone and luteinizing hormone levels, but exhibit varying degrees of oligospermia due to impaired Sertoli cell stimulation. This patient's profoundly low testosterone and elevated luteinizing hormone levels make this isolated receptor mutation unlikely.
Choice D: Mutation in the 21-hydroxylase gene is the most common cause of congenital adrenal hyperplasia. Patients with nonclassic forms can present in adolescence with early pubarche, accelerated growth, and advanced bone age due to excess adrenal androgens. This patient's delayed puberty, small testes, and low serum testosterone levels make an androgen-excess condition unlikely.
Video Review: High Yield Genetic Disorders
Block 2, Question 3
Correct Answer: B. AldosteroneExplanation
This newborn girl presents with listlessness, poor feeding, ambiguous genitalia, hyponatremia, and metabolic acidosis. These findings in a neonate born to an unmonitored mother indicate classic salt-wasting congenital adrenal hyperplasia due to 21-hydroxylase deficiency. Management requires immediate glucocorticoid and mineralocorticoid replacement, making the most appropriate pharmacotherapy a drug that targets aldosterone.
Congenital adrenal hyperplasia is most commonly caused by an autosomal recessive defect in the 21-hydroxylase enzyme. This deficiency impairs the synthesis of both cortisol and aldosterone in the adrenal cortex. The lack of cortisol removes negative feedback on the pituitary, leading to elevated adrenocorticotropic hormone and subsequent adrenal hyperplasia. Shunting of steroid precursors into the androgen pathway causes virilization of female infants, resulting in ambiguous genitalia. The concurrent lack of aldosterone leads to renal sodium loss and potassium retention, presenting as hypovolemia, hyponatremia, and hyperkalemia. Treatment requires lifelong mineralocorticoid replacement with fludrocortisone to restore intravascular volume, alongside hydrocortisone to replace cortisol.
Diagnosis of this condition is typically established through newborn screening, which detects elevated levels of 17-hydroxyprogesterone, the direct precursor to the defective enzyme. During times of physiological stress, such as infection or surgery, patients require stress-dose glucocorticoids to prevent life-threatening cardiovascular collapse and severe hypoglycemia. Furthermore, female patients with ambiguous genitalia may require surgical evaluation, but assigning a sex of rearing involves a multidisciplinary approach focusing on the underlying 46,XX karyotype and long-term functional outcomes.
Key TakeawayWhy the Other Choices Are Wrong
- Classic salt-wasting congenital adrenal hyperplasia presents in neonates with ambiguous genitalia, hyponatremia, and hyperkalemia due to 21-hydroxylase deficiency.
- Acute management requires restoring intravascular volume and replacing both glucocorticoids and mineralocorticoids.
Choice A: Adrenocorticotropic hormone (ACTH) analogs, such as cosyntropin, are used to diagnose adrenal insufficiency. Administration of exogenous ACTH normally stimulates the adrenal glands to produce cortisol, which can be measured to differentiate primary from secondary adrenal insufficiency. This patient's ambiguous genitalia and hyponatremia indicate an enzymatic block in steroidogenesis, meaning the adrenal glands cannot produce cortisol even if stimulated by ACTH.
Choice C: Androgen receptor agonists, such as testosterone, are utilized for hormone replacement in primary or secondary hypogonadism. These medications promote the development of male secondary sexual characteristics, increase muscle mass, and support bone density in patients with deficient endogenous production. This patient's ambiguous genitalia is caused by an excess of endogenous androgens due to precursor shunting; administering additional androgens would worsen virilization.
Choice D: Gonadotropin-releasing hormone (GnRH) analogs are administered continuously to suppress the gonadal axis. Continuous administration downregulates pituitary GnRH receptors, decreasing gonadotropins, which is useful in treating precocious puberty or prostate cancer. This patient's virilization is driven by adrenal androgen overproduction independent of the hypothalamic-pituitary-gonadal axis, making GnRH modulation useless for addressing the ambiguous genitalia or the acute electrolyte derangements.
Choice E: Growth hormone receptor agonists, such as somatropin, are indicated for pediatric growth failure due to growth hormone deficiency or Turner syndrome. These agents stimulate the production of insulin-like growth factor 1, promoting linear bone growth, increasing muscle mass, and altering lipid metabolism. This patient's listlessness and poor feeding are driven by an acute adrenal crisis, not a primary growth disorder, making growth hormone therapy inappropriate.
Video Review: Adrenal Glands
Block 2, Question 4
Correct Answer: C. Pericardial friction rubExplanation
This 59-year-old man presents with progressive chronic kidney disease and laboratory evidence of severe renal impairment, including markedly elevated blood urea nitrogen and creatinine levels. These findings indicate advanced uremia, a state of retained nitrogenous waste products that can lead to life-threatening complications requiring urgent renal replacement therapy, such as the development of a pericardial friction rub, which indicates pericarditis.
The primary indications for urgent hemodialysis include severe acidemia, refractory electrolyte abnormalities like hyperkalemia, dialyzable intoxications, volume overload refractory to medical management, and symptomatic uremia. Uremia typically manifests clinically when blood urea nitrogen levels exceed 60 mg/dL, causing systemic toxicity. One of the most severe manifestations is uremic pericarditis, an inflammatory condition of the pericardial sac. On physical examination, this classically produces a high-pitched, scratchy sound representing the inflamed visceral and parietal pericardial layers rubbing against each other, which serves as an absolute indication for the immediate initiation of renal replacement therapy.
Beyond pericardial inflammation, severe nitrogenous waste accumulation can precipitate uremic encephalopathy, which presents with altered mental status, asterixis, and potentially fatal seizures. When evaluating a patient with suspected renal failure-associated pericarditis, an electrocardiogram is a critical diagnostic step. Unlike viral or idiopathic etiologies, uremic pericardial inflammation rarely penetrates the underlying myocardium. Consequently, the classic electrocardiographic finding of diffuse ST-segment elevation is typically absent in these patients. Because the condition results directly from retained toxins rather than primary inflammation, standard therapies like nonsteroidal anti-inflammatory drugs or colchicine are ineffective, making hemodialysis the only definitive, life-saving intervention.

Why the Other Choices Are Wrong
- Urgent indications for hemodialysis include severe acidemia, refractory hyperkalemia, dialyzable intoxications, volume overload refractory to medical management, and symptomatic uremia (AEIOU).
- Uremic pericarditis, manifesting as a pericardial friction rub, is an absolute indication for immediate hemodialysis.
Choice A: Increasingly severe anemia is a common complication of chronic kidney disease due to decreased erythropoietin production. Patients develop a normocytic, normochromic anemia that worsens as functional renal mass declines, leading to fatigue, pallor, and decreased exercise tolerance. Although this patient's deteriorating renal function likely contributes to anemia, this condition is managed with erythropoiesis-stimulating agents and iron supplementation, not immediate hemodialysis.
Choice B: Moderate pedal edema represents peripheral fluid accumulation due to decreased glomerular filtration and subsequent sodium and water retention. Chronic kidney disease frequently causes dependent edema, which can progress to anasarca. While refractory pulmonary edema is an indication for urgent dialysis, this patient's hypothetical moderate peripheral edema would be initially managed with loop diuretics and sodium restriction rather than immediate renal replacement therapy.
Choice D: Persistent hypertension despite medication use describes resistant hypertension, a nearly universal finding in advanced renal failure. The pathogenesis involves volume expansion from impaired sodium excretion and inappropriate activation of the renin-angiotensin-aldosterone system due to localized renal ischemia. While this patient's progressive renal deterioration makes blood pressure control difficult, resistant hypertension is managed by optimizing multidrug antihypertensive regimens and volume status, not by initiating emergent hemodialysis.
Choice E: Recurrent episodes of hypoglycemia can occur in advanced diabetic nephropathy due to decreased renal clearance of insulin and oral hypoglycemic agents. The kidneys normally degrade roughly one-third of circulating insulin, so progressive renal impairment prolongs the half-life of these medications. Although this patient's type 2 diabetes and failing kidneys increase this risk, this complication is managed by adjusting hypoglycemic medications, not with immediate hemodialysis.
Video Review: Chronic Kidney Disease
Block 2, Question 5
Correct Answer: C. W -> ZExplanation
This 65-year-old woman presents with acute chest and arm pain, jugular venous distention, and pulmonary crackles alongside anterolateral ST-segment elevations and elevated troponin I, indicating an acute myocardial infarction complicated by acute heart failure. The initial ischemic insult causes an immediate reduction in myocardial contractility and, subsequently, an increase in end-diastolic volume (EDV) as beat-to-beat stroke volume diminishes, represented on the Frank-Starling curve by a shift from W -> Z.
The Frank-Starling relationship dictates that cardiac output is proportional to initial myocardial fiber stretch, represented by ventricular EDV. Each curve on the graph represents a specific level of intrinsic contractility (inotropy); a higher curve means greater cardiac output for any given preload. Acute myocardial ischemia causes rapid depletion of cellular ATP, leading to immediate failure of the actin-myosin cross-bridge cycling required for normal contraction. This results in profound systolic dysfunction within seconds of the ischemic insult, shifting the ventricular function curve downward. Over the next few cardiac cycles within those initial seconds, the impaired ejection results in a slightly increased residual end-systolic volume, which translates to a modest increase in EDV as blood accumulates in the ventricle. The net effect is a shift from point W to point Z—predominantly downward (decreased contractility) with a slight rightward shift (early volume accumulation).
Following these initial shifts, the reduced forward flow causes blood to back up into the pulmonary and systemic circulations, progressively increasing preload. This elevated hydrostatic pressure produces the clinical signs of pulmonary edema (crackles) and right-sided volume overload (jugular venous distention). The anterolateral ST-segment elevations and new Q waves localize the infarction to the territory of the left anterior descending artery or left circumflex artery. Without rapid reperfusion, this profound pump failure progresses with further ventricular dilation and continued decline in cardiac output, ultimately resulting in irreversible cardiogenic shock, characterized by severe end-organ hypoperfusion, lactic acidosis, and hemodynamic collapse.

Why the Other Choices Are Wrong
- Acute myocardial ischemia causes an immediate downward shift of the Frank-Starling curve due to a rapid loss of contractility.
- Impaired contractility reduces stroke volume, leaving unejected residual blood in the ventricle, while normal venous return adds to this volume, raising end-diastolic volume beat by beat.
Choice A: W -> X represents a drop to a lower Frank-Starling curve at approximately the same EDV—a pure decrease in contractility with no change in preload. While the drop in contractility is correct, this ignores the immediate beat-to-beat volume accumulation. When the ventricle fails to eject fully, residual volume remains, and the next diastolic filling adds to it. EDV therefore rises within seconds, not just over hours via neurohormonal mechanisms.
Choice B: W -> Y represents a rightward shift along the normal ventricular function curve. This change reflects an isolated increase in preload (end-diastolic volume) with preserved myocardial contractility, such as following a rapid intravenous infusion of normal saline. This patient's elevated troponin I and anterolateral ST-segment elevations indicate acute myocardial injury, which would depress the curve rather than maintain it.
Choice D: X -> W represents a shift from a low-contractility state to a higher-contractility state, indicating an improvement in cardiac function. This is the opposite of what happens during an acute MI. This transition might represent successful treatment with positive inotropes (eg, dobutamine), restoring the heart to a more favorable position on a higher Starling curve; however, it does not describe the initial ischemic insult.
Choice E: X -> Y represents a direct upward shift from a depressed ventricular function curve to a normal curve at an elevated end-diastolic volume. This change reflects an acute increase in contractility in a volume-overloaded state, such as administering a positive inotropic agent to a patient in cardiogenic shock. This patient's acute myocardial infarction would decrease contractility, not increase it.
Choice F: X -> Z illustrates an isolated increase in EDV along a depressed cardiac function curve. This may represent volume optimization in a preload-dependent patient with a primary cardiac insult; however, it is inconsistent with the acute deterioration of an acute myocardial infarction.
Choice G: Z -> W represents a shift to a higher contractility curve with decreased EDV. This describes the ideal therapeutic response in severe heart failure: an inotrope increases contractility while a diuretic reduces volume overload, moving the patient from a congested, low-output state (Z) back toward normal function (W). It is the reverse of the acute pathophysiology described here.
Choice H: Z -> X represents a decrease in EDV along a reduced cardiac function curve. This may occur in a patient with underlying cardiac pathology who experiences volume loss through overdiuresis. In acute myocardial infarction, preload increases from residual volume accumulation.
Choice I: Z -> Y represents an upward shift to a normal ventricular function curve combined with a rightward shift indicating increased end-diastolic volume. This change reflects simultaneous increases in both contractility and preload, such as during intense aerobic exercise or following administration of intravenous fluids and a positive inotrope. This patient's acute ischemic injury makes an increase in contractility impossible.
Video Review: Myocardial Infarction
Block 2, Question 6
Correct Answer: E. SpleenExplanation
This 25-year-old man presents with confusion, tachycardia, hypotension, and cold, clammy skin following a gunshot wound to the left posterior 10th intercostal space. His clinical signs indicate early hypovolemic shock from acute hemorrhage, and the abdominal CT scan confirms a metallic projectile lodged in the left upper quadrant organ located posterior and lateral to the stomach, which is the spleen.
The spleen is an intraperitoneal lymphoid organ situated in the left upper quadrant of the abdomen. It lies deep to the left 9th, 10th, and 11th ribs, making it highly vulnerable to penetrating trauma in the lower left thorax or upper left abdomen. On axial imaging, it is positioned posterior and lateral to the stomach and superior to the left kidney. Because it is a highly vascular organ, splenic injury frequently results in massive internal hemorrhage leading to hypovolemic shock. This manifests with compensatory sympathetic activation, producing the tachycardia and peripheral vasoconstriction seen in this patient.
Severe splenic trauma often requires surgical removal to achieve hemostasis. Following splenectomy, patients lose the primary site of IgM production and opsonization by splenic macrophages, rendering them highly susceptible to severe infections from encapsulated bacteria such as Streptococcus pneumoniae, Haemophilus influenzae, and Neisseria meningitidis. To prevent overwhelming post-splenectomy infection, these patients require targeted vaccinations against these organisms. Additionally, the loss of splenic culling function results in the appearance of Howell-Jolly bodies on peripheral blood smear, which are basophilic nuclear remnants normally removed from erythrocytes. Target cells may also be observed due to decreased membrane lipid clearance.
Key TakeawayWhy the Other Choices Are Wrong
- The spleen is located in the left upper quadrant deep to the 9th, 10th, and 11th ribs, making it highly susceptible to penetrating trauma.
- Splenic rupture causes massive internal hemorrhage leading to hypovolemic shock.
Choice A: The adrenal gland is a retroperitoneal endocrine organ located at the superior pole of each kidney. Injuries to the left adrenal gland typically occur with trauma slightly more medial and inferior to the spleen. On axial CT, it appears as an inverted Y-shaped structure medial to the spleen. This patient's CT scan shows the bullet lodged lateral to the stomach, making adrenal injury unlikely.
Choice B: The colon includes the splenic flexure, which is located in the left upper quadrant inferior to the spleen. Colonic perforation typically presents with peritonitis, marked by severe abdominal pain, rigidity, and rebound tenderness, along with free air under the diaphragm on imaging. This patient's CT scan shows the bullet in a solid organ rather than a hollow viscus, making colonic involvement unlikely.
Choice C: The kidney is a retroperitoneal organ responsible for filtration and urine production. Left renal trauma commonly presents with flank pain, ecchymosis, and gross or microscopic hematuria. On axial CT, the left kidney is located posterior to the descending colon and inferior to the spleen. This patient's CT finding of a projectile posterior and lateral to the stomach makes a primary renal injury unlikely.
Choice D: The lung is a vital respiratory organ occupying the pleural cavities. Penetrating trauma to the left lower lung lobe typically causes pneumothorax or hemothorax, presenting with dyspnea, decreased breath sounds, and hypoxia. On CT, the lung fields appear radiolucent due to air. This patient's normal oxygen saturation and the CT showing the bullet in a solid abdominal organ make lung injury unlikely.
Video Review: Hypovolemic Shock
Block 2, Question 7
Correct Answer: C. Monoamine oxidase BExplanation
This 66-year-old man presents with persistent motor symptoms including freezing episodes, clumsy gait, and upper extremity rigidity despite ongoing carbidopa-levodopa therapy. These findings indicate "wearing-off" phenomenon and motor fluctuations associated with progressive Parkinson disease, which can be managed by adding an adjunct medication that inhibits central dopamine degradation via Monoamine oxidase B.
Levodopa is the most effective treatment for Parkinson disease, but long-term use often leads to a narrowing therapeutic window, resulting in the "freezing" episodes seen in this patient. To prolong the effects of endogenous dopamine and exogenous levodopa, adjunct therapies are used to block dopamine metabolism in the central nervous system. Monoamine oxidase B is an enzyme that selectively degrades dopamine in the striatum. Medications like selegiline and rasagiline irreversibly inhibit this enzyme, thereby increasing synaptic dopamine concentrations. This reduces the required dose of levodopa and minimizes debilitating motor fluctuations that characterize advanced Parkinson disease.
Another strategy to extend levodopa efficacy involves inhibiting catechol-O-methyltransferase, an enzyme responsible for both peripheral levodopa degradation and central dopamine breakdown. Agents like entacapone block this peripheral conversion, further increasing central levodopa availability. When utilizing monoamine oxidase B inhibitors, physicians must monitor for adverse effects related to excess dopaminergic activity, including nausea, orthostatic hypotension, and visual hallucinations. Furthermore, while these agents are relatively selective at standard doses, coadministration with serotonergic drugs like selective serotonin reuptake inhibitors requires caution due to the risk of precipitating serotonin syndrome, characterized by autonomic instability, altered mental status, and neuromuscular hyperactivity.
Key TakeawayWhy the Other Choices Are Wrong
- Motor fluctuations (e.g., freezing) in Parkinson disease can be managed by adding a monoamine oxidase B (MAO-B) inhibitor like selegiline.
- MAO-B inhibitors block the central degradation of dopamine, prolonging the effects of endogenous dopamine and exogenous levodopa.
Choice A: Aromatic L-amino acid decarboxylase converts levodopa to dopamine. Carbidopa is a peripheral inhibitor of this enzyme and is already included in this patient's regimen to prevent premature systemic levodopa breakdown. Inhibiting this enzyme centrally would prevent the conversion of levodopa to active dopamine within the brain. This patient's need to increase central dopaminergic activity makes central inhibition of this enzyme counterproductive.
Choice B: Dopamine β-hydroxylase catalyzes the conversion of dopamine to norepinephrine within catecholaminergic neurons. Deficiencies or inhibition of this enzyme lead to impaired sympathetic nervous system function, classically presenting with severe orthostatic hypotension, ptosis, and retrograde ejaculation. This patient's primary issue is a lack of central dopamine causing motor freezing, and inhibiting its conversion to norepinephrine would not alleviate these extrapyramidal symptoms.
Choice D: Phenylethanolamine N-methyltransferase is the terminal enzyme in the catecholamine synthesis pathway, responsible for converting norepinephrine to epinephrine primarily within the adrenal medulla. Epinephrine functions as a major systemic stress hormone regulating cardiovascular and metabolic responses. This patient's Parkinson disease motor fluctuations stem from nigrostriatal dopamine depletion, making an adrenal enzyme involved in systemic epinephrine synthesis irrelevant to his required treatment.
Choice E: Tyrosine hydroxylase is the rate-limiting enzyme in catecholamine biosynthesis, converting the amino acid tyrosine to dihydroxyphenylalanine (DOPA). Metyrosine inhibits this enzyme and is utilized clinically to reduce catecholamine production in patients with pheochromocytoma prior to surgery. Because this patient suffers from a neurodegenerative disease characterized by dopamine deficiency, inhibiting the initial step of endogenous dopamine synthesis would severely exacerbate his rigidity and freezing episodes.
Video Review: Basal Ganglia
Block 2, Question 8
Correct Answer: B. Muscle rigidityExplanation
This 33-year-old man presents with hyperthermia, altered mental status, and autonomic instability (tachycardia, tachypnea, hypertension) 5 days after initiating olanzapine and clonazepam. While his alcohol history raises the possibility of withdrawal, concurrent clonazepam use makes this unlikely. Instead, his profound fever and encephalopathy following dopamine antagonist exposure indicate neuroleptic malignant syndrome, which characteristically presents with muscle rigidity.
Neuroleptic malignant syndrome is a life-threatening neurologic emergency caused by central dopamine receptor blockade in the hypothalamus and nigrostriatal pathways. It is most commonly associated with high-potency typical antipsychotics like haloperidol, but atypical agents such as olanzapine can also trigger the condition. The classic tetrad includes altered mental status, autonomic instability, hyperthermia, and severe "lead-pipe" rigidity. The profound muscle contraction generates excessive heat, leading to the extreme temperatures seen in this patient. Laboratory evaluation typically reveals markedly elevated creatine kinase levels secondary to rhabdomyolysis, which can subsequently precipitate acute kidney injury due to myoglobinuria.
Management of neuroleptic malignant syndrome requires immediate discontinuation of the offending antipsychotic and aggressive supportive care, including rapid cooling and intravenous fluids to maintain renal perfusion. In severe or refractory cases, pharmacologic intervention is necessary. Dantrolene is a direct-acting muscle relaxant that inhibits calcium ion release from the sarcoplasmic reticulum, effectively reversing the severe rigidity and hyperthermia. Alternatively, dopamine agonists such as bromocriptine or amantadine can be administered to overcome the central receptor blockade. Electroconvulsive therapy may be considered for treatment-resistant cases or when the underlying psychosis remains uncontrolled after stopping antipsychotic medications.

Why the Other Choices Are Wrong
- Neuroleptic malignant syndrome presents with altered mental status, autonomic instability, hyperthermia, and "lead-pipe" muscle rigidity following antipsychotic administration.
- Management includes discontinuing the offending agent, supportive care, and administering dantrolene or bromocriptine in severe cases.
Choice A: Hyperreflexia and myoclonus are characteristic neurologic findings in serotonin syndrome, a potentially fatal condition caused by excessive serotonergic activity. Serotonin syndrome typically presents with the triad of altered mental status, autonomic hyperarousal, and neuromuscular hyperactivity (hyperreflexia, clonus, tremor), predominantly affecting the lower extremities. This patient's exposure to a dopamine antagonist rather than a serotonergic agent makes serotonin syndrome unlikely.
Choice C: Mydriasis is a classic pupillary finding in anticholinergic toxicity, which can result from intentional overdose or adverse effects of medications like tricyclic antidepressants. Anticholinergic toxidrome presents with hyperthermia, tachycardia, dry skin, decreased bowel sounds, urinary retention, and altered mental status. While olanzapine has mild anticholinergic properties, this patient's extreme hyperthermia (40.3°C) and lack of other classic anticholinergic signs make this toxidrome unlikely.
Choice D: A petechial rash is a hallmark dermatologic manifestation of meningococcal meningitis, a life-threatening bacterial infection caused by Neisseria meningitidis. Meningococcal disease presents with sudden onset of high fever, severe headache, neck stiffness, photophobia, and altered mental status, rapidly progressing to a non-blanching purpuric rash. This patient's lack of reported headache or nuchal rigidity, alongside his recent initiation of an antipsychotic, makes a medication-induced toxidrome much more likely.
Choice E: Unilateral hemiparesis is a focal neurologic deficit typically indicative of an acute ischemic or hemorrhagic stroke involving the contralateral cerebral hemisphere. Acute stroke presents with sudden-onset focal neurologic signs, such as facial droop, arm or leg weakness, aphasia, or visual field deficits. This patient's diffuse encephalopathy, extreme hyperthermia, and profound autonomic instability indicate a systemic toxic-metabolic process rather than a focal structural brain lesion.
Video Review: Typical Antipsychotics
Block 2, Question 9
Correct Answer: E. Urothelial carcinomaExplanation
This 68-year-old man presents with intermittent painless hematuria and a left renal pelvis mass in the setting of extensive tobacco use and occupational exposure to naphthylamine. Gross pathology of the resected kidney demonstrates a large, pale, exophytic, papillary tumor localized to the renal calyces. This classic triad of painless hematuria, aromatic amine exposure, and a papillary renal pelvis mass indicates urothelial carcinoma.
Urothelial carcinoma typically arises in the bladder but can occur anywhere along the urinary tract, including the renal pelvis. The pathogenesis is strongly linked to environmental exposures that undergo renal excretion, concentrating carcinogens in the urine; notably, alcohol use disorder is not a recognized risk factor. Tobacco smoke is the most significant overall risk factor, while occupational exposure to aromatic amines, such as naphthylamine used in dye industries, classically predisposes individuals to this malignancy. These tumors frequently exhibit a field defect, wherein the entire urothelium undergoes malignant transformation, leading to multifocal lesions that often recur after resection.
The gross morphological appearance of this malignancy typically features friable, exophytic growths with a distinct papillary architecture projecting into the lumen, as seen in this patient's resected kidney. Histologically, these tumors have fibrovascular cores lined by atypical transitional epithelium. Two distinct pathways drive tumor development: a low-grade papillary pathway associated with FGFR3 gene mutations, and a high-grade flat pathway characterized by early TP53 mutations. Patients characteristically present with painless hematuria, though clot formation or ureteral obstruction by the tumor mass can occasionally precipitate renal colic.
Key TakeawayWhy the Other Choices Are Wrong
- Urothelial carcinoma presents with painless hematuria and can arise anywhere along the urinary tract, including the renal pelvis.
- Major risk factors include tobacco smoking, cyclophosphamide therapy, and occupational exposure to aromatic amines like naphthylamine.
Choice A: Angiomyolipoma is a benign mesenchymal tumor composed of blood vessels, smooth muscle, and adipose tissue. It typically presents as a well-circumscribed, echogenic cortical mass on imaging and is strongly associated with tuberous sclerosis. This patient's tumor location in the renal pelvis, papillary gross appearance, and lack of characteristic fat density make angiomyolipoma unlikely.
Choice B: Metastatic melanoma is a highly aggressive skin cancer that can disseminate to virtually any organ, including the kidneys. Renal metastases typically manifest as multiple, bilateral, well-circumscribed cortical nodules that may exhibit dark pigmentation due to melanin production. This patient's solitary, pale, exophytic mass confined to the renal pelvis makes metastatic melanoma unlikely.
Choice C: Nephroblastoma, or Wilms tumor, is the most common primary renal malignancy of childhood, arising from embryonic renal cells. It classically presents in children under five years old as a large, palpable, unilateral flank mass, often accompanied by hematuria and hypertension. This patient's advanced age and occupational history make nephroblastoma unlikely.
Choice D: Oncocytoma is a benign epithelial tumor arising from the intercalated cells of the renal collecting ducts. Grossly, it presents as a well-circumscribed, mahogany-brown cortical mass with a characteristic central stellate scar. This patient's tumor is located in the renal pelvis and exhibits a pale, papillary morphology, making oncocytoma unlikely.
Video Review: Inflammatory Conditions & Malignancy
Block 2, Question 10
Correct Answer: A. Effect of alcohol on the conditionExplanation
This 37-year-old woman presents with a 3-year history of episodic facial erythema, warmth, and burning precipitated by stress, with physical examination revealing telangiectasias on the cheeks, nose, and chin. These findings indicate erythematotelangiectatic rosacea, a chronic inflammatory skin condition characterized by transient flushing that can be triggered by specific dietary factors, making it most appropriate to ask about the effect of alcohol on the condition.
The patient's clinical presentation is classic for erythematotelangiectatic rosacea, one of four major subtypes of this chronic dermatosis. The exact pathophysiology remains incompletely understood but involves an exaggerated innate immune response and vasomotor instability leading to abnormal neurovascular signaling. This dysregulation results in the characteristic transient flushing and persistent central facial erythema with telangiectasias. Aberrant processing of antimicrobial peptides, specifically elevated levels of cathelicidin, promotes local inflammation and angiogenesis. Patients typically experience exacerbations triggered by factors that induce vasodilation, including emotional stress, temperature extremes, ultraviolet light exposure, hot beverages, and certain dietary choices such as alcohol.
Beyond the flushing and telangiectasias seen in this patient, other subtypes include papulopustular rosacea, which presents with acne-like eruptions but lacks comedones, and phymatous rosacea, characterized by sebaceous gland hypertrophy and tissue thickening most commonly affecting the nose (rhinophyma). Ocular involvement can also occur, presenting with conjunctivitis, blepharitis, or recurrent chalazia. Management begins with trigger avoidance, such as limiting red wine consumption, and gentle skin care, as topical corticosteroids like hydrocortisone can paradoxically worsen symptoms over time. First-line pharmacologic therapy for inflammatory lesions includes topical metronidazole, azelaic acid, or ivermectin, while persistent erythema may respond to topical alpha-agonists like brimonidine.
Key TakeawayWhy the Other Choices Are Wrong
- Rosacea is a chronic inflammatory skin condition presenting with facial erythema, telangiectasias, and flushing.
- Exacerbations are commonly triggered by vasodilation-inducing factors, including emotional stress, temperature extremes, hot beverages, spicy foods, and alcohol consumption.
Choice B: Excessive sweating is a characteristic feature of hyperhidrosis or autonomic dysregulation. Primary focal hyperhidrosis typically presents with excessive, uncontrollable sweating of the palms, soles, or axillae due to sympathetic nervous system overactivity. Secondary hyperhidrosis can result from endocrine disorders like hypoglycemia. This patient's well-controlled type 1 diabetes and localized facial erythema with telangiectasias make a sweating disorder unlikely.
Choice C: A family history of adenomas is relevant when evaluating for multiple endocrine neoplasia type 1. This autosomal dominant syndrome includes parathyroid, pituitary, and pancreatic neuroendocrine tumors. Functioning tumors, such as VIPomas or carcinoid tumors, can cause episodic facial flushing, diarrhea, and abdominal pain. This patient's isolated facial erythema with visible telangiectasias and lack of gastrointestinal symptoms make a neuroendocrine tumor unlikely.
Choice D: Numbness of the fingers and toes is a classic symptom of peripheral neuropathy. Diabetic sensorimotor polyneuropathy typically presents with a stocking-glove distribution of sensory loss, paresthesias, and pain due to chronic microvascular damage. Autonomic neuropathy can cause vasomotor changes in the extremities. While this patient has type 1 diabetes, her symptoms are confined to the face and show classic features of rosacea, making peripheral neuropathy unlikely.
Choice E: Poor healing of skin lacerations is a hallmark of poorly controlled diabetes mellitus or hypercortisolism. Chronic hyperglycemia impairs wound healing by decreasing leukocyte function and reducing peripheral perfusion. Cushing syndrome causes poor wound healing, facial plethora, and skin thinning. Although this patient used over-the-counter hydrocortisone, her presentation of episodic facial flushing triggered by stress with telangiectasias points to rosacea rather than impaired wound healing.
Video Review: Inflammatory Diseases of the Skin
Block 2, Question 11
Correct Answer: B. Herd immunityExplanation
This 5-year-old girl presents with a history of good health for a kindergarten physical examination despite her mother consistently declining all recommended childhood immunizations. Her lack of vaccine-preventable illnesses in the absence of individual immunity is best explained by the protective effect of the immunized population surrounding her, known as herd immunity.
Herd immunity occurs when a sufficient proportion of a population becomes immune to an infectious disease, thereby limiting further pathogen transmission. This phenomenon shields susceptible individuals, such as those who are unvaccinated, immunocompromised, or too young to receive immunizations. The specific percentage of immune individuals required to achieve this community-level defense depends heavily on the basic reproduction number, which represents the average number of secondary infections produced by a single infected patient in a completely susceptible population. Highly contagious pathogens like measles require a very high herd immunity threshold to prevent outbreaks. Maintaining high community vaccination rates is essential to provide this indirect protection to vulnerable populations.
When addressing vaccine hesitancy, physicians must explore the underlying reasons for parental refusal using open-ended questions. Providers should clearly communicate the risks of remaining unvaccinated while utilizing a presumptive delivery approach, which introduces vaccination as the default standard of care rather than an optional choice. If parents continue to decline, the physician must document the discussion and may have the parent sign a vaccine refusal form to acknowledge the clinical risks. Dismissing patients from a pediatric practice solely due to vaccination status is generally discouraged by professional guidelines. Maintaining a strong therapeutic alliance allows for ongoing education, regular well-child care, and future opportunities to immunize the child.
Key TakeawayWhy the Other Choices Are Wrong
- Herd immunity provides indirect protection to unvaccinated individuals when a sufficiently high proportion of the surrounding population is immunized against a specific pathogen.
- Physicians should address vaccine hesitancy using a presumptive delivery approach while maintaining a strong therapeutic alliance.
Choice A: Community eradication of vaccine-preventable disease refers to the complete elimination of a pathogen's incidence within a specific geographic area. True eradication requires global coordination and has currently only been achieved for smallpox. While regional elimination of certain diseases exists, pathogens still circulate globally. This patient's lack of illness is not due to eradication, as diseases like pertussis remain endemic in most communities.
Choice C: Lingering protection of maternal antibodies provides passive immunity to neonates through transplacental IgG transfer and secretory IgA in breast milk. This passive immunity is crucial for protecting infants before their adaptive immune system matures. However, maternally derived IgG antibodies naturally degrade, typically waning completely by six to twelve months of age. This patient's age of 5 years makes lingering maternal antibodies an impossible explanation for her current protection.
Choice D: A normal immune system is essential for mounting an effective response to pathogens. An intact adaptive immune system allows a child to generate specific antibodies upon encountering a novel antigen. However, a primary infection must occur first to develop immunologic memory, typically causing symptomatic illness. This patient's normal physical examination suggests immune competence, but a normal immune system alone does not prevent the initial acquisition of contagious illnesses.
Choice E: Underdiagnosis of vaccine-preventable conditions occurs when a patient contracts an illness that goes unrecognized by caregivers. This can happen with mild or subclinical infections. However, many classic childhood vaccine-preventable diseases, such as measles or pertussis, present with highly distinct and recognizable clinical syndromes that prompt medical evaluation. This patient's mother explicitly reports no history of such illnesses, making underdiagnosis highly unlikely given their typical symptomatic severity.
Video Review: Vaccinations
Block 2, Question 12
Correct Answer: A. Binding to the D antigen on fetal erythrocytesExplanation
This 28-year-old pregnant woman presents with a history of being blood group A, Rh-negative with an Rh-positive husband, and an indirect Coombs titer of 1:32 following her first delivery. These findings indicate maternal Rh alloimmunization, a condition that can be prevented in unsensitized at-risk pregnancies through the administration of Rh(D) immune globulin, which works by binding to the D antigen on fetal erythrocytes.
Rh(D) immune globulin consists of IgG anti-D antibodies derived from human plasma. During pregnancy or delivery, small amounts of fetal blood can enter the maternal circulation. If the fetus is Rh-positive, these erythrocytes can trigger the maternal immune system to produce endogenous antibodies. Administering Rh(D) immune globulin provides passive immunity by coating the fetal red blood cells. This leads to their rapid opsonization and clearance by maternal macrophages in the reticuloendothelial system. By sequestering and destroying the antigen before maternal B cells are activated, this therapy effectively prevents maternal alloimmunization and protects future pregnancies.
If prophylaxis is omitted or fails, maternal antibodies can freely cross the placenta and attack fetal erythrocytes, causing hemolytic disease of the newborn. This condition presents with severe fetal anemia, hyperbilirubinemia, and extramedullary hematopoiesis. In severe cases, the profound anemia leads to high-output heart failure and hydrops fetalis, characterized by generalized skin edema, ascites, and pleural effusions. To prevent this, standard guidelines mandate prophylactic administration of Rh(D) immune globulin at 28 weeks gestation and within 72 hours postpartum for all unsensitized Rh-negative mothers carrying an Rh-positive fetus.
Key TakeawayWhy the Other Choices Are Wrong
- Rh(D) immune globulin prevents maternal alloimmunization by binding to the D antigen on fetal erythrocytes in the maternal circulation, promoting their rapid clearance by macrophages.
- Prophylaxis is given at 28 weeks gestation and postpartum to prevent hemolytic disease of the newborn.
Choice B: Blockade of complement binding to fetal erythrocytes is the mechanism of complement inhibitors like eculizumab. This monoclonal antibody binds to C5, preventing the formation of the membrane attack complex. It is classically used to treat paroxysmal nocturnal hemoglobinuria, which presents with hemolytic anemia and venous thrombosis. This patient's presentation of Rh incompatibility and an elevated indirect Coombs titer make a complement inhibitor unlikely to be the indicated therapy.
Choice C: Induction of class switching by maternal B lymphocytes describes the natural progression of an active immune response, not a preventative pharmacotherapy. During active immunization, antigen presentation and T-cell help induce B cells to switch from producing IgM to IgG. This exact pathophysiologic process causes maternal Rh sensitization. This patient's goal of preventing complications from her Rh-negative status requires inhibiting this exact process, making induction of class switching unlikely to be the correct mechanism.
Choice D: Inhibition of production of fetal blood group A erythrocytes is not a recognized mechanism of any current pharmacotherapy. Blood group A antigens are genetically determined surface glycoproteins that develop early in fetal life. Suppressing fetal red blood cell production would cause severe fetal anemia rather than preventing complications. This patient's goal is to prevent immune-mediated destruction of fetal erythrocytes due to her Rh-negative status, making this mechanism counterproductive and unlikely.
Choice E: Prevention of fetal erythrocytes from entering maternal blood circulation cannot be achieved pharmacologically. Fetomaternal hemorrhage occurs naturally during pregnancy, particularly during the third trimester, labor, and delivery. While careful obstetric techniques can minimize excess blood mixing, microscopic transfer is a normal physiologic occurrence. This patient's positive indirect Coombs titer of 1:32 confirms that fetal erythrocytes have already entered her circulation, making prevention of this transfer impossible and unlikely.
Video Review: Pathologies of Pregnancy
Block 2, Question 13
Correct Answer: D. Purine degradation pathwayExplanation
This 40-year-old man presents with acute-onset, severe monoarticular arthritis of the first metatarsophalangeal joint (podagra) following the consumption of purine-rich foods and alcohol. These classic clinical findings are highly characteristic of an acute gout flare, which is driven by the accumulation of uric acid, an end product of the purine degradation pathway.
Gout is an inflammatory arthritis caused by the deposition of monosodium urate crystals. Uric acid is generated through the breakdown of purine nucleotides. In this cascade, adenosine and guanosine are converted to hypoxanthine and guanine, which are subsequently metabolized into xanthine. The critical enzyme xanthine oxidase catalyzes the final steps, oxidizing hypoxanthine to xanthine, and xanthine to uric acid. Consuming purine-rich foods like shellfish and beer increases the purine load, leading to hyperuricemia and crystal precipitation. This triggers an intense neutrophil-mediated inflammatory response within the affected first metatarsophalangeal joint.
Diagnosis of an acute gout flare is confirmed via arthrocentesis, revealing negatively birefringent needle-shaped crystals under polarized light microscopy. During an acute attack, serum uric acid levels can paradoxically be normal due to inflammatory cytokines promoting renal urate excretion. Acute management focuses on reducing inflammation. Colchicine works by binding to tubulin and inhibiting microtubule polymerization, thereby impairing leukocyte chemotaxis. Once the acute flare resolves, patients with recurrent attacks may be started on urate-lowering therapy, such as the competitive inhibitor allopurinol, to prevent future episodes.

Why the Other Choices Are Wrong
- Gout is an acute monoarticular arthritis caused by monosodium urate crystal deposition, often triggered by purine-rich foods like seafood and beer.
- Uric acid is the final product of the purine degradation pathway, catalyzed by the enzyme xanthine oxidase.
Choice A: Defects in the chylomicron processing pathway, such as lipoprotein lipase deficiency, cause familial chylomicronemia syndrome. This condition classically manifests with severe hypertriglyceridemia, recurrent acute pancreatitis, hepatosplenomegaly, and eruptive skin xanthomas. This patient's isolated acute monoarticular arthritis following a purine-rich meal makes a lipid metabolism disorder unlikely.
Choice B: Impaired methionine regeneration occurs in homocystinuria, typically due to cystathionine beta-synthase deficiency. Patients classically exhibit a Marfanoid habitus, downward lens subluxation, intellectual disability, and a high risk of premature arterial and venous thromboembolic events. This patient's localized joint inflammation and lack of systemic thrombotic or connective tissue findings rule out homocystinuria.
Choice C: The pentose phosphate pathway generates NADPH, which is essential for protecting erythrocytes from oxidative stress. Glucose-6-phosphate dehydrogenase deficiency impairs this pathway, leading to episodic hemolytic anemia characterized by jaundice, dark urine, and bite cells on peripheral smear following exposure to oxidative triggers. This patient's localized toe erythema and edema do not align with hemolysis.
Choice E: The urea cycle is responsible for converting toxic ammonia into excretable urea. Defects in this pathway, such as ornithine transcarbamylase deficiency, result in severe hyperammonemia presenting with vomiting, lethargy, asterixis, seizures, and cerebral edema. This patient's normal vital signs and isolated joint pain without any signs of encephalopathy make a urea cycle defect unlikely.
Video Review: Rheumatologic Diseases
Block 2, Question 14
Correct Answer: A. "Do you have any concerns about your alcohol use?"Explanation
This 34-year-old woman presents for a routine examination with a history of hypertension well-controlled on lisinopril and a recent citation for driving under the influence. Despite her electronic health record indicating only social drinking and a normal physical examination, her recent legal consequence suggests problematic drinking behavior that should be explored using open-ended, non-judgmental inquiry, making the most appropriate initial response "Do you have any concerns about your alcohol use?"
When a patient discloses an adverse event related to substance use, such as a legal citation, the physician must assess for problematic drinking. The initial approach should utilize principles of motivational interviewing, which emphasizes a collaborative, patient-centered communication style. The most effective first step is asking an open-ended question to gauge the patient's insight into their behavior and its consequences. This technique helps build therapeutic rapport and avoids making the patient defensive. By asking if she has concerns, the physician invites her to share her perspective without imposing judgment or prematurely diagnosing a substance use disorder. This approach directly informs the clinician's assessment of the stages of change model, revealing whether she is in the precontemplation or contemplation phase.
Further evaluation of this patient's drinking habits should incorporate validated screening tools like the AUDIT-C questionnaire, which quantifies consumption frequency and volume. If screening is positive, the physician must evaluate for specific diagnostic criteria, including recurrent use in physically hazardous situations, such as driving. Chronic alcohol consumption is also a significant, often overlooked contributor to secondary hypertension. Although her blood pressure is currently managed with an angiotensin-converting enzyme inhibitor, ongoing heavy alcohol use can cause refractory hypertension through sympathetic nervous system activation and endothelial dysfunction. Recognizing and addressing her drinking is crucial not only for preventing future legal or traumatic consequences but also for optimizing her cardiovascular risk reduction.
Key TakeawayWhy the Other Choices Are Wrong
- When a patient discloses a substance-related adverse event, the physician should initially use open-ended, non-judgmental questions to assess insight and readiness to change.
- Motivational interviewing builds therapeutic rapport and prevents defensiveness before progressing to specific screening or interventions.
Choice B: Asking how alcohol use compares to last week is a closed-ended, highly specific question. Closed-ended questions limit the patient's ability to elaborate and often yield brief, uninformative answers. They are best reserved for gathering specific quantitative data after establishing rapport. This patient's recent legal consequence requires an open-ended exploration of her insight, making a narrow comparative question an inappropriate starting point.
Choice C: Stating that the patient is here because she is concerned about her alcohol use is an assumption-based, closed-ended statement. Presuming a patient's primary concern can damage the physician-patient relationship, provoke defensiveness, and shut down meaningful dialogue regarding sensitive topics. This patient's stated reason for the visit is a routine examination, and she has minimized her drinking as "social," making this assumption incorrect.
Choice D: Asking when the patient had her last drink is a direct, closed-ended question used to assess the timeline of recent consumption. This question is clinically crucial when evaluating a patient at acute risk for alcohol withdrawal syndrome; such patients typically present with tremors, diaphoresis, tachycardia, and potentially seizures. This patient's normal physical examination indicates she is not in acute withdrawal, making this specific question unnecessary initially.
Choice E: Asking if the patient is willing to enter a detoxification program is a premature, action-oriented intervention. Detoxification programs are indicated for patients with severe physiologic dependence who require medical supervision to safely manage withdrawal symptoms. Recommending treatment before adequately assessing readiness to change often leads to resistance. This patient's self-described "social" drinking and lack of withdrawal signs mean she needs further assessment, not immediate detoxification.
Video Review: Ethics
Block 2, Question 15
Correct Answer: C. MesodermExplanation
This 4-year-old girl presents with slowly progressive, unilateral lower extremity edema caused by anomalous development of the lymphatic vessels. Primary lymphedema occurs due to congenital defects in lymphatic network formation, which, alongside the cardiovascular system and blood cells, originates from the embryonic germ layer known as the mesoderm.
During the third week of embryonic development, gastrulation establishes the three primary germ layers. The mesoderm differentiates into several critical structural and circulatory components of the body. It gives rise to the musculoskeletal system, the entire cardiovascular system, and the urogenital system. The lymphatic vessels specifically develop as endothelial outgrowths from the primitive venous system, which itself originates from splanchnic mesoderm. Other notable derivatives of this germ layer include the dermis, the spleen, and the adrenal cortex. Defects in these developmental pathways can lead to congenital anomalies such as primary lymphedema, as seen in this patient's unilateral leg swelling.
Congenital lymphatic dysplasia often presents in childhood as primary lymphedema, which is characterized by the accumulation of protein-rich interstitial fluid. When present at birth, this condition is frequently associated with Turner syndrome, where impaired lymphatic drainage leads to cystic hygromas and a characteristic webbed neck. In isolated familial cases, mutations in vascular endothelial growth factor receptor 3 can cause Milroy disease. Regardless of the etiology, chronic lymphatic stasis places patients at increased risk for recurrent soft tissue infections and, in severe, long-standing cases, the development of cutaneous angiosarcoma. Management primarily involves compression therapy and meticulous skin care.
Key TakeawayWhy the Other Choices Are Wrong
- The lymphatic system, along with the cardiovascular system, blood cells, and musculoskeletal system, derives from the embryonic mesoderm.
- Primary lymphedema results from congenital anomalous development of these mesoderm-derived lymphatic vessels.
Choice A: Ectoderm is the outermost embryonic germ layer that divides into surface ectoderm and neuroectoderm. The surface ectoderm gives rise to the epidermis, hair, nails, cutaneous glands, anterior pituitary, lens of the eye, and inner ear. This patient's defect involves the lymphatic vessels, which are circulatory structures, making an ectodermal origin incorrect.
Choice B: Endoderm is the innermost germ layer responsible for forming the epithelial linings of the respiratory and digestive tracts. It also gives rise to the parenchyma of the liver, pancreas, thyroid, parathyroid, thymus, and the epithelial lining of the bladder and urethra. This patient's anomalous lymphatic vessels are part of the circulatory system rather than an epithelial lining of a visceral organ, ruling out an endodermal origin.
Choice D: Neural crest cells are a specialized subpopulation of ectodermal cells that migrate extensively during development. They give rise to the peripheral nervous system, melanocytes, facial cartilage, dentin, parafollicular cells of the thyroid, and the adrenal medulla. Although neural crest cells form the aorticopulmonary septum of the heart, the systemic lymphatic and venous vessels implicated in this patient's unilateral leg edema do not derive from this tissue.
Choice E: Neuroectoderm forms the neural tube, which serves as the precursor to the central nervous system. Derivatives include the brain, spinal cord, posterior pituitary, pineal gland, and the retina. This patient's presentation involves a peripheral fluid accumulation due to a structural vascular defect, which does not align with the central nervous system structures derived from the neuroectoderm.
Block 2, Question 16
Correct Answer: B. Increased hemoglobin concentrationExplanation
This 50-year-old man presents with daytime somnolence, extreme obesity, and cyanosis alongside arterial blood gas findings of hypercapnia and hypoxemia. These findings indicate obesity hypoventilation syndrome, a condition characterized by chronic respiratory failure that triggers compensatory erythropoiesis, making the most likely additional finding an increased hemoglobin concentration.
Extreme obesity severely restricts chest wall mechanics and blunts the central ventilatory drive. This causes chronic alveolar hypoventilation, evidenced by this patient's severe hypercapnia and hypoxemia. The resulting chronic reduction in arterial oxygen tension is sensed by interstitial fibroblasts in the renal cortex, which synthesize and release erythropoietin. This hormone stimulates the bone marrow to produce more red blood cells, leading to secondary polycythemia. This compensatory mechanism increases the oxygen-carrying capacity of the blood, attempting to optimize tissue oxygen delivery in the setting of chronic hypoxia and manifesting clinically as cyanosis.
In addition to polycythemia, chronic hypoxemia in these patients triggers widespread hypoxic pulmonary vasoconstriction, which significantly increases pulmonary vascular resistance. Over time, this sustained resistance leads to pulmonary hypertension and subsequent right ventricular failure, known as cor pulmonale. Furthermore, the chronic respiratory acidosis prompts renal compensation via the retention of bicarbonate to buffer the excess carbon dioxide. Management of this condition primarily centers on weight loss and noninvasive positive pressure ventilation, such as continuous positive airway pressure therapy, which improves nocturnal gas exchange and reduces daytime hypercapnia.
Key TakeawayWhy the Other Choices Are Wrong
- Obesity hypoventilation syndrome causes chronic hypoxemia, which stimulates renal erythropoietin release and leads to compensatory secondary polycythemia.
- Chronic respiratory acidosis in this condition triggers compensatory renal bicarbonate retention.
Choice A: Decreased serum bicarbonate concentration is a hallmark of metabolic acidosis or a compensatory response to chronic respiratory alkalosis. In these states, bicarbonate is either depleted to buffer excess non-volatile acids or renally excreted to normalize pH. This patient's ABG demonstrates chronic respiratory acidosis, which would instead trigger renal bicarbonate retention, leading to an increased serum bicarbonate concentration.
Choice C: Increased total lung capacity is a classic pulmonary function test finding in obstructive lung diseases, such as emphysema or chronic bronchitis. These conditions involve airway trapping and destruction of alveolar septa, leading to hyperinflation of the lungs and an elevated residual volume. This patient's severe obesity causes a restrictive lung physiology due to excess chest wall mass impeding expansion, which would result in a decreased total lung capacity.
Choice D: Left ventricular hypertrophy is an adaptive structural change of the heart typically caused by chronic systemic hypertension or aortic stenosis. The left ventricle thickens concentrically in response to chronically elevated systemic afterload, eventually leading to diastolic dysfunction. This patient's chronic hypoxemia causes hypoxic pulmonary vasoconstriction, increasing right-sided afterload. Therefore, he is at risk for right ventricular hypertrophy rather than left ventricular hypertrophy, especially given his normal systemic blood pressure.
Video Review: Restrictive Lung Disease
Block 2, Question 17
Correct Answer: B. Escherichia coliExplanation
This 5-year-old girl presents with a recent episode of bloody diarrhea followed by acute kidney injury (oliguria, hypertension, elevated creatinine), thrombocytopenia, and microangiopathic hemolytic anemia (pallor, low hemoglobin and hematocrit). This classic triad of hemolytic uremic syndrome in a child is most commonly caused by Shiga toxin-producing Escherichia coli.
E. coli O157:H7 produces Shiga-like toxin, which inhibits the 60S ribosomal subunit in human cells, halting protein synthesis and causing cell death. The toxin targets the endothelial cells of the gastrointestinal tract and glomeruli. Endothelial damage in the kidneys triggers platelet activation and the formation of microthrombi. As red blood cells pass through these partially occluded vessels, they are sheared, resulting in schistocytes on peripheral blood smear and microangiopathic hemolytic anemia. The consumption of platelets in these microthrombi leads to thrombocytopenia, while the glomerular damage causes acute kidney injury.
Transmission of this pathogen typically occurs through the consumption of undercooked ground beef or unpasteurized milk. The management of hemolytic uremic syndrome is primarily supportive, focusing on fluid and electrolyte balance, blood transfusions for severe anemia, and dialysis for refractory acute kidney injury. Notably, the use of antibiotics is contraindicated in these patients, as it can increase the release of toxin from dying bacteria and worsen the clinical course. Most children recover renal function completely with appropriate supportive care, though a small percentage may develop chronic kidney disease.
.webp)
Why the Other Choices Are Wrong
- Hemolytic uremic syndrome presents with a triad of microangiopathic hemolytic anemia, thrombocytopenia, and acute kidney injury following an episode of bloody diarrhea.
- The most common cause in children is Shiga toxin-producing Escherichia coli, which is managed supportively without antibiotics.
Choice A: Campylobacter jejuni is a common cause of bacterial gastroenteritis worldwide. Infection typically presents with fever, abdominal pain, and bloody diarrhea. It is strongly associated with the subsequent development of Guillain-Barré syndrome, an acute demyelinating polyneuropathy characterized by ascending flaccid paralysis. This patient's acute kidney injury and severe thrombocytopenia make Campylobacter jejuni unlikely.
Choice C: Rotavirus is a viral pathogen that causes gastroenteritis, primarily in unvaccinated infants and young children. The virus destroys enterocytes in the duodenum and jejunum, leading to villous blunting and a secretory, watery diarrhea. Patients typically present with fever, vomiting, and nonbloody diarrhea. This patient's initial presentation of bloody diarrhea and subsequent development of acute kidney injury make rotavirus unlikely.
Choice D: Salmonella enterica serovar enteritidis is a common cause of foodborne illness associated with poultry and eggs. Infection typically causes an inflammatory gastroenteritis characterized by fever, abdominal cramping, vomiting, and bloody or nonbloody diarrhea. The bacteria invade the intestinal mucosa and cause a massive neutrophil response. This patient's progression to acute kidney injury and severe thrombocytopenia makes Salmonella enterica serovar enteritidis unlikely.
Choice E: Yersinia pestis is a gram-negative coccobacillus that causes bubonic, septicemic, and pneumonic plague. Transmission occurs via flea bites from infected rodents. Bubonic plague presents with sudden onset of high fever, chills, and exquisitely tender, swollen lymph nodes. Septicemic plague can cause disseminated intravascular coagulation. This patient's initial presentation of bloody diarrhea and the absence of painful lymphadenopathy make Yersinia pestis unlikely.
Video Review: Escherichia Coli
Block 2, Question 18
Correct Answer: C. Increased synthesis of contractile filaments
Explanation
This 52-year-old woman presents with headaches, elevated blood pressure, a laterally displaced point of maximal impulse, and left axis deviation with prominent R waves in the lateral precordial leads. These findings indicate left ventricular hypertrophy secondary to chronic hypertension, a compensatory response to increased afterload mediated by increased synthesis of contractile filaments.
Chronic hypertension increases systemic vascular resistance, forcing the left ventricle to contract against a chronically elevated afterload. To maintain cardiac output and reduce wall stress, the myocardium undergoes concentric hypertrophy, characterized by adding sarcomeres in parallel. This structural adaptation thickens the ventricular wall and decreases the chamber radius. The process is driven by altered gene expression and enhanced protein synthesis, specifically the upregulation of myosin heavy chain and actin. This cellular remodeling decreases ventricular compliance, leading to diastolic dysfunction, though the absence of an S3 gallop indicates no overt systolic failure.
The electrocardiographic findings of left axis deviation and exaggerated R wave amplitude in leads V5 and V6 reflect increased electrical forces generated by the enlarged left ventricular mass. As hypertrophy progresses, the thickened myocardium outgrows its blood supply, creating relative ischemia that can manifest as angina pectoris even without significant coronary artery disease. Furthermore, structural remodeling and associated interstitial fibrosis disrupt normal electrical conduction pathways, predisposing patients to atrial fibrillation and premature ventricular contractions, which likely explains this patient's skipped beats. Management primarily focuses on stringent blood pressure control to prevent further remodeling.
.webp)
Key Takeaway
- Left ventricular hypertrophy secondary to chronic hypertension is a compensatory response to increased afterload.
- The myocardium adapts via concentric hypertrophy, which is characterized by the addition of sarcomeres in parallel and increased synthesis of contractile filaments.
Why the Other Choices Are Wrong
Choice A: Excessive accumulation of glycogen occurs in Pompe disease, a lysosomal storage disorder caused by acid alpha-glucosidase deficiency. This condition classically presents in infancy with severe cardiomegaly, profound hypotonia, macroglossia, and early death from heart failure. This patient's adult onset of symptoms, chronic hypertension, and lack of systemic neuromuscular findings make Pompe disease unlikely.
Choice B: Fibrosis of intraventricular conduction pathways is a hallmark of Lev disease, an age-related degenerative process of the cardiac electrical system. It typically presents with progressive bradycardia, bundle branch blocks, or complete heart block, often requiring pacemaker implantation. This patient's prominent voltage criteria for hypertrophy and laterally displaced point of maximal impulse make a primary conduction system disease unlikely.
Choice D: Misfolding and aggregation of cytoskeletal proteins is the underlying mechanism of desmin-related myopathy, a rare genetic disorder. It is characterized by progressive skeletal muscle weakness, restrictive cardiomyopathy, and conduction blocks, often presenting in early adulthood. This patient's isolated left ventricular hypertrophy in the setting of uncontrolled hypertension makes an inherited cytoskeletal protein aggregation disorder unlikely.
Choice E: Myocyte hyperplasia as a result of induction of embryonic genes refers to an increase in the total number of cardiac muscle cells. While fetal myocardium grows primarily through hyperplasia, adult cardiac myocytes are terminally differentiated and respond to mechanical stress exclusively through cellular enlargement. This patient's left ventricular enlargement in response to chronic hypertension is driven by cellular hypertrophy rather than hyperplasia.
Video Review: Hypertension - Overview
Block 2, Question 19
Correct Answer: B. Cytochrome P450Explanation
This question describes an investigator's study on the genetic predisposition to lung cancer associated with occupational benzene exposure combined with smoking. The study highlights that single-nucleotide polymorphisms in enzymes responsible for the metabolic activation of procarcinogens increase cancer risk, a process primarily mediated by Cytochrome P450.
Environmental toxins, such as those in cigarette smoke and industrial chemicals like benzene, often enter the body as inactive procarcinogens. These substances must undergo biotransformation to become water-soluble for excretion. The initial step is phase I metabolism, which involves oxidation, reduction, or hydrolysis. While this step typically prepares molecules for further detoxification, it can paradoxically convert procarcinogens into highly reactive, mutagenic intermediates. This metabolic activation is predominantly catalyzed by the microsomal monooxygenase system, specifically the diverse family of CYP450 enzymes. Genetic polymorphisms increasing the activity of these enzymes lead to higher intracellular accumulation of toxic epoxide intermediates that damage DNA and drive carcinogenesis.
Following initial modification, these reactive intermediates typically undergo phase II metabolism to neutralize their toxicity. This subsequent step involves conjugation reactions, such as glucuronidation, sulfation, or acetylation, which yield highly polar, inactive metabolites that are readily excreted in the urine or bile. If the initial oxidative enzymes are overactive due to genetic variation, or if they are upregulated by a cytochrome inducer like chronic alcohol use or certain anticonvulsants, the production of toxic metabolites can overwhelm the conjugation capacity. Consequently, the imbalance between activation and detoxification allows electrophilic compounds to form covalent bonds with cellular macromolecules, ultimately leading to malignant transformation or acute cellular necrosis.
Key TakeawayWhy the Other Choices Are Wrong
- Procarcinogens in cigarette smoke and benzene are metabolically activated into highly reactive, mutagenic intermediates by phase I metabolism.
- This activation is primarily catalyzed by Cytochrome P450 enzymes; genetic polymorphisms increasing their activity elevate the risk of carcinogenesis.
Choice A: Aldehyde dehydrogenase is an enzyme responsible for the oxidation of aldehydes into carboxylic acids. It plays a critical role in ethanol metabolism by converting toxic acetaldehyde into harmless acetate. Genetic polymorphisms in this enzyme lead to alcohol flushing syndrome due to acetaldehyde accumulation. This enzyme is involved in detoxification rather than the metabolic activation of procarcinogens like benzene described in the vignette.
Choice C: Glutathione S-transferase is a phase II metabolic enzyme that catalyzes the conjugation of reduced glutathione to various electrophilic compounds. This specific pathway neutralizes reactive intermediates produced during initial oxidative metabolism, rendering them more water-soluble to prevent cellular damage. Because this enzyme functions to detoxify reactive metabolites rather than generate them, increased activity would theoretically protect against, rather than increase the risk of, cancer development.
Choice D: Methyltransferase enzymes transfer methyl groups from a donor molecule, such as S-adenosylmethionine, to various substrates including DNA, proteins, and small molecules. Thiopurine methyltransferase is a notable example that metabolizes and inactivates thiopurine drugs like azathioprine. While epigenetic modifications are involved in carcinogenesis, these enzymes primarily participate in phase II conjugation and epigenetic regulation rather than the direct metabolic activation of procarcinogens.
Choice E: Succinate dehydrogenase is an enzyme complex embedded in the inner mitochondrial membrane that participates in both the citric acid cycle and the electron transport chain. It catalyzes the oxidation of succinate to fumarate while simultaneously reducing FAD to FADH2. This enzyme is central to cellular respiration and energy production, and it does not play a role in the biotransformation or metabolic activation of xenobiotics like benzene.
Video Review: DNA Mutations, Damage, and Repair
Block 2, Question 20
Correct Answer: B. Phase 1Explanation
This question describes a clinical trial enrolling 80 healthy volunteers assessing the maximum tolerated dose and pharmacokinetic properties of a new antimalarial drug. Testing a drug's safety profile and metabolism in a small group of disease-free individuals is the hallmark of Phase 1.
The primary objective of a Phase 1 clinical trial is to evaluate the safety profile of a new pharmacological agent in humans. These studies typically enroll a small cohort of 20 to 100 healthy volunteers, though patients with the target disease may be used for highly toxic medications like chemotherapeutics. Investigators focus on determining the maximum tolerated dose, identifying dose-limiting toxicities, and observing the drug's pharmacokinetics (absorption, distribution, metabolism, and excretion). This phase establishes whether the drug is safe enough to proceed to efficacy testing, operating under the core ethical principle of nonmaleficence to minimize potential harm to human subjects.
Prior to initiating human testing, a pharmaceutical sponsor must submit an Investigational New Drug application to the Food and Drug Administration, detailing preclinical animal data that demonstrates a reasonable expectation of safety. If the agent successfully passes initial human safety evaluations, it advances to Phase 2 trials, which assess clinical efficacy and optimal dosing in a small sample of patients afflicted with the target condition. Subsequently, Phase 3 trials compare the novel therapy against the established standard of care or placebo in a large, randomized cohort. Successful completion of these rigorous stages culminates in a New Drug Application for market approval.
Key TakeawayWhy the Other Choices Are Wrong
- Phase 1 clinical trials evaluate the safety, toxicity, maximum tolerated dose, and pharmacokinetics of a new drug.
- These initial human studies typically enroll a small number (20-100) of healthy volunteers.
Choice A: Phase 0 trials involve exploratory, first-in-human microdosing studies. These studies use subtherapeutic doses of a drug in a very small number of people (typically 10 to 15) to gather preliminary data on the agent's pharmacodynamics and pharmacokinetics before formal testing. This trial's assessment of the maximum tolerated dose and inclusion of 80 participants make a Phase 0 study unlikely.
Choice C: Phase 2 trials are designed to evaluate the clinical efficacy of a new medication. This stage typically enrolls 100 to 300 patients who actually have the disease of interest to determine if the drug works, identify optimal dosing regimens, and monitor for short-term adverse effects. This study's use of healthy volunteers rather than patients infected with malaria makes a Phase 2 trial unlikely.
Choice D: Phase 3 trials represent the final pre-approval stage of clinical testing. These large-scale studies randomize hundreds to thousands of patients with the target disease to receive either the experimental drug, placebo, or current gold-standard treatment to definitively prove comparative efficacy. This investigation's small sample size of 80 individuals and focus on safety rather than efficacy make a Phase 3 trial unlikely.
Choice E: Phase 4 trials consist of post-marketing surveillance after a drug has received regulatory approval. These observational studies monitor the general population using the medication in real-world settings to identify rare, long-term adverse effects that were not apparent during the initial clinical trials. This investigator's evaluation of a drug that is still undergoing the pre-approval process makes a Phase 4 trial unlikely.
Video Review: Experimental Studies
Block 3, Question 1
Correct Answer: A. Depletion of glycogen storesExplanation
This 21-year-old man presents with unresponsiveness, hypothermia, tachycardia, and cool, clammy skin secondary to severe hypoglycemia (glucose 25 mg/dL) in the setting of type 1 diabetes mellitus and marathon training. Administration of exogenous glucagon fails to raise his serum glucose concentration, indicating an inability to rapidly mobilize endogenous glucose reserves. This failure of glucagon rescue following prolonged strenuous exercise is best explained by depletion of glycogen stores.
Glucagon is a counter-regulatory peptide hormone secreted by pancreatic alpha cells that raises blood glucose levels during fasting or hypoglycemia. It acts primarily on the liver by binding to G protein-coupled receptors, which activates adenylate cyclase and increases intracellular cAMP. This signaling cascade rapidly stimulates hepatic glycogenolysis while simultaneously inhibiting glycogen synthesis. However, because exogenous glucagon relies on existing biochemical reserves to produce an immediate glycemic response, its efficacy is severely blunted in states of prolonged endurance exercise. In this marathon runner, prolonged physical exertion has completely exhausted his hepatic glycogen stores, rendering the rescue injection ineffective at rapidly correcting his exertional hypoglycemia.
Patients with type 1 diabetes mellitus are particularly vulnerable to exercise-induced hypoglycemia because exogenous insulin absorption continues regardless of physiological demand, blocking endogenous glucose production. The patient's tachycardia and cool, clammy skin reflect a compensatory sympathetic nervous system surge triggered by neuroglycopenia. While glucagon also stimulates gluconeogenesis, this pathway is too slow to provide immediate rescue in an unresponsive patient. Therefore, when a hypoglycemic patient is unresponsive and ineligible for glucagon due to suspected glycogen depletion, the immediate treatment of choice is administration of intravenous dextrose. If intravenous access cannot be rapidly established, intraosseous access should be utilized to deliver life-saving glucose.
Key TakeawayWhy the Other Choices Are Wrong
- Glucagon rapidly corrects severe hypoglycemia by stimulating hepatic glycogenolysis, which requires adequate hepatic glycogen stores to be effective.
- In states of glycogen depletion (e.g., prolonged endurance exercise, starvation), exogenous glucagon is ineffective, and severe hypoglycemia must be treated with intravenous dextrose.
Choice B: Downregulation of glucagon receptors by exercise proposes that physical exertion decreases hepatic sensitivity to glucagon. Receptor downregulation typically occurs in response to chronic overexposure to an agonist, leading to decreased receptor density to prevent cellular overstimulation. This patient's lack of response is due to substrate depletion, not receptor changes; exercise actually increases hepatic sensitivity to counter-regulatory hormones to maintain euglycemia.
Choice C: Impairment of glycogenolysis caused by an increased circulating concentration of catecholamines incorrectly suggests that sympathetic activation prevents glycogen breakdown. Catecholamines like epinephrine are counter-regulatory hormones released during stress or hypoglycemia. They bind to beta-adrenergic receptors, actively stimulating glycogenolysis to increase blood glucose. This patient's tachycardia and diaphoresis indicate a robust catecholamine surge, which would promote, rather than impair, glycogenolysis.
Choice D: Inhibition of gluconeogenesis caused by an increased circulating insulin concentration suggests excess exogenous insulin is blocking new glucose production. Insulin lowers blood glucose by promoting peripheral uptake and strongly inhibiting hepatic gluconeogenesis. While this patient's insulin pump contributes to his initial hypoglycemia, glucagon administration normally overrides insulin's inhibitory effect on gluconeogenesis. Substrate depletion, not insulin-mediated inhibition, explains the failed rescue.
Video Review: Insulin Physiology
Block 3, Question 2
Correct Answer: B. "I'm concerned the mass could be cancer. The biopsy will provide more information."Explanation
This 72-year-old woman presents with jaundice, weight loss, and a pancreatic head mass with liver lesions on CT scan, findings highly suspicious for metastatic pancreatic adenocarcinoma. When delivering bad news, physicians should provide clear, honest information about suspected diagnoses rather than withholding concerns until definitive testing is complete, making the most appropriate next remark "I'm concerned the mass could be cancer. The biopsy will provide more information."
Delivering difficult information requires a structured, empathetic approach, often guided by the SPIKES protocol. After establishing the setting and assessing the patient's perception, the physician must provide knowledge clearly and directly. In this scenario, the clinical picture of jaundice and a pancreatic mass with hepatic lesions strongly suggests a malignancy. When a life-threatening diagnosis is highly suspected based on initial imaging, physicians have a fiduciary duty to share these concerns honestly. Withholding this suspicion deprives the patient of the opportunity to process the potential reality and violates the ethical principle of patient autonomy.
Pancreatic adenocarcinoma typically presents late; pancreatic head tumors compress the common bile duct, causing obstructive jaundice, while body tumors remain asymptomatic until metastasizing. The presence of liver lesions indicates stage IV disease, carrying a poor prognosis. During communication, using a warning shot (e.g., "I am concerned") helps prepare the patient emotionally for devastating news. Physicians must avoid medical jargon, ensure comprehension, and respond to emotions using empathic communication skills before discussing the next steps in management, such as the recommended liver biopsy for definitive tissue diagnosis.
Key TakeawayWhy the Other Choices Are Wrong
- When a serious diagnosis is highly suspected based on clinical findings and imaging, physicians must share their concerns honestly and compassionately before definitive biopsy results are available.
- Withholding suspicion of cancer or providing false reassurance violates patient autonomy.
Choice A: "I suspect you have a malignant mass in the pancreas, but I'll need the biopsy results to confirm my suspicion." is an overly blunt statement that lacks empathy. While physicians must be honest about suspected diagnoses, delivering news of a likely terminal illness requires tact and emotional preparation. This patient's sudden exposure to the word "malignant" without a softening introductory phrase makes this approach inappropriately harsh.
Choice C: "This could be something serious, but let's not worry about that until we know for sure." is an example of false reassurance. False reassurance occurs when a physician minimizes a patient's legitimate concerns or provides unwarranted optimism to alleviate immediate anxiety. This patient's CT findings of a pancreatic mass with liver lesions are highly concerning for metastatic cancer, making it inappropriate to tell her not to worry.
Choice D: "This mass could be benign or malignant. I'd like to wait for the biopsy results before I share the suspected diagnosis." represents inappropriate withholding of information. Paternalism occurs when a physician decides what information a patient can handle. This patient's right to autonomy dictates she be informed of the high clinical suspicion for cancer rather than having the physician unilaterally conceal this likely diagnosis until biopsy confirmation.
Choice E: "We don't know what this mass is yet, but the biopsy should give us some answers." is an evasive statement that fails to disclose the physician's clinical suspicion. Evasion often stems from the physician's own discomfort with delivering bad news. This patient's presentation with weight loss, jaundice, and a pancreatic mass with liver lesions strongly points to cancer, and failing to share this concern violates the principle of informed consent.
Video Review: Pancreatic Adenocarcinoma
Block 3, Question 3
Correct Answer: B. Janus kinase 2Explanation
This 56-year-old man presents with headaches, fatigue, splenomegaly, and marked erythrocytosis (hemoglobin 19.5 g/dL, hematocrit 59%) without a history of smoking. This clinical picture of hyperviscosity symptoms, borderline hypertension, and splenomegaly alongside primary polycythemia is highly suggestive of polycythemia vera, a myeloproliferative neoplasm driven by a mutation in Janus kinase 2.
Polycythemia vera is one of the classic Philadelphia chromosome-negative myeloproliferative neoplasms. The vast majority of cases are caused by a point mutation (V617F) in the JAK2 gene, which encodes a non-receptor tyrosine kinase. Normally, this kinase is activated only when a ligand, such as erythropoietin, binds to its respective cell surface receptor. The mutation results in constitutive, ligand-independent activation of the JAK-STAT signaling pathway. This drives unchecked proliferation of myeloid lineages, predominantly erythrocytes, leading to the markedly elevated hemoglobin and hematocrit seen in this patient, along with a concurrent mild elevation in platelets.
Patients with this condition frequently experience hyperviscosity symptoms, including headaches, blurry vision, and venous thromboses. A classic clinical hallmark is aquagenic pruritus, characterized by severe itching following a hot shower due to histamine release from increased basophils. Because the erythroid proliferation is autonomous, laboratory evaluation classically reveals decreased erythropoietin levels, distinguishing this primary polycythemia from secondary causes like chronic hypoxia or paraneoplastic syndromes. The splenomegaly observed in this patient reflects extramedullary hematopoiesis or splenic congestion. Initial management focuses on reducing red blood cell mass and cardiovascular risk through therapeutic phlebotomy and daily low-dose aspirin.
Key TakeawayWhy the Other Choices Are Wrong
- Polycythemia vera is a myeloproliferative neoplasm caused by a V617F mutation in JAK2, a non-receptor tyrosine kinase.
- It presents with hyperviscosity symptoms, splenomegaly, elevated hemoglobin/hematocrit, and characteristically low erythropoietin levels.
Choice A: G protein mutations are implicated in various endocrine and neoplastic disorders, such as McCune-Albright syndrome or pituitary adenomas. Activating mutations in the GNAS gene lead to constitutive cAMP production, causing autonomous endocrine hyperfunction, fibrous dysplasia of bone, and café-au-lait macules. This patient's isolated hyperviscosity symptoms, splenomegaly, and marked erythrocytosis make a G protein mutation unlikely.
Choice C: Platelet-derived growth factor receptor mutations are associated with chronic eosinophilic leukemia and dermatofibrosarcoma protuberans. These conditions typically present with marked peripheral eosinophilia, organ damage from eosinophil infiltration, or slow-growing nodular skin lesions. This patient's normal leukocyte count and massive expansion of the erythroid lineage rather than eosinophils make a platelet-derived growth factor mutation unlikely.
Choice D: Retinoic acid receptor alpha mutations characterize acute promyelocytic leukemia, a subtype of acute myeloid leukemia. This condition is driven by the t(15;17) translocation, which creates a fusion protein that halts myeloid differentiation and classically presents with pancytopenia and disseminated intravascular coagulation. This patient's elevated hemoglobin and normal leukocyte count, rather than pancytopenia and bleeding diathesis, make a retinoic acid receptor mutation unlikely.
Choice E: Thrombopoietin receptor mutations are implicated in essential thrombocythemia and primary myelofibrosis, which are other myeloproliferative neoplasms. Essential thrombocythemia classically manifests with massive megakaryocytic proliferation leading to extreme thrombocytosis and associated bleeding or thrombotic complications. While this patient has a borderline-high platelet count, his primary abnormality is severe erythrocytosis, making a Janus kinase 2 mutation much more likely than a thrombopoietin receptor mutation.
Video Review: Polycythemia Vera & Essential Thrombocythemia
Block 3, Question 4
Correct Answer: E. EExplanation
This 34-year-old woman presents with medically refractory seizures characterized by olfactory auras, oral automatisms, and emotional outbursts. These clinical features are classic for focal impaired awareness seizures originating in the medial temporal lobe, making the most appropriate target for intracranial electroencephalography electrodes region E.
Temporal lobe epilepsy is the most common cause of focal seizures in adults and is frequently refractory to anticonvulsant therapy, necessitating surgical evaluation. Seizures arising from this region typically begin with an aura, which represents a simple focal seizure before consciousness is impaired. The uncus houses the primary olfactory cortex, so abnormal electrical activity here produces phantom smells, classically described as burning rubber. Subsequent spread to the adjacent amygdala generates intense affective responses, which manifest clinically as sudden fear, panic, or emotional shouting.
As the seizure propagates through the temporal lobe and impairs consciousness, patients frequently exhibit repetitive, non-purposeful movements known as automatisms, such as lip smacking, chewing, or picking at clothes. These episodes typically last several minutes and are followed by a postictal state of confusion. The most common underlying pathology in these patients is mesial temporal sclerosis, characterized by neuronal loss and gliosis in the hippocampus. Surgical intervention, such as an anterior temporal lobectomy, can be curative when the epileptogenic focus is precisely localized using intracranial electrodes.
Key TakeawayWhy the Other Choices Are Wrong
- Medial temporal lobe epilepsy classically presents with olfactory auras (uncus), emotional changes (amygdala), and oral automatisms like lip smacking.
- Mesial temporal sclerosis is the most common underlying pathology for medically refractory focal seizures in adults.
Choice A: Region A indicates the medial longitudinal fissure and falx cerebri, which separate the cerebral hemispheres. Seizures originating in the adjacent medial frontal lobe or supplementary motor area typically present with asymmetric tonic posturing (fencer's posture) or bilateral leg motor symptoms. This patient's olfactory auras and emotional shouting make a medial frontal lobe focus unlikely.
Choice B: Region B points to the cingulate gyrus, a key component of the limbic system involved in emotion processing and autonomic regulation. Cingulate epilepsy is rare and typically manifests with hypermotor seizures, complex autonomic signs, and intense affective symptoms like sudden terror. While this patient has emotional shouting, her prominent olfactory auras and oral automatisms strongly point to a temporal rather than cingulate focus.
Choice C: Region C represents the deep gray matter structures, including the thalamus and basal ganglia, which relay sensory and motor signals. Lesions or abnormal electrical activity here can cause movement disorders or widespread sensory deficits, and the thalamus plays a key role in generalizing seizure activity across the cortex. This patient's focal sensory auras and complex partial semiology make a primary deep gray matter focus unlikely.
Choice D: Region D identifies the insular cortex, which lies deep within the lateral sulcus and processes gustatory, visceral, and autonomic information. Insular seizures classically produce visceral sensory auras (e.g., laryngeal constriction, epigastric rising sensations), gustatory hallucinations, and prominent autonomic changes. This patient's olfactory auras and lip smacking make an insular focus less likely than a medial temporal focus.
Video Review: Seizures
Block 3, Question 5
Correct Answer: A. Binding to muscarinic acetylcholine receptorsExplanation
This 20-year-old woman presents with bilateral salivary gland swelling, dental enamel erosion, and dorsal hand scarring (Russell sign) consistent with bulimia nervosa. Her normal BMI and lack of suicidal ideation support this diagnosis over anorexia nervosa or severe major depressive disorder. The recent onset of buccal pain and glandular swelling suggests acute sialadenosis, which is best managed symptomatically with a sialagogue that acts by binding to muscarinic acetylcholine receptors.
Patients with bulimia nervosa frequently develop noninflammatory salivary gland enlargement, known as sialadenosis, due to chronic autonomic stimulation from recurrent vomiting. While typically painless, the hypertrophied glands can occasionally cause discomfort or acute pain if salivary ducts become transiently obstructed or inflamed. Management of this condition primarily involves cessation of purging behavior, which this patient is likely attempting given her recent psychiatric admission. For symptomatic relief of painful glandular swelling, patients benefit from sialagogues, such as pilocarpine or sour candies. These agents directly stimulate salivary flow by agonizing the M3 muscarinic receptors located on salivary acinar cells.
The diagnosis of bulimia nervosa is supported by this patient's normal body weight, distinguishing it from the significantly low weight required for anorexia nervosa. Frequent self-induced vomiting exposes the oral cavity to gastric acid, leading to characteristic dental enamel erosion, while repeated friction against the incisors causes calluses on the knuckles, known as Russell sign. Although her laboratory studies are currently normal, recurrent purging classically causes a hypokalemic, hypochloremic metabolic alkalosis. Fluoxetine, a selective serotonin reuptake inhibitor, was appropriately started on admission as it is the only FDA-approved medication for bulimia nervosa, helping to reduce binge-purge cycles.

Why the Other Choices Are Wrong
- Bulimia nervosa can cause painful salivary gland hypertrophy (sialadenosis) due to chronic autonomic stimulation from recurrent vomiting.
- Symptomatic relief is achieved with sialagogues (e.g., pilocarpine), which stimulate salivary flow by agonizing muscarinic acetylcholine receptors.
Choice B: Binding to nicotinic acetylcholine receptors is the mechanism of action for nicotine replacement therapies and varenicline. These agents are primarily used for smoking cessation by stimulating receptors in the central nervous system to reduce cravings and withdrawal symptoms. This patient's acute buccal pain and salivary gland swelling require an autonomic secretagogue, making a nicotinic agonist unhelpful.
Choice C: Inhibition of protein synthesis via binding to 50S ribosomal subunits describes the mechanism of macrolide antibiotics (e.g., azithromycin). Macrolides treat atypical pneumonias and acute bacterial sialadenitis, which typically presents with unilateral, exquisitely tender gland swelling, purulent ductal discharge, and fever. This patient's normal vital signs, bilateral presentation, and lack of purulent discharge make a bacterial infection requiring macrolide therapy unlikely.
Choice D: Inhibition of protein synthesis via loss of DNA helical structure is the mechanism of metronidazole, which forms toxic free radicals that damage bacterial DNA. Metronidazole is highly effective against anaerobic bacteria and certain protozoa, serving as a primary treatment for bacterial vaginosis and intra-abdominal infections. This patient's parotid swelling is a noninfectious consequence of recurrent purging, making antimicrobial therapy with metronidazole inappropriate.
Choice E: Interference with bacterial wall synthesis is the mechanism of beta-lactam antibiotics, such as penicillins, which bind penicillin-binding proteins to halt peptidoglycan cross-linking. They are frequently prescribed for acute suppurative sialadenitis, typically presenting with unilateral gland induration, erythema, and fever. This patient's afebrile status, normal laboratory studies, and bilateral glandular swelling point toward a noninfectious etiology, ruling out the need for beta-lactam antibiotics.
Block 3, Question 6
Correct Answer: D. Type IV (delayed)Explanation
This 42-year-old man presents with a severely pruritic, erythematous, vesicular rash that developed 24 hours after clearing weeds from his yard. The delayed onset of this characteristic skin eruption following direct physical contact with plant allergens strongly suggests allergic contact dermatitis, which is mediated by a Type IV (delayed) hypersensitivity reaction.
Allergic contact dermatitis occurs in two distinct phases following exposure to haptens like urushiol. During the initial sensitization phase, cutaneous Langerhans cells capture the antigen and migrate to regional lymph nodes to generate memory T cells. Upon re-exposure during the elicitation phase, these memory cells migrate to the skin and release cytokines like interferon-gamma, which recruits and activates macrophages. This inflammatory cascade leads to tissue damage, erythema, and vesicle formation. Because this cellular process takes 24 to 72 hours to develop, it is classified as a cell-mediated immune response, distinguishing it from antibody-driven hypersensitivities. The resulting epidermal spongiosis manifests clinically as the weeping vesicles characteristic of allergic contact dermatitis.
Beyond plant haptens, this delayed reaction is frequently triggered by nickel, neomycin, and latex. Diagnosis is primarily clinical, but when the offending agent is unclear, patch testing is the gold standard for identification. During this procedure, suspected allergens are applied to the back and evaluated after 48 hours for localized induration and erythema. Management of mild localized eruptions involves supportive care with cool compresses and topical corticosteroids to reduce inflammation and pruritus. In severe cases with extensive body surface area involvement or facial swelling, a tapering course of oral prednisone is required over two to three weeks to prevent rebound flares.

Why the Other Choices Are Wrong
- Allergic contact dermatitis (e.g., poison ivy) is a Type IV (delayed) hypersensitivity reaction mediated by antigen-specific T cells.
- Symptoms typically develop 24 to 72 hours after exposure and manifest as a severely pruritic, erythematous, vesicular rash.
Choice A: Type I (immediate) hypersensitivity is an IgE-mediated reaction occurring within minutes of allergen exposure. Cross-linking of IgE on mast cells leads to rapid degranulation and histamine release. This classically produces urticaria, characterized by transient, intensely pruritic wheals, or anaphylaxis. This patient's delayed symptom onset 24 hours after exposure and the presence of vesicles rather than transient wheals make an immediate hypersensitivity reaction unlikely.
Choice B: Type II (complement-mediated cytotoxic) hypersensitivity involves IgG or IgM antibodies binding to fixed cell surface antigens. This leads to cellular destruction via complement activation or opsonization. Classic examples include autoimmune hemolytic anemia and Goodpasture syndrome, presenting with systemic symptoms, anemia, or organ-specific dysfunction. This patient's localized cutaneous vesicular eruption following direct contact with plant matter is not consistent with a cytotoxic antibody-mediated process.
Choice C: Type III (immune complex-mediated) hypersensitivity occurs when circulating antigen-antibody complexes deposit in tissues, activating complement. This mechanism underlies conditions like serum sickness and systemic lupus erythematosus. Cutaneous manifestations typically include palpable purpura from leukocytoclastic vasculitis, often accompanied by fever and arthralgias. This patient's isolated, intensely pruritic, vesicular rash appearing after direct environmental exposure lacks the purpuric lesions characteristic of immune complex deposition.
Video Review: Type I Hypersensitivity Reactions
Block 3, Question 7
Correct Answer: E. Right ventricular diastolic complianceExplanation
This 45-year-old woman presents with shortness of breath at rest, jugular venous distention, and pedal edema after living at high altitude for two years. These findings indicate right-sided heart failure secondary to chronic hypoxic pulmonary vasoconstriction, a condition known as cor pulmonale. The resulting right ventricular hypertrophy leads to a progressive reduction in right ventricular diastolic compliance.
Chronic exposure to high altitude causes persistent alveolar hypoxia, triggering widespread hypoxic pulmonary vasoconstriction. Unlike the systemic circulation, which dilates in response to low oxygen, the pulmonary vasculature constricts to shunt blood toward better-ventilated alveoli. When this response occurs due to environmental hypoxia, it substantially elevates pulmonary vascular resistance and causes pulmonary hypertension. The right ventricle must generate higher pressures to overcome this increased afterload, leading to compensatory concentric hypertrophy. As the right ventricular wall thickens, the chamber becomes stiffer, resulting in impaired relaxation and decreased compliance.
The stiffened right ventricle eventually fails to maintain adequate cardiac output, culminating in cor pulmonale. This right-sided heart failure causes blood to back up into the systemic venous circulation, producing the characteristic physical exam findings of elevated central venous pressure. Increased hydrostatic pressure drives fluid extravasation, manifesting as peripheral edema and hepatic congestion. Because these structural cardiac changes are chronic, her symptoms persist even when evaluated at a sea-level clinic with normal vital signs. Additionally, high-altitude hypoxia stimulates renal erythropoietin release, leading to a compensatory secondary polycythemia.

Why the Other Choices Are Wrong
- Chronic high-altitude hypoxia causes global hypoxic pulmonary vasoconstriction, leading to pulmonary hypertension and right ventricular hypertrophy (cor pulmonale).
- Right ventricular hypertrophy decreases the chamber's diastolic compliance, impairing filling and causing systemic venous congestion.
Choice A: Height of P waves in lead I of the patient's ECG reflects left atrial depolarization and enlargement. Left atrial enlargement classically produces broad, notched P waves in lead II and biphasic P waves in lead V1. It typically results from left-sided heart pathologies like mitral stenosis. This patient's isolated right-sided heart failure signs and lack of left-sided pathology make left atrial enlargement unlikely.
Choice B: Height of R waves in lead V1 of the patient's ECG represents right ventricular depolarization forces. Right ventricular hypertrophy progressively increases the R wave amplitude in right-sided precordial leads, often producing an R/S ratio greater than 1 in lead V1. The thickened muscle mass generates larger electrical vectors directed anteriorly. This patient's chronic pulmonary hypertension would cause an increase, rather than a decrease, in these R wave amplitudes.
Choice C: Hematocrit measures the volume percentage of red blood cells in the blood. Chronic hypoxia stimulates renal interstitial cells to synthesize and release erythropoietin. This hormone drives bone marrow erythropoiesis, resulting in secondary polycythemia to enhance systemic oxygen delivery. This patient's two-year residence at 10,000 feet above sea level would result in a compensatory increase, not a decrease, in her hematocrit.
Choice D: Pulmonary vascular resistance is the resistance offered by the pulmonary circulation against blood flow from the right ventricle. Alveolar hypoxia induces localized vasoconstriction to optimize ventilation-perfusion matching. In environments with globally low partial pressures of oxygen, this mechanism causes diffuse pulmonary vasoconstriction and extensive vascular remodeling. This patient's chronic exposure to high altitude would significantly increase, rather than decrease, her pulmonary vascular resistance.
Choice F: Right ventricular wall thickness reflects the myocardial muscle mass of the right heart chamber. Chronic elevation in pulmonary arterial pressure forces the right ventricle to contract against a persistently high afterload. The myocardium adapts by adding sarcomeres in parallel, resulting in concentric hypertrophy. This patient's jugular venous distention and edema indicate right heart failure, which follows an increase, not a decrease, in right ventricular wall thickness.
Video Review: Blood Physiology
Block 3, Question 8
Correct Answer: A. Delayed femoral pulsesExplanation
This 7-year-old boy presents for a well-child examination with upper extremity hypertension, a significant upper-to-lower extremity blood pressure gradient, normal oxygen saturation, and a systolic ejection murmur heard at the left sternal border and left paravertebral intrascapular area. This localized vascular resistance represents coarctation of the aorta, which is classically associated with delayed femoral pulses.
Coarctation of the aorta is a congenital narrowing of the descending aorta, typically located distal to the left subclavian artery. This constriction creates significant resistance to blood flow, resulting in elevated pressures proximally and decreased pressures distally. Consequently, patients develop upper extremity hypertension and lower extremity hypotension. The hallmark physical examination finding is a brachial-femoral delay, characterized by diminished and delayed femoral pulses compared to upper extremity pulses. This condition is frequently associated with other congenital anomalies, most notably a bicuspid aortic valve, occurring in over half of affected patients.
To bypass the aortic narrowing, older children develop collateral circulation through the internal thoracic and intercostal arteries. Engorgement of these vessels leads to the classic radiographic finding of rib notching on the inferior rib margins. The intrascapular systolic murmur reflects turbulent blood flow directly through the coarcted segment or enlarged collaterals. If untreated, chronic proximal hypertension leads to compensatory left ventricular hypertrophy and an increased risk of heart failure. Additionally, patients have a heightened risk of ruptured cerebral aneurysms due to the sustained elevation in cerebral perfusion pressure.

Why the Other Choices Are Wrong
- Coarctation of the aorta presents with upper extremity hypertension, lower extremity hypotension, and a systolic murmur radiating to the back.
- The hallmark physical examination finding is a brachial-femoral delay, characterized by diminished and delayed femoral pulses.
Choice B: Increased jugular venous pressure is a classic sign of elevated right-sided heart pressures, commonly seen in right ventricular failure, cardiac tamponade, or constrictive pericarditis. Patients typically present with peripheral edema, ascites, and hepatosplenomegaly. This patient's lack of hepatosplenomegaly and the presence of a localized upper-to-lower extremity blood pressure gradient make right heart failure unlikely.
Choice C: A nontender mass in the inguinal area typically indicates an indirect inguinal hernia or an undescended testis. Indirect inguinal hernias occur due to a patent processus vaginalis, allowing abdominal contents to protrude through the deep inguinal ring. This patient's prominent cardiovascular findings, including the significant blood pressure gradient and intrascapular murmur, make an isolated inguinal pathology unlikely.
Choice D: A pulsatile abdominal mass is the hallmark physical examination finding of an abdominal aortic aneurysm, which involves focal dilation of the aortic wall. While it can rarely occur in children with connective tissue disorders, it typically presents with abdominal or back pain. This patient's upper extremity hypertension and diminished lower extremity blood pressures make a coarctation much more likely than an aneurysm.
Choice E: Pulsus paradoxus is an exaggerated drop in systolic blood pressure of greater than 10 mm Hg during inspiration. It is classically associated with cardiac tamponade, severe asthma exacerbations, and constrictive pericarditis due to enhanced ventricular interdependence. This patient's clear lungs, absence of respiratory distress, and specific upper-to-lower extremity blood pressure discrepancy make pulsus paradoxus unlikely.
Video Review: Acyanotic Congenital Heart Defects
Block 3, Question 9
Correct Answer: A. Calcitriol production by activated macrophagesExplanation
This 52-year-old woman presents with symptoms of hypercalcemia (fatigue, constipation, polyuria), suppressed parathyroid hormone, and chest x-ray findings of bilateral hilar lymphadenopathy with interstitial infiltrates. This clinical picture is highly characteristic of sarcoidosis, a granulomatous disease that causes hypercalcemia via calcitriol production by activated macrophages.
Sarcoidosis is a systemic inflammatory condition characterized by the formation of noncaseating granulomas in various organs, most commonly the lungs and lymph nodes. The hypercalcemia seen in this condition is parathyroid hormone-independent, as evidenced by this patient's suppressed parathyroid hormone levels. It occurs because the macrophages within the granulomas possess 1-alpha-hydroxylase activity. This enzyme converts 25-hydroxyvitamin D into active calcitriol. The resulting excess calcitriol increases intestinal calcium absorption, leading to hypercalcemia. This manifests clinically with polyuria due to a nephrogenic diabetes insipidus-like effect on renal tubules, and mild hypertension secondary to calcium-induced vascular smooth muscle contraction.
Beyond calcium derangements, pulmonary involvement is the most common manifestation of sarcoidosis, explaining this patient's bilateral crackles and interstitial infiltrates. Patients often present with an insidious onset of dry cough and dyspnea. Diagnosis typically requires transbronchial biopsy demonstrating the characteristic granulomas, alongside exclusion of other granulomatous diseases like tuberculosis. First-line treatment for symptomatic pulmonary sarcoidosis or hypercalcemia involves systemic glucocorticoids, which rapidly reduce granulomatous inflammation and decrease abnormal vitamin D conversion. Additionally, patients with chronic hypercalcemia and hypercalciuria are at significant risk for developing calcium oxalate nephrolithiasis, making routine monitoring of renal function and serum angiotensin-converting enzyme levels useful in disease management.

Why the Other Choices Are Wrong
- Sarcoidosis causes parathyroid hormone-independent hypercalcemia due to the production of 1-alpha-hydroxylase by activated macrophages within noncaseating granulomas.
- This enzyme converts 25-hydroxyvitamin D to active calcitriol, leading to increased intestinal calcium absorption and hypercalcemia.
Choice B: Local resorption of bone by metastases occurs in malignancies that spread to the skeletal system, such as breast or prostate cancer. Osteolytic lesions cause localized bone destruction and calcium release into the bloodstream, typically presenting with severe, localized bone pain and elevated alkaline phosphatase. This patient's lack of focal bone pain and presence of bilateral hilar lymphadenopathy make metastatic bone disease unlikely.
Choice C: Parathyroid hormone-related peptide secretion is a common cause of humoral hypercalcemia of malignancy, most classically associated with squamous cell carcinoma of the lung. This peptide mimics normal parathyroid hormone, leading to increased bone resorption and renal calcium reabsorption. While this patient has lung findings, the bilateral hilar lymphadenopathy and interstitial infiltrates strongly favor sarcoidosis over a primary squamous cell lung malignancy.
Choice D: Secretion of parathyroid hormone from an adenoma or hyperplastic gland causes primary hyperparathyroidism. This condition typically presents with hypercalcemia, hypophosphatemia, and elevated or inappropriately normal parathyroid hormone levels. This patient's explicitly decreased serum parathyroid hormone concentration directly rules out primary hyperparathyroidism as the etiology of her hypercalcemia.
Choice E: Secretion of thyroid-stimulating hormone from a pituitary adenoma causes secondary hyperthyroidism. Severe thyrotoxicosis can occasionally cause mild hypercalcemia due to increased bone turnover driven by excess thyroid hormone. However, patients typically present with weight loss, heat intolerance, tremors, and tachycardia. This patient's normal pulse rate, prominent pulmonary findings, and lack of hypermetabolic symptoms make a thyrotropin-secreting tumor unlikely.
Video Review: Familial Hypocalciuric Hypercalcemia
Block 3, Question 10
Correct Answer: C. LipaseExplanation
This 34-year-old man presents with chronic abdominal pain, significant weight loss, and steatorrhea (copious, oily, foul-smelling stools) in the setting of recurrent acute pancreatitis since early adulthood. The absence of bloody stools and a negative fecal occult blood test make an inflammatory or neoplastic process unlikely. His presentation indicates exocrine pancreatic insufficiency causing severe fat malabsorption, which is best treated with lipase.
Recurrent episodes of acute pancreatitis lead to progressive parenchymal inflammation, fibrosis, and irreversible destruction of the pancreas. This structural damage eventually causes exocrine pancreatic insufficiency due to the profound loss of enzyme-producing acinar cells. While the pancreas secretes multiple digestive enzymes, fat malabsorption typically presents earliest and most severely. This occurs because the digestion of dietary triglycerides relies almost entirely on pancreatic enzymes, whereas protein and carbohydrate digestion are supported by gastric, salivary, and intestinal brush border enzymes. Consequently, patients develop profound steatorrhea and fat-soluble vitamin deficiencies, necessitating targeted enzyme replacement therapy.
Management of this condition requires pancreatic enzyme replacement therapy, which contains a mixture of all three major digestive enzymes but is dosed and titrated specifically based on its lipase content. Because exogenous lipase is rapidly denatured by gastric acid, these supplements are typically enteric-coated or co-administered with a proton pump inhibitor to ensure delivery of active enzymes to the duodenum. Beyond malabsorption, progressive glandular fibrosis also destroys the islets of Langerhans. Consequently, these patients require routine monitoring for pancreatogenic diabetes, a unique form of diabetes mellitus characterized by the loss of both insulin and glucagon.
Key TakeawayWhy the Other Choices Are Wrong
- Chronic pancreatitis leads to exocrine pancreatic insufficiency, presenting with weight loss and steatorrhea due to acinar cell destruction.
- Lipase replacement is the most critical intervention because fat digestion relies almost exclusively on pancreatic enzymes.
Choice A: Amylase is a digestive enzyme responsible for the breakdown of complex carbohydrates into oligosaccharides and disaccharides. Carbohydrate malabsorption typically presents with watery, acidic diarrhea, flatulence, and abdominal bloating due to osmotic fluid shifts and bacterial fermentation of unabsorbed sugars. Although this patient has bloating, his oily, foul-smelling stools specifically indicate fat malabsorption rather than isolated carbohydrate malabsorption, making amylase supplementation insufficient.
Choice B: Lactase is a brush border enzyme located in the small intestine that hydrolyzes lactose into glucose and galactose. Lactase deficiency causes lactose intolerance, characterized by osmotic diarrhea, abdominal cramping, and severe flatulence following the ingestion of dairy products. This patient's history of recurrent pancreatitis, profound weight loss, and distinctly oily, foul-smelling stools point to pancreatic exocrine failure rather than a brush border enzyme deficiency.
Choice D: Protease enzymes, including trypsin and chymotrypsin, are secreted by the pancreas to facilitate the breakdown of dietary proteins. Protein malabsorption can lead to severe weight loss, muscle wasting, and hypoalbuminemia, manifesting clinically as peripheral edema. While this patient likely has concurrent protein malabsorption, his prominent steatorrhea indicates that fat malabsorption is the primary driver of his symptoms, making lipase the more critical intervention.
Choice E: Tryptase is a neutral protease stored in mast cell granules and released alongside histamine during anaphylactic reactions. Elevated serum tryptase is used clinically as a marker for mast cell activation, helping confirm anaphylaxis or diagnose systemic mastocytosis, which can cause flushing and diarrhea. This patient's chronic gastrointestinal symptoms and recurrent pancreatitis are unrelated to mast cell degranulation, and tryptase is not a digestive enzyme supplement.
Video Review: Chronic Pancreatitis
Block 3, Question 11
Correct Answer: C. Eradication of intestinal organismsExplanation
This 46-year-old man presents with fever, right upper quadrant pain, and a hypoechoic liver lesion following recent travel to India. These findings are highly suspicious for an amebic liver abscess caused by Entamoeba histolytica, which requires dual therapy with a tissue amebicide and a luminal agent for the eradication of intestinal organisms.
Infection with Entamoeba histolytica typically occurs following ingestion of cysts from fecally contaminated food or water. After excystation in the terminal ileum, the trophozoites colonize the colon and can subsequently invade the colonic mucosa, traveling through the portal venous system to cause an amebic liver abscess. Treatment of invasive amebiasis requires a two-pronged pharmacological approach. First, a systemic tissue amebicide like metronidazole is administered to eliminate the invasive trophozoites within the liver abscess and intestinal wall. However, systemic agents are poorly concentrated in the gut lumen, necessitating the addition of a luminal amebicide to prevent relapse.
Paromomycin is a nonabsorbable aminoglycoside antibiotic that acts locally within the gastrointestinal tract to eradicate asymptomatic cyst colonization, thereby preventing future invasive disease and transmission. Alternative luminal agents include iodoquinol or diloxanide furoate. Diagnosis of an amebic liver abscess is typically confirmed with serology, as stool microscopy is often negative in extraintestinal disease. Needle aspiration is rarely required but classically yields a reddish-brown fluid resembling anchovy paste. Unlike pyogenic liver abscesses, amebic abscesses are generally treated medically rather than with surgical drainage unless there is an imminent risk of rupture into the pleural or peritoneal space.
Key TakeawayWhy the Other Choices Are Wrong
- Treatment of amebic liver abscesses requires a systemic tissue amebicide (metronidazole) to treat the invasive disease, followed by a luminal agent (paromomycin) to eradicate intestinal cysts.
- Paromomycin is a nonabsorbable aminoglycoside that prevents disease relapse and transmission.
Choice A: Avoidance of drug resistance development is the rationale for multi-drug regimens in infections like tuberculosis or HIV. In these conditions, high mutation rates combined with selective pressure from single-agent therapy rapidly lead to resistant strains, necessitating concurrent use of agents with different mechanisms of action. This patient's amebic liver abscess requires dual therapy to target organisms in different anatomic compartments, not to prevent resistance to metronidazole.
Choice B: Effective penetration into the liver is a necessary pharmacokinetic property for drugs treating hepatic infections. Tissue amebicides must achieve high concentrations in the hepatic parenchyma and abscess cavity to effectively eradicate invasive trophozoites causing right upper quadrant pain and fever. This patient's metronidazole serves this exact function by penetrating the liver lesion, whereas paromomycin remains confined to the gastrointestinal tract due to poor systemic absorption.
Choice D: Prevention of central nervous system infection is a consideration for pathogens that frequently disseminate to the brain. While extraintestinal amebiasis can rarely spread hematogenously to cause brain abscesses, this is an exceptionally uncommon complication. This patient's paromomycin is administered specifically because it is poorly absorbed, meaning it cannot cross the blood-brain barrier to prevent central nervous system dissemination.
Video Review: Entamoeba
Block 3, Question 12
Correct Answer: D. RhabdomyosarcomaExplanation
This 3-year-old boy presents with acute-onset unilateral exophthalmos and eye pain in the setting of a retrobulbar mass involving the extraocular muscles. Biopsy of the lesion reveals malignant cells with cross-striations, indicating a neoplasm of skeletal muscle origin. In a young child, an orbital mass exhibiting skeletal muscle differentiation is highly characteristic of rhabdomyosarcoma.
Rhabdomyosarcoma is the most common soft tissue sarcoma in the pediatric population, arising from immature mesenchymal cells committed to skeletal muscle differentiation. The embryonal subtype is the most frequent variant and has a strong predilection for the head and neck region, particularly the orbit, explaining this patient's rapid-onset proptosis. Histopathological evaluation classically demonstrates primitive spindle cells, and cytoplasmic cross-striations are a hallmark finding confirming the tumor's myogenic origin. Diagnosis is supported by positive immunohistochemical staining for desmin, an intermediate filament found in muscle tissue.
While the orbital variant often presents early due to visible anatomical changes, another major variant is the alveolar subtype, which typically affects adolescent extremities and carries a worse prognosis. This aggressive form is strongly associated with a t(2;13) chromosomal translocation, leading to the fusion of PAX3 and FOXO1 genes. Management of pediatric soft tissue sarcomas requires a multimodal approach involving surgical resection, chemotherapy, and radiation. Fortunately, orbital tumors often have a favorable prognosis because their striking clinical presentation prompts early medical intervention before distant metastasis occurs.
Key TakeawayWhy the Other Choices Are Wrong
- Rhabdomyosarcoma is the most common pediatric soft tissue sarcoma and frequently presents as an orbital mass causing unilateral exophthalmos.
- Diagnosis is confirmed by biopsy showing malignant cells with skeletal muscle cross-striations and positive immunohistochemical staining for desmin.
Choice A: Neuroblastoma is a pediatric malignancy of neural crest origin that typically arises in the adrenal medulla or along the sympathetic chain. Patients often present with an abdominal mass, elevated urinary catecholamines, and occasionally periorbital ecchymoses from orbital metastasis. This patient's primary ocular muscle mass with histologic striations, rather than a metastatic lesion with Homer-Wright rosettes, makes neuroblastoma unlikely.
Choice B: Pheochromocytoma is a catecholamine-secreting tumor of the adrenal medulla derived from chromaffin cells. The classic presentation includes episodic headaches, diaphoresis, and tachycardia, often accompanied by severe hypertension. This patient's normal vital signs, prepubescent age, and presence of a primary orbital mass with skeletal muscle striations strongly argue against a catecholamine-secreting adrenal tumor.
Choice C: Retinoblastoma is the most common primary intraocular malignancy of childhood, caused by a mutation in the RB1 tumor suppressor gene. The classic clinical sign is leukocoria (an abnormal white pupillary reflex), often accompanied by strabismus. Histology typically reveals Flexner-Wintersteiner rosettes. This patient's presentation with an extraocular muscle mass causing exophthalmos and a biopsy showing cross-striations, rather than an intraocular mass, rules out retinoblastoma.
Choice E: Thyroid cancer encompasses several subtypes that typically present as an asymptomatic anterior neck mass or thyroid nodule. While autoimmune hyperthyroidism can cause exophthalmos due to retro-orbital fibroblast proliferation and extraocular muscle swelling, thyroid malignancies do not present as isolated orbital masses. This patient's localized extraocular muscle tumor with skeletal muscle striations and lack of a primary neck mass make thyroid cancer unlikely.
Block 3, Question 13
Correct Answer: E. Staphylococcus aureusExplanation
This 37-year-old man presents with fever, tachycardia, tachypnea, borderline hypotension, and leukocytosis four days after sustaining a puncture wound to his hand that failed topical antibacterial therapy. His local exam shows a necrotic wound with surrounding erythema, and his low arterial PCO2 reflects a primary respiratory alkalosis driven by hyperventilation. This severe skin and soft tissue infection rapidly progressing to sepsis is due to Staphylococcus aureus.
Staphylococcus aureus is a Gram-positive, catalase-positive, coagulase-positive coccus that is the leading cause of purulent skin and soft tissue infections. Following a breach in the skin barrier, the bacteria rapidly proliferate and secrete virulence factors like alpha-toxin, which forms pores in cell membranes leading to tissue necrosis. The localized infection can disseminate, resulting in bacteremia and septic shock, characterized by massive cytokine release. This systemic inflammatory response triggers peripheral vasodilation and increased capillary permeability, leading to the patient's hypotension and compensatory tachycardia. The resulting poor tissue perfusion often causes a lactic acidosis.
In addition to direct tissue destruction, certain strains of this pathogen produce superantigens like toxic shock syndrome toxin-1, which cross-link the T-cell receptor to the major histocompatibility complex class II on macrophages. This causes an uncoordinated release of interferon-gamma and interleukin-2, precipitating sudden and profound hemodynamic collapse. The patient's acute shortness of breath may also represent early acute respiratory distress syndrome, a severe complication of widespread endothelial damage. Initial management of such severe, potentially methicillin-resistant infections requires prompt source control and broad-spectrum empiric antibiotics such as intravenous vancomycin to ensure adequate coverage.
Why the Other Choices Are Wrong
- Staphylococcus aureus is the leading cause of purulent skin infections, which can rapidly progress to life-threatening sepsis.
- Sudden systemic deterioration following localized necrosis suggests massive cytokine release or toxin-mediated virulence.
Choice A: Clostridium tetani causes tetanus, a neurologic disease characterized by severe muscle spasms, trismus, and autonomic instability. It is classically transmitted via puncture wounds contaminated with soil or rust. This patient's prominent local tissue necrosis, diffuse swelling, and rapid progression to vasodilatory shock make C. tetani unlikely, as tetanus typically lacks significant local inflammation and presents primarily with spastic paralysis.
Choice B: Mycobacterium abscessus is a rapidly growing, nontuberculous mycobacterium that causes chronic skin and soft tissue infections following trauma or surgery. Infections typically present as erythematous, tender nodules that may ulcerate or form abscesses over weeks to months. This patient's acute presentation of a necrotic wound and rapid onset of severe systemic toxicity within four days make this indolent pathogen unlikely.
Choice C: Pasteurella multocida is a Gram-negative coccobacillus that causes rapid-onset cellulitis, often within 24 hours of an inoculation event. It is classically associated with animal bites or scratches, particularly from cats or dogs. This patient's occupation as a carpenter and the lack of any reported animal exposure make a classic wound infection much more likely than P. multocida.
Choice D: Pseudomonas aeruginosa is a Gram-negative, oxidase-positive rod that causes severe skin infections, such as ecthyma gangrenosum in immunocompromised patients or osteomyelitis following puncture wounds through rubber-soled shoes. While it can cause necrosis, this patient's injury occurred on the hand rather than the foot, making a ubiquitous skin colonizer the more probable etiology for his acute sepsis.
Block 3, Question 14
Correct Answer: C. T1Explanation
This 24-year-old woman presents with lower extremity upper motor neuron signs (hyperreflexia, spasticity, Babinski sign), bilateral hand weakness with intrinsic muscle atrophy, and sensory loss below the clavicles following spinal trauma. The combination of lower motor neuron findings in the hands with preserved biceps and triceps reflexes localizes the injury to the lower cervical or upper thoracic spine, specifically at T1.
Spinal cord trauma produces lower motor neuron signs at the level of injury due to anterior horn damage and upper motor neuron signs below the lesion. This patient's bilateral intrinsic hand muscle atrophy indicates focal destruction at the C8-T1 level. However, her preserved biceps and triceps reflexes confirm that the C5-C8 segments are functionally intact, localizing the injury specifically to T1. Additionally, damage to the descending lateral corticospinal tract at T1 causes the observed spasticity and hyperreflexia in the lower extremities, while disruption of the ascending spinothalamic tract explains the loss of pinprick sensation.
The sensory examination corroborates this localization. The C4 dermatome covers the clavicles, while C5-T1 extend down the upper extremities. The T2 dermatome covers the upper chest immediately below the clavicles, perfectly matching this patient's anesthesia to pinprick. Patients with high thoracic spinal cord injuries are at significant risk for autonomic dysreflexia, a life-threatening sympathetic response triggered by noxious stimuli below the lesion. Management requires immediate removal of the stimulus, most commonly a distended neurogenic bladder, and administration of rapid-acting antihypertensive agents if blood pressure remains dangerously elevated.

Why the Other Choices Are Wrong
- Spinal cord lesions produce lower motor neuron signs at the level of injury and upper motor neuron signs below the lesion.
- Intrinsic hand muscle atrophy with preserved biceps and triceps reflexes localizes a lesion specifically to the T1 spinal level.
Choice A: A C5 spinal cord lesion causes lower motor neuron signs in the shoulder and upper arm. Patients typically exhibit weakness in shoulder abduction and elbow flexion, along with an absent or diminished biceps reflex, which is mediated by the C5 and C6 nerve roots. This patient's normal biceps reflexes and lack of proximal upper extremity weakness make a C5 lesion unlikely.
Choice B: A C7 spinal cord lesion affects the lower cervical spine, impacting the innervation of the posterior arm and forearm. This injury characteristically produces lower motor neuron signs such as weakness in elbow extension and wrist flexion, accompanied by an absent or diminished triceps reflex. This patient's normal triceps reflexes and isolated intrinsic hand muscle atrophy make a C7 lesion unlikely.
Choice D: A T3 spinal cord lesion occurs in the upper thoracic spine, below the brachial plexus. Injury at this level causes upper motor neuron signs in the lower extremities and a sensory level at the third intercostal space, but it completely spares all upper extremity motor and reflex functions. This patient's bilateral intrinsic hand muscle atrophy makes a T3 lesion unlikely.
Choice E: A T5 spinal cord lesion localizes to the mid-thoracic region, well below the brachial plexus. This injury produces lower extremity spasticity, hyperreflexia, and a sensory level at the fifth intercostal space (just below the nipples), with completely normal upper extremity function. This patient's profound hand weakness, intrinsic muscle atrophy, and higher sensory loss make a T5 lesion unlikely.
Video Review: Descending Spinal Cord Tracts
Block 3, Question 15
Correct Answer: D. FEV1: 84, FVC: 78, Total Lung Capacity: 78, Diffusing Capacity: 92Explanation
This 33-year-old man presents with progressive exertional dyspnea, severe obesity (BMI 46 kg/m²), and a normal pulmonary examination without evidence of intrinsic lung disease. His clear lungs, normal oxygen saturation, and lack of smoking history point to an extrapulmonary restrictive lung defect caused by excess chest wall adiposity, which is best represented by FEV1: 84, FVC: 78, Total Lung Capacity: 78, Diffusing Capacity: 92.
Severe obesity causes an extrapulmonary restrictive pattern due to the physical mass of adipose tissue on the thorax and a protuberant abdomen pushing against the diaphragm. This mechanical load decreases chest wall compliance, leading to a reduction in total lung capacity to below 80% of predicted. Because the lung parenchyma itself is unaffected, airway resistance remains normal, resulting in a proportional decrease in both forced expiratory volume in 1 second and forced vital capacity. Consequently, the FEV1/FVC ratio remains normal or is slightly increased, distinguishing this extrapulmonary restriction from obstructive lung diseases.
A hallmark of obesity-related restrictive lung disease is a preserved diffusing capacity of the lungs for carbon monoxide, as the alveolar-capillary membrane remains intact. This contrasts with intrinsic fibrotic lung diseases, which destroy the pulmonary vasculature and impair gas exchange. The most characteristic volume change in obese patients is a marked reduction in expiratory reserve volume, which can lead to airway closure during normal tidal breathing and subsequent microatelectasis. Despite the exertional dyspnea and mild hypertension, this patient's normal resting oxygen saturation indicates that alveolar ventilation is currently sufficient to maintain systemic oxygenation.
Key TakeawayWhy the Other Choices Are Wrong
- Severe obesity causes an extrapulmonary restrictive lung pattern characterized by reduced total lung capacity, proportional decreases in FEV1 and FVC, and a normal FEV1/FVC ratio.
- Diffusing capacity for carbon monoxide (DLCO) remains normal in obesity-related restriction, distinguishing it from intrinsic interstitial lung diseases.
Choice A: FEV1: 19, FVC: 40, Total Lung Capacity: 110, Diffusing Capacity: 35 represents a severe obstructive pattern with hyperinflation and impaired gas exchange. Emphysema classically presents with a markedly reduced FEV1/FVC ratio, increased total lung capacity due to air trapping, and a significantly decreased DLCO from alveolar septal destruction. This patient's lack of smoking history, clear lungs on auscultation, and normal oxygen saturation make severe emphysema unlikely.
Choice B: FEV1: 43, FVC: 40, Total Lung Capacity: 40, Diffusing Capacity: 28 indicates a severe intrinsic restrictive pattern with significantly impaired gas exchange. Interstitial lung diseases, such as idiopathic pulmonary fibrosis, cause parenchymal scarring that restricts lung expansion (low TLC) and thickens the alveolar-capillary membrane (low DLCO). This patient's normal resting oxygen saturation and clear lungs without crackles rule out a severe fibrotic interstitial lung disease.
Choice C: FEV1: 65, FVC: 76, Total Lung Capacity: 96, Diffusing Capacity: 70 demonstrates an obstructive pattern (FEV1 reduced out of proportion to FVC) with a mildly reduced diffusing capacity. This pattern can be seen in conditions like chronic bronchitis, where airway inflammation causes airflow limitation and mild gas exchange abnormalities. This patient's lack of chronic cough, absence of smoking history, and clear lungs make an obstructive pulmonary disorder unlikely.
Choice E: FEV1: 95, FVC: 102, Total Lung Capacity: 98, Diffusing Capacity: 89 represents completely normal pulmonary function testing across all parameters. Healthy individuals without cardiopulmonary disease or significant mechanical restrictions to breathing will display lung volumes, airflow rates, and diffusing capacities within 80-120% of their predicted values. This patient's severe obesity and progressive exertional dyspnea make entirely normal pulmonary function tests highly unlikely, as adiposity predictably reduces lung volumes.
Video Review: Restrictive Lung Disease
Block 3, Question 16
Correct Answer: C. Decreased vaginal rugationExplanation
This 67-year-old woman presents with a 6-month history of decreased libido and a history of menopause at age 51. Her lack of psychosocial stressors suggests an organic etiology, most likely genitourinary syndrome of menopause, which often causes dyspareunia that patients secondarily interpret as low sexual desire. Physical examination of this condition classically reveals decreased vaginal rugation.
Genitourinary syndrome of menopause occurs due to a profound drop in estrogen following the cessation of ovarian function. Estrogen maintains the collagen content and epithelial thickness of the urogenital tract. Without it, the vaginal mucosa becomes thin, pale, and dry, leading to the flattening of mucosal folds and decreased rugae. Patients frequently experience dyspareunia, which can cause secondary sexual avoidance and decreased libido despite a healthy relationship, alongside a notable increase in vaginal pH and a reduction in protective lactobacilli.
Management of vulvovaginal atrophy depends on symptom severity. First-line therapy includes non-hormonal vaginal moisturizers and lubricants to alleviate friction during intercourse. If symptoms persist, topical vaginal estrogen is the most effective pharmacologic treatment, directly restoring mucosal integrity with minimal systemic absorption. Alternatively, patients may use ospemifene, a selective estrogen receptor modulator that improves mucosal thickness. Because postmenopausal women experience generalized urogenital atrophy, they are at increased risk for recurrent urinary tract infections due to the altered flora, making prompt recognition of this syndrome essential.

Why the Other Choices Are Wrong
- Genitourinary syndrome of menopause causes vulvovaginal atrophy, presenting with decreased vaginal rugation, mucosal pallor, and elevated vaginal pH.
- Dyspareunia from this atrophy often leads to secondary decreased libido and sexual avoidance in postmenopausal women.
Choice A: Bulging of the anterior vaginal wall through the introitus describes a cystocele, which occurs due to a defect in the pubocervical fascia. This condition classically presents with pelvic pressure, a palpable mass, and urinary symptoms such as stress incontinence or incomplete emptying. This patient's complete lack of urinary symptoms makes a cystocele unlikely.
Choice B: Bulging of the posterior vaginal wall through the introitus describes a rectocele, caused by a defect in the rectovaginal septum. Patients typically experience pelvic pressure, a sensation of a mass, and defecatory dysfunction requiring manual splinting to complete bowel movements. This patient's normal bowel movements make a rectocele unlikely.
Choice D: Palpable ovaries bilaterally is an abnormal finding in postmenopausal women. During the reproductive years, ovaries are palpable, but following menopause, they undergo significant atrophy and shrink considerably. If a postmenopausal patient has palpable ovaries, it strongly suggests a neoplastic process such as an ovarian malignancy, which is not indicated by this patient's presentation.
Choice E: Uterine size of 8 cm represents a normal premenopausal uterus. Following menopause, the lack of estrogen stimulation causes the myometrium and endometrium to undergo significant atrophy, resulting in a much smaller uterine volume. A normal-sized or enlarged uterus in a 67-year-old woman would suggest pathology such as fibroids or malignancy rather than normal postmenopausal changes.
Video Review: Pregnancy and Menstruation
Block 3, Question 17
Correct Answer: E. "What is your understanding of what your hemoglobin A1c should be?"Explanation
This 47-year-old woman presents with a 35-year history of type 1 diabetes mellitus and a markedly elevated hemoglobin A1c of 12%, stating she hopes this level is acceptable. Her comment indicates a fundamental lack of knowledge regarding disease management goals, requiring an assessment of her baseline health literacy before addressing treatment modifications. The most appropriate initial response is to ask, "What is your understanding of what your hemoglobin A1c should be?"
The patient's statement reveals a significant discrepancy between clinical reality and her personal perception of disease control. A hemoglobin A1c of 12% reflects severely uncontrolled diabetes, yet she expresses hope that this value is acceptable. Before adjusting medications or discussing lifestyle modifications, the physician must first gauge her health literacy to appropriately tailor subsequent education. Utilizing open-ended questions allows the clinician to explore the patient's knowledge base without being confrontational or judgmental. Establishing this baseline understanding is a core tenet of patient-centered interviewing, which prioritizes exploring the patient's unique perspective before formulating a shared, effective management plan.
Once the patient's baseline understanding is established, the physician can educate her that the general target for most non-pregnant adults is a hemoglobin A1c less than 7 percent. Chronic elevation at 12% significantly increases the risk of long-term microvascular complications, such as retinopathy, nephropathy, and neuropathy. After providing this targeted education, the physician should employ the teach-back method to ensure complete comprehension of the newly established goals. Only after achieving a shared understanding of the target should the clinician explore specific barriers to glycemic control, such as insulin adherence, dietary habits, or psychosocial stressors.
Key TakeawayWhy the Other Choices Are Wrong
- When a patient demonstrates a fundamental misunderstanding of their disease, the physician must first assess baseline health literacy using open-ended questions.
- Exploring specific barriers to care should only occur after establishing a shared understanding of treatment goals.
Choice A: Asking "Do you ever skip a dose of insulin?" attempts to identify a specific behavioral cause for poor glycemic control. Assessing medication adherence is a critical component of diabetes management, as missed insulin doses directly cause hyperglycemia and elevate hemoglobin A1c. This patient's statement reveals a foundational misunderstanding of her target laboratory values, making an immediate inquiry into medication adherence premature until her knowledge deficit is addressed.
Choice B: Stating "Noncompliance in your disease can be deadly" utilizes a paternalistic and confrontational approach to patient communication. Using fear-based tactics or accusatory language damages the therapeutic alliance, increases patient defensiveness, and generally fails to motivate long-term behavioral change in chronic disease management. This patient's comment suggests a lack of education rather than intentional noncompliance, making this hostile response highly inappropriate and counterproductive to establishing a collaborative physician-patient relationship.
Choice C: Asking "Please inform me of any recent traumas or stresses that would be contributing to your poor compliance" explores psychosocial barriers to care. Acute stress or trauma can elevate counterregulatory hormones like cortisol and epinephrine, worsening hyperglycemia, while also negatively impacting a patient's ability to adhere to complex medical regimens. This patient's explicit uncertainty about her hemoglobin A1c goal indicates a primary educational deficit, making an investigation into psychosocial stressors a secondary step.
Choice D: Asking "Tell me about the kinds of foods you eat" is an open-ended inquiry into the patient's dietary habits. Nutritional counseling is an essential pillar of diabetes care, as excessive carbohydrate intake directly contributes to sustained hyperglycemia and elevated hemoglobin A1c levels. This patient's belief that a 12% hemoglobin A1c might be acceptable must be corrected first; exploring dietary habits is a subsequent step in management once she actually understands her glycemic targets.
Video Review: Interviewing Patients
Block 3, Question 18
Correct Answer: D. Less chance of a Type II errorExplanation
This scenario describes a study evaluating the effect of finasteride on prostate cancer incidence in which investigators increase the sample size from 500 to 1500 patients. Expanding the number of participants increases the statistical power to detect a true difference between the experimental and control groups, directly resulting in a less chance of a Type II error.
A Type II error occurs when investigators fail to reject a false null hypothesis, missing a true clinical effect. The probability of this error is denoted as beta. Statistical power represents the probability of correctly identifying a true difference and is defined as one minus beta. Because power and beta are inversely related, increasing power inherently decreases the likelihood of a Type II error. The most direct method to increase power is expanding the sample size. Enrolling more subjects provides a precise estimate of population parameters, narrowing the standard error and improving detection capabilities.
While participant numbers heavily influence power, they do not alter the probability of a Type I error. This error occurs when researchers incorrectly reject a true null hypothesis, creating a false positive. The maximum acceptable risk for this error is defined by the significance level, or alpha, predetermined before data collection. Because alpha is a fixed threshold, adding more participants does not change it. Other critical factors influencing a study's power include the expected effect size, representing the magnitude of difference between groups, and the underlying variance within the measured population data.
Key TakeawayWhy the Other Choices Are Wrong
- Increasing a study's sample size increases its statistical power to detect a true difference between groups.
- Because power is mathematically defined as 1 - beta, increasing sample size directly decreases the probability of committing a Type II (beta) error.
Choice A: A greater chance of a Type I error means an increased probability of falsely concluding that finasteride affects prostate cancer incidence when it does not. The risk of this false positive error is determined entirely by the alpha level, an arbitrary threshold set prior to the study. This study's addition of 1000 patients does not alter the predetermined alpha level, making a change in Type I error probability unlikely.
Choice B: A greater chance of a Type II error indicates an increased likelihood of missing a true association between finasteride and prostate cancer. This false negative error becomes more common when a study lacks sufficient statistical power, frequently occurring with too few participants or high population variability. This study's expansion from 500 to 1500 patients increases rather than decreases statistical power, making a higher risk of this error unlikely.
Choice C: A less chance of a Type I error implies a reduced risk of falsely rejecting a true null hypothesis. To decrease this false positive risk, researchers must intentionally lower the alpha level during the study design phase, requiring stronger evidence to declare statistical significance. This study's intervention involves recruiting more patients rather than adjusting the predetermined alpha threshold, making a decreased Type I error rate unlikely.
Choice E: An impossible to predict outcome suggests that changing the number of participants has an unknown effect on statistical error rates. While certain parameters are unknown until data analysis, the mathematical relationship between participant numbers, power, and beta error is well-defined. This study's specific modification of adding 1000 patients has a direct mathematical consequence on statistical power, making the effect entirely possible to predict.
Video Review: Statistical Testing
Block 3, Question 19
Correct Answer: D. Ureteropelvic junctionExplanation
This 56-year-old woman presents with chronic left flank pain and recurrent urinary tract infections, with imaging demonstrating left-sided hydronephrosis and a dilated renal pelvis that abruptly narrows before the ureter. These findings indicate a proximal obstruction of the urinary tract leading to urinary stasis and subsequent infections, specifically localizing the defect to the ureteropelvic junction.
The ureteropelvic junction is the most common site of unilateral fetal hydronephrosis, but it can also present or become symptomatic in adulthood. Primary ureteropelvic junction obstruction typically results from an abnormal smooth muscle arrangement at the junction of the renal pelvis and the proximal ureter, leading to aperistaltic segments that impede forward urine flow. Alternatively, it can be secondary to crossing renal vessels that externally compress the ureter. The resulting urinary stasis predisposes patients to recurrent urinary tract infections and nephrolithiasis. The provided T2-weighted MRI clearly demonstrates a dilated, hyperintense fluid-filled renal pelvis that abruptly tapers, confirming the anatomic level of the blockage.
If left untreated, chronic obstruction at this level causes progressive back-pressure that can lead to renal parenchyma atrophy and irreversible loss of kidney function. Patients with symptomatic presentations, such as recurrent infections or intractable flank pain, require surgical intervention. The definitive treatment is a pyeloplasty, which involves excising the stenotic segment and reanastomosing the normal ureter to the renal pelvis. When the diagnosis or severity of obstruction is equivocal on standard imaging, diuretic renography is utilized to assess the functional significance of the blockage and measure the relative glomerular filtration rate of the affected kidney.
Key TakeawayWhy the Other Choices Are Wrong
- Ureteropelvic junction obstruction is a common cause of unilateral hydronephrosis, often presenting with flank pain and recurrent urinary tract infections due to urinary stasis.
- Imaging demonstrates a dilated renal pelvis with abrupt tapering and a normal-caliber ureter distally.
Choice A: Bladder neck obstruction occurs at the junction of the bladder and urethra, most commonly due to benign prostatic hyperplasia in men or pelvic organ prolapse in women. This condition classically causes lower urinary tract symptoms such as hesitancy, poor stream, and incomplete emptying, eventually leading to bilateral hydronephrosis. This patient's strictly unilateral left-sided hydronephrosis and lack of lower urinary tract symptoms make a bladder neck lesion unlikely.
Choice B: Mid ureter obstructions can occur due to ureteral calculi, strictures, or extrinsic compression from retroperitoneal masses or fibrosis. Blockage at this level typically causes proximal dilation of the ureter above the obstruction in addition to hydronephrosis. This patient's MRI demonstrates a dilated renal pelvis with an abrupt cutoff before the ureter begins, indicating the obstruction is more proximal than the mid ureter.
Choice C: Renal calyx obstruction involves a blockage within the intrarenal collecting system, often secondary to a calyceal stone, stricture, or urothelial neoplasm. An isolated calyceal obstruction produces focal dilation of a single calyx, known as hydrocalyx, while the rest of the renal pelvis and ureter remain normal. This patient's imaging shows widespread dilation of the entire left renal pelvis rather than an isolated calyceal dilation.
Choice E: Ureterovesical junction obstruction occurs where the distal ureter enters the bladder, often due to congenital strictures, distal ureteral stones, or bladder tumors. An obstruction at this distal location characteristically produces hydroureter, which is a dilation of the entire ureter, along with proximal hydronephrosis. This patient's imaging lacks ureteral dilation, localizing the obstruction much higher in the urinary tract.
Block 3, Question 20
Correct Answer: G. MyofibroblastsExplanation
This 53-year-old woman presents with a recurrent, enlarging subcutaneous mass on her chest at the site of a prior resection. The clinical history of a growing lesion following skin trauma, combined with histology showing dense, haphazardly arranged collagen bundles and spindle-shaped cells, indicates a keloid scar. Keloids result from excessive collagen production driven by myofibroblasts.
Keloids are benign fibroproliferative tumors that arise from abnormal wound healing, extending beyond the boundaries of the original injury. They most commonly occur on the upper chest, shoulders, and earlobes. Following tissue trauma, the proliferative phase of wound healing involves fibroblasts differentiating into contractile cells under the influence of transforming growth factor-beta. These specialized spindle-shaped cells possess contractile properties mediated by alpha-smooth muscle actin and are responsible for wound contraction and extracellular matrix synthesis. In keloids, these cells fail to undergo apoptosis, leading to continuous, unregulated deposition of disorganized type I and type III collagen.
It is critical to distinguish keloids from hypertrophic scars, which also manifest as raised lesions following trauma. Unlike keloids, hypertrophic scars remain confined to the original wound margins and typically regress spontaneously over time. Histologically, hypertrophic scars feature parallel collagen fibers, whereas keloids display thick, haphazardly arranged eosinophilic bands known as keloidal collagen. Management of keloids is notoriously difficult due to high recurrence rates following surgical excision, as seen in this patient. First-line therapy typically involves intralesional corticosteroid injections, which suppress fibroproliferation. For refractory cases, surgical excision combined with postoperative radiation therapy may be required.
Key TakeawayWhy the Other Choices Are Wrong
- Keloids are characterized by excessive, disorganized type I and III collagen deposition extending beyond the original wound margins.
- They are driven by the unregulated proliferation and matrix synthesis of myofibroblasts, which appear as spindle-shaped cells embedded in dense eosinophilic collagen.
Choice A: Macrophages are phagocytic innate immune cells that orchestrate the inflammatory and proliferative phases of wound healing by clearing debris and secreting cytokines. While they secrete the growth factors that stimulate fibroproliferation, they are not the spindle-shaped cells directly responsible for synthesizing the dense collagen bundles seen in this patient's biopsy.
Choice B: Mast cells are tissue-resident granulocytes involved in allergic responses and wound healing through the release of histamine and tryptase. Patients with systemic mastocytosis or mast cell tumors typically present with pruritus, urticaria, and a positive Darier sign. This patient's subcutaneous mass with dense collagen deposition makes a mast cell-driven lesion unlikely.
Choice C: Melanocytic cells are neural crest-derived pigment-producing cells located in the stratum basale. Patients with malignant proliferation of these cells (melanoma) classically present with an asymmetric, irregularly bordered, variably colored, and evolving skin lesion. This patient's skin-colored mass at a prior surgical site with haphazard collagen bundles makes a melanocytic neoplasm unlikely.
Choice D: Mesothelial cells form the simple squamous epithelial lining of the pleural, peritoneal, and pericardial cavities. Malignant proliferation of these cells causes mesothelioma, a tumor strongly associated with asbestos exposure that produces pleural effusions and chest pain. This patient's superficial subcutaneous mass and lack of respiratory symptoms make a mesothelial origin impossible.
Choice E: Myeloblasts are immature granulocyte precursor cells found in the bone marrow. Extramedullary proliferation of these cells can form a solid tumor known as a myeloid sarcoma, which is associated with acute myeloid leukemia. This patient's localized scar-associated mass and lack of leukemic signs or systemic illness make a myeloblast-derived lesion unlikely.
Choice F: Myocytes are the functional cellular units of skeletal, cardiac, and smooth muscle tissue. Benign tumors of smooth muscle (leiomyomas) feature intersecting fascicles of spindle cells with blunt-ended, cigar-shaped nuclei. This patient's history of prior resection at the exact site and the presence of dense collagen bundles point to a scar-related process rather than a primary muscle tumor.
Block 4, Question 1
Correct Answer: E. Dysfunctional interferon-γ receptorsExplanation
This 13-year-old boy presents with fever, polyarticular joint pain, and left ischial osteomyelitis with Mycobacterium avium complex isolated from bone and synovial fluid. The development of disseminated atypical mycobacterial infection in an otherwise healthy, HIV-negative adolescent arises from a primary immunodeficiency affecting the macrophage-T-cell signaling axis, most commonly due to dysfunctional interferon-γ receptors.
Mendelian susceptibility to mycobacterial disease is a group of primary immunodeficiencies characterized by severe infections with weakly virulent intracellular pathogens. The underlying pathophysiology involves defects in the signaling axis between macrophages and T cells. Normally, macrophages phagocytose mycobacteria and secrete interleukin-12, which stimulates T cells and natural killer cells to produce interferon-γ. This cytokine then binds to its receptor on macrophages, activating the JAK-STAT signaling pathway to promote phagolysosome maturation and intracellular killing. Dysfunctional receptors prevent this crucial activation, rendering the patient highly susceptible to atypical mycobacteria, the Bacille Calmette-Guérin vaccine strain, and Salmonella species.
Patients with complete receptor deficiencies require continuous antimycobacterial therapy and often need hematopoietic stem cell transplantation for definitive cure. Because the receptor itself is defective, these individuals do not respond to supplemental cytokine therapy and characteristically exhibit impaired granuloma formation on tissue biopsy. In contrast, a related defect in this axis is IL-12 receptor deficiency, which presents with similar susceptibility to mycobacteria. However, because the downstream signaling components remain intact in this condition, patients can often be successfully treated with exogenous cytokine therapy to bypass the defect and directly stimulate macrophage microbicidal activity.
Key TakeawayWhy the Other Choices Are Wrong
- Mendelian susceptibility to mycobacterial disease is often caused by defects in the IL-12/IFN-γ axis, such as dysfunctional IFN-γ receptors.
- Patients present with severe, disseminated infections from weakly virulent intracellular organisms like atypical mycobacteria or Salmonella.
Choice A: Absent expression of C5 is a terminal complement deficiency. Terminal complement deficiencies (C5-C9) prevent the formation of the membrane attack complex, which is crucial for lysing encapsulated bacteria. Patients are at highly increased risk for recurrent, severe Neisseria infections, particularly meningococcal meningitis or disseminated gonococcal infection. This patient's lack of sexual activity and disseminated atypical mycobacterial infection make a terminal complement deficiency unlikely.
Choice B: Bilobed neutrophil nuclei with abnormal granule morphology are characteristic of Chediak-Higashi syndrome. This autosomal recessive disorder involves a defect in lysosomal trafficking, leading to impaired phagolysosome formation. It presents with oculocutaneous albinism, peripheral neuropathy, and recurrent pyogenic infections. This patient's presentation with a mycobacterial infection and lack of albinism or neuropathy make Chediak-Higashi syndrome unlikely.
Choice C: Decreased absolute CD8+ T-lymphocyte count occurs in major histocompatibility complex class I deficiency. This rare immunodeficiency results from mutations in TAP proteins, preventing peptide loading onto MHC class I molecules. It leads to impaired CD8+ T-cell positive selection and recurrent viral and respiratory bacterial infections. This patient's disseminated MAC infection, which is primarily controlled by macrophages and CD4+ T cells, makes an isolated CD8+ T-cell defect unlikely.
Choice D: Decreased serum concentration of IgG is seen in B-cell deficiencies such as X-linked agammaglobulinemia or common variable immunodeficiency. Humoral immunodeficiencies impair opsonization, predisposing patients to recurrent sinopulmonary infections with encapsulated bacteria and certain enteroviruses. This patient's isolated, severe infection with an intracellular pathogen like MAC points toward a cellular or phagocytic defect rather than a humoral immunodeficiency.
Block 4, Question 2
Correct Answer: C. Fetal renal hemodynamicsExplanation
This 36-year-old woman with obesity presents with secondary amenorrhea, abdominal weight gain, and an enlarged uterus consistent with a 24-week gestation due to an unrecognized pregnancy. Her use of lisinopril during the second trimester has led to fetal oligohydramnios, a small bladder, and cranial deformities, which are characteristic of ACE inhibitor fetopathy caused by disruption of fetal renal hemodynamics.
Angiotensin-converting enzyme (ACE) inhibitors are contraindicated in pregnancy due to their profound teratogenic effects, particularly during the second and third trimesters. Fetal kidneys rely on angiotensin II to maintain glomerular filtration rate by constricting the efferent arteriole. Maternal use of ACE inhibitors crosses the placenta, leading to fetal hypotension and decreased renal perfusion. This disruption results in fetal anuria and subsequent oligohydramnios, as amniotic fluid in later pregnancy is primarily composed of fetal urine. The lack of amniotic fluid causes fetal compression, leading to Potter sequence, which manifests with a misshapen cranium, limb deformities, and pulmonary hypoplasia.
Beyond renal impairment, fetal ACE inhibitor exposure causes systemic hypoperfusion due to severe hypotension. This ischemia can result in an echogenic bowel on ultrasound, representing bowel necrosis or meconium peritonitis, as well as fluid extravasation leading to pericardial effusions. Because of these severe complications, women of childbearing age with hypertension should be transitioned to safer antihypertensives before conception or as soon as pregnancy is confirmed. Preferred agents during pregnancy include labetalol, nifedipine, and methyldopa, which effectively manage maternal blood pressure without compromising fetal renal function or causing significant teratogenicity.
Key TakeawayWhy the Other Choices Are Wrong
- ACE inhibitors are teratogenic and disrupt fetal renal hemodynamics by decreasing angiotensin II levels, leading to fetal anuria and oligohydramnios.
- The resulting oligohydramnios causes Potter sequence, characterized by cranial and limb deformities, as well as pulmonary hypoplasia.
Choice A: Fetal lung epithelial differentiation is a critical component of pulmonary development that is stimulated by glucocorticoids. Primary defects in this process lead to neonatal respiratory distress syndrome, while secondary impairment occurs in Potter sequence due to a lack of amniotic fluid needed for lung expansion. This patient's maternal lisinopril use and fetal small bladder make a primary defect in fetal lung epithelial differentiation unlikely.
Choice B: Fetal lung surfactant development is an essential process for reducing alveolar surface tension and preventing neonatal respiratory distress syndrome. Surfactant production typically accelerates after 32 weeks of gestation and is characterized by an increasing lecithin-to-sphingomyelin ratio in the amniotic fluid. This patient's 24-week gestation and fetal small bladder make impaired fetal lung surfactant development unlikely.
Choice D: Maternal placental perfusion is the primary determinant of nutrient and oxygen delivery to the fetus and can be compromised by severe chronic hypertension or preeclampsia. Placental insufficiency classically presents with asymmetric fetal growth restriction, oligohydramnios, and abnormal umbilical artery Doppler waveforms. This patient's lisinopril use and fetal small bladder make impaired maternal placental perfusion unlikely.
Choice E: Maternal prostaglandin synthesis is the target of nonsteroidal anti-inflammatory drugs like indomethacin, which are sometimes used as tocolytics. Third-trimester NSAID exposure classically causes premature closure of the fetal ductus arteriosus, leading to right heart failure, and can decrease fetal renal blood flow. This patient's exclusive use of lisinopril and fetal misshapen cranium make impaired maternal prostaglandin synthesis unlikely.
Block 4, Question 3
Correct Answer: C. Massive myocardial infarctionExplanation
This 64-year-old woman presents with sudden-onset respiratory distress progressing rapidly to death within 30 minutes, accompanied by autopsy findings of alveolar hemorrhage and fluid deposition. This hyperacute presentation of severe respiratory failure and alveolar fluid accumulation is highly characteristic of acute left ventricular failure secondary to a massive myocardial infarction.
A massive myocardial infarction often involves extensive necrosis of the left ventricular myocardium, leading to a sudden loss of forward pump function. This precipitous decline in cardiac output causes an acute, severe rise in left ventricular end-diastolic pressure. The elevated pressure transmits retrogradely to the left atrium and pulmonary venous system. When pulmonary capillary hydrostatic pressure acutely exceeds plasma oncotic pressure, fluid rapidly extravasates into the interstitial and alveolar spaces. The resulting acute pulmonary edema severely impairs gas exchange, leading to profound hypoxemia, respiratory distress, and rapid death due to cardiogenic shock.
The autopsy findings of alveolar hemorrhage and proteinaceous fluid deposition reflect the extreme severity of the acute hydrostatic pressure increase. The sudden elevation in pulmonary capillary pressure causes mechanical failure of the capillary walls, leading to focal alveolar capillary rupture and subsequent microhemorrhages. Unlike chronic left heart failure, which provides time for macrophages to phagocytose red blood cells and form hemosiderin-laden macrophages, this hyperacute presentation lacks these classic "heart failure cells." Furthermore, the rapid 30-minute timeline precludes the development of the inflammatory exudates or hyaline membranes characteristic of acute respiratory distress syndrome, confirming a purely hemodynamic etiology.

Why the Other Choices Are Wrong
- Acute left ventricular failure from a massive myocardial infarction causes a sudden, severe increase in pulmonary venous hydrostatic pressure.
- This pressure gradient rapidly drives fluid and red blood cells into the alveoli, causing acute pulmonary edema, alveolar hemorrhage, and rapid death.
Choice A: Bilateral bronchopneumonia is a bacterial lung infection characterized by patchy consolidation around bronchioles. Histologically, it presents with a neutrophil-rich purulent exudate filling the alveolar spaces and bronchioles, often accompanied by fever and a productive cough over days. This patient's hyperacute 30-minute timeline to death and the lack of neutrophilic infiltrates on autopsy make bilateral bronchopneumonia unlikely.
Choice B: Bronchial asthma is a chronic inflammatory airway disease characterized by reversible bronchoconstriction. Fatal asthma exacerbations typically show hyperinflated lungs with extensive mucous plugging of the bronchi and bronchioles, accompanied by eosinophilic infiltration and Charcot-Leyden crystals. This patient's autopsy findings of alveolar hemorrhage and fluid deposition, rather than airway mucous plugging, make bronchial asthma unlikely.
Choice D: Thromboembolism in a bronchial artery represents an occlusion of the systemic blood supply to the lung parenchyma. Because the lungs have a dual blood supply from both the pulmonary and bronchial arteries, occlusion of a bronchial artery rarely causes significant infarction or sudden death. This patient's rapid death and diffuse alveolar hemorrhage make thromboembolism in a bronchial artery unlikely.
Choice E: Viral pneumonia is an interstitial lung infection often caused by influenza, respiratory syncytial virus, or cytomegalovirus. It classically presents with a gradual onset of fever, nonproductive cough, and dyspnea, while histology shows an interstitial mononuclear inflammatory infiltrate with widened alveolar septa. This patient's sudden death within 30 minutes and alveolar hemorrhage make viral pneumonia unlikely.
Block 4, Question 4
Correct Answer: E. Induction of cytochrome enzymesExplanation
This 78-year-old man presents for follow-up after recent initiation of ciprofloxacin and rifampin for a nontuberculous mycobacterial infection. He requires therapeutic anticoagulation with warfarin for a mechanical aortic valve, but his recent laboratory results demonstrate a subtherapeutic international normalized ratio despite a recent doubling of his warfarin dose. This presentation of decreased warfarin efficacy following the initiation of a new antimicrobial regimen is due to induction of cytochrome enzymes.
Warfarin is a widely used oral anticoagulant that requires careful monitoring due to its narrow therapeutic index and susceptibility to numerous drug interactions. It is primarily metabolized in the liver by the cytochrome P450 system, specifically the CYP2C9 isoenzyme. When patients are prescribed rifampin for mycobacterial infections, this medication acts as a potent inducer of these hepatic enzymes. The induction accelerates the metabolism and clearance of warfarin from the bloodstream. Consequently, the patient experiences a significant decrease in the international normalized ratio, placing them at increased risk for thrombotic complications such as mechanical valve thrombosis unless the warfarin dose is appropriately escalated.
Interestingly, this patient was also prescribed ciprofloxacin, a known CYP450 inhibitor. While inhibitors typically decrease warfarin metabolism and elevate the international normalized ratio, the profound inducing effect of the antimycobacterial agent predominates in this clinical scenario. Patients with a mechanical aortic valve require a target INR of 2.0 to 3.0 to prevent catastrophic valve thrombosis or systemic embolization. Managing these complex drug interactions requires frequent laboratory monitoring and aggressive dose titration, as the anticoagulant effect will also rapidly rebound to supratherapeutic levels once the inducing agent is discontinued.
Key TakeawayWhy the Other Choices Are Wrong
- Rifampin is a potent inducer of cytochrome P450 enzymes, which accelerates the metabolism of warfarin and leads to a subtherapeutic international normalized ratio.
- Patients on warfarin require close laboratory monitoring and dose adjustments when starting or stopping CYP450 inducers or inhibitors.
Choice A: Decreased protein binding occurs when a newly introduced drug displaces a highly protein-bound medication from serum albumin. Warfarin is highly albumin-bound, and displacement by medications like sulfonamides transiently increases the free fraction of warfarin, leading to an elevated international normalized ratio. This patient's subtherapeutic laboratory findings and lack of newly prescribed displacing agents make this unlikely.
Choice B: Eradication of gut flora is a frequent consequence of broad-spectrum antibiotic therapy. Intestinal bacteria synthesize a significant portion of the body's vitamin K. When antibiotics eliminate these microbes, endogenous vitamin K production falls, synergizing with warfarin to cause a dangerously elevated international normalized ratio. This patient's subtherapeutic coagulation parameters, necessitating a dose increase, make eradication of gut flora unlikely.
Choice C: Increased alcohol intake can significantly alter hepatic drug metabolism depending on the pattern of consumption. Acute alcohol intoxication inhibits hepatic enzymes, decreasing warfarin metabolism and raising the international normalized ratio. Conversely, chronic heavy alcohol consumption induces hepatic enzymes, lowering the international normalized ratio. This patient's steady, moderate consumption of two beers daily makes increased alcohol intake an unlikely cause for the acute change in his coagulation parameters.
Choice D: Increased vegetable consumption can directly antagonize the therapeutic effects of vitamin K antagonists. Leafy green vegetables are rich in vitamin K, and a sudden dietary increase provides the liver with excess substrate to synthesize clotting factors, effectively lowering the international normalized ratio. While this patient reports a healthier diet, the profound subtherapeutic findings immediately following antimycobacterial initiation make increased vegetable consumption a less likely primary cause.
Video Review: Cytochrome P450 Interactions
Block 4, Question 5
Correct Answer: A. AgeExplanation
This 80-year-old African American woman presents with painless, progressive, asymmetric central vision loss and an increased need for bright illumination. Her fundoscopic examination reveals yellow subretinal deposits characteristic of drusen alongside retinal hemorrhages, confirming a diagnosis of age-related macular degeneration, for which the most significant non-modifiable risk factor is Age.
Age-related macular degeneration causes progressive central vision loss due to the gradual degeneration of the macula. The dry, or nonexudative, subtype is characterized by the formation of drusen, which are extracellular lipid and protein deposits located between the retinal pigment epithelium and Bruch's membrane. Over time, these deposits cause localized retinal atrophy and photoreceptor dysfunction, leading to gradual central scotomas and the need for brighter light during detailed tasks. The primary risk factor for this condition is advanced age, typically affecting individuals over 50. Other significant risk factors include cigarette smoking, which this patient denies, and a positive family history.
While dry age-related macular degeneration progresses slowly, it can advance to the wet, or exudative, subtype, which is suggested by this patient's retinal hemorrhages. This severe form involves choroidal neovascularization, where abnormal, leaky blood vessels grow beneath the retina, causing rapid vision loss and fluid accumulation. Affected individuals often experience metamorphopsia, where straight lines appear wavy on an Amsler grid. Management of the dry subtype focuses on antioxidant vitamin supplementation. In contrast, the wet subtype requires prompt treatment with intravitreal injections of vascular endothelial growth factor inhibitors to halt vessel proliferation and preserve vision.
Key TakeawayWhy the Other Choices Are Wrong
- Age-related macular degeneration causes painless, progressive central vision loss and the accumulation of drusen on fundoscopic examination.
- Advanced age is the most significant risk factor for developing this condition, followed by cigarette smoking and a positive family history.
Choice B: Alcohol consumption is a lifestyle factor associated with toxic optic neuropathy. Chronic alcohol abuse causes bilateral, painless vision loss and central scotomas in affected patients, often accompanied by color vision deficits. This patient's fundoscopic findings of drusen and hemorrhages, rather than optic disc pallor, alongside her lack of substance use history, make alcohol consumption an irrelevant risk factor.
Choice C: Ethnicity plays a role in the epidemiology of several ocular conditions, such as open-angle glaucoma, which is more prevalent in individuals of African descent. While age-related macular degeneration is more common in White individuals, ethnicity is a less significant risk factor compared to advancing age. This patient's drusen and central vision changes are primarily driven by her age rather than her ethnic background.
Choice D: Family history is a known risk factor for age-related macular degeneration, as genetic variants in the complement cascade increase susceptibility. A positive family history of macular degeneration significantly elevates an individual's risk of developing the disease. This patient has a family history of glaucoma and type 2 diabetes mellitus, but no family history of macular degeneration, making this a less significant contributing factor than her age.
Choice E: Hypertension is a systemic vascular disease that can cause hypertensive retinopathy. Chronically elevated blood pressure damages retinal blood vessels, classically causing arteriovenous nicking, flame-shaped hemorrhages, and cotton-wool spots. Although this overweight patient has hypertension and hypercholesterolemia treated with amlodipine, hydrochlorothiazide, and atorvastatin, her well-controlled blood pressure (132/75 mm Hg) and the specific presence of drusen make hypertensive retinopathy unlikely.
Block 4, Question 6
Correct Answer: E. NeutropeniaExplanation
This 4-year-old boy presents with fever, tachycardia, tachypnea, and gram-negative bacteremia 3 weeks after initiating induction chemotherapy for acute lymphoblastic leukemia. His physical examination reveals pallor, alopecia, and gum ulcerations alongside a central venous catheter without surrounding erythema. This classic presentation of chemotherapy-induced immunosuppression with absent localized signs of infection is most likely caused by neutropenia.
Patients receiving systemic treatment for acute lymphoblastic leukemia are at high risk for developing febrile neutropenia, a life-threatening complication defined by an absolute neutrophil count of less than 500/mm3. Agents like doxorubicin and vincristine cause profound myelosuppression by inhibiting rapidly dividing cells, which also leads to the observed alopecia, mucosal ulcerations, and pallor. Because neutrophils are required to form pus and mediate localized inflammation, these patients often lack classic signs of focal infection, explaining why this patient's central venous catheter site has no surrounding erythema despite being a potential portal of entry for his bacteremia.
The pathogenesis of gram-negative bacteremia in this setting is strongly linked to mucosal barrier injury caused by the chemotherapy regimen. The observed gum ulcerations reflect widespread gastrointestinal mucositis, which allows endogenous bowel flora such as Escherichia coli, Klebsiella, and Pseudomonas species to translocate into the bloodstream. Due to the rapid progression and high mortality of these infections in the absence of an adequate immune response, immediate empiric therapy with an anti-pseudomonal beta-lactam such as cefepime is required. Treatment must be initiated promptly after drawing blood cultures, without waiting for the return of specific microbial susceptibilities.
Key TakeawayWhy the Other Choices Are Wrong
- Cytotoxic chemotherapy causes profound myelosuppression and neutropenia, leaving patients highly susceptible to life-threatening bacterial infections from translocating endogenous flora.
- Neutropenic patients often lack classic signs of localized inflammation (eg, erythema, purulence) due to an inability to mount an adequate immune response.
Choice A: Deficiency of terminal complement (C5-C9) impairs the formation of the membrane attack complex. This primary immunodeficiency classically presents in late childhood or adolescence with recurrent, invasive infections caused by encapsulated Neisseria species, such as recurrent meningococcal meningitis or disseminated gonococcal infection. This patient's recent initiation of cytotoxic chemotherapy and blood culture growing gram-negative rods rather than gram-negative diplococci makes a terminal complement deficiency unlikely.
Choice B: Hypogammaglobulinemia involves decreased circulating immunoglobulins, impairing pathogen opsonization. Patients typically present with recurrent sinopulmonary and gastrointestinal infections caused by encapsulated bacteria (eg, Streptococcus pneumoniae) and enteroviruses. It can be primary or secondary to conditions like chronic lymphocytic leukemia. This patient's acute gram-negative bacteremia and absent localized erythema shortly after starting induction therapy point to a phagocytic deficit rather than an antibody deficiency.
Choice C: Impaired T-lymphocyte function causes defects in cell-mediated immunity, preventing the clearance of intracellular pathogens. This immunodeficiency classically predisposes individuals to opportunistic infections with fungi (eg, Pneumocystis jirovecii), viruses (eg, Cytomegalovirus), and intracellular bacteria (eg, Mycobacterium). Although dexamethasone suppresses T-cell function, this patient's rapid-onset gram-negative bacteremia and the absence of localized inflammatory signs are characteristic of a profound phagocytic cell deficit.
Choice D: Inhibition of tumor necrosis factor α (TNF-α) function occurs with targeted biologic therapies like infliximab or etanercept. TNF-α is crucial for macrophage activation and granuloma formation. Inhibiting this cytokine classically leads to the reactivation of latent granulomatous infections, most notably tuberculosis, and invasive fungal infections. This patient is receiving traditional cytotoxic chemotherapy, and his acute gram-negative bacteremia does not align with latent granulomatous disease reactivation.
Block 4, Question 7
Correct Answer: A. (18/1000) − (12/1000)Explanation
This randomized clinical trial is evaluating wound infection rates between two surgical closure procedures. Procedure A yielded an infection rate of 12 per 1000 women, whereas Procedure B yielded an infection rate of 18 per 1000 women, allowing for the calculation of the absolute risk reduction as (18/1000) − (12/1000).
The primary metric evaluated here is the absolute risk reduction, which measures the simple difference in event rates between a control group and an experimental group. It represents the proportion of patients spared the adverse outcome by receiving the experimental intervention. In this trial, Procedure B serves as the baseline control with a higher infection rate, while Procedure A represents the improved intervention. The calculation requires subtracting the experimental event rate from the control event rate. Therefore, the difference between 18/1000 and 12/1000 provides the absolute decrease in wound infections attributable to the superior procedure.
Understanding risk measures is essential for determining an intervention's clinical impact. Once the absolute difference is calculated, it determines the number needed to treat, which is the inverse of this value and indicates how many patients must receive the intervention to prevent one adverse outcome. Conversely, the relative risk reduction describes the proportional decrease in adverse events, calculated by dividing the absolute difference by the baseline risk. The 85% participation rate represents the study enrollment fraction, providing context for external validity without mathematically altering risk metrics.
Key TakeawayWhy the Other Choices Are Wrong
- Absolute risk reduction is calculated by subtracting the experimental event rate from the control event rate.
- Study enrollment fractions provide information about external validity but are not used in the mathematical calculation of risk reduction metrics.
Choice B: 0.85 × (12/1000) incorporates the proportion of eligible patients who enrolled in the study multiplied by the infection rate of Procedure A. Multiplying an event rate by the enrollment fraction calculates a hypothetical population-level frequency rather than a comparative epidemiological metric. This study's 85% enrollment figure and request for a comparative risk reduction make this isolated calculation incorrect.
Choice C: 0.85 × (18/1000) multiplies the study's enrollment fraction by the infection rate observed with Procedure B. The proportion of eligible patients who agreed to participate is useful for assessing selection bias and generalizability but plays no role in comparing outcomes between randomized groups. This study's request for a comparative metric between two procedures makes this single-group calculation irrelevant.
Choice D: [0.85 × (18/1000 – 12/1000)] multiplies the study enrollment fraction by the actual absolute risk reduction. While the term in the parentheses correctly represents the difference in event rates, modifying this value by the participation rate is mathematically invalid for determining treatment efficacy. This study's 85% enrollment fraction is independent of the risk metrics calculated from the enrolled cohort.
Choice E: [(1.2/100) − (1.8/100)]/(1.8/100) represents the calculation for the relative change in risk, which yields the negative equivalent of the relative risk reduction. This proportional metric describes the percentage decrease in adverse events relative to the baseline control rate. This study's specific request for the absolute risk reduction makes this relative calculation incorrect.
Block 4, Question 8
Correct Answer: B. Acute myelogenous leukemiaExplanation
This 67-year-old man presents with signs of bone marrow failure, including fatigue, severe thrombocytopenia with mucocutaneous bleeding, and an acute lower respiratory tract infection. His peripheral blood smear reveals large, immature leukocytes containing needle-like cytoplasmic inclusions known as Auer rods, identifying the underlying disease as acute myelogenous leukemia.
Acute myelogenous leukemia is characterized by the clonal proliferation of abnormal myeloid precursors, or myeloblasts, which cause extensive bone marrow replacement. Tobacco smoke contains benzene, a known leukemogen that likely contributed to this patient's disease. This infiltrative process suppresses normal hematopoiesis, resulting in functional pancytopenia despite an elevated total leukocyte count. Consequently, patients develop fatigue from anemia, mucosal bleeding from thrombocytopenia, and severe infections (like his pneumonia) due to a lack of mature neutrophils. The pathognomonic Auer rods are azurophilic cytoplasmic inclusions composed of fused lysosomes that stain positive for myeloperoxidase.
A highly testable variant of this disease is acute promyelocytic leukemia, which is driven by a t(15;17) chromosomal translocation that fuses the promyelocytic leukemia gene with the retinoic acid receptor alpha gene. This fusion produces an abnormal receptor that halts myeloid differentiation. Patients with this subtype are at exceptionally high risk for developing life-threatening disseminated intravascular coagulation due to the release of procoagulant factors from the abundant Auer rods. Management requires immediate administration of all-trans retinoic acid, which forces the malignant blasts to mature into functional neutrophils and rapidly resolves the coagulopathy.
Key TakeawayWhy the Other Choices Are Wrong
- Acute myelogenous leukemia presents with signs of bone marrow failure (anemia, thrombocytopenia, neutropenia) and circulating myeloblasts.
- The presence of Auer rods (linear, myeloperoxidase-positive cytoplasmic inclusions) on a peripheral blood smear is pathognomonic for acute myelogenous leukemia.
Choice A: Acute lymphocytic leukemia is a hematologic malignancy of immature lymphoid precursors. It predominantly affects children and classically presents with bone pain, lymphadenopathy, hepatosplenomegaly, and signs of bone marrow failure. Lymphoblasts are typically terminal deoxynucleotidyl transferase (TdT) positive and lack cytoplasmic granules. This patient's advanced age and the presence of Auer rods on the peripheral blood smear make acute lymphocytic leukemia unlikely.
Choice C: Chronic lymphocytic leukemia is an indolent neoplasm of mature B lymphocytes. It is the most common adult leukemia and often presents asymptomatically with isolated, striking leukocytosis. When symptomatic, patients develop painless lymphadenopathy, hepatosplenomegaly, and B symptoms. Peripheral smears characteristically show small, mature-appearing lymphocytes and fragile smudge cells. This patient's acute presentation of bone marrow failure and the presence of Auer rods make chronic lymphocytic leukemia unlikely.
Choice D: Chronic myelogenous leukemia is a myeloproliferative neoplasm driven by the BCR-ABL1 fusion gene. It typically presents in middle-aged adults with fatigue, weight loss, and massive splenomegaly. Blood smears reveal a markedly elevated leukocyte count featuring a full spectrum of maturing myeloid cells, alongside increased basophils. This patient's acute onset of severe thrombocytopenia and the predominance of blasts with Auer rods make chronic myelogenous leukemia unlikely.
Video Review: Acute Myeloid Leukemia
Block 4, Question 9
Correct Answer: D. LDL receptorExplanation
This 45-year-old man presents with an acute myocardial infarction, tendinous xanthomas, severe hypercholesterolemia, and a strong family history of premature coronary artery disease. This classic triad of extremely high serum cholesterol, tendon xanthomas, and premature atherosclerosis indicates familial hypercholesterolemia, an autosomal dominant disorder most commonly caused by a deficiency of the LDL receptor.
Familial hypercholesterolemia (Type IIa dyslipidemia) is an autosomal dominant condition characterized by severe elevations in total cholesterol and low-density lipoprotein. The primary defect involves absent or defective hepatic receptors that normally bind apolipoprotein B-100 to clear circulating lipids. Without functional receptors, serum cholesterol levels typically exceed 300 mg/dL in heterozygotes and 700 mg/dL in homozygotes. This massive lipid accumulation leads to the formation of foam cells as tissue macrophages engulf oxidized lipoproteins. These lipid-laden macrophages subsequently deposit in various tissues, forming characteristic tendinous xanthomas in the Achilles tendons and extensor tendons of the hands.
The most devastating consequence of this impaired lipid clearance is accelerated atherosclerosis, which manifests as premature coronary artery disease and myocardial infarction, often occurring before age 50. Patients may also develop corneal arcus, a grayish-white lipid ring around the peripheral cornea that is highly specific for hyperlipidemia when seen in young individuals. Management of this condition requires aggressive lipid-lowering therapy. First-line treatment involves high-intensity statins, which competitively inhibit the rate-limiting enzyme in hepatic cholesterol synthesis. For patients who do not achieve target lipid levels, the addition of PCSK9 inhibitors can significantly decrease receptor degradation, thereby increasing hepatic lipid clearance.
Key TakeawayWhy the Other Choices Are Wrong
- Familial hypercholesterolemia (Type IIa dyslipidemia) is an autosomal dominant disorder caused by absent or defective LDL receptors.
- It classically presents with severe hypercholesterolemia, tendinous xanthomas, corneal arcus, and premature coronary artery disease.
Choice A: Apo B48 deficiency occurs in abetalipoproteinemia, an autosomal recessive condition causing defective chylomicron assembly. This disorder classically presents in infancy with severe fat malabsorption, steatorrhea, failure to thrive, spinocerebellar degeneration, and acanthocytosis (spurred red blood cells). Total cholesterol and triglyceride levels are typically extremely low. This patient's profound hypercholesterolemia, premature atherosclerosis, and tendinous xanthomas make Apo B48 deficiency unlikely.
Choice B: Apo C-II deficiency causes familial chylomicronemia syndrome (Type I dyslipidemia), an autosomal recessive lipid disorder. Apo C-II is an essential cofactor for lipoprotein lipase. Its absence leads to massive chylomicronemia and severe hypertriglyceridemia, classically causing recurrent acute pancreatitis, hepatosplenomegaly, and eruptive skin xanthomas. This patient's normal triglyceride concentration of 140 mg/dL and presence of tendinous rather than eruptive xanthomas make Apo C-II deficiency unlikely.
Choice C: Decreased HMG-CoA reductase activity is not a recognized genetic disorder, as this enzyme is essential for endogenous cholesterol synthesis. HMG-CoA reductase catalyzes the rate-limiting step in cholesterol production. Pharmacologic inhibition of this enzyme with statins is actually the primary treatment for hypercholesterolemia. This patient's severe hypercholesterolemia indicates massive cholesterol accumulation rather than impaired synthesis, making decreased HMG-CoA reductase activity unlikely.
Choice E: Lipoprotein lipase activity deficiency causes familial hyperchylomicronemia (Type I dyslipidemia). This enzyme normally degrades triglycerides circulating in chylomicrons and very-low-density lipoproteins. Deficiency results in severe hypertriglyceridemia, manifesting clinically with recurrent acute pancreatitis, lipemia retinalis, hepatosplenomegaly, and eruptive xanthomas without significantly increasing atherosclerosis risk. This patient's normal triglyceride levels, tendinous xanthomas, and premature coronary artery disease make lipoprotein lipase deficiency unlikely.
Block 4, Question 10
Correct Answer: C. Delayed maturation of detrusor and sphincter controlExplanation
This 5-year-old boy presents with primary nocturnal enuresis, characterized by bed-wetting without a prior period of prolonged nighttime continence. His normal physical examination, normal urinalysis, and absence of daytime symptoms rule out secondary causes such as urinary tract infections or diabetes mellitus. The most common etiology for this presentation is delayed maturation of detrusor and sphincter control.
Primary nocturnal enuresis is defined as urinary incontinence during sleep in children aged 5 years or older. The pathogenesis is multifactorial but predominantly driven by a delay in the normal maturation of the central nervous system pathways governing bladder function. This leads to an inability to inhibit spontaneous bladder contractions or awaken to a full bladder. Additionally, many patients exhibit decreased nocturnal secretion of antidiuretic hormone, resulting in overnight polyuria that exceeds the functional capacity of the detrusor muscle. There is also a strong genetic component, especially if parents have a history of monosymptomatic enuresis.
Management begins with reassurance and behavioral modifications, as the spontaneous resolution rate is approximately 15% per year. Initial steps include motivational therapy, restricting evening fluid intake, and ensuring the child voids before bedtime. If these measures fail, the most effective long-term intervention is an enuresis alarm, which conditions the child to awaken to a full bladder. Pharmacologic treatment with oral desmopressin may be used for short-term management, such as for sleepovers, as it decreases urine production but has a high relapse rate upon discontinuation.
Key TakeawayWhy the Other Choices Are Wrong
- Primary nocturnal enuresis in children aged 5 years or older is most commonly caused by delayed maturation of detrusor and sphincter control.
- Initial management involves behavioral modifications and reassurance, followed by an enuresis alarm or short-term desmopressin.
Choice A: Abnormal insertion of the terminal ureter describes an ectopic ureter, which often bypasses the external urinary sphincter. This congenital anomaly typically presents with continuous, low-volume urinary incontinence (dribbling) that occurs both during the day and at night. This patient's normal daytime continence and lack of continuous dribbling make an ectopic ureter unlikely.
Choice B: Bladder colonization leading to recurrent urinary tract infection can cause secondary enuresis, daytime incontinence, urgency, and frequency. Patients typically present with systemic or localized symptoms such as fever, dysuria, suprapubic pain, and malodorous urine. This patient's lack of dysuria or fever, combined with a completely normal dipstick urinalysis, makes a urinary tract infection unlikely.
Choice D: Occult neurologic lesion leading to disruption of bladder innervation can occur with conditions such as tethered cord syndrome or spina bifida occulta. These lesions typically present with lower extremity weakness, altered deep tendon reflexes, gait abnormalities, or lumbosacral cutaneous stigmata like a hair tuft. This patient's completely normal physical examination and normal development make an occult neurologic lesion unlikely.
Choice E: Retrograde flow of urine from the bladder into the ureter describes vesicoureteral reflux, a congenital anomaly of the ureterovesical junction. This condition predisposes children to recurrent febrile urinary tract infections and subsequent renal scarring, rather than isolated nocturnal enuresis. This patient's lack of a history of serious illness, fever, or abnormal urinalysis makes vesicoureteral reflux unlikely.
Block 4, Question 11
Correct Answer: A. ConstipationExplanation
This 5-year-old boy presents with hematochezia, passage of hard stools, infrequent bowel movements, and a slightly distended abdomen with hypoactive bowel sounds. Rectal examination reveals protruding bright red mucosa, indicating a rectal prolapse. In a pediatric patient with normal growth parameters and a clear history of difficult, infrequent defecation, this prolapse is most likely a complication of constipation.
Rectal prolapse occurs when the rectal mucosa or the full thickness of the rectal wall descends through the anal sphincter. In pediatric populations, the most common trigger is increased intra-abdominal pressure generated by excessive straining during defecation. Functional constipation is the leading underlying cause, characterized by infrequent, hard, pebble-like stools that cause pain upon passage. This painful experience frequently leads to stool withholding behavior, which worsens the fecal impaction and necessitates even more forceful straining during subsequent bowel movements. The repeated physical stress on the pelvic floor and supporting ligaments eventually allows the rectal mucosa to evert.
Management of constipation-associated prolapse primarily involves treating the underlying bowel dysfunction. First-line therapy includes dietary modifications alongside osmotic laxatives to soften stools and facilitate painless passage. Acute management of the protruding tissue often requires manual reduction, which can be performed using gentle, steady pressure. Although this patient is at the lower end for height and weight, his normal body mass index suggests constitutional growth delay rather than failure to thrive. If a child presents with recurrent prolapse accompanied by true failure to thrive or respiratory symptoms, a sweat chloride test is indicated to evaluate for cystic fibrosis.
Key TakeawayWhy the Other Choices Are Wrong
- Rectal prolapse in children is most commonly caused by excessive straining secondary to functional constipation.
- Management focuses on treating the underlying constipation with dietary changes and osmotic laxatives, alongside manual reduction of the prolapsed tissue.
Choice B: Cystic fibrosis is an autosomal recessive disorder caused by CFTR gene mutations that can lead to rectal prolapse. Patients classically present with recurrent sinopulmonary infections, pancreatic insufficiency, steatorrhea, and failure to thrive. Viscous intestinal secretions can cause meconium ileus in neonates. This patient's normal body mass index, lack of respiratory symptoms, and clear history of hard, pebble-like stools make cystic fibrosis unlikely.
Choice C: Hirschsprung disease is a congenital aganglionic megacolon resulting from the failure of neural crest cells to migrate to the distal colon. It typically presents in neonates with failure to pass meconium, bilious emesis, and severe abdominal distention. Digital rectal examination classically reveals an empty rectal vault followed by an explosive expulsion of stool. This patient's presentation at 5 years of age with hard stools makes this diagnosis unlikely.
Choice D: Hookworm infestation is a parasitic infection caused by Necator americanus or Ancylostoma duodenale. Larvae penetrate the skin and eventually reach the small intestine to feed on host blood. Patients typically present with a pruritic rash at the entry site, gastrointestinal distress, eosinophilia, and profound iron deficiency anemia. This patient's lack of travel history and isolated bright red rectal bleeding make hookworm infestation unlikely.
Choice E: Intussusception is the telescoping of a proximal bowel segment into a distal segment, most commonly at the ileocecal junction. It classically presents in children under 3 years old with sudden, severe, intermittent abdominal pain and vomiting. As ischemia progresses, patients pass characteristic "currant jelly" stools containing blood and mucus. This patient's painless, hard stools and visible protruding rectal mucosa make intussusception unlikely.
Block 4, Question 12
Correct Answer: D. 2 of 3Explanation
This 27-year-old woman presents for preconception counseling regarding her risk of carrying cystic fibrosis, given her brother's diagnosis. Because cystic fibrosis is an autosomal recessive condition and the patient is phenotypically unaffected despite having an affected sibling, her parents are obligate carriers, making her probability of being a carrier 2 of 3.
Cystic fibrosis follows an autosomal recessive inheritance pattern, meaning an individual must inherit two mutated alleles to manifest the disease. When two unaffected parents have an affected child, both parents are obligate carriers of the mutation. A standard Mendelian cross for two carrier parents yields a 25% chance of an affected child, a 50% chance of a carrier child, and a 25% chance of an unaffected non-carrier child. Because this patient does not have the disease, the 25% chance of being affected is eliminated from the denominator. This leaves three possible genotypes for her phenotypically normal presentation: two carrier states and one homozygous normal state, which is easily visualized using a Punnett square.
Preconception counseling for this condition often involves targeted carrier screening for common mutations in the CFTR gene on chromosome 7. The most frequent mutation is a three-base pair deletion resulting in the loss of a phenylalanine residue at position 508. If this patient is confirmed to be a carrier, her partner would also be offered screening to determine the risk to their offspring. If her partner's carrier status is unknown, his risk would be estimated using the Hardy-Weinberg principle based on the general population carrier frequency. A fetus inherits the disease only if both parents pass on a mutated allele, demonstrating the concept of compound heterozygosity if the inherited mutations differ.

Why the Other Choices Are Wrong
- Unaffected siblings of an individual with an autosomal recessive condition have a 2/3 probability of being a carrier.
- The 25% chance of being homozygous recessive is eliminated from the probability denominator because the sibling is phenotypically normal.
Choice A: A probability of 1 of 2 represents the chance that an offspring of two carrier parents will be a carrier when considering all possible genetic outcomes. This calculation retains the 25% chance of having an affected child in the denominator. This patient's unaffected clinical status eliminates the affected genotype from consideration, making this unadjusted probability incorrect.
Choice B: A probability of 1 of 3 represents the chance of an unaffected sibling of an affected individual inheriting two normal alleles. This represents the homozygous dominant genotype in a standard Mendelian cross, resulting in an individual completely free of the disease mutation. This patient's specific inquiry regarding her risk of carrying the mutation makes this calculation for the non-carrier state incorrect.
Choice C: A probability of 1 of 4 represents the overall risk for two carrier parents to have a child affected by an autosomal recessive disease. It also represents the overall chance of having a homozygous normal child. This patient's healthy status rules out the affected genotype entirely, and her question specifically addresses carrier risk rather than disease risk.
Choice E: A probability of 3 of 4 represents the overall chance that two carrier parents will have a phenotypically normal child in an autosomal recessive inheritance pattern. This combined probability includes both the homozygous normal and heterozygous carrier genotypes. This patient's established status as an unaffected adult means she already falls within this demographic, requiring a modified denominator to determine carrier risk.
Block 4, Question 13
Correct Answer: E. α-Adrenergic agonistExplanation
This 45-year-old woman presents with sudden crushing chest pain, severe hypotension, tachycardia, and anteroseptal ST-segment elevations with reciprocal inferior depressions. These findings indicate cardiogenic shock secondary to an acute myocardial infarction, requiring a vasopressor that increases systemic vascular resistance without exacerbating her tachycardia, which is best achieved with an α-adrenergic agonist.
The primary goal in managing this patient's cardiogenic shock is to restore perfusion pressure while minimizing myocardial oxygen demand. Her extreme tachycardia already places significant stress on the ischemic myocardium. Administration of an agent that stimulates alpha-1 receptors causes smooth muscle contraction in peripheral blood vessels, leading to a profound increase in systemic vascular resistance and mean arterial pressure. Unlike agents with mixed adrenergic activity, pure alpha agonists lack direct chronotropic or inotropic effects on the heart. This selective vasoconstriction successfully raises blood pressure without directly stimulating the sinoatrial node, thereby avoiding further increases in heart rate.
Phenylephrine is the classic prototype for this drug class and is frequently utilized when hypotension is accompanied by severe tachyarrhythmias. As the drug rapidly elevates systemic blood pressure, it activates stretch receptors in the carotid sinus and aortic arch. This triggers the baroreceptor reflex, which increases parasympathetic outflow via the vagus nerve while simultaneously withdrawing sympathetic tone. Consequently, patients often experience a compensatory decrease in heart rate, known as reflex bradycardia. In this patient with an acute anteroseptal myocardial infarction, this physiologic response is highly desirable because it improves coronary perfusion pressure while concurrently reducing myocardial oxygen consumption.
Key TakeawayWhy the Other Choices Are Wrong
- Pure alpha-1 adrenergic agonists (e.g., phenylephrine) increase systemic vascular resistance and blood pressure without directly stimulating the heart.
- The resulting elevation in mean arterial pressure triggers the baroreceptor reflex, leading to increased vagal tone and reflex bradycardia.
Choice A: Dopamine agonists, such as fenoldopam, are vasodilators used primarily for hypertensive emergencies. Activation of D1 receptors in the renal, mesenteric, and coronary beds causes smooth muscle relaxation, leading to decreased systemic vascular resistance and increased renal perfusion. This patient's profound hypotension and systolic blood pressure of 70 mm Hg make a vasodilating dopamine agonist contraindicated.
Choice B: Beta-adrenergic agonists, such as isoproterenol or dobutamine, primarily stimulate beta-1 and beta-2 receptors to increase cardiac contractility and heart rate while causing peripheral vasodilation. These agents are useful for severe bradycardia or specific types of heart failure. This patient's baseline heart rate of 136/min makes a beta-adrenergic agonist inappropriate, as it would fatally exacerbate her tachycardia.
Choice C: Beta-adrenergic antagonists, such as metoprolol, are negative inotropes and chronotropes that decrease myocardial oxygen demand by lowering heart rate and contractility. While these agents are a cornerstone of long-term post-myocardial infarction management, they can precipitate cardiovascular collapse in hemodynamically unstable patients. This patient's cardiogenic shock and severe hypotension make beta-blocker administration immediately life-threatening.
Choice D: Alpha-adrenergic antagonists, such as phentolamine or prazosin, block peripheral alpha-1 receptors to cause vasodilation and decrease systemic vascular resistance. These agents are indicated for hypertensive emergencies related to sympathetic overactivity, such as pheochromocytoma or cocaine toxicity. This patient's systolic blood pressure of 70 mm Hg makes an alpha-adrenergic antagonist unlikely to be beneficial.
Video Review: Alpha Adrenergic Antagonists
Block 4, Question 14
Correct Answer: D. Fusion of the inferior poles of the metanephros during ascentExplanation
This 5-year-old girl presents with a 2-day history of fever, urgency, and dysuria along with a history of recurrent urinary tract infections, and renal ultrasonography revealing a large U-shaped kidney. This imaging finding is characteristic of a horseshoe kidney, a congenital anomaly resulting from the fusion of the inferior poles of the metanephros during ascent.
During normal embryogenesis, the kidneys develop in the pelvis and ascend to their retroperitoneal position in the upper abdomen. In a horseshoe kidney, the inferior poles of both metanephric blastemas fuse together. As this fused structure ascends from the pelvis, it becomes physically trapped under the inferior mesenteric artery. This vascular obstruction halts their upward migration, leaving the fused kidney situated lower in the abdomen than normal kidneys, typically at the level of the lower lumbar vertebrae. The ureters must pass anteriorly over the fused isthmus, which alters normal drainage and creates urinary stasis, explaining this patient's recurrent urinary tract infections.
Although many patients with horseshoe kidneys remain asymptomatic, the altered anatomy predisposes individuals to several complications, including nephrolithiasis, hydronephrosis, and an elevated risk of specific renal malignancies such as Wilms tumor or renal cell carcinoma. Furthermore, horseshoe kidneys are strongly associated with chromosomal aneuploidies, most notably Turner syndrome, as well as trisomies 13, 18, and 21. Because normal ascent and rotation are disrupted in this condition, the renal pelvis is often directed anteriorly rather than medially, further contributing to the poor drainage that causes recurrent febrile episodes and dysuria.
Key TakeawayWhy the Other Choices Are Wrong
- Horseshoe kidney occurs when the inferior poles of the metanephros fuse, causing the ascending kidney to become trapped under the inferior mesenteric artery.
- The abnormal anatomy predisposes patients to urinary stasis, recurrent infections, nephrolithiasis, and is strongly associated with Turner syndrome.
Choice A: Failure of the kidneys to rotate 90 degrees medially describes incomplete or malrotation of the kidneys. Normal renal development involves a medial rotation during ascent so the hilum faces anteromedially. Malrotation typically presents as an isolated, normally separated kidney with an anteriorly facing pelvis. This patient's ultrasound demonstrating a fused, U-shaped kidney rules out simple malrotation.
Choice B: Failure of normal kidney ascent results in a pelvic kidney (ectopic kidney). This occurs when the metanephros fails to migrate from its embryonic pelvic origin to the normal lumbar position. While pelvic kidneys can predispose patients to poor drainage and recurrent infections, this patient's ultrasound specifically shows a large, fused U-shaped structure rather than a single, isolated kidney remaining in the pelvis.
Choice C: Failure of one ureteric bud to develop normally leads to unilateral renal agenesis. The ureteric bud induces the differentiation of the metanephric mesenchyme into the functional kidney; without it, the kidney does not form. Unilateral renal agenesis results in a single, often hypertrophied, normal-appearing kidney on the contralateral side. This patient's imaging showing a large, bilaterally fused U-shaped kidney makes unilateral agenesis incorrect.
Block 4, Question 15
Correct Answer: C. 'I'm glad you came in today and told me about this.'Explanation
This 16-year-old boy presents with a 3-day history of a scrotal lesion and expresses anxiety about a potential sexually transmitted infection. When an adolescent discloses sensitive information or vulnerable concerns regarding sexual health, the physician must first establish rapport and validate the patient's proactive healthcare-seeking behavior before gathering further clinical details, making the most appropriate initial response 'I'm glad you came in today and told me about this.'
Effective communication with adolescent patients requires building a foundation of trust before delving into sensitive sexual histories. The initial response to a vulnerable disclosure should utilize patient-centered interviewing techniques that prioritize empathy and validation. By acknowledging the patient's courage in bringing up a stigmatized topic, the physician reinforces positive healthcare-seeking behavior. This approach lowers the patient's defensive barriers and facilitates a more accurate and comprehensive subsequent history. Establishing a therapeutic alliance is critical in this population, as adolescents are often hesitant to discuss sexual health due to fear of judgment or breaches of confidentiality.
After validating the patient's concern, the physician should transition to gathering specific details using the HEEADSSS assessment to evaluate psychosocial factors and risk behaviors. The sexual history should be obtained using open-ended, non-judgmental questions regarding partners, practices, and protection. Furthermore, it is essential to inform the adolescent that all states have minor consent laws allowing adolescents to receive STI testing and treatment without parental notification. Reassuring the patient about these legal protections for sexual health encourages honest disclosure and ensures timely management of the suspected scrotal lesion.
Key TakeawayWhy the Other Choices Are Wrong
- When an adolescent discloses sensitive information, the physician's initial response should validate the patient's concerns and reinforce positive healthcare-seeking behavior.
- Establishing rapport and trust must precede gathering specific clinical details or sexual history.
Choice A: 'Are you sexually active with men, women, or both?' is a standard question used to ascertain the gender of a patient's sexual partners. This non-judgmental phrasing is an essential component of taking a comprehensive sexual history and assessing individual risk factors for specific infections. This patient's immediate need for validation regarding his anxiety makes this an inappropriate first response, though it should be asked later in the interview.
Choice B: 'Does your mother know you are sexually active?' inquires about parental involvement in the adolescent's sexual health. While family dynamics are important, asking about parental knowledge immediately after a vulnerable disclosure can sound judgmental, threatening, or punitive to an adolescent. This patient's fear of having an STI requires a supportive environment, and introducing the topic of parental knowledge prematurely would likely damage rapport and hinder further disclosure.
Choice D: 'What kind of protection do you use when you have sex?' evaluates barrier method utilization and pregnancy prevention strategies. Assessing the use of condoms and other contraceptives is a crucial step in evaluating a patient's risk for acquiring or transmitting infections. This patient's primary concern is an existing scrotal lesion, making this question overly interrogative for an initial response before empathy and rapport have been established.
Choice E: 'When was your last sexual experience?' attempts to establish a timeline for potential infectious exposures. Determining the incubation period is necessary for diagnosing specific pathogens, such as the 10 to 90-day incubation (average 21 days) for a primary syphilitic chancre or the shorter window for herpes simplex virus. This patient's disclosure of a sensitive concern requires immediate validation, meaning this clinical data-gathering question should be deferred until after the physician acknowledges his proactive disclosure.
Video Review: Treponema Pallidum
Block 4, Question 16
Correct Answer: D. Increased fasting insulin concentrationExplanation
This 54-year-old woman presents with a history of failed diets, a body mass index of 27 kg/m², hypertension, and impaired fasting glucose in the setting of a strong family history of type 2 diabetes mellitus. These findings indicate the presence of metabolic syndrome driven by peripheral insulin resistance, which typically manifests early in its course with an increased fasting insulin concentration.
Excess adiposity is a primary driver of insulin resistance, characterized by a decreased physiologic response of peripheral tissues to normal insulin levels. Visceral fat releases free fatty acids and inflammatory cytokines that disrupt intracellular insulin signaling pathways. To maintain euglycemia and overcome this peripheral resistance, pancreatic beta cells undergo compensatory hyperplasia and hypertrophy, leading to hyperinsulinemia. Over time, this compensatory mechanism can fail, resulting in progressive hyperglycemia and the eventual development of frank type 2 diabetes mellitus. The presence of elevated blood pressure and impaired fasting glucose in this overweight patient strongly suggests underlying metabolic syndrome.
The diagnosis of metabolic syndrome requires three or more specific criteria, including elevated waist circumference, hypertriglyceridemia, reduced high-density lipoprotein cholesterol, hypertension, and elevated fasting blood glucose. Patients with this condition are at significantly increased risk for developing cardiovascular disease and nonalcoholic fatty liver disease. Initial management focuses on lifestyle modifications, including dietary changes, weight loss, and regular aerobic exercise, which directly improve peripheral insulin sensitivity. If lifestyle interventions are insufficient, pharmacologic therapy with metformin may be initiated to decrease hepatic glucose production and improve peripheral glucose uptake, thereby reducing the risk of macrovascular complications.
Key TakeawayWhy the Other Choices Are Wrong
- Obesity and metabolic syndrome are characterized by peripheral insulin resistance, which leads to compensatory pancreatic beta-cell hyperplasia and hyperinsulinemia.
- Adipose tissue is endocrinologically active, producing increased levels of leptin and estrone in overweight individuals.
Choice A: Decreased cholesterol excretion represents a reduction in biliary cholesterol elimination. Obesity is actually associated with increased biliary cholesterol excretion due to upregulated hepatic cholesterol synthesis, which supersaturates the bile and increases the risk of cholesterol gallstone formation. This patient's elevated body mass index makes increased, rather than decreased, cholesterol excretion more likely.
Choice B: Decreased estrone concentration reflects a state of low peripheral estrogen production. Adipose tissue is a major site of peripheral aromatization, where the aromatase enzyme converts adrenal androgens into estrone, leading to higher circulating estrogen levels in obese individuals. This patient's overweight status would result in increased estrone concentrations compared to a normal-weight woman.
Choice C: Decreased leptin concentration occurs in rare genetic leptin deficiencies or states of extreme starvation. Leptin is an adipokine produced directly by fat cells to signal satiety to the hypothalamus, and circulating levels are directly proportional to total adipose tissue mass. This patient's elevated body mass index indicates she would have increased leptin levels due to leptin resistance.
Choice E: Increased growth hormone concentration occurs in conditions like acromegaly or during fasting states. Obesity is classically associated with suppressed growth hormone secretion, characterized by decreased spontaneous release and a blunted pulsatile secretory pattern. This patient's overweight status makes an increased growth hormone concentration highly unlikely.
Choice F: Increased thyroid-stimulating hormone concentration is a hallmark of primary hypothyroidism. Primary hypothyroidism classically presents with weight gain, cold intolerance, fatigue, and bradycardia. While hypothyroidism can cause secondary weight gain, obesity itself does not intrinsically elevate thyroid-stimulating hormone. This patient's lack of hypothyroid symptoms and clear metabolic syndrome presentation make this finding unlikely.
Block 4, Question 17
Correct Answer: D. PotassiumExplanation
This 17-year-old boy presents with episodic full-body weakness triggered by rest after exertion and ingestion of carbohydrate-rich, high-sodium meals. His transient symptoms and normal inter-episode laboratory findings point to a skeletal muscle channelopathy that alters resting membrane potentials during specific metabolic shifts, most commonly affecting the serum concentration of potassium.
The patient's presentation is classic for hypokalemic periodic paralysis, an autosomal dominant disorder most frequently caused by mutations in skeletal muscle voltage-gated calcium channels. Attacks of flaccid paralysis are precipitated by factors that promote intracellular potassium shifts. Ingestion of carbohydrate-rich meals stimulates insulin release, which upregulates sodium-potassium ATPase activity, rapidly driving potassium into cells. Similarly, rest after vigorous exercise causes an epinephrine-mediated intracellular potassium shift. This acute drop in extracellular potassium hyperpolarizes the muscle cell membrane, rendering it refractory to depolarization and resulting in profound weakness. Between attacks, serum potassium levels return to normal.
Acute management of these paralytic episodes relies on the administration of oral potassium chloride to restore extracellular concentrations and regain muscle excitability. Intravenous repletion is generally avoided due to the high risk of rebound hyperkalemia once the intracellular shift reverses. Long-term prevention focuses on avoiding known triggers through a low-carbohydrate, low-sodium diet and maintaining low-intensity physical activity during recovery periods. Pharmacologic prophylaxis is typically achieved with carbonic anhydrase inhibitors like acetazolamide, which induce a mild non-anion gap metabolic acidosis that shifts potassium extracellularly, or with potassium-sparing diuretics to maintain higher baseline serum potassium levels.
Key TakeawayWhy the Other Choices Are Wrong
- Hypokalemic periodic paralysis presents with episodic flaccid weakness triggered by high-carbohydrate meals or rest after exercise.
- These triggers stimulate insulin and epinephrine release, driving potassium intracellularly via the Na+/K+-ATPase and causing transient, profound hypokalemia.
Choice A: Hypocalcemia causes increased neuromuscular excitability, presenting with perioral numbness, carpopedal spasm, tetany, and seizures. Physical examination often reveals positive Chvostek and Trousseau signs. This patient's episodic flaccid weakness and lack of muscle spasms or hyperreflexia make an abnormality in serum calcium unlikely.
Choice B: Hypochloremia typically occurs in the setting of gastrointestinal losses from vomiting or renal losses from loop diuretic use, leading to a metabolic alkalosis. Severe cases can cause weakness or muscle cramps, but symptoms are generally persistent rather than episodic. This patient's discrete attacks triggered by carbohydrates and exercise make a primary chloride abnormality unlikely.
Choice C: Hypomagnesemia often results from poor dietary intake, alcohol use disorder, or gastrointestinal losses. It causes neuromuscular excitability, manifesting as tremors, tetany, and hyperreflexia, and frequently leads to concurrent hypokalemia and hypocalcemia that are refractory to supplementation. This patient's episodic flaccid paralysis and normal inter-episode metabolic profiles make a primary magnesium abnormality unlikely.
Choice E: Hyponatremia frequently presents with neurologic symptoms such as nausea, malaise, headache, lethargy, and, in severe cases, seizures or coma due to cerebral edema. While severe hyponatremia can cause generalized weakness, it does not typically cause transient, profound flaccid paralysis. This patient's specific triggers of rest after exercise and high-carbohydrate meals make a sodium abnormality unlikely.
Video Review: Potassium
Block 4, Question 18
Correct Answer: F. Supraoptic nucleusExplanation
This 26-year-old man presents with a one-week history of polyuria and polydipsia with severely dilute urine that normalizes following exogenous vasopressin administration. These findings indicate a failure of endogenous antidiuretic hormone production, characteristic of arginine vasopressin deficiency (previously known as central diabetes insipidus). Because antidiuretic hormone is synthesized in the hypothalamus before being transported to the posterior pituitary, this patient's condition is most likely caused by dysfunction of the supraoptic nucleus.
Arginine vasopressin deficiency occurs when the deficient secretion of antidiuretic hormone leads to an inability to concentrate urine. Antidiuretic hormone is synthesized primarily by magnocellular neurons located in the supraoptic and paraventricular nuclei of the hypothalamus. Following synthesis, the hormone and its carrier protein neurophysin II travel via anterograde axonal transport down the hypothalamo-hypophysial tract to the posterior pituitary gland, where they are stored and released into the systemic circulation. Damage to these specific hypothalamic nuclei or their proximal axonal tracts results in a permanent loss of antidiuretic hormone production, causing central diabetes insipidus.
The diagnosis is confirmed when patients produce inappropriately dilute urine despite hypernatremia or water deprivation. To differentiate central from nephrogenic causes, exogenous desmopressin is administered. A significant increase in urine osmolality, as seen in this patient, confirms a central etiology, whereas a lack of response indicates nephrogenic resistance. Once released, antidiuretic hormone binds to V2 receptors on the basolateral membrane of principal cells in the renal collecting duct. This interaction stimulates an intracellular signaling cascade that inserts aquaporin-2 channels into the apical membrane, facilitating water reabsorption and concentrating the urine.
Key TakeawayWhy the Other Choices Are Wrong
- Arginine vasopressin deficiency (previously known as central diabetes insipidus) is caused by a deficiency of antidiuretic hormone, which is synthesized in the supraoptic and paraventricular nuclei of the hypothalamus.
- The condition presents with polyuria and dilute urine that normalizes following the administration of exogenous vasopressin.
Choice A: The anterior pituitary gland (adenohypophysis) secretes numerous trophic hormones including TSH, ACTH, FSH, LH, growth hormone, and prolactin. Lesions in this region typically cause hypopituitarism, presenting with secondary hypothyroidism, adrenal insufficiency, or hypogonadism. This patient's isolated inability to concentrate urine without exogenous vasopressin points to a posterior pituitary or hypothalamic hormone deficiency, making an anterior pituitary lesion unlikely.
Choice B: Bowman capsule is the cup-like sac at the beginning of the tubular component of a nephron that performs the first step in the filtration of blood to form urine. Glomerular diseases affecting this structure typically present with proteinuria, hematuria, or cellular casts, leading to nephrotic or nephritic syndromes. This patient's isolated dilute polyuria that corrects with vasopressin makes a structural defect in Bowman capsule unlikely.
Choice C: The glomerulus is a network of capillaries responsible for the ultrafiltration of plasma. Damage to the glomerular basement membrane or podocytes classically results in the leakage of large molecules or red blood cells into the urinary space, manifesting as edema, hypertension, and abnormal urinalysis findings. This patient's normal physical examination and underlying defect in water reabsorption rather than primary filtration make a primary glomerular pathology unlikely.
Choice D: The hypophysial portal system is a network of blood vessels in the brain that connects the hypothalamus with the anterior pituitary. Its primary function is the transport of releasing and inhibiting hormones to regulate anterior pituitary endocrine function. This patient's vasopressin deficiency involves the posterior pituitary pathway, which relies on direct neural axonal transport rather than the vascular hypophysial portal system.
Choice E: The loop of Henle is responsible for creating the corticomedullary concentration gradient necessary for water reabsorption in the collecting duct. Dysfunction of the thick ascending limb impairs sodium-potassium-chloride cotransport, leading to hypokalemia, metabolic alkalosis, and polyuria. This patient's normal serum chemistry studies and complete correction of urine osmolality with exogenous vasopressin make a primary loop of Henle defect unlikely.
Block 4, Question 19
Correct Answer: B. SeminomaExplanation
This 25-year-old man presents with a painless, firm, solid right testicular mass that, upon orchiectomy, demonstrates round cells with clear cytoplasm and prominent, central nuclei. This classic "fried egg" histologic appearance in a young adult male identifies the most common type of testicular germ cell tumor, a seminoma.
Seminomas are the most common malignant testicular germ cell tumors, typically affecting men between the ages of 15 and 35. They originate from the germinal epithelium of the seminiferous tubules and are characterized by a slow growth rate. Grossly, these tumors appear as homogeneous, lobulated, fleshy masses lacking hemorrhage or necrosis. Microscopically, the cells exhibit a classic fried egg appearance due to their large size, clear glycogen-rich cytoplasm, and distinct central nuclei with prominent nucleoli. These neoplastic cells are often arranged in lobules separated by delicate fibrous septa containing a lymphocytic infiltrate. While alpha-fetoprotein is never elevated, patients may have increased levels of beta-human chorionic gonadotropin or placental alkaline phosphatase.
The initial diagnostic workup for any suspicious solid testicular mass includes a scrotal ultrasound followed by tumor marker assessment. Biopsy is strictly contraindicated due to the high risk of tumor seeding into the scrotum. Instead, definitive diagnosis and primary treatment require a radical inguinal orchiectomy. Seminomas typically spread via the lymphatic system first, most commonly metastasizing to the para-aortic lymph nodes because the gonadal lymphatic drainage follows the testicular arteries back to the retroperitoneum. Fortunately, these tumors carry an excellent prognosis because they are highly radiosensitive and highly responsive to platinum-based chemotherapy, resulting in cure rates exceeding 95% even in advanced stages.
Key TakeawayWhy the Other Choices Are Wrong
- Seminomas are the most common testicular germ cell tumors, typically presenting as painless solid masses in young men.
- Histology classically shows a "fried egg" appearance with large round cells, clear cytoplasm, and prominent central nuclei.
Choice A: Embryonal carcinoma is a highly aggressive non-seminomatous germ cell tumor. Histologically, it features pleomorphic, poorly differentiated cells forming glandular or papillary structures, and grossly exhibits extensive hemorrhage and necrosis. This patient's histology showing uniform round cells with clear cytoplasm rather than pleomorphic cells with hemorrhage and necrosis makes embryonal carcinoma unlikely.
Choice C: Sertoli cell tumors are rare, typically benign sex cord-stromal tumors. These neoplasms can produce androgens or estrogens, sometimes leading to precocious puberty in children or gynecomastia in adults. Histologically, they are characterized by tall, columnar cells arranged in hollow or solid tubules. This patient's lack of feminizing symptoms and the presence of clear cells with prominent central nuclei make a Sertoli cell tumor unlikely.
Choice D: Teratomas are non-seminomatous germ cell tumors derived from two or more embryonic germ layers. Unlike in females where they are typically benign, mature teratomas in adult males are considered malignant. Microscopic examination reveals a disorganized mixture of differentiated tissues such as cartilage, neural tissue, muscle, and squamous epithelium. This patient's uniform population of round cells with clear cytoplasm instead of diverse tissue elements makes a teratoma unlikely.
Choice E: Yolk sac tumors, or endodermal sinus tumors, are the most common testicular malignancies in boys under three years old. They characteristically secrete high levels of alpha-fetoprotein. The histologic hallmark is the Schiller-Duval body, which resembles a primitive glomerulus. This patient's adult age and the presence of uniform clear cells rather than Schiller-Duval bodies make a yolk sac tumor unlikely.
Block 4, Question 20
Correct Answer: D. Short palpebral fissuresExplanation
This 2-week-old male newborn presents for a well-child examination following an unmonitored, 41-week gestation complicated by heavy maternal alcohol consumption. This history strongly suggests fetal alcohol syndrome, a teratogenic condition characterized by pre- and postnatal growth restriction, central nervous system impairment, and distinct facial dysmorphisms such as short palpebral fissures.
Fetal alcohol syndrome is the most severe manifestation of in utero alcohol exposure and is a leading cause of preventable intellectual disability. The teratogenic effects of alcohol are mediated through impaired cell migration and the generation of reactive oxygen species, which disrupt normal embryogenesis. The classic facial triad required for diagnosis includes a smooth philtrum, a thin vermilion border of the upper lip, and shortened palpebral fissures. These distinct dysmorphic features result from disrupted development of the cranial neural crest cells during the first trimester. Additional craniofacial abnormalities can include microcephaly and midfacial hypoplasia.
Beyond craniofacial abnormalities, neonates with fetal alcohol syndrome typically exhibit significant pre- and postnatal growth restriction, often falling below the tenth percentile for height and weight. Central nervous system involvement manifests early as hypotonia, poor feeding, and irritability, eventually progressing to severe cognitive deficits and behavioral issues such as attention-deficit hyperactivity disorder. Structural cardiac defects are also highly prevalent, with ventricular septal defects being the most common congenital heart anomaly associated with this condition. Because there is no safe amount of alcohol consumption during pregnancy, complete maternal abstinence is universally recommended to prevent these irreversible developmental complications.

Why the Other Choices Are Wrong
- Fetal alcohol syndrome presents with a classic facial triad: short palpebral fissures, a thin vermilion border, and a smooth philtrum.
- Pathogenesis involves impaired neural crest cell migration, leading to craniofacial dysmorphisms, growth restriction, and central nervous system deficits.
Choice A: Hypospadias is a congenital urologic anomaly characterized by the ventral displacement of the urethral meatus. This defect results from the failure of the urethral folds to fuse completely during the first trimester. It is associated with maternal progestin use and advanced maternal age. This patient's history of heavy maternal vodka consumption makes facial dysmorphisms much more likely than this genitourinary defect.
Choice B: Limb hypoplasia is a severe congenital malformation involving the underdevelopment or absence of one or more limbs. This teratogenic complication is classically associated with maternal thalidomide use during early pregnancy, which inhibits angiogenesis and disrupts normal limb bud development. This patient's mother only took a prenatal vitamin and consumed alcohol, making thalidomide-induced limb anomalies highly unlikely in this newborn.
Choice C: Neck webbing is a cutaneous anomaly characterized by bilateral folds of skin extending from the mastoid to the acromion. This physical finding is classically associated with Turner syndrome, a chromosomal disorder (45,X) resulting from the in utero resolution of a cystic hygroma. This patient's male sex and lack of relevant genetic risk factors make this finding impossible.
Choice E: Spasticity is a motor disorder characterized by a velocity-dependent increase in muscle tone and exaggerated tendon jerks. In neonates, this finding is a hallmark of cerebral palsy, which typically arises from perinatal asphyxia or prematurity leading to upper motor neuron damage. This patient's delivery at 41 weeks was uncomplicated, making hypoxic-ischemic encephalopathy and subsequent spasticity unlikely compared to the hypotonia expected with fetal alcohol syndrome.
Video Review: Teratogenic Medications
Block 5, Question 1
Correct Answer: D. Lymphocytic infiltration of the thyroidExplanation
This 25-year-old woman presents with palpitations, heat intolerance, tachycardia, hyperreflexia, and a nontender goiter three months after delivery. Her laboratory findings of an undetectable TSH with elevated T4 and T3 confirm primary hyperthyroidism, while the recent pregnancy and absence of exophthalmos strongly suggest postpartum thyroiditis, a condition characterized by lymphocytic infiltration of the thyroid.
Postpartum thyroiditis is a destructive autoimmune condition occurring within one year of childbirth, widely considered a variant of Hashimoto thyroiditis. The initial hyperthyroid phase is caused by autoimmune destruction of thyroid follicles, leading to the release of preformed thyroid hormone into the circulation. This transient thyrotoxicosis typically occurs two to six months postpartum and manifests with classic hypermetabolic symptoms alongside a painless, enlarged thyroid gland. Because the hyperthyroidism results from follicular rupture rather than increased de novo synthesis, patients characteristically demonstrate decreased radioiodine uptake, distinguishing this condition from other causes of primary thyrotoxicosis.
Following the initial thyrotoxic phase, patients progress to a transient hypothyroid state as preformed hormone stores deplete and the damaged gland cannot adequately synthesize new hormone. During this phase, patients may develop fatigue and cold intolerance, and serum testing typically reveals high titers of anti-thyroid peroxidase antibodies. Most women eventually return to a euthyroid state within one year. Symptomatic management of the hyperthyroid phase relies on beta-adrenergic antagonists to control palpitations and tachycardia. Antithyroid medications like methimazole are ineffective and inappropriate because there is no increased hormone synthesis to inhibit in this destructive thyroiditis.

Why the Other Choices Are Wrong
- Postpartum thyroiditis is a destructive autoimmune condition occurring within one year of delivery, characterized by lymphocytic infiltration of the thyroid gland.
- It classically presents with a transient hyperthyroid phase due to the release of preformed thyroid hormone, followed by a hypothyroid phase.
Choice A: Activation of mutations of TSH receptors describes the pathophysiology of a toxic adenoma or toxic multinodular goiter. These conditions typically present in older individuals with hyperthyroidism and one or more distinct, palpable thyroid nodules that autonomously produce thyroid hormone. This patient's young age, postpartum status, and diffusely enlarged thyroid without distinct palpable nodules make an activating mutation unlikely.
Choice B: Increased serum thyroglobulin concentration occurs in conditions causing thyroid inflammation or hypersecretion, serving as a marker of thyroid tissue destruction or tumor burden. While thyroglobulin levels are elevated in postpartum thyroiditis due to follicular rupture, thyroglobulin itself is an inactive precursor protein and does not cause hypermetabolic symptoms. This patient's symptoms are driven by elevated active T3 and T4, making thyroglobulin unlikely to be the mechanism.
Choice C: Ischemic injury to the hypothalamus or pituitary gland can occur following severe postpartum hemorrhage, known as Sheehan syndrome. This condition presents with failure to lactate, amenorrhea, and secondary hypothyroidism due to decreased production of TRH or TSH. This patient's successful breastfeeding, tachycardia, heat intolerance, and elevated T4 and T3 levels make ischemic brain injury unlikely.
Choice E: Presence of TSH receptor autoantibodies is the underlying mechanism of Graves disease, the most common cause of hyperthyroidism. Graves disease classically presents with a diffusely enlarged thyroid, a thyroid bruit, pretibial myxedema, and infiltrative ophthalmopathy. This patient's lack of exophthalmos and the specific onset of symptoms three months postpartum make destructive postpartum thyroiditis more likely than Graves disease.
Video Review: Hyper/Hypothyroidism: Hashimoto's and Postpartum Thyroiditis
Block 5, Question 2
Correct Answer: D. 9992Explanation
This question describes a screening test administered to 1000 women with biopsy-proven breast cancer and 1000 women without breast cancer. The question for breast cancer screening in a population of 100,000 women with a disease prevalence of 80 per 100,000. The screening test's initial trial demonstrated 100 false-positive results among 1000 healthy subjects, establishing a 10% false-positive rate. Applying this rate to the 99,920 disease-free women in the new screening population yields the expected number of false-positives, which is 9992.
Calculating the expected number of false-positives in a new population requires determining the test's false-positive rate and the absolute number of healthy individuals. This rate is the proportion of individuals without the disease who incorrectly test positive, calculated as false-positives divided by all disease-negative individuals. In the initial study, 100 out of 1000 healthy women tested positive, yielding a rate of 10%. This metric is mathematically equivalent to one minus the specificity of the test. Because these intrinsic test characteristics are independent of disease prevalence, the 10% rate remains constant when applied to the new population.
To find the total number of false-positives in the new population, the 10% rate must be multiplied by the actual number of disease-free individuals. With 80 cases of breast cancer per 100,000 women, there are 99,920 healthy women. Multiplying 99,920 by 0.10 results in 9992 expected false-positives. While intrinsic test properties do not change with population demographics, the positive predictive value is highly dependent on how common the disease is. In a population with such a low disease burden, even a test with high accuracy will yield a massive number of false-positives, leading to unnecessary confirmatory testing and patient anxiety.
Key TakeawayWhy the Other Choices Are Wrong
- The number of false-positives in a population equals the number of disease-free individuals multiplied by the false-positive rate (1 - specificity).
- The number of disease-free individuals is calculated by subtracting the total number of diseased individuals from the total population.
Choice A: 20 represents the expected number of true-positive results in the new population. True-positives are calculated by multiplying the test sensitivity by the total number of diseased individuals. The initial study demonstrated a sensitivity of 25 percent (250 true-positives out of 1000 diseased women). Applying this 25 percent sensitivity to the 80 diseased women in the new population yields 20 true-positives, not false-positives.
Choice B: 80 represents the total number of women with breast cancer in the new population. This value is derived directly from the stated prevalence rate of 80 per 100,000 women. False-positives occur exclusively in individuals who do not have the disease. Because this number reflects the disease-positive cohort rather than the disease-negative cohort, it cannot represent the expected number of false-positive test results.
Choice C: 8993 represents an arithmetic error derived from incorrectly applying the false-positive rate or miscalculating the total population of healthy individuals. False-positives must be determined by multiplying the exact false-positive rate by the exact number of disease-free individuals. This screening scenario involves exactly 99,920 disease-free women and a 10 percent false-positive rate, which mathematically calculates to 9992, making 8993 incorrect.
Choice E: 10,012 represents the total number of positive test results in the new population, combining both true-positives and false-positives. The total positive results are calculated by adding the expected true-positives to the expected false-positives. Because this scenario yields 20 expected true-positives and 9992 expected false-positives, the combined total is 10,012, which does not answer the specific prompt for false-positives alone.
Block 5, Question 3
Correct Answer: E. Right parietalExplanation
This 73-year-old man presents with left-sided tactile extinction, left-sided spatial inattention causing him to bump into objects, and a left lower quadrantanopia with preserved motor, language, and proprioceptive function. This specific combination of contralateral hemispatial neglect and damage to the superior optic radiations localizes the brain lesion to the Right parietal.
The non-dominant parietal lobe, typically the right hemisphere, is responsible for spatial awareness and directing attention to the contralateral environment. Lesions here classically produce hemispatial neglect syndrome, characterized by a profound failure to acknowledge or respond to stimuli on the contralateral side despite intact primary sensory pathways. This explains why the patient bumps into objects on his left and exhibits tactile extinction, perceiving only right-sided stimuli during simultaneous bilateral testing. Furthermore, the parietal lobe houses the superior optic radiations, also known as Baum's loop. These fibers transmit visual information from the superior retina, representing the inferior visual field, to the occipital cortex.
Parietal lobe strokes most commonly result from ischemic occlusion of the middle cerebral artery inferior division. While primary somatosensory cortex damage can cause contralateral agraphesthesia and astereognosis, this patient's intact proprioception suggests the lesion primarily affects the posterior parietal association cortex rather than the postcentral gyrus. Patients with right parietal damage may also exhibit anosognosia, a severe denial of their own neurological deficits. Furthermore, constructional apraxia, such as the inability to draw a clock face or copy a simple figure, is a hallmark feature of non-dominant hemisphere parietal injury.
Key TakeawayWhy the Other Choices Are Wrong
- Non-dominant (right) parietal lobe lesions classically cause contralateral hemispatial neglect, manifesting as inattention to the left side of the body and space.
- Parietal lobe damage also disrupts the superior optic radiations (Baum's loop), resulting in a contralateral lower quadrantanopia.
Choice A: Left frontal lobe lesions typically involve the dominant hemisphere's motor and executive centers. Damage to the posterior inferior frontal gyrus causes Broca aphasia, characterized by nonfluent, effortful speech with intact comprehension. Primary motor cortex involvement produces contralateral right-sided hemiparesis, while frontal eye field damage causes gaze deviation toward the lesion. This patient's intact language and motor functions, alongside left-sided visual and attention deficits, make a left frontal lesion unlikely.
Choice B: Left parietal lobe lesions affect the dominant hemisphere in most individuals. Damage to the dominant inferior parietal lobule classically produces Gerstmann syndrome, characterized by agraphia, acalculia, finger agnosia, and left-right disorientation. Involvement of the superior optic radiations here would cause a right lower quadrantanopia. This patient's left-sided visual field defect and left-sided hemispatial neglect make a left parietal lesion unlikely.
Choice C: Left temporal lobe lesions typically impact the dominant hemisphere's language comprehension and visual pathways. Damage to the superior temporal gyrus causes Wernicke aphasia, characterized by fluent but nonsensical speech and poor comprehension. Disruption of Meyer's loop in the temporal lobe produces a contralateral right superior quadrantanopia. This patient's left lower quadrantanopia and lack of language deficits make a left temporal lesion unlikely.
Choice D: Right frontal lobe lesions affect the non-dominant hemisphere's motor and executive control areas. Damage to the primary motor cortex causes contralateral left-sided hemiparesis. Prefrontal cortex involvement leads to executive dysfunction and personality changes. Frontal eye field lesions cause gaze deviation to the right. This patient's isolated left-sided visual field defect and sensory neglect without any motor weakness make a right frontal lesion unlikely.
Choice F: Right temporal lobe lesions affect the non-dominant hemisphere's visual pathways and auditory processing centers. Damage to Meyer's loop, which carries visual fibers from the inferior retina through the temporal lobe, classically produces a contralateral left superior quadrantanopia. Non-dominant temporal lesions can also cause amusia or prosopagnosia. This patient's left lower quadrantanopia and prominent hemispatial neglect make a right temporal lesion unlikely.
Block 5, Question 4
Correct Answer: E. 22Explanation
This newborn girl presents with characteristic facial dysmorphism, a conotruncal cardiac defect, and hypocalcemic tetany. The combination of ocular hypertelorism, micrognathia, a short philtrum, an interrupted aortic arch, and hypocalcemia secondary to parathyroid hypoplasia strongly suggests DiGeorge syndrome, a condition caused by a microdeletion on chromosome 22.

DiGeorge syndrome is classically caused by a 22q11.2 microdeletion that disrupts the normal embryologic development of the third and fourth pharyngeal pouches. The third pouch normally gives rise to the inferior parathyroid glands and the thymus, while the fourth pouch forms the superior parathyroid glands. Aplasia of these structures directly results in the profound hypocalcemia and T-cell deficiency seen in these patients. Additionally, the genetic defect impairs normal neural crest cell migration into the branchial arches, causing craniofacial anomalies and severe conotruncal cardiac defects (interrupted aortic arch) that may require immediate palliative interventions like balloon septostomy.
Because the genetic loss is too small to be detected by standard karyotyping, definitive diagnosis requires fluorescence in situ hybridization or chromosomal microarray testing. The resulting thymic aplasia leads to a profound cellular immune deficiency, rendering affected infants highly susceptible to recurrent viral, fungal, and opportunistic infections. Management necessitates strict avoidance of live-attenuated vaccines to prevent disseminated disease. Furthermore, if these patients require transfusions during corrective cardiac surgeries, they must receive irradiated blood products to prevent fatal transfusion-associated graft-versus-host disease caused by donor T lymphocytes attacking the immunodeficient host.
Key TakeawayWhy the Other Choices Are Wrong
- DiGeorge syndrome is caused by a 22q11.2 microdeletion, resulting in abnormal development of the third and fourth pharyngeal pouches.
- Classic manifestations include conotruncal cardiac defects, abnormal facies, thymic hypoplasia (T-cell deficiency), and hypocalcemia secondary to parathyroid aplasia.
Choice A: A defect in chromosome 13 is the cause of Patau syndrome (trisomy 13). Patau syndrome typically presents with severe intellectual disability, microphthalmia, holoprosencephaly, cleft lip/palate, and polydactyly. Congenital heart defects, particularly ventricular septal defects, are common. This patient's specific combination of hypocalcemic tetany and an interrupted aortic arch without midline defects like holoprosencephaly makes a chromosome 13 defect unlikely.
Choice B: A defect involving chromosome 14 is most classically tested in the context of Robertsonian translocations, which commonly involve acrocentric chromosomes (13, 14, 15, 21, and 22). A balanced translocation between chromosomes 14 and 21 in a parent can lead to offspring with translocation Down syndrome. This patient's presentation of hypocalcemic tetany and an interrupted aortic arch points to a specific microdeletion syndrome, making chromosome 14 incorrect.
Choice C: A defect in chromosome 18 is the cause of Edwards syndrome (trisomy 18). Edwards syndrome classically manifests with severe intellectual disability, a prominent occiput, low-set ears, overlapping fingers (clenched fists), and rocker-bottom feet. Cardiac defects are nearly universal, most commonly ventricular septal defects. Although this patient has micrognathia, the specific presence of hypocalcemic tetany makes Edwards syndrome unlikely.
Choice D: A defect in chromosome 21 is the cause of Down syndrome (trisomy 21). Down syndrome presents with characteristic dysmorphic features including upslanting palpebral fissures, epicanthal folds, a single palmar crease, and hypotonia. The most common associated cardiac anomalies are endocardial cushion defects. This patient's interrupted aortic arch and hypocalcemic tetany are not characteristic of Down syndrome, making a chromosome 21 defect unlikely.
Video Review: Parietal Lobe
Block 5, Question 5
Correct Answer: E. Right atriumExplanation
This 76-year-old man presents with episodic palpitations, light-headedness, dyspnea, and fatigue in the setting of chronic alcohol use disorder. His ECG demonstrates an irregular ventricular rhythm with baseline undulating activity (often misinterpreted as variable P-waves or atrial fibrillation) representing sawtooth flutter waves, a pattern characteristic of atrial flutter. This macroreentrant arrhythmia is driven by a circuit located in the Right atrium.
Atrial flutter is a supraventricular tachycardia caused by a macroreentrant electrical circuit. The most common pathway, typical atrial flutter, travels around the tricuspid valve annulus and is critically dependent on the cavotricuspid isthmus, located in the right atrium between the inferior vena cava and tricuspid valve. This loop generates a rapid atrial rate of approximately 300/min, producing a classic sawtooth pattern on ECG, most prominent in inferior leads. The AV node protects the ventricles by imposing a physiologic atrioventricular block (e.g., variable conduction), explaining this patient's irregular ventricular rhythm.
Chronic alcohol consumption (evidenced by his recurrent pancreatitis) is a well-known trigger for supraventricular arrhythmias, classically termed holiday heart syndrome. While atrial flutter is more organized than atrial fibrillation, it carries a similarly high risk of left atrial appendage stasis and subsequent thromboembolic stroke. Consequently, patients require systemic anticoagulation based on standard risk stratification. For long-term management, rate control or antiarrhythmics can be used, but definitive treatment for recurrent typical atrial flutter involves radiofrequency catheter ablation of the isthmus to permanently interrupt the reentrant circuit.
Key TakeawayWhy the Other Choices Are Wrong
- Atrial flutter is a macroreentrant supraventricular tachycardia that produces a sawtooth ECG pattern and originates in the right atrium at the cavotricuspid isthmus.
- Alcohol use is a common trigger for atrial arrhythmias, which carry a significant risk of thromboembolism requiring anticoagulation.
Choice A: The atrioventricular node is the origin site for AV nodal reentrant tachycardia, the most common paroxysmal supraventricular tachycardia. It classically presents with a regular, narrow-complex tachycardia and absent or retrograde P waves buried within the QRS complex. This patient's irregular ventricular rhythm and distinct baseline atrial activity make an AV node origin unlikely.
Choice B: The bundle of His can be the origin for junctional tachycardias. These are characterized by a regular, narrow-complex rhythm, often with AV dissociation or retrograde P waves appearing shortly after the QRS complex. This patient's irregular rhythm and the presence of distinct atrial flutter waves rule out a primary bundle of His arrhythmia.
Choice C: The left ventricle is a common origin site for ventricular arrhythmias, such as ventricular tachycardia. These characteristically present with wide QRS complexes (≥120 ms) because the impulse spreads slowly outside the normal conduction system. This patient's narrow QRS complexes and organized atrial baseline activity make a left ventricle origin unlikely.
Choice D: The Purkinje fibers can initiate premature ventricular contractions or idiopathic ventricular tachycardias. Because these impulses originate in the distal conduction system, they produce wide, bizarre QRS complexes that do not follow normal rapid conduction pathways. This patient's narrow-complex irregular rhythm with visible atrial activity makes a Purkinje fibers origin unlikely.
Choice F: The sinoatrial node is the normal cardiac pacemaker, and arrhythmias originating here include sinus tachycardia and sick sinus syndrome. Sinus tachycardia presents with a regular rhythm and normal P waves preceding every QRS complex, while sick sinus syndrome typically shows sinus pauses. This patient's rapid, undulating atrial activity without normal P waves makes a sinoatrial node origin unlikely.
Block 5, Question 6
Correct Answer: D. Inhibition of cyclooxygenase-1Explanation
This 52-year-old woman with severe obesity presents with hematemesis, epigastric tenderness, positive stool occult blood, and signs of hypovolemic shock (tachycardia and hypotension) in the setting of chronic oral nonsteroidal anti-inflammatory drug use. Her presentation is highly suspicious for a bleeding peptic ulcer caused by decreased synthesis of protective gastric prostaglandins secondary to systemic inhibition of cyclooxygenase-1.
Nonsteroidal anti-inflammatory drugs (NSAIDs) like ibuprofen provide analgesia by inhibiting cyclooxygenase enzymes, but this nonselective action frequently leads to gastrointestinal toxicity. Cyclooxygenase-1 is constitutively expressed in the gastrointestinal tract, where it synthesizes prostaglandin E2 and prostacyclin. These lipid mediators are crucial for maintaining the protective gastric barrier by stimulating mucus and bicarbonate secretion from epithelial cells. Furthermore, prostaglandins maintain adequate gastric mucosal blood flow, which promotes rapid epithelial restitution and clears back-diffused hydrogen ions. When NSAIDs block this pathway, the gastric mucosa becomes highly susceptible to acidic damage, leading to erosions, ulceration, and potentially severe upper gastrointestinal bleeding.
While this patient also uses topical diclofenac for her weight-bearing osteoarthritis, topical formulations have minimal systemic absorption and carry a significantly lower risk of gastrointestinal complications compared to oral NSAIDs. For patients requiring chronic NSAID therapy who are at high risk for peptic ulcer disease, co-administration of proton pump inhibitors provides effective prophylaxis by directly suppressing gastric acid secretion. Alternatively, misoprostol, a synthetic prostaglandin analog, can be used to replace the deficient mucosal protective factors. Another strategy involves switching to selective COX-2 inhibitors like celecoxib, which spare the constitutively expressed gastrointestinal enzymes while providing targeted anti-inflammatory effects.
Key TakeawayWhy the Other Choices Are Wrong
- Nonselective NSAIDs cause peptic ulcers primarily through systemic inhibition of COX-1, which depletes protective gastric prostaglandins.
- Prostaglandins protect the gastric mucosa by stimulating mucus and bicarbonate secretion while maintaining adequate mucosal blood flow.
Choice A: Generation of nitric oxide represents a protective mechanism for the gastric mucosa rather than a cause of ulceration. Nitric oxide promotes vasodilation, enhancing mucosal blood flow and facilitating the clearance of damaging acid while supporting tissue repair. This patient's acute upper gastrointestinal bleeding and chronic NSAID use point toward prostaglandin depletion rather than increased nitric oxide generation.
Choice B: Increased prostaglandin production is the physiological response to mucosal injury that promotes healing and maintains the gastric barrier. Prostaglandins stimulate protective mucus secretion and inhibit parietal cell acid production. This patient's regular consumption of oral ibuprofen directly decreases, rather than increases, prostaglandin synthesis, making this an incorrect mechanism for her bleeding ulcer.
Choice C: Induction of pro-inflammatory cytokines is a primary mechanism of mucosal damage in Helicobacter pylori infection. This bacterium colonizes the gastric epithelium and secretes virulence factors that trigger a robust local immune response, leading to chronic gastritis and ulceration. While H. pylori is a major cause of ulcers, this patient's heavy reliance on oral ibuprofen points directly to drug-induced mucosal damage.
Choice E: Pre-absorptive topical injury to gastric epithelial cells occurs because NSAIDs are weak acids that remain non-ionized in the stomach, allowing them to enter and damage mucosal cells directly. This mechanism causes minor superficial erosions. However, this patient's severe bleeding and shock indicate a deep, penetrating ulcer, which is primarily driven by systemic prostaglandin depletion rather than local pre-absorptive irritation.
Video Review: Dilated Cardiomyopathy
Block 5, Question 7
Correct Answer: A. DeformationExplanation
This male newborn presents with small size for gestational age and bilateral clubfoot following a pregnancy complicated by oligohydramnios secondary to uteroplacental insufficiency. The presence of structurally normal tissue that is physically compressed by decreased amniotic fluid volume resulting in an altered shape is characteristic of a deformation.
Deformations occur when extrinsic mechanical forces alter the shape or position of an otherwise intrinsically normal developing structure. This process typically happens later in gestation during the fetal period. Oligohydramnios is a classic cause because amniotic fluid normally provides a protective cushion that allows free fetal movement and growth. Without adequate fluid, the uterine walls exert prolonged pressure on the fetus. This chronic mechanical compression frequently leads to musculoskeletal anomalies like talipes equinovarus (clubfoot), characterized by plantarflexed and inverted feet. Another severe manifestation of prolonged oligohydramnios is Potter sequence, which involves flattened facies and pulmonary hypoplasia.
The underlying uteroplacental insufficiency in this patient also explains the small for gestational age status, as chronic reduction in blood flow restricts fetal nutrient and oxygen delivery, leading to asymmetric fetal growth restriction. Despite this chronic intrauterine stress, the newborn's Apgar scores of 7 and 9 indicate a successful cardiopulmonary transition at birth, reflecting normal immediate postnatal vitality. Management of clubfoot typically involves the Ponseti method, utilizing serial casting to gradually correct the deformity, followed by bracing to prevent relapse. If conservative measures fail, surgical intervention such as an Achilles tenotomy may be required.
Key TakeawayWhy the Other Choices Are Wrong
- A deformation is a structural anomaly caused by extrinsic mechanical forces acting on intrinsically normal tissue, typically occurring late in gestation.
- Oligohydramnios limits the protective amniotic fluid cushion, leading to fetal compression and deformations such as clubfoot.
Choice B: Disruption is a developmental defect caused by the secondary destruction of an organ or body region that was previously developing normally. This typically occurs due to extrinsic insults such as vascular occlusion, infections, or amniotic bands, leading to structural loss like missing digits. This patient's intact, albeit abnormally positioned, feet and the history of oligohydramnios-induced compression make a disruption unlikely.
Choice C: Dysplasia refers to the abnormal cellular organization or function within a specific tissue type throughout the body. This process results in structural anomalies that affect all structures derived from that tissue, such as abnormal bone formation in osteogenesis imperfecta. This patient's isolated foot deformity without systemic skeletal abnormalities or features of a generalized connective tissue disorder makes dysplasia unlikely.
Choice D: Malformation is a primary structural defect arising from an intrinsically abnormal developmental process, typically occurring during the embryonic period. These errors in tissue formation lead to congenital anomalies such as neural tube defects, cleft lip, or congenital heart defects. This patient's isolated clubfoot, which arose from mechanical compression later in pregnancy rather than an early intrinsic error, makes malformation unlikely.
Block 5, Question 8
Correct Answer: B. Decreased Fremitus, Hyperresonant Percussion, Decreased Breath SoundsExplanation
This 19-year-old man presents with tachycardia, tachypnea, and contralateral tracheal deviation following a penetrating right chest injury, findings highly suspicious for a right-sided tension pneumothorax. In this life-threatening condition, air accumulates in the pleural space without an escape route, compressing the ipsilateral lung and shifting mediastinal structures. Consequently, pulmonary examination of the affected side will characteristically demonstrate Decreased Fremitus, Hyperresonant Percussion, Decreased Breath Sounds.
A pneumothorax occurs when air enters the pleural space, uncoupling the lung from the chest wall and causing partial or complete collapse. Because air is a poor conductor of low-frequency sound waves compared to solid tissue, tactile fremitus is markedly diminished over the affected area. Similarly, the insulating layer of extra-alveolar air attenuates the transmission of acoustic energy from the airways to the stethoscope, resulting in decreased or absent breath sounds. Finally, the abnormal accumulation of trapped air within the hemithorax produces a hollow, drum-like reflection upon striking the chest wall, known clinically as hyperresonance to percussion.
This patient's contralateral tracheal deviation indicates the progression to a tension pneumothorax, a critical emergency where a one-way valve effect allows air entry during inspiration but prevents its escape. The rapidly expanding intrathoracic pressure compresses the superior and inferior vena cava, leading to decreased venous return and subsequent obstructive shock. This manifests with tachycardia, tachypnea, and impending hypotension. Management must not be delayed for radiographic confirmation; it requires immediate needle thoracostomy in the second intercostal space at the midclavicular line or the fifth intercostal space at the midaxillary line, followed by definitive placement of a chest tube.

Why the Other Choices Are Wrong
- Tension pneumothorax presents with decreased tactile fremitus, hyperresonant percussion, and decreased breath sounds due to air accumulation in the pleural space.
- Contralateral tracheal deviation and hemodynamic compromise indicate tension physiology, requiring immediate needle decompression.
Choice A: Decreased fremitus, dull percussion, and decreased breath sounds are the classic physical examination findings associated with a pleural effusion. An accumulation of fluid in the pleural cavity acts as an acoustic insulator, diminishing breath sounds and fremitus, while the dense fluid produces a dull sound upon percussion. Although penetrating trauma can cause a hemothorax, this patient's contralateral tracheal deviation and mechanism strongly favor a tension pneumothorax.
Choice C: Decreased fremitus, hyperresonant percussion, and dull breath sounds is an incorrect combination of physical examination findings. While hyperresonance and decreased fremitus correctly describe a pneumothorax, breath sounds are characterized by their intensity or quality (e.g., vesicular, bronchial), not by "dullness." Dullness is strictly a percussion note used to describe solid organs or fluid. This patient's tension pneumothorax would yield decreased breath sounds, making this descriptive combination invalid.
Choice D: Increased fremitus, dull percussion, and bronchial breath sounds are the hallmark physical examination findings of pulmonary consolidation, such as lobar pneumonia. When alveolar air is replaced by inflammatory exudate, the solid medium conducts vocal vibrations efficiently, increasing tactile fremitus. The dense consolidation also produces percussion dullness and transmits harsh bronchial breath sounds. This patient's acute penetrating chest trauma and contralateral tracheal shift point to pleural air, not alveolar consolidation.
Choice E: Increased fremitus, dull percussion, and decreased breath sounds is a mixed clinical picture occasionally seen in severe consolidation with an obstructing bronchial mucous plug. Consolidation increases fremitus and produces a dull percussion note, but an obstructed airway prevents airflow, diminishing breath sounds over the affected area. This patient's acute presentation following a knife wound with tracheal deviation indicates a tension pneumothorax, which presents with hyperresonance rather than dullness.
Video Review: Pneumothorax
Block 5, Question 9
Correct Answer: D. PolychromasiaExplanation
This 22-year-old man presents with acute hemorrhage resulting in a 20% total volume blood loss following a motor vehicle collision. Immediate surgical control halts further loss, allowing the bone marrow to mount a compensatory erythropoietic response. By 10 days post-injury, this increased red blood cell production will manifest on a peripheral smear as polychromasia.
Acute hemorrhage reduces blood oxygen-carrying capacity, causing transient tissue hypoxia. The kidneys detect this decreased oxygen tension and respond by increasing the release of erythropoietin. This hormone stimulates the bone marrow to accelerate red blood cell production and prematurely release immature erythrocytes, known as reticulocytes, into the circulation. On a standard Wright-Giemsa stained smear, these immature cells appear larger than mature erythrocytes and exhibit a bluish-purple hue. This distinct coloration results from residual ribosomal RNA that continues to translate globin chains before the cell fully matures.
The reticulocyte response begins within three days of acute blood loss and peaks at approximately seven to ten days, aligning precisely with this patient's timeline. While standard stains reveal the bluish tint of polychromasia, a supravital stain is required to directly visualize the reticular network of RNA precipitates. A robust polychromatophilic response confirms an intact bone marrow. Conversely, an absent reticulocyte response following acute blood loss or hemolysis strongly suggests underlying bone marrow failure or a profound deficiency in essential substrates like iron.
Key TakeawayWhy the Other Choices Are Wrong
- Acute blood loss stimulates erythropoietin release, leading to a compensatory increase in reticulocytes that peaks at 7-10 days.
- On a standard peripheral smear, reticulocytes appear as larger, bluish-purple cells (polychromasia) due to residual ribosomal RNA.
Choice A: Heinz bodies are inclusions of denatured, precipitated hemoglobin that typically form due to oxidative stress. They are classically seen in glucose-6-phosphate dehydrogenase deficiency, where impaired glutathione production leaves red blood cells vulnerable to oxidative damage. This patient's acute traumatic hemorrhage without a history of oxidative triggers makes Heinz bodies unlikely.
Choice B: Hypochromia describes red blood cells with an expanded area of central pallor, reflecting decreased hemoglobin content. It is a hallmark feature of microcytic anemias, most notably iron deficiency anemia, thalassemia, and lead poisoning, which develop over weeks to months. This patient's bleeding was immediately controlled, preventing the chronic iron depletion necessary to produce hypochromic red blood cells.
Choice C: Microspherocytosis refers to the presence of small, dense red blood cells lacking central pallor. These cells are characteristically found in hereditary spherocytosis due to cytoskeletal membrane defects, or in autoimmune hemolytic anemia where macrophages remove portions of antibody-coated erythrocyte membranes. This patient's acute traumatic blood loss without evidence of intrinsic membrane defects or immune-mediated hemolysis makes microspherocytosis unlikely.
Choice E: Siderotic granules are iron-containing inclusions within red blood cells, known as Pappenheimer bodies when visualized on standard peripheral smears. They are characteristically seen in sideroblastic anemia, where defective heme synthesis leads to iron accumulation within mitochondria, or following splenectomy. This patient's acute blood loss and intact spleen without evidence of impaired heme synthesis make siderotic granules unlikely.
Block 5, Question 10
Correct Answer: B. Vitamin AExplanation
This 53-year-old man presents with a dry scaly rash, severe weight loss, and steatorrhea. These findings indicate a state of generalized malabsorption leading to the depletion of fat-soluble vitamins. The specific dermatologic manifestation of xerosis cutis in this context is caused by a deficiency in vitamin A.
Steatorrhea, characterized by large-volume, floating stools, occurs when the gastrointestinal tract fails to properly absorb dietary lipids. This condition commonly arises from pancreatic insufficiency, biliary tract disease, or intestinal mucosal defects. Because lipids are excreted rather than absorbed, patients concurrently lose the fat-soluble vitamins A, D, E, and K. Vitamin A, also known as retinol, is essential for the normal differentiation of epithelial cells into specialized tissue. Without adequate levels, patients develop follicular hyperkeratosis, which presents clinically as dry, scaly, and roughened skin. Severe deficiency also impairs the production of rhodopsin, leading to night blindness.
Beyond dermatologic and visual symptoms, severe depletion of this nutrient causes significant ocular surface changes, including Bitot spots, which are characteristic foamy plaques on the bulbar conjunctiva. It also plays a critical role in immune function, and deficient patients are particularly susceptible to severe complications from the measles virus. Conversely, excessive intake can lead to acute toxicity presenting with nausea and increased intracranial pressure, or chronic toxicity characterized by alopecia, hepatomegaly, and teratogenesis. Therefore, careful monitoring is required when supplementing this vitamin in patients with chronic malabsorption syndromes.

Why the Other Choices Are Wrong
- Fat malabsorption (steatorrhea) leads to deficiencies in the fat-soluble vitamins A, D, E, and K.
- Vitamin A deficiency typically presents with night blindness, generalized dry scaly skin (follicular hyperkeratosis), and ocular manifestations like Bitot spots.
Choice A: Magnesium deficiency can occur in chronic malabsorption, but it produces different clinical manifestations. Severe hypomagnesemia classically causes neuromuscular excitability, including tremors, tetany, and seizures, as well as cardiac arrhythmias like torsades de pointes. It also impairs parathyroid hormone release, leading to secondary hypocalcemia. This patient's isolated presentation of a dry scaly rash without neuromuscular irritability or cardiac abnormalities makes magnesium deficiency unlikely.
Choice C: Vitamin B12 (cobalamin) deficiency frequently occurs in malabsorption syndromes affecting the terminal ileum, such as Crohn disease. Depletion of this water-soluble vitamin impairs DNA synthesis, resulting in megaloblastic anemia, glossitis, and subacute combined degeneration of the spinal cord with symmetric paresthesias and ataxia. This patient's prominent dermatologic findings and lack of neurologic symptoms or reported anemia make a primary vitamin B12 deficiency unlikely.
Choice D: Vitamin C (ascorbic acid) deficiency causes scurvy due to impaired collagen hydroxylation. Scurvy classically manifests with perifollicular hemorrhages, easy bruising, petechiae, gingival swelling with bleeding, and poor wound healing. Patients may also develop corkscrew hairs. While this patient is malnourished, his dry scaly rash and steatorrhea point toward a fat-soluble vitamin issue rather than the hemorrhagic manifestations of vitamin C deficiency.
Choice E: Zinc deficiency can result from severe malnutrition or malabsorption, but its dermatologic presentation differs. Inadequate zinc levels cause acrodermatitis enteropathica, characterized by well-demarcated, erythematous, vesiculobullous, and pustular lesions primarily located around the body orifices and on the extremities. It also causes alopecia, hypogonadism, and dysgeusia. This patient's generalized dry scaly rash lacks the specific periorificial and acral distribution seen in zinc deficiency.
Video Review: Vitamin A
Block 5, Question 11
Correct Answer: C. Oxygen Tension: Decreased, Osmolality: IncreasedExplanation
This 22-year-old woman presents with isolated painless hematuria and CT evidence of renal papillary necrosis in the setting of sickle cell disease. The unique microenvironment of the renal medulla promotes hemoglobin polymerization and subsequent vaso-occlusion, leading to ischemic damage of the renal papillae. This sickling process is specifically triggered by medullary conditions characterized by Oxygen Tension: Decreased, Osmolality: Increased.
The renal medulla possesses a distinct physiologic environment that makes it highly susceptible to ischemic injury in patients with sickle cell disease or sickle cell trait. Blood supply to the medulla is provided by the vasa recta, which have sluggish, low-volume blood flow resulting in a naturally hypoxic state. Furthermore, the countercurrent multiplier system creates a steep concentration gradient, leading to extreme medullary hypertonicity. The combination of low oxygen tension, high osmolality, and low pH promotes the deoxygenation and dehydration of erythrocytes. This environment accelerates hemoglobin S polymerization, causing red blood cells to sickle, occlude medullary capillaries, and induce microinfarctions.
Recurrent microinfarctions in the renal medulla ultimately culminate in the sloughing of the renal papillae, a condition known as renal papillary necrosis. Patients typically present with gross hematuria and may experience colicky flank pain if sloughed tissue obstructs the ureter, though this patient's lack of pain, nausea, and urinary symptoms makes concurrent nephrolithiasis or infection unlikely. Beyond sickle cell hemoglobinopathies, other classic triggers for this condition include chronic analgesic nephropathy, severe acute pyelonephritis, and poorly controlled diabetes mellitus. Management is generally supportive with hydration and pain control, though severe cases may require intervention to relieve urinary tract obstruction.
Key TakeawayWhy the Other Choices Are Wrong
- The renal medulla is characterized by low oxygen tension, high osmolality, and low pH.
- This unique environment promotes hemoglobin S polymerization and erythrocyte sickling, predisposing patients with sickle cell disease to microinfarctions and renal papillary necrosis.
Choice A: Increased oxygen tension and increased osmolality do not accurately describe the renal medullary environment. While the medulla is hyperosmolar to concentrate urine, its restricted blood supply results in a naturally hypoxic state. High oxygen tension prevents erythrocyte sickling rather than promoting it. This patient's development of papillary necrosis indicates a hypoxic medullary environment triggered vaso-occlusion, making increased oxygen tension incorrect.
Choice B: Increased oxygen tension and decreased osmolality represent the opposite of the physiologic conditions found in the renal medulla. The renal cortex, which receives the vast majority of renal blood flow, exhibits higher oxygen tension and lower osmolality compared to the medulla. This patient's localized medullary damage, evidenced by papillary necrosis on CT, requires an environment of low oxygen and high osmolality, ruling out this combination.
Choice D: Decreased oxygen tension and decreased osmolality incorrectly characterize the osmotic gradient of the kidney. Although the medulla is hypoxic, it maintains a highly concentrated interstitium essential for water reabsorption. A hypotonic or isotonic environment would fail to dehydrate red blood cells, thereby reducing the risk of sickling. This patient's sickle cell-induced papillary necrosis relies on the dehydrating effects of a hyperosmolar medulla, making decreased osmolality incorrect.
Block 5, Question 12
Correct Answer: C. LeukotrieneExplanation
This 32-year-old woman, who takes no medications, presents with high fever, tachycardia, nausea, vomiting, and right lower quadrant rebound tenderness leading to an appendectomy. The photomicrograph of the resected appendix demonstrates a dense neutrophilic infiltrate within the appendiceal wall, characteristic of acute appendicitis. The accumulation of these inflammatory cells at the site of infection is primarily mediated by potent chemotactic factors, including Leukotriene.
Acute appendicitis is typically initiated by obstruction of the appendiceal lumen, leading to bacterial overgrowth and a robust acute inflammatory response. The hallmark of acute inflammation is the recruitment of neutrophils from the vasculature to the site of tissue injury. This process relies on a chemical gradient to guide leukocyte migration. Leukotriene B4 is an arachidonic acid metabolite produced by the lipoxygenase pathway in active leukocytes. It serves as a highly potent mediator of neutrophil chemotaxis, binding to specific cell surface receptors to stimulate targeted migration and reactive oxygen species production for bacterial killing.
In addition to arachidonic acid metabolites, several other mediators drive the recruitment of polymorphonuclear cells during acute bacterial infections. The complement cascade generates C5a, a potent anaphylatoxin that upregulates adhesion molecules and strongly attracts neutrophils. Macrophages residing in the affected tissue secrete interleukin-8, a major cytokine responsible for inducing neutrophil migration and activation. Furthermore, exogenous bacterial formyl peptides released during pathogen multiplication act as direct chemoattractants. Together, these mediators ensure rapid accumulation of neutrophils in the appendiceal wall, resulting in the dense purulent infiltrate observed on histopathology.
Key TakeawayWhy the Other Choices Are Wrong
- Neutrophil chemotaxis during acute inflammation is primarily mediated by Leukotriene B4, C5a, Interleukin-8, and bacterial formyl peptides.
- Leukotriene B4 is an arachidonic acid metabolite produced via the lipoxygenase pathway that strongly attracts neutrophils to sites of tissue injury.
Choice A: Bradykinin is a vasoactive nonapeptide generated from high-molecular-weight kininogen by the action of kallikrein during tissue injury. It classically mediates vasodilation, increased vascular permeability, and the sensation of pain in acute inflammation. This patient's severe abdominal pain is partially mediated by bradykinin, but this molecule lacks chemotactic properties and would not cause the dense neutrophilic infiltrate seen on the photomicrograph.
Choice B: Histamine is a biogenic amine stored in the granules of mast cells, basophils, and platelets. It is released immediately upon tissue injury or IgE cross-linking, causing profound vasodilation of arterioles and increased permeability of postcapillary venules. While histamine initiates the early vascular phase of acute inflammation, it is not a chemoattractant and cannot explain this patient's appendiceal accumulation of neutrophils.
Choice D: Lipoxin is an anti-inflammatory eicosanoid generated from arachidonic acid through transcellular biosynthesis involving lipoxygenase pathways in leukocytes and platelets. It actively promotes the resolution of acute inflammation by inhibiting neutrophil chemotaxis and stimulating macrophage efferocytosis of apoptotic cells. This patient's active acute appendicitis with a dense, progressive neutrophilic infiltrate indicates an ongoing pro-inflammatory state rather than lipoxin-mediated resolution.
Choice E: Thromboxane is a prostanoid synthesized from arachidonic acid via the cyclooxygenase pathway, primarily within platelets. It functions as a potent vasoconstrictor and a critical mediator of platelet aggregation during primary hemostasis. Although thromboxane plays a major role in vascular injury and thrombosis, it lacks chemotactic activity and is not responsible for the massive neutrophil recruitment observed in this patient's resected appendix.
Block 5, Question 13
Correct Answer: B. Brief psychotic disorderExplanation
This 15-year-old boy presents with acute-onset agitation, disorganized speech, paranoia, and auditory and visual hallucinations following a recent psychological stressor. His sudden onset of multiple psychotic symptoms lasting less than one month, in the absence of substance use or medical abnormalities, is characteristic of brief psychotic disorder.
Brief psychotic disorder is characterized by the sudden onset of at least one of the core positive psychotic symptoms, which include delusions, hallucinations, and disorganized speech. Grossly disorganized or catatonic behavior may also be present. The defining temporal feature is a symptom duration of at least one day but less than one month. Following the episode, patients experience a complete return to premorbid functioning. While not strictly required for diagnosis, episodes frequently occur in response to a significant psychological stressor, as seen in this patient whose symptoms began shortly after learning about a school shooting.
The psychiatric diagnosis of primary psychotic disorders relies heavily on symptom duration. If this patient's symptoms persist beyond one month but resolve before six months, the diagnosis would be reclassified as schizophreniform disorder. Furthermore, before diagnosing a primary psychiatric condition, clinicians must exclude physiological causes; this patient's negative urine toxicology screening, normal routine laboratory studies, and normal vital signs effectively rule out a substance-induced psychotic disorder or underlying medical etiology. Acute management prioritizes patient safety, often requiring psychiatric hospitalization given his paranoia and weapon possession, alongside a short course of second-generation antipsychotics to target dopamine and serotonin receptors.
Key TakeawayWhy the Other Choices Are Wrong
- Brief psychotic disorder presents with at least one psychotic symptom (delusions, hallucinations, disorganized speech) lasting between 1 day and 1 month.
- The episode is often triggered by a significant stressor and is followed by a full return to baseline functioning.
Choice A: Adjustment disorder with anxiety involves the development of disproportionate anxiety symptoms within three months of an identifiable stressor. Patients typically exhibit excessive worry, nervousness, or jitteriness that impairs social or occupational functioning, but they maintain intact reality testing and do not experience frank psychosis. This patient's auditory hallucinations, visual hallucinations, and paranoid delusions indicate a break from reality, which makes adjustment disorder with anxiety unlikely.
Choice C: Post-traumatic stress disorder (PTSD) is a trauma-related condition triggered by experiencing or witnessing a life-threatening event. Core features include intrusive memories, nightmares, avoidance of trauma reminders, negative mood alterations, and hyperarousal lasting longer than one month. This patient's symptom duration of only one week and lack of direct trauma exposure make PTSD unlikely.
Choice D: Schizophrenia is a chronic, severe psychiatric disorder characterized by a combination of positive, negative, and cognitive symptoms. Diagnosis requires at least two psychotic symptoms (with at least one being delusions, hallucinations, or disorganized speech) and continuous signs of the disturbance persisting for at least six months. This patient's acute symptom onset of only one week makes schizophrenia unlikely.
Choice E: Schizotypal personality disorder is a Cluster A personality disorder characterized by a pervasive pattern of social deficits and eccentricities. Individuals exhibit odd beliefs, magical thinking, unusual perceptual experiences, and paranoid ideation, but these traits are chronic and ego-syntonic. This patient's acute onset of true hallucinations and disorganized speech following a period of normal functioning makes a chronic personality disorder unlikely.
Block 5, Question 14
Correct Answer: B. EnterovirusExplanation
This 10-year-old boy presents with fever, headache, photophobia, and nuchal rigidity in the setting of a summer camp outbreak. His cerebrospinal fluid analysis reveals a normal opening pressure, normal glucose relative to serum levels, mildly elevated protein, and a lymphocytic pleocytosis, indicating aseptic meningitis. Given the summer seasonality and highly contagious nature among children, the most likely causative infectious agent is an Enterovirus.
Enteroviruses, including echovirus and coxsackievirus, are small, non-enveloped, positive-sense single-stranded RNA viruses responsible for the vast majority of viral meningitis cases. Transmission occurs primarily via the fecal-oral route, making outbreaks highly prevalent among children in close-contact settings such as summer camps or daycares. The incidence peaks during the summer and early fall months. The cerebrospinal fluid profile in viral meningitis classically demonstrates a lymphocytic pleocytosis, normal glucose levels, and normal to mildly elevated protein levels. This contrasts sharply with bacterial meningitis, which typically presents with a neutrophilic pleocytosis and marked hypoglycorrhachia.
The clinical course of enteroviral meningitis is generally self-limited and benign compared to bacterial etiologies. Management consists primarily of supportive care, including antipyretics, analgesics, and adequate hydration. Patients typically recover fully within one to two weeks without permanent neurological sequelae. Diagnosis is most accurately and rapidly confirmed using polymerase chain reaction testing of the cerebrospinal fluid, which has largely replaced viral culture due to its high sensitivity and quick turnaround time. Notably, while enteroviruses are the most common etiology, other viruses like the mumps virus can also cause aseptic meningitis, particularly in unvaccinated populations.

Why the Other Choices Are Wrong
- Enteroviruses are the most common cause of viral meningitis, frequently presenting as summer outbreaks among children due to fecal-oral transmission.
- Viral meningitis cerebrospinal fluid typically shows a lymphocytic pleocytosis, normal glucose, and normal to mildly elevated protein.
Choice A: Adenovirus is a non-enveloped, double-stranded DNA virus that commonly causes pharyngoconjunctival fever, gastroenteritis, and acute respiratory tract infections. Outbreaks frequently occur in crowded environments like military barracks or summer camps, often linked to poorly chlorinated swimming pools. This patient's classic meningeal signs and lymphocytic cerebrospinal fluid profile make an isolated adenovirus infection unlikely, as it rarely causes meningitis.
Choice C: Herpes simplex virus is an enveloped, double-stranded DNA virus that can cause viral meningitis, particularly herpes simplex virus type 2. Genital lesions typically precede or accompany the neurological symptoms. Herpes simplex virus type 1 classically causes a severe, necrotizing encephalitis localizing to the temporal lobes, presenting with altered mental status and seizures. This patient's lack of genital lesions, intact sensorium, and summer camp outbreak history make this etiology unlikely.
Choice D: Neisseria meningitidis is a Gram-negative diplococcus that causes bacterial meningitis, often presenting in outbreaks among adolescents and young adults in crowded living conditions. Cerebrospinal fluid analysis classically demonstrates an elevated opening pressure, marked neutrophilic pleocytosis, elevated protein, and significantly decreased glucose. This patient's normal cerebrospinal fluid glucose and lymphocytic predominance make a bacterial etiology unlikely.
Choice E: Streptococcus pneumoniae is a Gram-positive, lancet-shaped diplococcus and the most common cause of bacterial meningitis in adults and children. Patients typically present with acute, severe meningeal signs, often preceded by otitis media or pneumonia. Cerebrospinal fluid analysis reveals profound hypoglycorrhachia, highly elevated protein, and a robust neutrophilic pleocytosis. This patient's normal cerebrospinal fluid glucose and 95% lymphocytes rule out this bacterial pathogen.
Block 5, Question 15
Correct Answer: B. Decreased respiratory muscle strengthExplanation
This 85-year-old woman with cachexia presents with progressive dyspnea, decreased diaphragmatic excursion, and a restrictive pulmonary function pattern (eg, narrow flow-volume loop) with a normal diffusing capacity for carbon monoxide and an elevated residual volume. These findings indicate an extrapulmonary restrictive lung defect caused by decreased respiratory muscle strength..
Restrictive lung diseases are characterized by a proportional decrease in both forced expiratory volume in 1 second (FEV1) and forced vital capacity (FVC), resulting in a normal or increased FEV1/FVC ratio alongside a decreased total lung capacity. To differentiate the underlying etiology, clinicians evaluate the diffusing capacity for carbon monoxide (DLCO). A normal DLCO indicates an intact alveolar-capillary membrane, ruling out intrinsic fibrotic lung diseases. Extrapulmonary restriction is further divided into chest wall abnormalities (such as severe kyphoscoliosis) and neuromuscular weakness (such as amyotrophic lateral sclerosis or severe sarcopenia). In neuromuscular weakness, inspiratory muscle fatigue prevents full lung expansion, while expiratory muscle weakness prevents maximal exhalation, uniquely resulting in an elevated residual volume.
This patient's profound cachexia and low body mass index have led to severe sarcopenia, causing progressive diaphragmatic and accessory respiratory muscle weakness. This is evidenced by her significantly reduced diaphragmatic excursion. As respiratory muscle strength declines, patients develop alveolar hypoventilation, which manifests as hypercapnia and primary respiratory acidosis (eg, pH 7.33, PCO2 48 mm Hg) on arterial blood gas analysis. Management focuses on addressing the underlying nutritional deficit and providing noninvasive positive pressure ventilation to support the work of breathing and correct the hypercapnia.
Key TakeawayWhy the Other Choices Are Wrong
- Extrapulmonary restrictive lung disease due to neuromuscular weakness presents with a low total lung capacity, normal diffusing capacity for carbon monoxide, and an elevated residual volume due to expiratory muscle fatigue. Severe cachexia can cause diaphragmatic weakness and hypoventilation.
Choice A: Decreased lung elasticity is the primary pathophysiologic mechanism of emphysema, which leads to hyperinflation and an obstructive pulmonary function pattern. This is characterized by a decreased FEV1/FVC ratio and a decreased diffusing capacity for carbon monoxide due to alveolar destruction. This patient's normal diffusing capacity, low total lung capacity, and FEV1/FVC ratio of 1.0 make decreased lung elasticity unlikely.
Choice C: Decreased surfactant production occurs when type II pneumocytes are injured, most classically in acute respiratory distress syndrome which is characterized histologically by diffuse alveolar damage. Loss of surfactant raises alveolar surface tension, causing collapse, decreased lung compliance, and hypoxemia. Underlying insults such as sepsis, aspiration, trauma, and pancreatitis share this common pathway of type II pneumocyte dysfunction.
Choice D: Increased alveolar surface tension occurs in acute respiratory distress syndrome due to inflammatory exudate, characterized by noncardiogenic pulmonary edema, severe hypoxemia, and bilateral infiltrates following an acute insult. This patient's chronic 4-month progressive course, pulmonary examination showing no abnormalities, and normal diffusing capacity for carbon monoxide make increased alveolar surface tension unlikely.
Choice E: Increased bronchial mucous secretions are the hallmark of chronic bronchitis, which is characterized by a chronic productive cough, wheezing, and an obstructive pulmonary function pattern with a decreased FEV1/FVC ratio and normal diffusing capacity. This patient's pulmonary auscultation showing no abnormalities and restrictive pulmonary function pattern make increased bronchial mucous secretions unlikely.
Choice F: Increased lung compliance occurs in emphysema due to alveolar septal destruction, resulting in an obstructive pulmonary function pattern, hyperinflation, and a decreased diffusing capacity for carbon monoxide. This patient's restrictive pulmonary function pattern, low total lung capacity, and normal diffusing capacity make increased lung compliance unlikely.
Block 5, Question 16
Correct Answer: C. Inhibition of prostaglandin synthesisExplanation
This 25-year-old woman presents with a long history of severe, cyclic pelvic pain occurring on the first day of menstruation. This predictable, intense pain at the onset of menses without other organic findings represents primary dysmenorrhea. The first-line pharmacotherapy for this condition operates via the inhibition of prostaglandin synthesis.
The pathogenesis of primary dysmenorrhea involves the cyclical sloughing of the endometrial lining, which triggers the release of inflammatory mediators. During the luteal phase and subsequent menstruation, a drop in progesterone leads to the release of arachidonic acid from endometrial cells. This substrate is rapidly converted into prostaglandin F2$\alpha$ and other eicosanoids. These local mediators cause intense myometrial contractions, uterine ischemia, and sensitization of nerve endings, culminating in severe pelvic pain. Nonsteroidal anti-inflammatory drugs are the first-line treatment because they directly block cyclooxygenase, thereby halting the production of these algogenic mediators and relieving the uterine ischemia.
If initial therapy with nonsteroidal anti-inflammatory drugs is ineffective, contraindicated, or if the patient also desires pregnancy prevention, combined oral contraceptives are the next appropriate step in management. These agents work by suppressing ovulation and thinning the endometrial lining, which secondarily reduces arachidonic acid accumulation and subsequent inflammatory mediator production. Patients who fail to respond to both of these first-line therapies require further evaluation for secondary causes of cyclic pelvic pain. Conditions such as endometriosis, adenomyosis, or chronic pelvic inflammatory disease should be suspected if the pain progressively worsens, extends beyond the menstrual period, or is accompanied by abnormal bleeding.
Key TakeawayWhy the Other Choices Are Wrong
- Primary dysmenorrhea is caused by excessive prostaglandin production in the endometrium, leading to painful uterine contractions and ischemia.
- First-line pharmacotherapy consists of NSAIDs, which alleviate pain by inhibiting cyclooxygenase and decreasing prostaglandin synthesis.
Choice A: Inhibition of estrogen synthesis is the mechanism of aromatase inhibitors. These agents are primarily used to treat estrogen receptor-positive breast cancer in postmenopausal women by preventing the peripheral conversion of androgens to estrogens. They can also be used off-label for severe, refractory endometriosis. This patient's classic presentation of primary dysmenorrhea is treated first-line with NSAIDs, making aromatase inhibitors an inappropriate initial therapy.
Choice B: Inhibition of 11β-hydroxylase activity is the mechanism of metyrapone. This medication blocks the final step of cortisol synthesis in the adrenal cortex and is used to diagnose adrenal insufficiency or to treat hypercortisolism in Cushing syndrome. Patients with Cushing syndrome typically present with central obesity, striae, and proximal muscle weakness. This patient's isolated cyclic menstrual pain lacks any signs of hypercortisolism, making metyrapone therapy incorrect.
Choice D: Stimulation of follicle-stimulating hormone synthesis occurs with selective estrogen receptor modulators like clomiphene or with recombinant gonadotropin therapy (which provides exogenous FSH rather than stimulating its endogenous synthesis). Exogenous follicle-stimulating hormone directly stimulates ovarian follicular growth and is used in assisted reproductive technologies for patients with anovulatory infertility. This patient's regular, albeit painful, menses indicate normal ovulatory cycles, making follicular stimulation unnecessary and inappropriate for her pain.
Choice E: Stimulation of luteinizing hormone synthesis is achieved via pulsatile gonadotropin-releasing hormone therapy. Increased luteinizing hormone triggers the mid-cycle surge necessary for follicular rupture and ovulation. This therapy is specifically indicated for hypothalamic amenorrhea. This patient's predictable monthly pain on the first day of her cycle confirms normal ovulatory function, rendering luteinizing hormone stimulation unhelpful for her dysmenorrhea.
Block 5, Question 17
Correct Answer: D. Increased aquaporin expressionExplanation
This 60-year-old woman presents with lethargy, tachycardia, hypotension, and poor skin turgor after running a marathon in hot weather. These findings indicate severe volume depletion secondary to excessive sweating, which triggers neurohormonal compensatory mechanisms to maximize renal water retention via increased aquaporin expression.
Sweating causes the loss of hypotonic fluid, leading to both systemic hyperosmolarity and profound hypovolemia. These changes stimulate osmoreceptors in the hypothalamus and baroreceptors in the aortic arch and carotid sinus. The posterior pituitary responds by releasing antidiuretic hormone (ADH), which binds to V2 receptors on the basolateral membrane of principal cells in the collecting duct. This activates a Gs protein-coupled receptor pathway, increasing intracellular cAMP. The resulting kinase cascade triggers the exocytosis of vesicles containing aquaporin-2 channels into the apical membrane, significantly increasing water permeability.
In addition to ADH release, hypovolemia-induced renal hypoperfusion stimulates the juxtaglomerular apparatus to secrete renin, activating the renin-angiotensin-aldosterone system. Angiotensin II causes efferent arteriole constriction to maintain glomerular filtration despite low systemic pressure, while aldosterone promotes distal sodium reabsorption. The patient's mild hyperthermia and confusion reflect early heat exhaustion, which can progress to life-threatening heat stroke if thermoregulatory mechanisms fail. Furthermore, severe dehydration and hypotension during strenuous exercise predispose patients to acute tubular necrosis due to prolonged ischemic injury to the metabolically active medullary segments of the nephron.
Key TakeawayWhy the Other Choices Are Wrong
- Severe volume depletion and hyperosmolarity from excessive sweating robustly stimulate ADH release.
- ADH binds V2 receptors in the collecting duct, increasing aquaporin-2 expression to maximize free water reabsorption and concentrate the urine.
Choice A: Decreased ADH (vasopressin) receptors in the collecting duct characterize nephrogenic diabetes insipidus, leading to an inability to concentrate urine. This condition presents with polyuria, polydipsia, and hypernatremia, often secondary to lithium toxicity, hypercalcemia, or hereditary mutations in the AVPR2 gene. This patient's profound volume depletion from sweating would stimulate maximal ADH activity and upregulate, rather than decrease, receptor function to conserve water.
Choice B: Decreased renin production occurs in states of volume expansion, high sodium intake, or primary hyperaldosteronism. Suppressed renin typically manifests with hypertension, hypokalemia, and metabolic alkalosis due to autonomous aldosterone secretion from an adrenal adenoma or bilateral hyperplasia. This patient's hypotension and tachycardia indicate severe hypovolemia, which would robustly stimulate juxtaglomerular cells to increase renin production to support blood pressure.
Choice C: Decreased urine osmolality reflects the excretion of dilute urine, which occurs during states of primary polydipsia or diabetes insipidus. Dilute urine is physiologically appropriate when plasma osmolality is low, prompting suppression of ADH to facilitate free water excretion and prevent hyponatremia. This patient's excessive sweating causes hypotonic fluid loss and hyperosmolar hypovolemia; her kidneys would excrete highly concentrated urine with increased osmolality to conserve free water.
Choice E: Increased glomerular filtration rate (GFR) occurs during early diabetic nephropathy or pregnancy due to physiologic hyperfiltration. Hyperfiltration is driven by afferent arteriole vasodilation and efferent arteriole vasoconstriction, leading to increased intraglomerular capillary pressure. This patient's profound hypotension and volume depletion reduce renal perfusion pressure, which would decrease, rather than increase, her GFR despite compensatory efferent constriction.
Choice F: Increased reabsorption of albumin is not a primary compensatory mechanism for hypovolemia, as the glomerulus normally restricts large proteins from entering the filtrate. Small amounts of filtered albumin are reabsorbed in the proximal tubule via receptor-mediated endocytosis, but massive proteinuria indicates glomerular basement membrane damage. This patient's primary physiologic derangement is water and sodium loss from sweating; her kidneys will prioritize fluid retention, not albumin handling.
Block 5, Question 18
Correct Answer: D. Mumps virusExplanation
This 19-year-old man presents with a viral prodrome of fever, malaise, and decreased appetite followed by tender parotid gland swelling. The development of acute parotitis in a college student living in close quarters is highly characteristic of an infection with mumps virus.
Mumps is caused by a single-stranded, negative-sense RNA virus belonging to the Paramyxoviridae family. The virus is highly contagious and transmits primarily through respiratory droplets or direct contact with infected saliva, making outbreaks common in crowded environments like college dormitories. Following inhalation, the virus replicates in the upper respiratory tract and local lymph nodes before causing a transient viremia. This systemic spread allows the pathogen to seed multiple glandular tissues, most notably the parotid glands. Viral replication within the glandular epithelium leads to localized inflammation, edema, and the classic clinical presentation of acute nonsuppurative parotitis. The presence of the hemagglutinin-neuraminidase surface protein facilitates viral entry and release from host cells.
Beyond salivary gland involvement, systemic dissemination frequently affects other organs, particularly in postpubertal males. The most common complication in this demographic is orchitis, which presents with severe testicular pain and swelling and carries a risk of subsequent testicular atrophy and impaired fertility. The virus also exhibits strong neurotropism, frequently causing aseptic meningitis that typically resolves without permanent sequelae. Less common complications include pancreatitis, which manifests as severe epigastric pain, and sensorineural hearing loss. Prevention relies on the live-attenuated measles, mumps, and rubella vaccine, typically administered in a two-dose childhood series. However, waning immunity can still leave young adults susceptible during outbreaks, necessitating a third booster dose in high-risk settings.
Key TakeawayWhy the Other Choices Are Wrong
- Mumps is a paramyxovirus that classically presents with a viral prodrome followed by acute, tender parotitis, often occurring in outbreaks among young adults in close quarters.
- Severe complications in postpubertal males include epididymo-orchitis, which can lead to testicular atrophy and impaired fertility.
Choice A: Epstein-Barr virus causes infectious mononucleosis, characterized by the triad of fever, tonsillar pharyngitis, and generalized lymphadenopathy. Patients often exhibit extreme fatigue, hepatosplenomegaly, and atypical lymphocytosis on peripheral blood smear. This patient's isolated parotid swelling rather than generalized cervical lymphadenopathy or exudative pharyngitis makes Epstein-Barr virus unlikely.
Choice B: Hepatitis B virus is a hepadnavirus transmitted through blood and body fluids that causes acute and chronic liver inflammation. Acute infection typically manifests with a serum sickness-like prodrome of fever, arthralgias, and urticarial rash, followed by right upper quadrant pain and jaundice. This patient's parotid swelling and lack of hepatic symptoms make hepatitis B virus unlikely.
Choice C: Measles virus is a paramyxovirus that causes a highly contagious childhood exanthem. The classic presentation begins with a prodrome of cough, coryza, conjunctivitis, and Koplik spots on the buccal mucosa, followed by a maculopapular rash that spreads cephalocaudally. This patient's lack of a descending rash and prominent parotid swelling make measles virus unlikely.
Choice E: Rubella virus is a togavirus that causes a mild febrile illness and a maculopapular rash. Characteristic features include tender postauricular and suboccipital lymphadenopathy, mild fever, and a rapidly spreading cephalocaudal rash that clears within three days. This patient's parotid gland enlargement rather than postauricular lymphadenopathy and absence of a rash make rubella virus unlikely.
Block 5, Question 19
Correct Answer: D. CTLA4Explanation
This 64-year-old man presents with unresectable metastatic melanoma and normal baseline vital signs and body mass index, making him a candidate for systemic pharmacologic therapy. In advanced melanoma, enhancing the host immune system's ability to recognize and destroy tumor cells has become a cornerstone of treatment, which can be achieved by administering monoclonal antibodies that block T-cell inhibitory receptors such as CTLA4.
Effective T-cell activation requires both T-cell receptor binding to the major histocompatibility complex and a secondary costimulatory signal achieved through the interaction of CD28 on the T cell with B7 on the antigen-presenting cell. To prevent unchecked immune responses, T cells express cytotoxic T-lymphocyte-associated protein 4, an inhibitory receptor that competitively binds B7 with much higher affinity than CD28. This interaction induces T-cell anergy and dampens the immune response. Monoclonal antibodies such as ipilimumab block this inhibitory receptor, thereby restoring T-cell activation and allowing for a robust cytotoxic response against melanoma cells.
Another critical pathway targeted in advanced melanoma involves programmed cell death protein 1, a receptor on T cells that normally binds its ligand on peripheral tissues to maintain peripheral tolerance. Monoclonal antibodies targeting this receptor or its ligand similarly prevent tumor-mediated immune evasion. Because immune checkpoint inhibitors fundamentally remove the physiological brakes on the immune system, they frequently cause immune-related adverse events. These toxicities can affect nearly any organ system but most commonly manifest as dermatologic toxicity, endocrinopathies, and severe autoimmune colitis, which requires prompt recognition and management with systemic corticosteroids.
Key TakeawayWhy the Other Choices Are Wrong
- Immune checkpoint inhibitors target inhibitory receptors like CTLA4, preventing them from binding B7 and thereby restoring robust T-cell activation against tumor cells.
- These therapies are highly effective for advanced melanoma but frequently cause immune-related adverse events requiring corticosteroid management.
Choice A: B7 is a surface protein expressed on antigen-presenting cells that provides the necessary second signal for T-cell activation. Binding of B7 to CD28 on naive T cells promotes T-cell survival and proliferation. Conversely, binding of B7 to CTLA4 inhibits T-cell activation. Blocking B7 in this patient would prevent the crucial CD28-mediated costimulatory signal, thereby suppressing rather than enhancing the anti-tumor immune response needed to treat his metastatic melanoma.
Choice B: CD28 is a costimulatory receptor constitutively expressed on naive T cells that interacts with B7 on antigen-presenting cells. This interaction generates the essential second signal required for robust T-cell activation, preventing anergy and promoting clonal expansion. Administering an antibody blockade against CD28 would inhibit T-cell activation and induce immune tolerance, which is counterproductive in this patient who requires an augmented cytotoxic response to clear his metastatic disease.
Choice C: CD40 is a costimulatory protein found on antigen-presenting cells like B cells and macrophages. Its interaction with CD40 ligand on helper T cells is essential for B-cell class switching and dendritic cell maturation. CD40 blockade is utilized to prevent organ rejection by dampening immunity. Providing an antibody blockade against CD40 would suppress this patient's immune system, accelerating the progression of his unresectable melanoma.
Choice E: FcγR is a cell surface receptor found on macrophages, neutrophils, and natural killer cells that binds the Fc portion of IgG antibodies. This receptor mediates phagocytosis of opsonized pathogens and facilitates antibody-dependent cellular cytotoxicity. Blocking FcγR would impair the immune system's ability to destroy antibody-coated targets, which would inhibit rather than promote the clearance of this patient's metastatic melanoma cells.
Block 5, Question 20
Correct Answer: D. Use a telephone interpreter serviceExplanation
This 78-year-old woman presents with jaundice and a pancreatic mass requiring a timely discussion of prognosis and informed consent for an impending biopsy. Because she speaks only Mandarin and a hospital interpreter is unavailable until the next morning, the physician must secure professional medical translation to ensure patient autonomy and accurate communication, making the most appropriate next step to use a telephone interpreter service.
Effective communication is a fundamental requirement for obtaining informed consent, which necessitates that patients fully understand their diagnosis, the proposed intervention, alternatives, and potential risks. When a language barrier exists, physicians must use trained medical interpreters to facilitate this discussion. Family members, including bilingual spouses, should generally not be used as interpreters in clinical settings because they lack training in medical terminology and may intentionally or unintentionally alter the information provided. Furthermore, relying on family members can compromise patient autonomy and confidentiality, particularly when discussing sensitive topics like a potential malignancy.
While in-person professionals are ideal, telecommunication interpreter services (telephone or video) are the standard alternative when face-to-face translation is unavailable. These services provide immediate access to certified translators who are bound by strict privacy standards to maintain patient confidentiality and trained to remain objective. In rare, life-threatening emergencies where a delay would result in imminent harm, a family member or untrained staff may temporarily assist with basic communication. However, a scheduled biopsy for suspected pancreatic cancer does not qualify as one of these emergent clinical situations, requiring the use of a formal translation service to proceed.
Key TakeawayWhy the Other Choices Are Wrong
- Trained medical interpreters, including telephone services, must be used for patients with limited English proficiency to ensure accurate communication and informed consent.
- Family members should not be used as interpreters except in life-threatening emergencies where delay would cause imminent harm.
Choice A: Allowing the patient's husband to serve as an interpreter involves using a bilingual family member to translate complex medical information. Family members lack formal training in medical terminology and may filter or alter information to protect the patient from distressing news, compromising independent decision-making. This patient's need for a detailed discussion regarding a suspected cancer diagnosis and procedural consent makes using her anxious husband inappropriate.
Choice B: Consulting the hospital ethics committee is an intervention used to resolve complex moral disagreements between healthcare providers, patients, and families regarding care plans. Ethics committees typically address dilemmas such as end-of-life decision-making or conflicts over surrogate decision-makers. This patient's situation involves a standard logistical barrier regarding language translation rather than an ethical conflict, making an ethics consultation unnecessary.
Choice C: Explaining to the husband that information cannot be provided until the hospital interpreter arrives in the morning involves delaying the goals of care discussion. Unnecessarily postponing critical conversations can increase anxiety and delay necessary procedures. This patient's biopsy is scheduled for the next morning, meaning the consent process must be completed promptly, which can be achieved without delay using an available telephone service.
Block 6, Question 1
Correct Answer: C. MacrolideExplanation
This 5-month-old boy presents with a 10-day history of severe paroxysmal coughing spells followed by an inspiratory gasp and post-tussive emesis. In an unimmunized infant with normal vital signs, clear lungs, and no signs of respiratory distress between episodes, this classic presentation is highly suspicious for pertussis, for which the most appropriate treatment is a macrolide.
Pertussis, or whooping cough, is a highly contagious respiratory infection caused by the gram-negative coccobacillus Bordetella pertussis. The clinical course progresses through three phases: the highly infectious catarrhal stage with mild coryza, the paroxysmal stage with severe coughing spells and post-tussive emesis, and the convalescent stage. Because this infant has not received routine childhood immunizations, he is highly susceptible. Antimicrobial therapy is indicated to eradicate the organism from the nasopharynx and decrease transmission. First-line agents are macrolides, which act by binding to the bacterial 50S ribosomal subunit to inhibit protein synthesis.
While macrolides effectively prevent transmission, they only reduce symptom duration if initiated early; once paroxysms develop, antibiotics have minimal effect on the clinical course. Infants under six months are at highest risk for severe complications, including apnea, pneumonia, seizures, and pulmonary hypertension. Close contacts of an infected patient should receive post-exposure prophylaxis regardless of immunization status. If a patient cannot tolerate first-line therapy or has a contraindication such as a prolonged QT interval, the preferred alternative agent is trimethoprim-sulfamethoxazole, though it is generally avoided in neonates.
Key TakeawayWhy the Other Choices Are Wrong
- Pertussis classically presents with paroxysmal coughing spells, an inspiratory whoop, and post-tussive emesis in unimmunized infants.
- First-line treatment is a macrolide antibiotic, which decreases transmission by eradicating the nasopharyngeal organism but does not alter the clinical course once paroxysms begin.
Choice A: Cephalosporins are beta-lactam antibiotics that inhibit bacterial cell wall synthesis and are commonly used to treat respiratory infections like acute otitis media or community-acquired pneumonia. Typical bacterial pneumonias present with fever, tachypnea, and focal lung findings such as crackles or decreased breath sounds. This patient's afebrile presentation with clear lungs and classic paroxysmal coughing spells makes a typical bacterial pneumonia requiring cephalosporin therapy unlikely.
Choice B: Fluoroquinolones are broad-spectrum antibiotics that inhibit bacterial DNA topoisomerase and are often used for complicated respiratory, genitourinary, and gastrointestinal infections. They are generally contraindicated in pediatric patients due to the risk of cartilage damage and arthropathy. This patient's young age and classic presentation of whooping cough make a fluoroquinolone an inappropriate and potentially harmful choice.
Choice D: Penicillins are beta-lactam antibiotics frequently used for streptococcal pharyngitis, syphilis, and susceptible pneumococcal infections. While amoxicillin is a first-line treatment for pediatric bacterial pneumonia and acute otitis media, it lacks efficacy against the causative organism of this patient's infection. This infant's characteristic inspiratory whoop and post-tussive emesis make penicillin an ineffective choice for his underlying disease.
Choice E: Sulfonamides, such as sulfamethoxazole, inhibit bacterial folate synthesis and are typically combined with trimethoprim to treat urinary tract infections, skin infections, and certain opportunistic pneumonias. While trimethoprim-sulfamethoxazole is the preferred alternative treatment for pertussis in patients with macrolide allergies or intolerances, it is a second-line agent. This patient's lack of known drug allergies or contraindications makes a sulfonamide an inappropriate initial choice.
Block 6, Question 2
Correct Answer: F. Increased release of biogenic aminesExplanation
This 25-year-old man presents with acute-onset irritability, restlessness, tremor, and palpitations alongside significant tachycardia, tachypnea, and hypertension with an otherwise normal physical examination following known amphetamine use. These classic signs of stimulant intoxication are driven by a massive surge of catecholamines, primarily mediated by an increased release of biogenic amines.
Amphetamines are indirect-acting sympathomimetics that dramatically elevate synaptic concentrations of dopamine, norepinephrine, and serotonin. They enter the presynaptic neuron via monoamine reuptake transporters and subsequently enter neurotransmitter storage vesicles via the vesicular monoamine transporter. Once inside, amphetamines alter the vesicular pH and displace endogenous catecholamines into the cytoplasm. This high intracellular concentration reverses the direction of the presynaptic reuptake transporters, pumping massive amounts of neurotransmitters into the synaptic cleft. This flood of catecholamines directly stimulates adrenergic receptors, causing the classic toxidrome of diaphoresis, pupillary dilation, and profound sympathetic hyperactivity.
The profound catecholamine surge manifests with cardiovascular overstimulation, explaining this patient's markedly elevated blood pressure and tachycardia without focal abnormalities on physical examination. Severe intoxication can lead to life-threatening complications such as myocardial infarction, stroke, or hyperthermia due to extreme muscle hyperactivity and peripheral vasoconstriction. Initial management of amphetamine toxicity prioritizes supportive care and chemical restraint with benzodiazepines to control psychomotor agitation, lower blood pressure, and prevent seizures. Beta-blockers must be strictly avoided in these patients due to the risk of unopposed alpha-adrenergic stimulation, which can precipitate paradoxical hypertensive crisis.
Key TakeawayWhy the Other Choices Are Wrong
- Amphetamines are indirect-acting sympathomimetics that cause massive presynaptic release of biogenic amines (dopamine, norepinephrine, serotonin) by reversing monoamine transporters.
- Intoxication presents with profound sympathetic hyperactivity (tachycardia, hypertension, agitation) and is managed primarily with benzodiazepines while avoiding beta-blockers.
Choice A: Decreased intracellular metabolism of biogenic amines describes the mechanism of monoamine oxidase inhibitors. These medications prevent the breakdown of dopamine, norepinephrine, and serotonin, leading to increased synaptic levels and potential hypertensive crisis if combined with tyramine. While amphetamines weakly inhibit monoamine oxidase, this patient's profound sympathomimetic toxidrome is primarily driven by direct neurotransmitter displacement and release.
Choice B: Decreased monoamine oxidase activity refers directly to the primary pharmacological effect of monoamine oxidase inhibitors, such as phenelzine or tranylcypromine. These agents are used for treatment-resistant depression and can cause sympathetic overactivity in overdose. However, this patient's acute presentation of severe tachycardia and hypertension is directly linked to amphetamine use, which primarily causes massive vesicular displacement rather than enzyme inhibition.
Choice C: Decreased presynaptic receptor activation is the mechanism of alpha-2 adrenergic antagonists, such as mirtazapine. By blocking presynaptic inhibitory autoreceptors, these drugs prevent negative feedback and increase the release of norepinephrine and serotonin. This patient's severe sympathomimetic symptoms, including a heart rate of 120/min and blood pressure of 150/100 mm Hg, are caused by amphetamine-induced reverse transport, not autoreceptor blockade.
Choice D: Increased intracellular metabolism of biogenic amines would result in decreased synaptic concentrations of catecholamines, leading to reduced sympathetic activity. Patients with depleted monoamines typically present with lethargy, bradycardia, hypotension, and depressed mood. This patient's profound psychomotor agitation, prominent tremor, and marked hypertension directly contradict a state of increased neurotransmitter breakdown.
Choice E: Increased presynaptic receptor activation describes the action of alpha-2 adrenergic agonists, such as clonidine or dexmedetomidine. These medications stimulate inhibitory presynaptic autoreceptors, which decreases the central release of norepinephrine and dampens sympathetic outflow. This patient's marked irritability, restlessness, and hyperdynamic vital signs indicate massive sympathetic stimulation, making an inhibitory mechanism incorrect.
Video Review: Bordetella Pertussis
Block 6, Question 3
Correct Answer: E. Stretched aortic anulusExplanation
This 19-year-old man presents with severe upper back pain, hypotension, tachycardia, and a late diastolic murmur at the left lower sternal border following a sudden collapse. His exceptionally tall stature and acute presentation strongly suggest an acute aortic dissection secondary to Marfan syndrome, which causes acute aortic regurgitation through a stretched aortic anulus.
Patients with Marfan syndrome possess a genetic defect in fibrillin-1, an essential glycoprotein that forms a sheath around elastin fibers. This defect leads to cystic medial necrosis, characterized by the degradation of elastic fibers and accumulation of mucopolysaccharides within the aortic media. This structural weakness profoundly increases the risk of proximal aortic aneurysms and dissections. When a dissection flap extends proximally into the aortic root, it disrupts the valvular commissures and causes severe dilation, resulting in acute aortic regurgitation from a stretched aortic anulus.
The sudden onset of valvular incompetence creates a massive volume overload on an unprepared left ventricle. Unlike chronic disease, the ventricle cannot undergo compensatory eccentric hypertrophy quickly enough to accommodate the regurgitant blood. Consequently, left ventricular end-diastolic pressure rises precipitously, causing a dramatic fall in forward stroke volume that manifests as profound hypotension, weak pulses, pallor, and reflex tachycardia. The resulting diastolic decrescendo murmur is heard best at the left sternal border. Immediate surgical repair is required to prevent fatal cardiogenic shock or rupture into the pericardial space causing cardiac tamponade, though this patient's lack of jugular venous distention makes tamponade unlikely currently.

Why the Other Choices Are Wrong
- Marfan syndrome predisposes patients to cystic medial necrosis, significantly increasing the risk of aortic root dilation and acute aortic dissection.
- Proximal aortic dissections can disrupt the aortic valve commissures, causing acute aortic regurgitation due to a stretched aortic anulus.
Choice A: Atrial septal defect is a congenital heart anomaly characterized by an opening in the interatrial septum. This condition causes left-to-right shunting, leading to right-sided volume overload. It classically produces a wide, fixed splitting of the S2 heart sound and a systolic ejection murmur at the upper left sternal border. This patient's acute cardiovascular collapse, sharp back pain, and diastolic murmur make an atrial septal defect unlikely.
Choice B: Mitral stenosis is a narrowing of the mitral valve orifice most commonly caused by rheumatic heart disease. This valvular lesion restricts blood flow from the left atrium to the left ventricle, leading to left atrial enlargement. It classically produces a loud S1, an opening snap, and a mid-to-late low-pitched diastolic rumble heard best at the cardiac apex. This patient's extremely tall stature, sudden onset of tearing back pain, and murmur located at the left lower sternal border make mitral stenosis unlikely.
Choice C: Papillary muscle rupture is a catastrophic mechanical complication that typically occurs days after a myocardial infarction. Ischemia and necrosis of the posteromedial papillary muscle lead to acute, severe mitral regurgitation. This presents with sudden-onset pulmonary edema, hypotension, and a new harsh holosystolic murmur heard best at the cardiac apex with radiation to the axilla. This patient's young age, presentation with a diastolic rather than systolic murmur, and sharp upper back pain make papillary muscle rupture unlikely.
Choice D: Perforated tricuspid valve is a destructive complication most frequently associated with right-sided infective endocarditis. Intravenous drug use introduces pathogens like Staphylococcus aureus, leading to large vegetations and valvular destruction. This causes acute tricuspid regurgitation, which presents with a holosystolic murmur at the left lower sternal border alongside prominent jugular venous distention. This patient's lack of jugular venous distention, presentation with a diastolic murmur, and acute tearing back pain make a perforated tricuspid valve unlikely.
Block 6, Question 4
Correct Answer: E. Myasthenic (Lambert-Eaton) syndromeExplanation
This 78-year-old woman presents with preoperative muscle weakness, lung cancer, and profound postoperative neuromuscular blockade following pancuronium administration. Electrophysiologic studies show a decreased end-plate potential (EPP) amplitude but normal miniature EPP (MEPP) and a normal response to exogenous acetylcholine, indicating a presynaptic defect in neurotransmitter release. In the setting of bronchogenic carcinoma, these findings are highly characteristic of a paraneoplastic presynaptic neuromuscular junction disorder known as myasthenic (Lambert-Eaton) syndrome.
Lambert-Eaton myasthenic syndrome is an autoimmune disorder caused by autoantibodies directed against presynaptic voltage-gated calcium channels at the neuromuscular junction. This prevents calcium influx during an action potential, leading to impaired fusion of synaptic vesicles and decreased acetylcholine release. Electrophysiologically, this manifests as a reduced EPP, which represents the total depolarization generated by all released acetylcholine vesicles. However, the MEPP, representing the postsynaptic response to a single spontaneously released vesicle, remains normal. Because the postsynaptic nicotinic acetylcholine receptors are completely intact, the muscle's response to exogenously applied acetylcholine is also preserved, distinguishing it from myasthenia gravis.
The condition is most commonly a paraneoplastic syndrome associated with small cell lung cancer, which explains this patient's underlying bronchogenic carcinoma and pathologic bone metastasis. Clinically, patients experience proximal muscle weakness that characteristically improves with repeated muscle use, as rapid action potentials eventually facilitate sufficient calcium accumulation to trigger neurotransmitter release. Furthermore, patients with presynaptic neuromuscular junction defects exhibit extreme sensitivity to non-depolarizing neuromuscular blockers like pancuronium. Because these agents competitively antagonize acetylcholine at the motor end-plate, the already diminished acetylcholine levels in this syndrome result in the profound, prolonged postoperative paralysis observed in this patient following general anesthesia.

Why the Other Choices Are Wrong
- Lambert-Eaton myasthenic syndrome is a presynaptic disorder characterized by decreased acetylcholine release, resulting in a reduced end-plate potential but normal miniature end-plate potential.
- It is often paraneoplastic (small cell lung cancer) and causes extreme sensitivity to non-depolarizing neuromuscular blockers.
Choice A: An adverse effect of pancuronium, a non-depolarizing neuromuscular blocker, involves prolonged competitive antagonism of postsynaptic acetylcholine receptors. Administration results in competitive antagonism at the motor end-plate, which decreases both the miniature end-plate potential (MEPP) and the muscle's response to exogenously applied acetylcholine. This patient's normal MEPP and normal response to applied acetylcholine confirm intact postsynaptic receptor function, making a prolonged pancuronium effect unlikely.
Choice B: An adverse effect of sevoflurane, an inhaled volatile anesthetic, typically involves malignant hyperthermia in susceptible individuals. Affected patients develop muscle rigidity, hypercapnia, tachycardia, and hyperthermia due to massive calcium release from the sarcoplasmic reticulum via defective ryanodine receptors. It does not alter neuromuscular junction electrophysiology. This patient's flaccid paralysis (profound neuromuscular block) and specific presynaptic electrophysiologic defects make an adverse sevoflurane reaction unlikely.
Choice C: A cholinergic crisis occurs due to excessive acetylcholine accumulation at the neuromuscular junction, typically from acetylcholinesterase inhibitor overdose. Affected patients experience continuous depolarization of the motor end-plate, leading to paradoxical muscle weakness, fasciculations, and profound parasympathetic overstimulation (salivation, lacrimation, urination, diarrhea). This patient's decreased end-plate potential amplitude indicates reduced, rather than excessive, acetylcholine release, making a cholinergic crisis unlikely.
Choice D: Myasthenia gravis is an autoimmune disorder caused by autoantibodies against postsynaptic nicotinic acetylcholine receptors. Affected patients experience fluctuating muscle weakness that worsens with use. Because the postsynaptic receptors are depleted, electrophysiologic testing shows a decreased miniature end-plate potential (MEPP) and a diminished response to exogenously applied acetylcholine. This patient's normal MEPP and normal response to applied acetylcholine rule out this postsynaptic pathology.
Video Review: Aortic Dissection
Block 6, Question 5
Correct Answer: C. Calcium-sensing receptorExplanation
This 28-year-old man presents with asymptomatic hypercalcemia, elevated intact parathyroid hormone, and a notably low fractional excretion of calcium in the setting of a strong family history of calcium abnormalities. These findings are highly characteristic of familial hypocalciuric hypercalcemia, an autosomal dominant disorder caused by a loss-of-function mutation in the calcium-sensing receptor.
Familial hypocalciuric hypercalcemia occurs due to defective G-protein coupled receptors located primarily in the parathyroid glands and kidneys. Under normal physiologic conditions, these receptors detect ionized calcium and suppress parathyroid hormone secretion when levels are adequate. In this condition, the mutated receptors have a higher threshold for activation, requiring significantly elevated serum calcium concentrations to inhibit hormone release. This altered set point results in mild to moderate hypercalcemia alongside inappropriately normal or elevated parathyroid hormone levels, mimicking primary hyperparathyroidism. However, unlike classical hyperparathyroidism, patients typically remain entirely asymptomatic and do not develop nephrolithiasis or reduced bone mineral density.
The renal manifestations of this disorder are critical for establishing the diagnosis and avoiding unnecessary surgical intervention. In the thick ascending limb of the loop of Henle, the defective receptors fail to inhibit the Na-K-2Cl cotransporter, leading to enhanced paracellular calcium reabsorption. This mechanism produces the hallmark finding of a fractional excretion of calcium of less than 1%, which definitively distinguishes this benign condition from other causes of hypercalcemia. Because this is a physiologic resetting rather than a destructive disease process, parathyroidectomy is contraindicated and patients require only routine clinical observation without specific medical therapy.
Key TakeawayWhy the Other Choices Are Wrong
- Familial hypocalciuric hypercalcemia is an autosomal dominant disorder caused by defective calcium-sensing receptors in the parathyroid glands and kidneys.
- It presents with mild hypercalcemia, normal or elevated parathyroid hormone, and a fractional excretion of calcium <1%, requiring no treatment.
Choice A: Calcitonin gene-related peptide (CGRP) receptor mutations are not associated with hypercalcemia. CGRP is a potent vasodilator primarily involved in the pathophysiology of migraines, where its release from the trigeminal nerve causes neurogenic inflammation and pain. This patient's asymptomatic presentation, elevated parathyroid hormone, and marked hypocalciuria make a primary disorder of CGRP signaling unlikely.
Choice B: Calcitonin receptor mutations would theoretically impair the ability of calcitonin to inhibit osteoclast activity and decrease serum calcium. However, calcitonin plays a minor role in adult human calcium homeostasis, and receptor mutations do not cause clinically significant hypercalcemia. Furthermore, this patient's elevated parathyroid hormone and low urinary calcium point to a different regulatory defect.
Choice D: Parathyroid hormone receptor mutations typically cause Jansen metaphyseal chondrodysplasia (activating) or pseudohypoparathyroidism (inactivating). Activating mutations cause hypercalcemia and hypophosphatemia, but parathyroid hormone levels are characteristically suppressed due to negative feedback. This patient's elevated intact parathyroid hormone level and profound hypocalciuria make a parathyroid hormone receptor mutation unlikely.
Choice E: Receptor activator of nuclear factor kappa-B (RANK) mutations can cause familial expansile osteolysis or early-onset Paget disease of bone due to unregulated osteoclast activation. While increased bone resorption can cause hypercalcemia, it typically presents with bone pain, fractures, and suppressed parathyroid hormone. This patient's asymptomatic state, elevated parathyroid hormone, and lack of skeletal findings rule this out.
Choice F: Vitamin D receptor mutations cause hereditary vitamin D-resistant rickets. This condition classically presents in childhood with hypocalcemia, early-onset rickets, alopecia, and secondary hyperparathyroidism due to end-organ resistance to calcitriol. This patient's hypercalcemia and completely asymptomatic adult presentation directly contradict the clinical picture of a vitamin D receptor defect.
Block 6, Question 6
Correct Answer: C. "I'd like to hear about your goals for the time you have remaining."Explanation
This 32-year-old woman presents with recurrent malignant right-sided pleural effusions secondary to terminal stage IV breast cancer and expresses a desire to discontinue invasive hospital procedures. Because she has exhausted curative treatment options and is fatigued from recurrent large-volume thoracenteses, the physician should transition the conversation toward palliative care by exploring her values, making the most appropriate response "I'd like to hear about your goals for the time you have remaining."
When a patient with a terminal illness indicates a desire to stop life-prolonging or symptom-directed invasive treatments, the physician must validate this choice and pivot to a goals of care discussion. This conversation identifies what matters most to the patient, such as maximizing comfort at home, spending time with family, or avoiding further hospitalizations. By asking open-ended questions about her priorities, the physician respects patient autonomy while gathering the necessary information to align future medical interventions with her personal values. This approach facilitates a smooth transition from disease-directed therapy to palliative care.
Once the patient's goals are established, the physician can introduce specialized support services tailored to her prognosis. Because her life expectancy is likely less than six months, she qualifies for hospice services, which focus entirely on symptom relief rather than curative intent. For her recurrent effusions, management can shift from repeated hospital-based thoracenteses to outpatient-focused interventions, such as the placement of a tunneled pleural catheter, allowing fluid drainage at home. Furthermore, involving a multidisciplinary team provides essential psychosocial support for her wife and young children as they navigate the impending bereavement process.
Key TakeawayWhy the Other Choices Are Wrong
- When a patient with a terminal illness expresses a desire to stop invasive treatments, physicians should use open-ended questions to explore their goals of care.
- This approach respects patient autonomy and helps align future medical interventions with the patient's values.
Choice A: "I am so sorry to hear that you're giving up" is a judgmental statement that implies the patient is failing by choosing to stop invasive procedures. Effective end-of-life communication requires unconditional positive regard and validation of the patient's choices. This patient's decision to forgo further thoracenteses after multiple grueling admissions reflects a shift in priorities, not a personal failure.
Choice B: "I imagine that this must be very difficult, but you should try to endure this for your wife and children" inappropriately uses guilt to coerce the patient into continuing unwanted medical interventions. Physicians must remain objective and avoid imposing their own values onto patients. This patient's explicit statement that she is "done" with hospitalizations must be respected, regardless of her family structure.
Choice D: "I'd like you to speak to one of my colleagues before making any decisions to ensure that you aren't depressed" incorrectly assumes that choosing to stop treatment stems from impaired decision-making capacity. While clinical depression can occur in terminal illness, choosing to prioritize comfort over recurrent, painful hospital admissions is a rational choice. This patient's clear articulation of her limits does not inherently suggest a psychiatric disorder requiring evaluation.
Choice E: "It's common for patients to hate thoracentesis procedures. You are not alone" minimizes the patient's broader existential statement about her terminal illness. While normalizing a patient's fear of procedures can be helpful in other contexts, it misses the deeper meaning here. This patient's declaration that she is "done" with the hospital signals a readiness to discuss end-of-life care, not merely a transient frustration with a specific procedure.
Video Review: Lambert-Eaton Syndrome
Block 6, Question 7
Correct Answer: C. Maternal androgen exposureExplanation
This vigorous newborn girl presents with ambiguous genitalia characterized by clitoromegaly and a urogenital sinus, alongside a normal 46,XX karyotype. In a genetically female infant, virilization of the external genitalia requires exposure to high levels of androgens during gestation, which can originate from an exogenous source, making the most likely cause maternal androgen exposure.
The development of male external genitalia in a 46,XX fetus requires exposure to high levels of androgens during the first trimester. While endogenous causes like congenital adrenal hyperplasia (CAH) are the most common etiology, exogenous virilization must be considered when endogenous pathways are intact. Exogenous sources typically involve maternal ingestion of androgenic medications or the presence of maternal androgen-secreting tumors, such as a luteoma of pregnancy. These maternal androgens cross the placenta and stimulate fetal androgen receptors, leading to clitoromegaly and labioscrotal fusion without affecting internal Müllerian structures, which develop normally in the absence of anti-Müllerian hormone.
In cases of maternal androgen excess, the mother often exhibits signs of virilization during pregnancy, such as hirsutism, acne, and deepening of the voice. Placental aromatase deficiency can also cause virilization of both the mother and a female fetus by preventing the conversion of fetal androgens into estrogens. Management of the newborn involves a multidisciplinary approach to assign sex of rearing based on genetic, gonadal, and anatomical factors. Unlike classical CAH, which requires lifelong glucocorticoid replacement therapy, virilization from maternal sources is self-limiting after birth, and these infants typically have normal ovarian function at puberty.
Key TakeawayWhy the Other Choices Are Wrong
- Virilization of a 46,XX fetus can be caused by maternal androgen exposure, leading to ambiguous external genitalia with normal internal female reproductive organs.
- Unlike congenital adrenal hyperplasia, virilization from maternal androgens is self-limiting and does not require lifelong glucocorticoid therapy.
Choice A: 17α-Hydroxyprogesterone deficiency typically reflects an upstream block in steroidogenesis, such as 17α-hydroxylase deficiency. This condition impairs the synthesis of both androgens and cortisol, leading to phenotypically female external genitalia in both 46,XX and 46,XY individuals, alongside hypertension and hypokalemia. This newborn's virilized external genitalia make a defect in this pathway unlikely.
Choice B: Increased concentration of müllerian-inhibiting substance (anti-Müllerian hormone) is normally produced by Sertoli cells in male fetuses to cause regression of the Müllerian ducts. This hormone prevents the formation of the uterus, fallopian tubes, and upper vagina, but it does not drive the virilization of external genitalia. This patient's prominent clitoris and labioscrotal fusion make this mechanism unlikely.
Choice D: Presence of the sex-determining region Y gene (SRY gene) initiates male gonadal differentiation by directing the formation of testes. Translocation of the SRY gene to an X chromosome causes 46,XX testicular disorder of sex development, typically resulting in normal-appearing male external genitalia without a vagina. This newborn's ambiguous genitalia with a distinct vaginal opening make this genetic anomaly unlikely.
Choice E: 5α-Reductase deficiency is an autosomal recessive condition affecting 46,XY individuals that impairs the conversion of testosterone to dihydrotestosterone. This defect results in ambiguous or female-appearing external genitalia at birth, with severe virilization occurring later during puberty due to rising testosterone levels. This newborn's 46,XX karyotype and presence of virilized genitalia make this enzyme deficiency unlikely.
Block 6, Question 8
Correct Answer: D. Squalene monooxygenaseExplanation
This 37-year-old man presents with a 3-week history of pruritic, burning feet and physical examination findings of interdigital and plantar erythema, scaling, and maceration. His occupational history of wearing wet footwear provides an ideal moist environment for dermatophyte infection, confirming a diagnosis of tinea pedis. The most appropriate pharmacotherapy for this condition is a topical allylamine, which inhibits squalene monooxygenase.
Tinea pedis is a superficial fungal infection most commonly caused by Trichophyton rubrum. First-line treatment involves topical terbinafine, a fungicidal agent belonging to the allylamine class. This medication exerts its effect by inhibiting the fungal enzyme squalene epoxidase (also known as squalene monooxygenase). This inhibition blocks the conversion of squalene to squalene epoxide, a crucial early step in the synthesis of ergosterol, which is the primary sterol component of the fungal cell membrane. The resulting depletion of this vital membrane component disrupts cellular permeability and function. Furthermore, the intracellular accumulation of unconverted squalene is directly toxic to the fungal cell, leading to rapid cell death.
Diagnosis of dermatophyte infections is typically clinical but can be confirmed using a potassium hydroxide preparation of skin scrapings, which dissolves keratinocytes to reveal characteristic branching septate hyphae. While topical allylamines are preferred due to their fungicidal nature and shorter required treatment duration, topical azoles (e.g., clotrimazole) are alternative fungistatic options that inhibit a later step in sterol synthesis via 14-alpha-demethylase. Patients with interdigital maceration and fissuring are at increased risk for secondary bacterial infections, most notably lower extremity cellulitis caused by Streptococcus pyogenes or Staphylococcus aureus, making prompt and effective antifungal therapy essential to prevent deeper tissue invasion.
Key TakeawayWhy the Other Choices Are Wrong
- Tinea pedis is a superficial dermatophyte infection treated first-line with topical allylamines such as terbinafine.
- Allylamines inhibit squalene monooxygenase (squalene epoxidase), blocking ergosterol synthesis and causing a fungicidal accumulation of toxic squalene.
Choice A: Chitin synthase is the target of nikkomycins, experimental antifungal agents that inhibit the synthesis of chitin, a structural polysaccharide in the fungal cell wall. Chitin provides rigidity, and its inhibition leads to osmotic swelling and lysis. This patient's classic presentation of tinea pedis requires standard therapy with an allylamine, making an inhibitor of this structural enzyme unlikely to be the appropriate pharmacotherapy.
Choice B: The 1,3-β-D-glucan synthase complex is inhibited by echinocandins, such as caspofungin. Echinocandins block the synthesis of beta-glucan, a major component of the fungal cell wall, leading to osmotic instability and cell death. They are administered intravenously and are primarily indicated for invasive candidiasis and severe aspergillosis. This patient's localized, superficial dermatophyte infection and lack of systemic symptoms make treatment with an intravenous echinocandin inappropriate.
Choice C: Phospholipase D is a virulence factor produced by certain bacteria and venomous arthropods like the brown recluse spider. This enzyme cleaves host cell membrane phospholipids, causing dermonecrosis and hemolysis. Brown recluse bites classically present with a painless bite progressing to a central necrotic eschar. This patient's bilateral, pruritic, macerated interdigital lesions and occupational moisture exposure point to a fungal etiology, making a necrotic process unlikely.
Choice E: Thymidylate synthase is the target of flucytosine, a pyrimidine analog that is converted to 5-fluorouracil within fungal cells. Flucytosine disrupts fungal DNA and RNA synthesis and is typically used with amphotericin B for severe, systemic infections like cryptococcal meningitis. This patient's superficial interdigital scaling and erythema indicate a localized dermatophyte infection, which does not require systemic DNA synthesis inhibitors.
Video Review: Familial Hypocalciuric Hypercalcemia
Block 6, Question 9
Correct Answer: B. Left medial longitudinal fasciculusExplanation
This 27-year-old woman presents with a two-week history of diplopia and an isolated inability to adduct the left eye during rightward horizontal gaze. These findings represent a left-sided internuclear ophthalmoplegia, a horizontal gaze palsy caused by disrupted communication between the contralateral abducens nucleus and ipsilateral oculomotor nucleus. This specific ocular movement deficit is most likely caused by damage to the left medial longitudinal fasciculus.
Normal horizontal conjugate gaze requires coordinated activation of the lateral rectus of one eye and medial rectus of the other. When looking right, the right paramedian pontine reticular formation stimulates the right abducens nucleus, which innervates the right lateral rectus to abduct the right eye. Simultaneously, contralateral projections from the right abducens nucleus cross the midline and ascend through the left MLF to synapse on the left oculomotor nucleus. This pathway stimulates the left medial rectus to adduct the left eye. An MLF lesion produces internuclear ophthalmoplegia, characterized by impaired adduction of the ipsilateral eye during contralateral gaze.
In young women, this presentation is highly suspicious for a demyelinating disease such as multiple sclerosis, which frequently causes unilateral or bilateral MLF lesions. Patients often exhibit a compensatory monocular horizontal nystagmus in the contralateral abducting eye, occurring because the intact eye attempts to correct the visual disparity caused by the lagging adducted eye. Importantly, the medial rectus muscle and its direct innervation remain fully functional. Consequently, patients demonstrate normal convergence, as the neural pathways mediating near vision bypass the brainstem gaze centers entirely.
Key TakeawayWhy the Other Choices Are Wrong
- Internuclear ophthalmoplegia is caused by a lesion in the medial longitudinal fasciculus (MLF), resulting in impaired adduction of the ipsilateral eye during contralateral horizontal gaze.
- In young women, this finding is highly suggestive of demyelination from multiple sclerosis.
Choice A: The left abducens nerve innervates the left lateral rectus muscle, which is responsible for left eye abduction. A lesion here produces an ipsilateral abduction deficit, causing the affected eye to rest in an adducted position due to unopposed medial rectus tone. This patient's normal leftward horizontal gaze makes a left abducens nerve lesion unlikely.
Choice C: The left nucleus of the abducens nerve coordinates leftward horizontal gaze by stimulating both the left lateral rectus and the right medial rectus via the right MLF. Damage to this structure causes a complete leftward conjugate gaze palsy, where neither eye can look to the left. This patient's intact leftward horizontal gaze definitively rules out a left abducens nucleus lesion.
Choice D: The right abducens nerve provides motor innervation to the right lateral rectus muscle, facilitating right eye abduction. Injury to this nerve results in an isolated right eye abduction deficit and horizontal diplopia that worsens when looking to the right. This patient's isolated left eye adduction deficit rather than a right eye abduction deficit makes this diagnosis incorrect.
Choice E: The right medial longitudinal fasciculus carries signals from the left abducens nucleus to the right oculomotor nucleus to coordinate leftward gaze. A lesion in this tract causes right internuclear ophthalmoplegia, characterized by an inability to adduct the right eye during leftward horizontal gaze. This patient's deficit involves left eye adduction during rightward gaze, making a right-sided lesion incorrect.
Choice F: The right nucleus of the abducens nerve houses motor neurons for the right lateral rectus and internuclear neurons that project to the left oculomotor nucleus. Destruction of this nucleus produces a complete rightward conjugate gaze palsy, preventing both right eye abduction and left eye adduction. This patient presents with an isolated left eye adduction deficit rather than a complete rightward gaze palsy.
Block 6, Question 10
Correct Answer: A. Arteriovenous nickingExplanation
This 50-year-old man presents with a two-month history of headaches and exertional shortness of breath in the setting of poorly controlled blood pressure (180/105 mm Hg) despite hydrochlorothiazide therapy. These findings indicate symptomatic, severe hypertension with likely end-organ effects, making the most expected ophthalmoscopic finding A. Arteriovenous nicking.
Chronic elevation of systemic blood pressure causes adaptive changes in the retinal vasculature, collectively termed hypertensive retinopathy. Initially, elevated pressure induces reversible vasospasm, but persistent hypertension leads to concentric thickening of the arteriolar walls. This arteriosclerosis causes the retinal arterioles to become rigid and compress the underlying retinal veins where they cross, producing the classic nicking appearance. As the vessel walls thicken further, their optical properties change, increasing the light reflex to produce a widened, burnished appearance known as copper wiring, which can progress to opaque silver wiring in severe disease.
If blood pressure continues to rise precipitously, patients can develop severe disease characterized by a breakdown of the blood-retinal barrier. This endothelial damage leads to necrosis of the vessel walls, resulting in flame-shaped hemorrhages within the nerve fiber layer. Ischemia from arteriolar occlusion disrupts axonal transport, causing accumulation of intracellular organelles that manifest as fluffy white cotton-wool spots. In the most advanced stages, severely elevated intracranial pressure or localized ischemia leads to optic disc swelling, or papilledema, which is a defining feature of malignant hypertension requiring immediate intravenous antihypertensive therapy.
Key TakeawayWhy the Other Choices Are Wrong
- Hypertensive retinopathy develops due to chronic blood pressure elevation, initially presenting with arteriosclerosis that causes arteriovenous nicking and copper or silver wiring.
- Severe hypertension can progress to cause flame-shaped hemorrhages, cotton-wool spots, and papilledema.
Choice B: Melanocytes in the uvea are normal anatomical structures that can proliferate to form a choroidal nevus or uveal melanoma. Uveal melanoma is the most common primary intraocular malignancy in adults, typically presenting as an asymptomatic pigmented dome-shaped mass on funduscopy. This patient's poorly controlled hypertension and exertional shortness of breath make vascular retinal changes much more likely than a primary intraocular neoplasm.
Choice C: Optic neuritis is an acute inflammatory demyelination of the optic nerve that classically presents with painful monocular vision loss worsened by eye movement and an afferent pupillary defect, most commonly in young women with multiple sclerosis. This patient's chronic headaches and severely elevated blood pressure — without eye pain, acute vision loss, or neurologic deficits — make optic neuritis very unlikely.
Choice D: Posterior subcapsular cataracts are opacities located in the posterior cortical layer of the lens. They typically cause painless, progressive vision loss with significant glare, especially in bright light or when driving at night. Risk factors include advanced age, diabetes mellitus, and prolonged corticosteroid use. This patient's presentation of headaches and severe hypertension points toward retinal vascular pathology rather than an opacification of the lens.
Choice E: Tractional retinal detachment occurs when fibrovascular scar tissue pulls the neurosensory retina away from the underlying retinal pigment epithelium. It classically presents with painless vision loss or a "curtain" falling over the visual field. This condition is a major complication of proliferative diabetic retinopathy. While this patient has vascular risk factors, his severe hypertension without advanced diabetes makes hypertensive retinopathy more expected than tractional detachment.
Block 6, Question 11
Correct Answer: D. Obstruction of bile flowExplanation
This 16-day-old boy presents with jaundice, dark urine, and laboratory evaluation demonstrating conjugated hyperbilirubinemia alongside elevated transaminases and GGT. In a neonate who initially appeared healthy but develops progressive jaundice, dark urine, and poor weight gain after the first two weeks of life, these findings strongly suggest extrahepatic biliary atresia leading to obstruction of bile flow.
Neonatal cholestasis is defined by elevated direct bilirubin levels exceeding 20% of the total bilirubin. Biliary atresia is the most common cause, characterized by progressive, idiopathic, fibro-obliterative destruction of the extrahepatic biliary tree. As bile cannot reach the intestines, it regurgitates into the systemic circulation, leading to conjugated hyperbilirubinemia and dark urine. Decreased intestinal bile also impairs fat absorption, explaining this patient's drop in weight percentiles despite a normal appetite. Laboratory evaluation typically reveals elevated gamma-glutamyltransferase, a sensitive marker for biliary damage, alongside mild transaminitis; alkaline phosphatase may be physiologically elevated from normal bone growth. Without intervention, ongoing obstruction leads to portal hypertension and irreversible hepatic fibrosis.
Evaluation of suspected biliary atresia begins with an abdominal ultrasound to assess the gallbladder and rule out other structural anomalies. A hepatobiliary iminodiacetic acid scan can demonstrate hepatic uptake without intestinal excretion, but an intraoperative cholangiogram remains the gold standard for definitive diagnosis. The primary surgical intervention is the Kasai portoenterostomy, which involves anastomosing a loop of jejunum directly to the hepatic porta to restore bile flow. This procedure is most successful when performed before eight weeks of life. Despite surgical intervention, many patients eventually develop progressive liver disease requiring liver transplantation, making it the leading indication for this procedure in children.

Why the Other Choices Are Wrong
- Biliary atresia presents in the first few weeks of life with conjugated hyperbilirubinemia, dark urine, acholic stools, and elevated gamma-glutamyltransferase.
- Early diagnosis via intraoperative cholangiogram and treatment with the Kasai portoenterostomy are critical to prevent irreversible hepatic fibrosis.
Choice A: Deficiency of UDP glucuronosyltransferase causes Crigler-Najjar and Gilbert syndromes. These conditions manifest with impaired bilirubin conjugation, leading to unconjugated hyperbilirubinemia and jaundice. Crigler-Najjar syndrome type I presents early in life with severe jaundice and risk of kernicterus. This patient's predominantly conjugated hyperbilirubinemia and lack of focal neurologic findings make a deficiency of this enzyme unlikely.
Choice B: Hemolysis involves the accelerated destruction of red blood cells, which can occur in neonates due to ABO or Rh incompatibility, hereditary spherocytosis, or glucose-6-phosphate dehydrogenase deficiency. Increased heme breakdown overwhelms the hepatic conjugation capacity, producing an unconjugated hyperbilirubinemia. This patient's normal complete blood count and predominantly conjugated hyperbilirubinemia make hemolysis unlikely.
Choice C: Low activity of the bile canalicular MRP transporter causes Dubin-Johnson syndrome. This autosomal recessive disorder impairs the excretion of conjugated bilirubin into the bile canaliculus, resulting in isolated conjugated hyperbilirubinemia and a grossly black liver. Patients typically have normal transaminases and gamma-glutamyltransferase levels. This patient's elevated liver enzymes and GGT make Dubin-Johnson syndrome unlikely.
Block 6, Question 12
Correct Answer: B. Fibromuscular dysplasiaExplanation
This 21-year-old woman presents with severe, asymptomatic hypertension, left ventricular hypertrophy, and an abdominal bruit with normal serum electrolytes and renal function. This pattern of severe, resistant hypertension in a young female without evidence of primary hyperaldosteronism or intrinsic renal disease is highly characteristic of renovascular hypertension due to fibromuscular dysplasia.
Fibromuscular dysplasia is a nonatherosclerotic, noninflammatory vascular disease that predominantly affects women of childbearing age. It most commonly involves the renal and internal carotid arteries. In the renal arteries, abnormal cellular proliferation within the arterial wall leads to alternating areas of fibromuscular thickening and aneurysmal dilation, creating a characteristic "string of beads" appearance on angiography. This structural narrowing decreases renal perfusion, which is sensed by the juxtaglomerular apparatus. The resulting activation of the renin-angiotensin-aldosterone system drives severe hypertension. The presence of an abdominal bruit reflects turbulent blood flow through the stenotic renal artery.
Despite the severe blood pressure elevation, patients often have normal serum creatinine because the unaffected kidney compensates for the ischemic kidney. However, the chronic hemodynamic burden frequently leads to end-organ damage, manifesting as the left ventricular hypertrophy seen on this patient's electrocardiogram. Diagnosis is typically confirmed with duplex ultrasonography or computed tomography angiography. First-line medical therapy involves antihypertensives, particularly ACE inhibitors or angiotensin receptor blockers, though these must be used cautiously if bilateral disease is suspected. Definitive management for sustained flow restoration is percutaneous transluminal angioplasty, which lacks the need for stent placement in most cases.

Why the Other Choices Are Wrong
- Fibromuscular dysplasia typically presents in young women with severe hypertension and an abdominal bruit due to nonatherosclerotic renal artery stenosis.
- It causes renovascular hypertension via renin-angiotensin-aldosterone system activation, often with normal serum creatinine due to contralateral kidney compensation.
Choice A: Extrinsic arterial compression occurs when outside structures, such as a tumor, cyst, or fibrous band, physically compress a blood vessel. While this can cause localized ischemia and a bruit, affected patients typically experience additional symptoms related to the compressing mass, such as abdominal pain or early satiety. This patient's lack of associated abdominal symptoms and normal physical examination aside from the bruit make an extrinsic mass unlikely.
Choice C: Mid-aortic syndrome is a rare condition characterized by segmental narrowing of the abdominal aorta. Affected individuals typically present in childhood or early adulthood with severe hypertension, claudication of the lower extremities, and absent or diminished femoral pulses. This patient's presentation lacks any mention of lower extremity claudication or pulse discrepancies, making isolated renal artery involvement much more likely than aortic narrowing.
Choice D: Premature atherosclerosis involves the early formation of lipid-rich plaques in arterial walls, leading to luminal narrowing. It is the most common cause of renal artery stenosis overall but typically occurs in older men with significant cardiovascular risk factors such as smoking, diabetes mellitus, or hyperlipidemia. This patient's young age, female sex, and lack of metabolic risk factors make atherosclerotic disease highly improbable.
Choice E: Spontaneous renal artery dissection is a rare vascular event where a tear in the intimal layer creates a false lumen, compromising blood flow. Affected patients classically present with acute, severe flank or abdominal pain, often accompanied by hematuria and a sudden spike in blood pressure. This patient's asymptomatic presentation and normal basic laboratory studies lack the acute, painful features characteristic of an arterial dissection.
Block 6, Question 13
Correct Answer: D. <7500/mm³Explanation
This sample of 100 individuals presents with a normally distributed mean leukocyte count of 7500/mm³ and a standard deviation of 1000/mm³. Because a normal distribution is perfectly symmetrical, the mean is equal to the median, meaning exactly half of the values fall below the average, making the expected range for 50% of the population <7500/mm³.
A normal distribution is a continuous probability distribution characterized by a perfectly symmetrical, bell-shaped curve. In this distribution, the measures of central tendency—the mean, median, and mode—are identical and located exactly at the center. Because the curve is perfectly balanced, exactly 50% of the data values lie to the left of the mean, and 50% lie to the right. Given that the mean leukocyte count in this population is 7500/mm³, exactly half of the sampled individuals will have a leukocyte count strictly below this average.
Beyond basic symmetry, the spread of data in a Gaussian curve is strictly defined by the empirical rule. This statistical principle dictates that approximately 68% of values fall within one standard deviation of the mean, 95% fall within two, and 99.7% fall within three. Understanding these predictable population intervals allows clinicians to interpret laboratory reference ranges and establish appropriate confidence intervals. While the standard deviation of 1000/mm³ provided in the stem is essential for calculating these percentage brackets, it is mathematically irrelevant when simply identifying the 50th percentile.

Why the Other Choices Are Wrong
- In a normal (Gaussian) distribution, the mean, median, and mode are identical, meaning exactly 50% of the values fall below the mean and 50% fall above it.
- The empirical rule states that 68%, 95%, and 99.7% of values fall within 1, 2, and 3 standard deviations of the mean.
Choice A: 5500–9500/mm³ represents the range encompassing two standard deviations above and below the mean. According to the 68-95-99.7 rule, this specific interval captures approximately 95% of a normally distributed population. This scenario specifically asks for the range containing exactly 50% of the individuals, making this 95% interval mathematically incorrect.
Choice B: <6500/mm³ or >8500/mm³ represents the values falling outside of one standard deviation from the mean. Because 68% of a normally distributed population falls within one standard deviation, the remaining 32% of the population is located in these two outer tails. This scenario asks for a 50% population range, making this 32% combined tail range incorrect.
Choice C: 6500–8500/mm³ represents the range encompassing exactly one standard deviation above and below the mean. In a standard Gaussian distribution, this central interval captures approximately 68% of the total population. This scenario specifically requires identifying the range that includes exactly 50% of the sample, making this 68% interval incorrect.
Choice E: >9500/mm³ represents the upper tail of the distribution falling beyond two standard deviations above the mean. Because 95% of the population falls within two standard deviations, the remaining 5% is split symmetrically between the upper and lower tails, leaving 2.5% in this upper extreme. This scenario asks for a 50% range, making this 2.5% tail incorrect.
Block 6, Question 14
Correct Answer: C. Glycoprotein IIb-IIIaExplanation
This 10-year-old boy presents with mucocutaneous bleeding, a family history of similar symptoms, and laboratory findings of a normal platelet count, normal coagulation studies, and absent platelet aggregation in response to thrombin. The normal response to ristocetin with impaired aggregation to other agonists, alongside normal platelet morphology, is characteristic of Glanzmann thrombasthenia, an autosomal recessive bleeding disorder caused by a defect in glycoprotein IIb-IIIa.
Glanzmann thrombasthenia is an autosomal recessive disorder of primary hemostasis caused by a quantitative or qualitative deficiency of the platelet surface receptor complex. Normally, upon platelet activation by agonists like thrombin, ADP, or collagen, this receptor undergoes a conformational change that allows it to bind fibrinogen. This binding forms cross-links between adjacent platelets, mediating the crucial step of platelet aggregation to form a stable platelet plug. A defect in this receptor prevents platelets from clumping together, leading to the mucocutaneous bleeding seen in this patient, such as epistaxis, gingival bleeding, and ecchymoses, despite a normal platelet count.
Diagnosis relies heavily on specialized platelet function testing. In Glanzmann thrombasthenia, the ristocetin cofactor assay demonstrates normal platelet agglutination because ristocetin facilitates the interaction between von Willebrand factor and glycoprotein Ib, both of which are intact in this condition. However, aggregation fails with all other physiologic agonists, including thrombin, because the final common pathway of cross-linking is broken. Furthermore, prothrombin time and activated partial thromboplastin time remain normal because the coagulation cascade, which drives secondary hemostasis, is completely unaffected. Management primarily involves supportive care with local hemostatic measures, antifibrinolytics, and platelet transfusions for severe bleeding episodes.
Key TakeawayWhy the Other Choices Are Wrong
- Glanzmann thrombasthenia is an autosomal recessive bleeding disorder caused by a defect in platelet glycoprotein IIb-IIIa, which prevents fibrinogen binding and subsequent platelet aggregation.
- It presents with mucocutaneous bleeding, normal platelet count, normal ristocetin response, but absent aggregation to other agonists like thrombin.
Choice A: Factor VII (proconvertin) deficiency is a rare autosomal recessive coagulation disorder that impairs the extrinsic pathway of the coagulation cascade. Patients typically present with deep tissue bleeding or severe epistaxis. Isolated deficiency characteristically prolongs the prothrombin time (PT) while the activated partial thromboplastin time (aPTT) remains normal. This patient's normal PT and isolated defect in platelet aggregation make a Factor VII deficiency unlikely.
Choice B: Fibrinogen (Factor I) deficiency, such as afibrinogenemia, is a rare bleeding disorder characterized by the absence or severe reduction of circulating fibrinogen. Fibrinogen is essential for both primary and secondary hemostasis. Consequently, severe deficiency results in prolonged PT, aPTT, and thrombin time, along with absent platelet aggregation to all agonists, including ristocetin. This patient's normal PT, normal aPTT, and normal response to ristocetin effectively rule out a quantitative fibrinogen defect.
Choice D: Granule storage pool deficiency involves an absence or dysfunction of platelet alpha or dense granules. Dense granule deficiency impairs the secondary wave of platelet aggregation due to inadequate release of ADP and serotonin. Aggregation studies typically show a normal primary wave but an absent secondary wave, while the response to thrombin remains largely intact. This patient's complete lack of aggregation to thrombin makes this defect unlikely.
Choice E: von Willebrand factor (vWF) deficiency causes von Willebrand disease, the most common inherited bleeding disorder. vWF normally bridges platelet glycoprotein Ib to exposed subendothelial collagen. Deficiency causes mucocutaneous bleeding and characteristically shows an abnormal ristocetin cofactor assay, as ristocetin requires vWF to induce platelet agglutination. The aPTT may also be prolonged. This patient's normal response to ristocetin and normal aPTT rule out von Willebrand disease.
Block 6, Question 15
Correct Answer: C. Geographically isolated populationExplanation
This 36-year-old woman presents with early-onset invasive ductal carcinoma of the breast associated with a specific BRCA2 mutation that is highly prevalent in her country of origin. The disproportionately high frequency of this specific 999del5 mutation in a population with a limited genetic pool is a classic example of the founder effect occurring within a geographically isolated population.
The high prevalence of the BRCA2 999del5 mutation in Iceland illustrates the founder effect, a specific type of genetic drift. This phenomenon occurs when a small group of individuals establishes a new colony, causing their specific alleles to become disproportionately frequent in subsequent generations. In geographically restricted areas, limited gene flow from outside sources maintains these high allele frequencies. This explains why certain genetic variants become highly concentrated in specific endogamous populations such as Ashkenazi Jews, Amish, or Icelanders. Furthermore, the lack of family history in this patient despite a strong genetic driver highlights how incomplete penetrance can obscure the presence of these alleles across generations.
The BRCA2 gene functions as a critical tumor suppressor gene responsible for repairing double-strand DNA breaks. It operates via homologous recombination, a highly accurate repair mechanism that uses a sister chromatid as a template to restore genetic integrity. Mutations like the 999del5 variant lead to truncated, nonfunctional proteins, forcing cells to rely on error-prone repair pathways such as non-homologous end joining. This genomic instability significantly increases the lifetime risk of developing early-onset breast, ovarian, and pancreatic malignancies. Patients with known mutations require intensive surveillance, often including annual magnetic resonance imaging of the breast starting at a young age to detect invasive ductal carcinomas early.
Key TakeawayWhy the Other Choices Are Wrong
- The founder effect occurs when a small group establishes a new, geographically isolated population, causing specific rare alleles (like the BRCA2 999del5 mutation in Iceland) to become disproportionately common.
- BRCA2 mutations impair homologous recombination, increasing the risk of breast and ovarian cancers.
Choice A: A population bottleneck describes a sharp reduction in population size due to environmental events, leading to decreased genetic diversity. This phenomenon occurs following catastrophic events such as famines, earthquakes, or widespread infectious disease pandemics that indiscriminately kill a large percentage of individuals. This patient's breast cancer diagnosis represents a post-reproductive somatic disease, not an acute environmental catastrophe capable of decimating an entire population.
Choice B: Genetic heterogeneity refers to the phenomenon where mutations at different genomic loci produce the same clinical phenotype. Breast and ovarian cancers exhibit profound locus heterogeneity, as mutations in BRCA1, BRCA2, TP53, or PALB2 can all lead to similar hereditary cancer syndromes. This patient's presentation of a single, specific mutation (999del5) causing a large percentage of regional cases illustrates an isolated founder mutation rather than broad genetic heterogeneity.
Choice D: Heterozygote advantage occurs when individuals carrying one copy of a recessive allele have a higher survival rate than both homozygous dominant and homozygous recessive individuals. The classic example is sickle cell trait, where heterozygous carriers possess a survival advantage against severe malaria infections. This patient's BRCA2 mutation confers a significantly increased risk of lethal malignancy without providing any known survival or reproductive advantage to heterozygous carriers.
Choice E: Random mating in a very large population is a core assumption of the Hardy-Weinberg principle, which states that allele frequencies remain constant across generations. In such populations, genetic drift is negligible, and rare mutations do not become highly prevalent. This patient's Icelandic heritage represents a small, historically restricted gene pool rather than a large, randomly mating population.
Block 6, Question 16
Correct Answer: B. Left atriumExplanation
This 65-year-old woman presents with recurrent syncope and signs of ventricular dysfunction (S3 and S4) and is found to have a pedunculated intracardiac mass with histology showing stellate cells in a myxoid stroma. These findings are highly characteristic of a cardiac myxoma, the most common primary cardiac tumor in adults, which most frequently arises in the Left atrium.
Cardiac myxomas are the most common primary cardiac neoplasms in adults and predominantly originate in the left atrium, typically attached to the fossa ovalis. Histologically, they are characterized by scattered spindle and multinucleated stellate cells embedded in an abundant, loose glycosaminoglycan-rich stroma. Because of their pedunculated morphology, these tumors are highly mobile and can intermittently prolapse through the mitral valve during diastole. This transient ball-valve obstruction of left ventricular filling leads to a sudden decrease in cardiac output, manifesting as the recurrent syncope seen in this patient.
Beyond mechanical obstruction, myxomas frequently produce systemic symptoms such as fever, weight loss, and fatigue due to the autonomous production of interleukin-6. Physical examination classically reveals an early diastolic tumor plop, though patients may also develop an S3 and S4 due to secondary heart failure or altered ventricular compliance from chronic mitral valve dysfunction. Another major complication is systemic embolization, which occurs when tumor fragments or overlying thrombi dislodge, potentially causing ischemic strokes or peripheral ischemia. Prompt surgical resection is usually curative and prevents these severe ischemic complications.
Key TakeawayWhy the Other Choices Are Wrong
- Cardiac myxomas are the most common primary cardiac tumor in adults and typically arise in the left atrium near the fossa ovalis.
- They present with syncope due to transient mitral valve obstruction and histologically show stellate cells in a glycosaminoglycan-rich myxoid stroma.
Choice A: The interventricular septum is the classic location for asymmetric septal hypertrophy seen in hypertrophic cardiomyopathy, as well as some congenital defects. Hypertrophic cardiomyopathy presents with exertional syncope, angina, and a harsh crescendo-decrescendo systolic murmur due to left ventricular outflow tract obstruction. Histology demonstrates massive myocyte hypertrophy and haphazard myofiber disarray. This patient's pedunculated mass and myxoid histology with stellate cells make hypertrophic cardiomyopathy and a septal location unlikely.
Choice C: The left ventricle is the most common site for cardiac fibromas, which are benign primary cardiac tumors. Fibromas typically occur in infants and young children, often presenting with arrhythmias, heart failure, or sudden cardiac death. Histologically, they are unencapsulated masses composed of dense, interlacing bundles of mature fibroblasts and collagen without a myxoid background. This patient's older age, pedunculated mass morphology, and classic myxoid histology make a left ventricular fibroma unlikely.
Choice D: The right atrium is a common location for cardiac angiosarcomas, the most frequent primary malignant cardiac tumor in adults. Angiosarcomas are highly aggressive tumors that frequently cause right-sided heart failure or cardiac tamponade. Histological examination reveals pleomorphic endothelial cells forming irregular vascular channels. This patient's benign-appearing stellate cells in a loose myxoid stroma lacking malignant vascular channels make a right atrial angiosarcoma unlikely.
Choice E: The right ventricle is a frequent site for cardiac rhabdomyomas, the most common primary cardiac tumor in children. Rhabdomyomas are strongly associated with tuberous sclerosis and typically present in infancy with heart failure or arrhythmias. Histologically, they are characterized by large, polygonal cells with clear cytoplasm and thin strands of cytoplasm extending to the cell membrane, known as spider cells. This patient's older age and the presence of scattered spindle cells in a myxoid stroma make a right ventricular rhabdomyoma unlikely.
Block 6, Question 17
Correct Answer: D. Preformed antibodies in the recipientExplanation
This 45-year-old woman presents with immediate graft swelling and multifocal hemorrhage within 10 minutes of vascular anastomosis during a kidney transplant for end-stage renal disease requiring hemodialysis. This rapid, intraoperative destruction of the transplanted organ despite well-controlled blood pressure on an ACE inhibitor is characteristic of hyperacute rejection, a process mediated by preformed antibodies in the recipient.
Hyperacute rejection occurs minutes to hours after transplantation when the recipient has preexisting antibodies against donor ABO or human leukocyte antigens (HLA). Previous exposure to foreign HLA through blood transfusions, pregnancies, or prior transplants leads to allosensitization. Once donor vessels are anastomosed, these circulating antibodies immediately bind to the graft vascular endothelium. This binding triggers complement activation, leading to widespread endothelial damage, platelet aggregation, and the formation of microvascular thrombi. The resulting severe ischemia causes rapid graft necrosis, manifesting intraoperatively as a mottled, cyanotic organ that requires immediate graft removal.
To prevent this catastrophic complication, patients awaiting transplantation undergo rigorous immunologic screening. A panel reactive antibody test assesses the recipient's baseline allosensitization by measuring existing antibodies against a broad array of population HLA antigens. Immediately prior to surgery, a direct crossmatch is performed by mixing recipient serum with donor lymphocytes to detect specific preformed donor-directed antibodies. If positive, the transplant is absolutely contraindicated. Unlike acute rejection, which is typically mediated by a cellular immune response occurring weeks to months later, hyperacute rejection is irreversible and unresponsive to medical therapy.
Key TakeawayWhy the Other Choices Are Wrong
- Hyperacute rejection occurs within minutes of transplantation due to preformed recipient antibodies against donor ABO or HLA antigens.
- It causes widespread microvascular thrombosis and graft ischemia, necessitating immediate removal of the transplanted organ.
Choice A: Perfusate hypersensitivity in the donor refers to an allergic reaction to the preservation fluid used to flush and store the organ before transplantation. Hypersensitivity reactions typically present with systemic signs like urticaria, bronchospasm, or hypotension in the affected individual. This patient's isolated, immediate graft thrombosis and hemorrhage without systemic anaphylactic signs make a perfusate hypersensitivity reaction unlikely.
Choice B: Perfusate hypersensitivity in the recipient would involve an IgE-mediated allergic reaction to the organ preservation solution once it enters the recipient's circulation. Classic manifestations include sudden-onset hypotension, wheezing, and angioedema upon reperfusion. This patient's stable vital signs and localized, rapid destruction of the allograft make an allergic reaction to the perfusate unlikely.
Choice C: Preformed antibodies in the donor would be diluted in the recipient's circulation and do not cause graft-versus-host disease. GVHD is mediated by immunocompetent donor T lymphocytes (not antibodies) that attack recipient tissues. This complication is common in hematopoietic stem cell transplants and typically manifests with maculopapular rash, jaundice, and diarrhea. This patient's immediate, organ-specific graft destruction rather than systemic recipient tissue damage makes donor-derived antibodies unlikely.
Choice E: Sensitized CD8+ T lymphocytes in the donor mediate graft-versus-host disease by recognizing recipient human leukocyte antigens as foreign. This cellular response leads to widespread epithelial apoptosis in the recipient's skin, liver, and gastrointestinal tract over weeks to months. This patient's immediate intraoperative timeline and isolated graft hemorrhage make donor-derived cellular rejection unlikely.
Choice F: Sensitized CD8+ T lymphocytes in the recipient mediate acute cellular rejection, which is a delayed type IV hypersensitivity reaction. This process typically occurs weeks to months after transplantation and presents with an asymptomatic rise in serum creatinine or decreased urine output. This patient's acute graft swelling and hemorrhage within 10 minutes of anastomosis make a cellular-mediated process unlikely.
Video Review: Hyperacute Rejection
Block 6, Question 18
Correct Answer: A. Bone remodelingExplanation
This 65-year-old man presents with sudden, non-traumatic right thigh pain and a midshaft femoral fracture in the setting of multiple myeloma. He is currently taking a bisphosphonate, which is commonly used to prevent skeletal-related events in this malignancy. This presentation of an atypical femoral fracture is a known complication of prolonged bisphosphonate therapy, which inherently disrupts normal bone remodeling.
Bisphosphonates are pyrophosphate analogs that avidly bind to hydroxyapatite crystals in bone tissue. During bone resorption, these drugs are internalized by osteoclasts, where they inhibit farnesyl pyrophosphate synthase, an essential enzyme in the mevalonate pathway. This disruption prevents the prenylation of small GTPase proteins, ultimately triggering osteoclast apoptosis. While this profound suppression of bone turnover effectively prevents pathologic fractures from osteolytic lesions in multiple myeloma, it severely impairs the clearance of normal skeletal microdamage. Over years of therapy, accumulated microcracks increase bone brittleness, predisposing patients to atypical femoral fractures in the subtrochanteric or diaphyseal regions following minimal or no trauma.
In addition to atypical fractures, prolonged bisphosphonate therapy carries a significant risk for osteonecrosis of the jaw, which classically presents as exposed, necrotic bone in the maxillofacial region following invasive dental procedures. Patients are typically advised to complete major dental work prior to initiating therapy. Another major adverse effect associated with oral formulations is pill-induced esophagitis, necessitating that patients remain upright for 30 minutes after ingestion with a full glass of water. Furthermore, rapid intravenous administration, often utilized in malignancy, can precipitate transient hypocalcemia, requiring adequate calcium and vitamin D supplementation prior to treatment to prevent neuromuscular irritability.

Why the Other Choices Are Wrong
- Prolonged bisphosphonate therapy severely suppresses bone turnover, impairing the clearance of normal skeletal microdamage.
- Accumulated microcracks increase bone brittleness, predisposing patients to atypical femoral fractures in the subtrochanteric or diaphyseal regions following minimal or no trauma.
Choice B: Osteoblast generation refers to the differentiation of mesenchymal stem cells into bone-forming cells, a process stimulated by intermittent parathyroid hormone administration. Impaired osteoblast generation characterizes conditions like adynamic bone disease or glucocorticoid-induced osteoporosis, leading to decreased bone formation. This patient's midshaft femoral fracture is a classic complication of bisphosphonate therapy, which primarily targets osteoclast-mediated bone resorption rather than directly inhibiting osteoblast generation.
Choice C: Decreased serum calcium concentration is a potential transient side effect of rapid intravenous bisphosphonate administration. Severe hypocalcemia presents with neuromuscular irritability, including perioral numbness, carpopedal spasm, and facial nerve twitching, eventually leading to seizures. This patient's presentation of a non-traumatic midshaft femoral fracture reflects structural bone compromise from impaired microdamage repair, not an acute derangement in serum calcium concentration.
Choice D: Serum 25-hydroxycholecalciferol concentration is the primary indicator of vitamin D stores, which are depleted in osteomalacia. Vitamin D deficiency impairs intestinal calcium absorption, leading to defective mineralization of osteoid. This manifests with diffuse bone pain, muscle weakness, and pseudofractures on radiography. This patient's acute, localized thigh pain and complete diaphyseal fracture point to bisphosphonate-induced suppression of bone turnover rather than a primary deficiency in serum 25-hydroxycholecalciferol concentration.
Choice E: Serum parathyroid hormone concentration is elevated in primary hyperparathyroidism, usually due to a parathyroid adenoma. Excess parathyroid hormone stimulates continuous osteoclast activity, leading to osteitis fibrosa cystica. This condition is characterized by subperiosteal bone resorption, cystic bone spaces filled with brown fibrous tissue, and hypercalcemia. This patient's isolated midshaft femoral fracture without evidence of cystic bone lesions makes an underlying abnormality in serum parathyroid hormone concentration unlikely.
Block 6, Question 19
Correct Answer: C. InversionExplanation
This 45-year-old man presents with acute left ankle pain, localized edema, and an inability to bear weight following a twisting injury. Physical examination reveals tenderness specifically located just distal to the lateral malleolus, localizing the injury to an anterior talofibular ligament sprain caused by inversion.
Lateral ankle sprains are the most common type of ankle injury, typically occurring when the foot is forcefully turned inward while bearing weight. This mechanism places excessive stress on the lateral ligamentous complex, which consists of the anterior talofibular, calcaneofibular, and posterior talofibular ligaments. The anterior talofibular ligament is the weakest and most frequently injured structure in this complex. Injury to this ligament produces localized pain, swelling, and ecchymosis directly anterior and distal to the lateral malleolus. Diagnosis is primarily clinical, utilizing the anterior drawer test to assess the integrity of this specific ligament by demonstrating increased forward translation of the talus.
Management of acute ankle sprains initially focuses on reducing inflammation and protecting the joint, utilizing rest, ice, compression, and elevation alongside early functional rehabilitation. While this patient has soft tissue tenderness, his inability to bear weight both immediately after the injury and in the emergency department necessitates radiographic evaluation according to the Ottawa ankle rules. This validated clinical decision aid helps clinicians rule out underlying fractures of the fibula, tibia, or midfoot. Severe or recurrent sprains can lead to chronic ankle instability, which may predispose patients to early-onset osteoarthritis and require prolonged physical therapy or eventual surgical reconstruction.

Why the Other Choices Are Wrong
- Lateral ankle sprains are the most common ankle injury, typically caused by forced inversion of the foot.
- The anterior talofibular ligament is the most frequently injured structure, presenting with tenderness distal to the lateral malleolus.
Choice A: Dorsiflexion is the upward movement of the foot toward the anterior tibia. Extreme dorsiflexion injuries typically damage the syndesmotic ligament complex between the distal tibia and fibula, causing a high ankle sprain. This presents with pain proximal to the ankle joint that worsens with external rotation of the foot. This patient's localized tenderness distal to the lateral malleolus makes a syndesmotic injury unlikely.
Choice B: Eversion involves the outward turning of the sole of the foot. This mechanism places stress on the medial aspect of the ankle, classically injuring the strong, multi-banded deltoid ligament. Patients with deltoid ligament sprains present with focal pain, swelling, and tenderness directly over or inferior to the medial malleolus. This patient's tenderness on the lateral aspect of the ankle makes a medial deltoid ligament injury unlikely.
Choice D: Plantar flexion is the downward movement of the foot away from the lower leg. While plantar flexion often accompanies inversion during lateral ankle sprains, isolated forceful plantar flexion primarily injures the dorsal capsular structures or contributes to Achilles tendon ruptures, presenting with posterior heel pain. This patient's focal tenderness distal to the lateral malleolus rather than the posterior ankle makes isolated plantar flexion unlikely.
Video Review: Ankle Sprain
Block 6, Question 20
Correct Answer: E. Ventilation-perfusion mismatchExplanation
This 3-year-old boy presents with sudden-onset coughing, gagging, post-tussive emesis, tachypnea, tachycardia, and mild hypoxemia after eating candy, with decreased breath sounds on the left. The chest x-ray shows hyperinflation of the left lung, widened intercostal spaces, and a rightward mediastinal shift, indicating a ball-valve obstruction from foreign body aspiration that causes hypoxemia via a ventilation-perfusion mismatch.
Foreign body aspiration typically occurs in young children and often involves food items like nuts or candy. When an object lodges in a bronchus, it can create a ball-valve obstruction where air enters during inspiration but is trapped during expiration. This leads to distal air trapping, localized hyperinflation, and contralateral mediastinal shift. The obstructed lung segment receives normal blood flow but lacks adequate ventilation, creating a localized area of intrapulmonary shunting. This extreme form of ventilation-perfusion mismatch results in impaired alveolar gas exchange, leading to poorly oxygenated blood returning to the systemic circulation and causing hypoxemia.
Management of suspected foreign body aspiration requires prompt intervention to prevent respiratory failure or post-obstructive pneumonia. The definitive diagnostic and therapeutic step is rigid bronchoscopy, allowing for direct visualization and safe removal of the object. While right mainstem bronchus aspirations are more common in adults due to its wider, more vertical path, children frequently aspirate into either side. If the obstruction is complete rather than partial, it leads to resorption atelectasis, characterized by volume loss and an ipsilateral mediastinal shift. Supplemental oxygen is essential until the airway is secured and bronchial clearance is achieved.
Key TakeawayWhy the Other Choices Are Wrong
- Foreign body aspiration can cause a ball-valve obstruction, leading to localized air trapping, hyperinflation, and a contralateral mediastinal shift.
- The obstructed lung segment continues to be perfused but is not ventilated, resulting in a ventilation-perfusion mismatch and subsequent hypoxemia.
Choice A: Decreased chest wall compliance refers to a restriction in the outward expansion of the thoracic cavity, limiting lung inflation. This restrictive pattern is typically seen in conditions like severe kyphoscoliosis, morbid obesity, or neuromuscular disorders such as Guillain-Barré syndrome. This patient's acute onset of symptoms following a choking episode and unilateral hyperinflation on x-ray make decreased chest wall compliance unlikely.
Choice B: A diffusion defect occurs when there is an impairment in the transfer of gases across the alveolar-capillary membrane. This mechanism of hypoxemia is characteristic of interstitial lung diseases, pulmonary fibrosis, or severe pulmonary edema, where the membrane is thickened or damaged. This patient's sudden onset of hypoxia after eating candy and unilateral decreased breath sounds make a diffusion defect unlikely.
Choice C: An extrapulmonary right-to-left shunt involves deoxygenated blood bypassing the lungs entirely and entering the systemic circulation. This pathophysiology is the hallmark of cyanotic congenital heart defects, such as tetralogy of Fallot or transposition of the great vessels, which typically present with chronic cyanosis or murmurs. This patient's previously healthy status, acute choking event, and localized lung hyperinflation make an extrapulmonary right-to-left shunt unlikely.
Choice D: Increased chest wall compliance refers to a highly distensible thoracic cavity, a normal physiologic state in infants and young children. This high compliance allows for easier chest expansion but can lead to pronounced intercostal retractions during episodes of increased work of breathing. This patient's sudden onset of hypoxia, unilateral decreased breath sounds, and localized hyperinflation make increased chest wall compliance an unlikely primary cause of his hypoxemia.




.jpg)
.webp)


